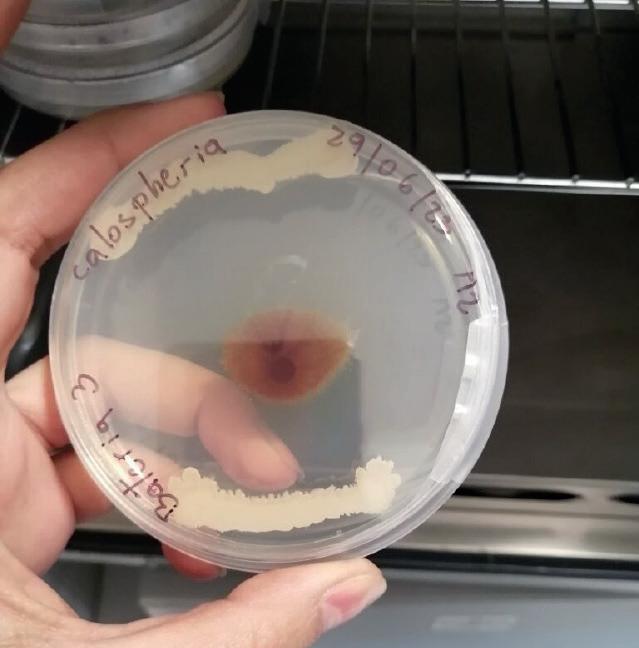

Superior Técnico Profesional y gestión del conocimiento Producción



Observatorio de la Educación Superior Técnico Profesional - Producción y gestión del conocimiento
Observatorio de la Educación Superior Técnico Profesional
Producción y gestión del conocimiento
Observatorio Duoc UC / Anuario 2024 / página 2
Observatorio de la Educación Superior Técnico Profesional - Producción y gestión del conocimiento
OBSERVATORIO DE LA EDUCACIÓN SUPERIOR TÉCNICO PROFESIONAL
Producción y gestión del conocimiento.
Anuario de publicaciones, período 2024. Duoc UC 2024.
ISBN N° 978-956-8901-32-5
Registro de Propiedad Intelectual N° 2025-A-12652
Coordinador / Editor
Samuel Vial Muñoz.
Secretaría General de Duoc UC.
Diseño y diagramación:
Agencia de Publicidad & Productora taller700 / www.taller700.cl patriciouribeb@taller700.cl
Octubre 2025
Para facilitar la lectura, se evita el uso continuo del duplicado de género. Así cada vez que se hace mención, por ejemplo, a profesor o docente se entiende que se considera a los dos géneros, sin que ello implique ningún tipo de valoración peyorativa o discriminatoria.
Las personas entrevistadas en los boletines, así como aquellas que escriben columnas de opinión, son mencionadas con los cargos que ocupaban al momento de aportar su contribución.
Observatorio Duoc UC / Anuario 2024 / página 3
Avances y transformaciones de Duoc UC en su identidad y expansión territorial (1985-1998)
Duoc UC: Cimientos y modernización entre 1968-1985
Duoc UC: Un legado de excelencia y compromiso desde 1968 hasta 2024.
El nacimiento y evolución del modelo formativo basado en competencias en Duoc UC entre 1998-2013.
Expansión territorial, excelencia académica y compromiso integral (1998-2012)
Inspiración, innovación y compromiso en los 56 años de Duoc UC
Un Duoc UC insertado en un contexto de ingentes cambios culturales y que se prepara para responder a las demandas del siglo XXI.
Duoc UC: Una
de acreditación: Un hito para mostrar la calidad en Duoc
Rumbo a la excelencia: Duoc UC terminando su proceso de autoevaluación para la acreditación 2024.
El aborto y la eutanasia, dilemas sobre el derecho a la vida
El nacimiento de Jesús en tiempos de transformaciones tecnológicas y esperanza eterna.
Observatorio de la Educación Superior Técnico Profesional - Producción y gestión del conocimiento
El sentido de la educación integral en Duoc
Trascendiendo la educación: Una mirada desde Duoc UC
Una perspectiva cristiana sobre la dignidad humana y la cultura del respeto en Duoc UC
Construyendo Puentes: Investigación aplicada, innovación y transferencia en Duoc
Innovación en las sedes de Duoc UC: Impulsando la excelencia educativa
Aprendizaje permanente: El rol esencial de las instituciones educativas en la era digital
Boletín N°69 Observatorio Duoc UC, algunas estrategias metodológicas activas para el aprendizaje que hoy se aplican en Duoc UC
Competencias, capacidades y empleabilidad: Lo que las empresas hoy buscan
Del aprender haciendo al aprender a innovar: El futuro para la Educación Técnico Profesional
La capacitación laboral en la era de la innovación tecnológic
La Educación Superior Técnico Profesional (ESTP): Un pilar para el futuro de Chile
La IA como asistente de las personas: Desafíos y oportunidades para la Educación Técnico Profesional
La inteligencia artificial y su impacto en la educación: una oportunidad, un desafío y un llamado ético
La naturaleza actual de la Educación Técnico Profesional chilena y su necesidad de transfomación
Transformación de la Educación Técnico Profesional: Imperativos para el siglo XXI
Observatorio de la Educación Superior Técnico Profesional - Producción y gestión del conocimiento
Un presente bisagra, entre la permanencia y el cambio urgente
VI. Gestión institucional, procesos y vinculación
Agilidad y mejora continua de nuestros procesos en Duoc UC
Boletín N°66: Conectados al territorio: Experiencias de VcM
Editorial: Boletín N°68 Observatorio Duoc UC: Instalación, resultados y desafíos de la Dirección de Gobierno de Datos y Análisis Institucional para decidir con convicción y actuar con agilidad en Duoc UC
Discurso del Rector Carlos Díaz Vergara con motivo de la cuenta anual 2023 de Duoc UC
Jornada de inclusión: Discurso del Vicerrector Académico, Kiyoshi Fukushi Mandiola.
La evolución de la Subdirección de Procesos Académicos: innovación y eficiencia en Duoc UC
Titulados inspiradores de Duoc UC
Un compromiso transformador hacia la convivencia, inclusión y equidad de género.
en Tecnologías
Conoce las Innovaciones de la UAP San Carlos de Apoquindo para fortalecer la Comunidad Docente
Curso Digital sobre Convivencia, Inclusión y Equidad de Género
Día del Técnico Profesional: 82 Años de progreso y desafíos
Discurso Cuenta Anual 2023 de Duoc UC
Mauricio Benavente Martínez.
Rojas Bustos.
María Loreto Ortúzar Squella
Claudio Salas Soto
Ignacio Sánchez Díaz
de la sede
Observatorio de la Educación Superior Técnico Profesional - Producción y gestión del conocimiento
Título
Discurso de finalización de la Jornada de jefes de UAP 2023
Docentes y titulados de Duoc UC al rescate de nuestro patrimonio
Sebastián Sánchez Díaz.
Andrea Valle Gabrielli.
El Poder del Podcast: Potenciando habilidades y conocimiento en la sede Plaza Norte
Matías Flores Decar. S
Director de Formación y Desarrollo Docente de Duoc UC. 153
Subdirectora de la Escuela de Comunicación, carrera de Actuación de Duoc UC.
157
Subdirector de Admisión, Comunicación y Extensión sede Plaza Norte de Duoc UC. 162
Paula Ramírez Hernández. Jefa de Comunicaciones sede Plaza Norte de Duoc UC.
Entrevista al sacerdote Pablo Leiva Rojas Equipo Editorial Observatorio Duoc UC Observatorio Duoc UC 165
Pozo Cáceres. Ingeniera de Control de Gestión sede Plaza Norte de Duoc UC.
Estrategias para Mejorar la Progresión y Titulación en la sede Plaza Norte
Ética y cultura, una mezcla virtuosa en Duoc UC
La inteligencia espiritual en el ámbito de la formación de personas. Reflexiones sobre nuestra identidad católica y nuestro propósito institucional
Pasantías Docentes: un desafío de humildad, motivación y profesionalismo
Puertas abiertas al conocimiento de inglés: English Corner, un espacio seguro para desarrollar las destrezas lingüísticas en comunidad
Taller de teatro para colaboradores. De la oficina al escenario, potenciando el desarrollo organizacional.
Testimonio de la estudiante de Diseño Gráfico Camila Droguett Castro, en la Jornada de Inclusión de Duoc UC.
Wladimir Ferrada Pino.
Juan Eugenio González P.
168
Director de Carreras de la Escuela de Ingeniería, Medioambiente y Recursos Naturales de la sede Plaza Norte de Duoc UC.
Jefe de los programas transversales de ética y formación cristiana en la sede San Carlos de Apoquindo de Duoc UC.
171
P. Paulo Lizama Silva. Capellán de la sede Viña del Mar de Duoc UC 175
Claudia Delgado Salas. Subdirectora de la Escuela Turismo y Hospitalidad de Duoc UC.
Juan Pedro Gutiérrez Rodríguez.
186
Jefe de los programas transversales de lenguaje e inglés de la sede San Carlos de Apoquindo de Duoc UC
189
Andrea Valle Gabrielli. Subdirectora Escuela de Comunicación. 193
Camila Droguett Castro
Estudiante de Diseño Gráfico sede Padre Alonso de Ovalle.
Observatorio Duoc UC / Anuario 2024 / página 7
197
Observatorio de la Educación Superior Técnico Profesional - Producción y gestión del conocimiento
Título
Autor Cargo Página
II. Investigación Aplicada, Innovación y Sustentabilidad 199
Desarrollo de Bioantagonistas para el Control de Hongos en Cerezos: Un Proyecto Colaborativo de Investigación Aplicada
Desarrollo de un Bioestimulante para la producción de setas, en base a algas nativas de las Costas de Chile
El impacto del cambio climático en la vitivinicultura chilena: Una solución innovadora para la reducción del alcohol en vinos
Expo Diseñar Sustentable
Gestión hídrica intrapredial utilizando sistemas de aeronaves pilotadas por control remoto (RPAS)
Innovación Tecnológica para el Cuidado de Adultos Mayores: Proyecto ELEAM@TIC y la Detección de Caídas en Chile
La contribución de proyectos tecnológicos al bienestar animal y la sustentabilidad: El caso del forraje hidropónico en Buinzoo
La experiencia del Proyecto Pyura de la Escuela de Gastronomía en la sede San Andrés de Concepción
Proyecto COIL 2024-02: Innovación y Tecnología en la Prevención de Enfermedades Crónicas
Claudia Carreras Castillo
Militza Urriola Ossandón
Cristóbal Parry Andrade
Cristina Rivera Bay-Schmith.
Paulo Caviglia Veloso.
María Edith Jiménez Gómez
Mauricio Figueroa Colarte
Abel Araya Castro
Gabriel Pinto Osses
Lionel Pizarro Melo
Docente de la Escuela de Ingeniería, Medio Ambiente y Recursos Naturales de la sede San Bernardo de Duoc UC.
Docente de la Escuela de Ingeniería, Recursos Naturales y Medioambiente de la sede Puente Alto de Duoc UC.
200
205
Docente de la Escuela de Ingeniería, Recursos Naturales y Medioambiente de la sede Puente Alto de Duoc UC. 210
Docente Investigadora de la Escuela de Diseño de Duoc UC. 214
Subdirector de Proyectos de la Escuela de Diseño de Duoc UC
Docente de la Escuela de Ingeniería, Medio Ambiente y Recursos Naturales de la sede Puente Alto de Duoc UC.
Docente Asociado e Investigador y Coordinador de Proyectos Tecnológicos en la sede Viña del Mar de Duoc UC.
Docente de la Escuela de Ingeniería, Recursos Naturales y Medioambiente de la sede Puente Alto de Duoc UC.
Docente de la Escuela de Gastronomía de la sede San Andrés de Concepción de Duoc UC
Docente titular Escuela de Informática y Telecomunicaciones sede Viña del Mar de Duoc UC.
218
224
230
234
238
Proyecto Cron app
Proyecto Piloto, Revista Ciencia Aplicada y Educación Duoc UC (CAED)
Claudia Orellana Lagos
Katia Isamitt García
Docente de la Escuela de Salud de la sede San Joaquín de Duoc UC.
Subdirectora Académica de la sede Alameda de Duoc UC.
Observatorio Duoc UC / Anuario 2024 / página 8
246
250
Observatorio de la Educación Superior Técnico Profesional - Producción y gestión del conocimiento
Título Autor
Reducción de la Brecha de Género en STEAM: Experiencias y resultados del proyecto Inclusteam
Tecnología y Medio Ambiente: Desarrollando Soluciones Sustentables para el Reciclaje de Plásticos en la Región del Biobío
Vivienda CLT-R: un proyecto de investigación aplicada basado en la innovación y la colaboración
Andrea Zambrano Marín
Adopción digital permanente: Más allá del cambio y la obsolescencia tecnológica
Aprendizaje con drones desde la meta teoría de David Kolb
Patricio Troncoso Ovando
Roger Salazar Sandoval
Docente de la Escuela de Informática y Telecomunicaciones de la sede San Andrés de Concepción de Duoc UC.
Docente de la Escuela de Ingeniería, Recursos Naturales y Medioambiente de la sede San Andrés de Concepción de Duoc UC.
Docente de la Escuela de Construcción de la sede San Bernardo de Duoc UC.
Alejandra Salinas Flores Especialista en Adopción Digital
Luis Torres Valencia.
Alejandro Salinas Cáceres.
C1DO1: Un nuevo paso de Duoc UC en la implementación de tecnologías educativas
CiberVoluntarios: Una nueva comunidad en Duoc UC
Docente Holograma: La tecnología que revolucionará el proceso de enseñanza aprendizaje
El Centro de Competencias Ágiles – Playbook para impulsar la cultura ágil, innovadora y colaborativa dentro de la Dirección General de Servicios Digitales
Gestionando la incertidumbre: estrategias de anticipación en productos digitales
Innovación y diversidad: La Escuela IT de Duoc UC como referente en tendencias internacionales
La investigación aplicada desde el Centro Tecnológico de la Escuela de Informática y Telecomunicaciones
Los desafíos de la ciberseguridad
Docente Escuela de Construcción de la sede Valparaíso de Duoc UC
Docente Escuela de Ingeniería, Medioambiente y Recursos Naturales de la sede Valparaíso de Duoc UC.
Manuel Ayala Maraboli Jefe de Proyectos de Tecnologías Educativas
Claudio Alcota Henríquez
Deninson Rangel Moreno
Subdirector de Proyectos de la Escuela de Informática y Telecomunicaciones de Duoc UC 279
Jefe de Proyectos de Tecnologías Educativas. Dirección de Experiencia y Aprendizaje Digital de Duoc UC. 283
Carlos Manzur Vicencio Líder Agile. Centro de Competencias Ágiles
Daniel Carrasco Medina
Jhonnathan Alexis Vergara Alvarado
Cristián Eduardo Molina Pedernera
Subdirector de Experiencia de Usuario y Adopción de Duoc UC
Coordinador del Centro de Innovación y Transferencia Tecnológica de la sede Viña del Mar de Duoc UC.
Docente Investigador, Centro Tecnológico (CeT) de Escuela de Informática y Telecomunicaciones de Duoc UC. 298
Ximena Sibils Ramos. Directora General de Servicios Digitales de Duoc UC. 303
Observatorio Duoc UC / Anuario 2024 / página 9
Observatorio de la Educación Superior Técnico Profesional - Producción y gestión del conocimiento
Título Autor
Más Mujeres en Ciberseguridad
Mes de la ciberseguridad en Duoc UC
Transformando el Aprendizaje Digital: Mi Experiencia en Blackboard Academy y su impacto en mi rol como docente y asesor UAP
Transformación digital y educación: novedades del nuevo CAPE de redes y telecomunicaciones para el 2025
Visita inmersiva a un referente en Latinoamérica, el Tecnológico de Monterrey
Alejandra Acuña Villalobos
Óscar Araya Tagle
Luis Acosta Romero.
Óscar Araya Tagle
José Ignacio Muñoz Faundez
Directora de la Escuela de Informática y Telecomunicaciones de Duoc UC.
Subdirector de la Escuela de Informática y Telecomunicaciones de Duoc UC.
307
309
Asesor en Tecnología Educativa de la sede Viña del Mar de Duoc UC. 313
Subdirector de la Escuela de Informática y Telecomunicaciones de Duoc UC. 315
Cientista de Datos y Análisis BI. Dirección de Estudios y Progresión Estudiantil. 317
Observatorio Duoc UC / Anuario 2024 / página 10
Observatorio de la Educación Superior Técnico Profesional - Producción y gestión del conocimiento
Prólogo
Observatorio Duoc UC / Anuario 2024 / página 11
Observatorio de la Educación Superior Técnico Profesional - Producción y gestión del conocimiento
El Anuario del Observatorio Duoc UC 2024 se levanta como un testimonio riguroso y reflexivo del quehacer institucional, documentando un año marcado por la excelencia consolidada, la profunda transformación digital y el compromiso inquebrantable con la formación integral de personas para una sociedad mejor. Este volumen no solo celebra los hitos alcanzados en la trayectoria de Duoc UC, una institución con más de 56 años de vida, sino que también aborda los desafíos urgentes que impone el dinámico contexto del siglo XXI, caracterizado por las revoluciones tecnológicas 4.0 y 5.0.
Los contenidos del Anuario se articulan en torno a ejes temáticos fundamentales que definen la identidad y la estrategia de Duoc UC, desde su legado histórico y su identidad católica, hasta su liderazgo en la Educación Superior Técnico Profesional (ESTP), la innovación y la gestión de la calidad. A continuación, se sintetizan los aspectos esenciales y los principales ejes temáticos presentados durante el 2024 en la web del Observatorio.
I. Historia, trayectoria institucional y la consolidación del modelo formativo
La historia de Duoc UC, iniciada en 1968 bajo el alero de la Pontificia Universidad Católica de Chile (PUC), es un relato de crecimiento y adaptación constante. En 2024, la institución celebra su legado de excelencia y compromiso, reafirmando su identidad técnico-profesional. Un hito crucial fue la adopción del modelo formativo basado en competencias a partir de 2002, influenciado por referentes internacionales como la red TAFE de Australia. Este modelo se distingue por su énfasis en la intervención efectiva en la realidad mediante técnicas, habilidades y actitudes, buscando resolver problemas concretos en el ámbito productivo y de servicios. La pertinencia laboral de las carreras y la alta empleabilidad de los egresados son metas centrales de este enfoque.
La trayectoria reciente, especialmente la marcada por el Plan de Desarrollo 2021-2025, subraya siete desafíos clave, incluyendo la innovación y digitalización, la modernización académica, la capacitación permanente de docentes, y la formación humana y ética. La institución, que cuenta con más de 108.000 estudiantes en 19 sedes, continúa su expansión territorial y la consolidación de modelos innovadores, como el modelo dual implementado en los Campus Arauco y Nacimiento, en alianza con empresas como Arauco y CMPC, que integra el aprendizaje en el aula con la experiencia práctica en el lugar de trabajo.
II. Acreditación y el aseguramiento de la calidad
El 2024 fue un año histórico con la obtención de la máxima acreditación institucional por 7 años por parte de la Comisión Nacional de Acreditación (CNA), lograda por tercer período consecutivo. Este logro es un reflejo de 21 años de liderazgo nacional y dedicación incansable a la excelencia académica. La acreditación máxima es una garantía pública de que Duoc UC es una institución madura, con capacidad de autorregulación, que reconoce sus brechas y posee un proyecto claro para avanzar hacia el futuro. Un hito sin precedentes en la ESTP chilena es que Duoc UC se convirtió en la primera institución del subsistema reconocida por la CNA en la dimensión de Investigación, Creación e Innovación. Las áreas evaluadas y acreditadas incluyeron la Docencia y resultados del proceso de formación, la Gestión estratégica y recursos institucionales, el Aseguramiento interno de la calidad, la Vinculación con el medio, y, por
Observatorio Duoc UC / Anuario 2024 / página 12
Observatorio de la Educación Superior Técnico Profesional - Producción y gestión del conocimiento
supuesto, la Investigación, creación e innovación. La elaboración del Informe de Autoevaluación Institucional fue un proceso altamente participativo, involucrando a más de 30.000 miembros de la comunidad (estudiantes, titulados, docentes, administrativos y empleadores), lo que reafirma el cumplimiento de la Misión y el Modelo Educativo.
III. Formación integral, identidad católica y valores institucionales
La formación integral es un pilar fundamental en Duoc UC, aspirando a ir más allá de la instrucción técnica para educar personas plenamente. El propósito institucional de “Formar personas para una sociedad mejor” se sustenta en una sólida base ética inspirada en los valores cristianos.
La visión antropológica de Duoc UC subraya que la dignidad de la naturaleza humana se origina en el ser, no en el actuar o la productividad laboral. Se busca formar profesionales competentes que entiendan su trabajo con un sentido profundo, buscando el bien común. La institución defiende la vida desde la concepción hasta la muerte natural, lo que se reafirmó en actividades y publicaciones que abordaron dilemas como el aborto y la eutanasia.
La identidad católica se manifiesta también en la promoción de una cultura de respeto, inclusión y convivencia. Un esfuerzo notable fue el lanzamiento del Curso Digital sobre Convivencia, Inclusión y Equidad de Género, desarrollado en colaboración con Vertebral, cuyo objetivo es educar a la comunidad educativa en temáticas de respeto, dignidad humana, y prevención de acoso sexual y violencia de género.
Además, se promueve la inteligencia espiritual como dimensión crucial para el desarrollo de la persona, especialmente en la sociedad del cansancio. La fe y la formación técnica no son ámbitos contrapuestos, sino partes complementarias, ofreciendo espacios para conocer a Jesucristo y su mensaje trascendente. La formación se enriquece con iniciativas que integran ética y cultura, como conciertos o muestras de artesanía, que fomentan la sensibilidad y el autoconocimiento en los estudiantes.
IV. Investigación Aplicada, Innovación y Transferencia Tecnológica (I+D+i+TT)
El eje de I+D+i+TT se ha consolidado como un motor de desarrollo, buscando contribuir a la sociedad mediante la resolución de problemas prácticos. La Dirección de Investigación Aplicada, Innovación y Transferencia (DIAIT) ha promovido activamente convocatorias internas y el acompañamiento a proyectos externos.
Los resultados se evidencian en numerosos proyectos emblemáticos que abarcan diversas áreas disciplinarias:
Sustentabilidad y Recursos Naturales: Proyectos como el desarrollo de Bioantagonistas para el Control de Hongos en Cerezos, el Bioestimulante para la producción de setas basado en algas nativas, la Vivienda CLT-R para abordar el déficit habitacional con paneles de madera reforzados, y Maquiplast, que busca soluciones para el reciclaje de plásticos en materiales de construcción en el Biobío.
Observatorio Duoc UC / Anuario 2024 / página 13
Observatorio de la Educación Superior Técnico Profesional - Producción y gestión del conocimiento
Salud y Tecnología: Destacan ELEAM@TIC, que utiliza tecnología sensorial (wearables) para la detección temprana de caídas en adultos mayores, y Proyecto Cron app, una aplicación móvil para el seguimiento de pacientes con enfermedades crónicas como diabetes e hipertensión.
Innovación Académica y Colaboración Internacional: Se promovió la metodología COIL (Collaborative Online International Learning), como el proyecto COIL 2024-02 entre estudiantes de Informática y Telecomunicaciones de Duoc UC y Medicina del Tecnológico de Monterrey, centrado en soluciones para la prevención de enfermedades crónicas.
Internamente, Duoc UC impulsa la innovación corporativa, reflejada en encuentros como Converge iCorp 24. Este esfuerzo ha logrado la digitalización de más de 92 tareas operativas, el ahorro de 747 horas en reprocesos y la reducción de más de 90 mil hojas impresas. La transferencia de conocimiento generado por I+D+i+TT es clave para enriquecer la docencia y fortalecer la vinculación con la industria y la sociedad.
V. La Educación Superior Técnico Profesional (ESTP) en el contexto actual
La ESTP se posiciona como un pilar estratégico para el futuro de Chile. Ante el dinamismo de la era digital y la automatización, la ETP enfrenta la necesidad de transformarse del tradicional aprender haciendo al aprender a innovar. Esto implica priorizar la integración de competencias digitales avanzadas y fomentar una cultura de innovación.
El mercado laboral demanda no solo conocimientos técnicos, sino también competencias y capacidades transversales, como la resolución de problemas, la adaptabilidad, el trabajo en equipo, la comunicación efectiva, y un enfoque ético. Duoc UC ha incorporado el enfoque de capacidades (basado en Amartya Sen y Martha Nussbaum) para asegurar que los estudiantes tengan las libertades y oportunidades para prosperar integralmente. En términos de resultados, los titulados de Duoc UC exhiben una alta empleabilidad (82.1% al primer año). Sin embargo, la institución se enfoca en desafíos como la actualización constante de las carreras, la mejora de la progresión y titulación oportuna, y la capacitación permanente de los docentes para mantener sus conocimientos al día con la vanguardia tecnológica.
VI. Gestión Institucional, procesos y vinculación con el medio (VcM)
La gestión institucional está orientada a la agilidad y mejora continua de los procesos. Se busca una organización más dinámica y eficiente, centrada en la experiencia de los estudiantes y colaboradores. Iniciativas como el uso del dato para la toma de decisiones estratégicas, a través de la Dirección de Gobierno de Datos y Análisis Institucional, son cruciales para decidir con convicción y actuar con agilidad. La Vinculación con el Medio (VcM) es una función misional que data desde los orígenes de la institución en 1968. En 2023, las iniciativas registradas de VcM se duplicaron, alcanzando los 1.300 casos. La VcM se realiza a través de proyectos de innovación social (ej. Quillota Respira, Operación Renta), alianzas estratégicas (Campus Arauco/Nacimiento), y una vasta cantidad de actividades de extensión (961 actividades, 75.000 personas participantes). La VcM busca la bidireccionalidad, conectándose al territorio para responder a las necesidades reales de la sociedad, alineándose con el desarrollo sostenible.
Observatorio Duoc UC / Anuario 2024 / página 14
Observatorio de la Educación Superior Técnico Profesional - Producción y gestión del conocimiento
VII. Transformación digital y tecnologías educativas
La transformación digital es un imperativo para Duoc UC, no solo en la gestión, sino también en el proceso de enseñanza y aprendizaje. La institución está abordando la irrupción de la Inteligencia Artificial (IA) como una oportunidad y un desafío ético. Se reconoce que la IA actuará como un “asistente invisible” en el ámbito profesional, obligando a los técnicos a enfocarse en la creatividad, el juicio crítico y las habilidades interpersonales. Es fundamental alfabetizar en IA a docentes y estudiantes, promoviendo un uso ético y responsable.
Duoc UC ha implementado tecnologías educativas disruptivas para mejorar la experiencia y el aprendizaje:
C1DO1: Una plataforma y metodología implementada en más de 21 asignaturas, impactando a más de 20.000 estudiantes, que permite la adquisición de habilidades prácticas mediante retroalimentación oportuna, específica y personalizada a través de videos.
Docente Holograma: Un proyecto pionero en Sudamérica lanzado en la sede San Andrés de Concepción, que proyecta a profesores expertos en tiempo real, rompiendo barreras demográficas y mejorando la interacción y motivación estudiantil.
Realidad Extendida (XR) y Metaverso: Exploración de tecnologías como Realidad Virtual (VR), Realidad Aumentada (RA) y Realidad Mixta (RM) en laboratorios (LIDETI) para crear experiencias de aprendizaje inmersivas y seguras, aplicando estas tecnologías en proyectos como EmotionLab y SportMind VR.
Además, se ha puesto un fuerte énfasis en la Ciberseguridad, un desafío creciente en la era digital. La institución ha lanzado la Comunidad de CiberVoluntarios y ha realizado campañas de concientización y simulaciones de phishing que han reducido el porcentaje de personas que caen en estos intentos del 20% al 4%. También se han desarrollado líneas de especialización en ciberseguridad para las carreras de la Escuela de Informática y Telecomunicaciones, respondiendo a la alta demanda de profesionales en Chile.
El Anuario 2024 de Duoc UC demuestra que la institución no solo se adapta a la vertiginosa aceleración tecnológica y cultural, sino que la impulsa y la encauza con un sentido de misión claro: ser un referente en la Educación Técnico Profesional que combina la excelencia técnica, la innovación práctica y una sólida base ética. La constante búsqueda de la excelencia, refrendada por la máxima acreditación, el fomento de la investigación aplicada y la integración de tecnologías avanzadas, preparan a Duoc UC para seguir siendo un motor de movilidad social y un actor clave en el desarrollo integral de Chile, siempre fiel a su identidad católica y a su propósito de formar personas para un mundo mejor. El camino es de aprendizaje continuo y colaboración, donde cada avance y cada reflexión, como las contenidas en este Anuario, sirven de guía para afrontar los horizontes de un futuro cada vez más complejo y dinámico.
Observatorio Duoc UC.
Observatorio Duoc UC / Anuario 2024 / página 15
Observatorio de la Educación Superior Técnico Profesional - Producción y gestión del conocimiento
PARTE I: EDITORIALES
Observatorio Duoc UC / Anuario 2024 / página 16
Observatorio de la Educación Superior Técnico Profesional - Producción y gestión del conocimiento
Historia y trayectoria
institucional de Duoc UC
Observatorio Duoc UC / Anuario 2024 / página 17
Observatorio de la Educación Superior Técnico Profesional - Producción y gestión del conocimiento
Avances y transformaciones de
Duoc UC en su identidad y expansión territorial (1985-1998)
Durante el período comprendido entre 1985 y 1998, Duoc UC experimentó un significativo avance en su identidad técnico-profesional y en la diversificación de su oferta académica, lo que marcó un hito en su desarrollo institucional. Este período estuvo caracterizado por una serie de transformaciones y mejoras que contribuyeron al fortalecimiento de la institución como referente en la formación técnica y profesional en Chile.
Un aspecto clave para el progreso de Duoc UC durante este período fue el papel desempeñado por destacadas figuras como Juan de Dios Vial Correa, quien, en su calidad de rector de la Universidad Católica, respaldó la autonomía institucional de Duoc UC y le proporcionó una identidad intelectual distintiva. Asimismo, el liderazgo de directivos con experiencia en gestión operacional, marketing y un firme compromiso con la excelencia académica, como Rodrigo Alarcón Jara, Aníbal Vial Echeverría y Jaime Alcalde Costadoat, fue fundamental para orientar el rumbo de la institución hacia la calidad y la excelencia educativa.
En 1987, se llevó a cabo una importante modificación en los estatutos de Duoc UC, lo que resultó en una mayor autonomía académica y administrativa para la institución. La creación de la figura de los consejeros, integrando a las principales autoridades de Duoc UC, permitió un equilibrio entre la gestión académica y la financiera, lo que posibilitó una eficiente administración de los recursos y una optimización de la calidad educativa. Esta autonomía de gestión permitió a Duoc UC contratar a nuevos profesionales más alineados con la visión de excelencia académica y profesional de la institución.
En el ámbito académico, se realizó una importante inversión en equipamiento modernizado para la gestión y el desarrollo de las carreras, lo que contribuyó significativamente a elevar el estándar de la oferta académica de Duoc UC. Además, se incorporó la formación ética y antropológica en los programas de estudio, siguiendo los lineamientos de la Ex Corde Ecclesiae del Papa Juan Pablo II, lo que enriqueció la formación integral de los estudiantes y reafirmó el compromiso de la institución con los valores éticos y morales.
En 1990, el panorama educativo chileno experimentó un cambio trascendental con la promulgación de la Ley Orgánica Constitucional de Enseñanza (LOCE), que permitió el lucro en la educación. Aunque Duoc UC, como fundación, no se vio directamente afectada por esta disposición, debió acreditarse ante el Consejo Superior de Educación para asegurar su autonomía definitiva. Esta acreditación se materializó el 14 de diciembre de 1995, cuando el Ministerio de Educación otorgó a Duoc UC la autonomía para entregar títulos técnicos y profesionales, lo que representó un importante reconocimiento a la calidad y excelencia de la institución.
Observatorio Duoc UC / Anuario 2024 / página 18
Observatorio de la Educación Superior Técnico Profesional - Producción y gestión del conocimiento
En el mismo año, Duoc UC inició su incursión en la educación media con la creación del Liceo Politécnico Andes, ampliando así su alcance y contribuyendo a la formación integral de los estudiantes desde una etapa temprana. Además, la institución experimentó un crecimiento territorial significativo con la apertura de nuevas sedes en distintas regiones del país, como Antonio Varas (1990), Concepción (1992), Viña del Mar (1993) y San Carlos de Apoquindo (1997), lo que permitió a Duoc UC llegar a un mayor número de estudiantes y expandir su impacto en la sociedad.
El período de 1985-1998 fue testigo de un notable desarrollo institucional y académico de Duoc UC, impulsado por el compromiso de sus autoridades y directivos, la obtención de mayores niveles de autonomía, la inversión en equipamiento modernizado y la expansión territorial. Estos avances permitieron a la institución consolidarse como un referente en la formación técnico-profesional en Chile, ofreciendo una oferta académica de calidad y formando a profesionales altamente capacitados para enfrentar los desafíos del mundo laboral del siglo XXI.
29 de abril de 2024
Equipo Editorial del Observatorio Duoc UC
Observatorio Duoc UC / Anuario 2024 / página 19
Observatorio de la Educación Superior Técnico Profesional - Producción y gestión del conocimiento
Duoc UC: Cimientos
y modernización entre 1968-1985
El primer período de la historia de DUOC, desde su fundación en 1968 hasta 1973, se caracterizó por ser una etapa de gestación y consolidación, en la que la institución estableció los pilares fundamentales de su misión y estructura administrativa. Este período estuvo enmarcado en un contexto histórico particular, marcado por la reforma universitaria, el impulso a la educación de adultos promovida por organismos internacionales como la Unesco, y a los cambios impulsados por el Concilio Vaticano II.
La visión inicial de DUOC era ofrecer una educación técnica imbuida de los valores católicos y éticos, con el propósito de contribuir a la construcción de una sociedad más justa y solidaria. La institución comenzó su labor con programas de recuperación para la educación básica y media, para luego expandirse hacia cursos de oficios y subtécnicos en diversas áreas tales como construcción civil, agronomía, medicina, arte y estética, sectores que necesitaban el acompañamiento de técnicos con más conocimientos específicos que apoyaran y complementaran a los profesionales egresados de estas carreras universitarias.
El crecimiento de DUOC durante este período fue vertiginoso, pasando de tener 400 estudiantes en 1969 a casi 53.000 en 1973, con más de 90 sedes[1] a lo largo del país. Sin embargo, esta rápida expansión también trajo consigo desafíos, como la falta de una estructura organizativa sólida y la dificultad para mantener un financiamiento estable.
A pesar de las dificultades iniciales, el primer período de DUOC estuvo marcado por el dinamismo y la creatividad de sus fundadores, quienes enfrentaron con determinación los retos de establecer una nueva institución educativa en un contexto de cambios sociales y políticos. La visión de DUOC como una institución técnico-profesional con una impronta católica, atrajo el interés y el apoyo de la Universidad Católica y la Iglesia, quienes reconocieron la importancia de ofrecer una educación integral que combinara la formación técnica con los valores éticos y morales.
La creación de la Fundación DUOC en 1974 representó un hito crucial en la historia de la institución, ya que otorgó a DUOC una mayor autonomía y capacidad de gestión. Esto permitió una toma de decisiones más ágil y eficiente, así como una mayor flexibilidad para adaptarse a las necesidades cambiantes del entorno educativo y social. Además, la fundación proporcionó un marco institucional sólido que facilitó el desarrollo y la expansión de DUOC en los años siguientes.
El segundo período, que se extendió desde 1974 hasta 1985, estuvo marcado por una reacción y modernización institucional que permitió a DUOC consolidarse como una institución líder en la formación técnico-profesional en Chile. La creación del primer Consejo de la Fundación DUOC representó un paso importante hacia la profesionalización de la institución, al reunir a destacados académicos y profesiona-
[1] No debemos entender las sedes como lo son hoy, sino solo como espacios facilitados por colegios católicos y algunos ministerios, que los prestaron para utilizar su infraestructura en horario vespertino.
Observatorio Duoc UC / Anuario 2024 / página 20
Observatorio de la Educación Superior Técnico Profesional - Producción y gestión del conocimiento
les para guiar su desarrollo y toma de decisiones estratégicas. Además, la modernización de la estructura administrativa de DUOC contribuyó a mejorar la eficiencia y la calidad de sus servicios educativos, garantizando una gestión más efectiva de los recursos y una mayor satisfacción de los estudiantes.
El reconocimiento estatal de los cursos subtécnicos de DUOC en 1976 fue un logro significativo que validó la calidad y pertinencia de la formación técnico-profesional impartida por la institución. Este reconocimiento no solo consolidó la posición de DUOC en el ámbito educativo nacional, sino que también abrió nuevas oportunidades de desarrollo y crecimiento para la institución. A pesar de los desafíos económicos y legislativos que enfrentó, DUOC logró adaptarse con éxito a las nuevas exigencias del entorno y consolidarse como una institución de referencia en la formación técnico-profesional en Chile.
El liderazgo del Rector Hernán Holley Merino (1980-1985) fue fundamental en este proceso de modernización y adaptación. Su experiencia empresarial y su visión estratégica permitieron a DUOC enfrentar los desafíos de la época y consolidar su posición en el ámbito educativo nacional.
Podemos concluir entonces, que entre los años 1968 a 1985 de DUOC fue un período de definición de su misión y un crecimiento sorprendente en sus números de matriculados, seguido por una etapa de modernización y consolidación. Estos períodos sentaron las bases para el desarrollo futuro de la institución como un referente en la formación técnico-profesional católica en Chile.
22 de abril de 2024
Equipo Editorial del Observatorio Duoc UC
Observatorio Duoc UC / Anuario 2024 / página 21
Observatorio de la Educación Superior Técnico Profesional - Producción y gestión del conocimiento
Duoc UC: Un legado de
excelencia y compromiso desde 1968 hasta 2024
Desde su fundación el 16 de noviembre de 1968, Duoc UC ha forjado una trayectoria marcada por hitos significativos que reflejan nuestro compromiso con la Educación Técnico Profesional en Chile. A lo largo de más de cinco décadas, hemos enfrentado desafíos, adaptándonos a los cambios y consolidando nuestra posición como una institución de excelencia. Hoy, mirando hacia el futuro, celebramos con orgullo nuestro legado y renovamos nuestra visión de seguir contribuyendo al desarrollo del país.
El primer gran paso fue la creación de la Fundación DUOC, establecida para dotar a la institución de una estructura organizativa sólida y personalidad jurídica. Con la ratificación de nuestros estatutos el 28 de diciembre de 1973 y el reconocimiento del Ministerio de Justicia el 30 de octubre de 1974, obtuvimos autonomía de gestión y una estructura de gobierno moderna, respaldada por las principales autoridades de la Universidad Católica. Este Consejo se enfocó en programar y realizar labores educacionales destinadas a la formación técnica y la integración social y cívica de los adultos.
En 1976, alcanzamos un logro histórico con el reconocimiento estatal de nuestros cursos subtécnicos. Mediante el Decreto N°205 del Mineduc, se aceptaron nuestros planes y programas de estudios de nivel mando medio en 35 carreras técnicas y subtécnicas. Duoc UC se convirtió así en la primera institución privada en ser reconocida oficialmente, anticipándose al Decreto con Fuerza de Ley N°24 de 1981 que creó los Centros de Formación Técnica como parte de la educación superior.
La crisis económica de 1982 representó uno de los desafíos más significativos en nuestra historia. Frente a la disminución de matrícula y el aumento de la deuda, implementamos medidas estratégicas, concentrando nuestra actividad académica en Santiago, Concepción y Valparaíso, y enfocándonos en áreas clave como administración, finanzas, marketing, informática, contabilidad, turismo, diseño arquitectónico y publicidad. Esta experiencia nos fortaleció y nos preparó para futuros desafíos, manteniendo siempre el foco en la calidad educativa.
Con la nueva Legislación de Educación Superior en 1981, establecida en el DFL N°5 del 5 de febrero de 1981 y el DFL N°24 del 7 de abril de 1981, trabajamos intensamente para adaptarnos y cumplir con las exigencias establecidas. Esto nos permitió ser considerados como una institución de educación superior, ofreciendo carreras que otorgaban títulos profesionales y técnicos conforme a los nuevos marcos legales.
En 1990, ampliamos nuestro compromiso con la educación al fundar el Liceo Politécnico Andes en la comuna de Renca, iniciativa que nos ha brindado innumerables satisfacciones por su destacado desempeño. El 14 de diciembre de 1995, alcanzamos la tan anhelada autonomía definitiva, otorgada por el Mineduc a través de la Resolución exenta N°7.169. Este hito nos permitió crear carreras con libertad y desplegar toda nuestra creatividad académica, consolidando nuestra posición en el sistema educativo chileno.
El cambio de nombre DUOC a Duoc UC en 1999 marcó un momento trascendental, reafirmando nuestra vinculación institucional y orgánica con la Universidad Católica. Esta unión, que nos llena de alegría y
Observatorio Duoc UC / Anuario 2024 / página 22
Observatorio de la Educación Superior Técnico Profesional - Producción y gestión del conocimiento
orgullo, nos diferencia marcadamente y nos desafía a alcanzar los altos niveles de calidad y prestigio que la UC exhibe a nivel mundial. Juntos, hemos intensificado múltiples trabajos colaborativos, fortaleciendo nuestra misión educativa.
En el ámbito académico, 2002 fue un año de transformación al adoptar el modelo formativo basado en competencias de influencia australiana. Esta renovación curricular significó una evolución radical en nuestros planes de estudio y perfiles de egreso, alineándonos con las demandas del mercado laboral y las necesidades de nuestros estudiantes.
Los éxitos en nuestras acreditaciones de calidad reflejan nuestro compromiso continuo con la excelencia. Nos acreditamos por seis años en gestión institucional y docencia de pregrado con la CNAP en 2004, y posteriormente obtuvimos siete años con la Comisión Nacional de Acreditación (CNA) en 2010, 2017 y 2024, consolidando nuestra reputación como institución líder en la Educación Superior Técnico Profesional.
La pandemia de COVID-19 representó un desafío sin precedentes. Sin embargo, toda la comunidad de Duoc UC se unió con determinación para continuar cumpliendo nuestra misión. Este período, aunque doloroso, nos dejó valiosas lecciones sobre resiliencia y trabajo en equipo, demostrando que unidos podemos superar cualquier adversidad en pos de formar personas para una sociedad mejor.
La alianza con Empresas Arauco y CMPC es otro hito que ha enriquecido nuestra propuesta educativa. Las sedes de Arauco y Nacimiento materializan nuestro modelo dual, integrando el aprendizaje en el aula con la experiencia práctica en el lugar de trabajo. Este enfoque ha fortalecido la conexión entre teoría y práctica, y es un ejemplo para el país de cómo la colaboración entre empresas e instituciones educativas puede mejorar la formación y empleabilidad de los jóvenes chilenos.
La construcción del Plan de Desarrollo 2021-2025 es nuestra hoja de ruta actual. Resultado de una reflexión colectiva y de un proceso participativo que involucró a docentes, administrativos/as, alumnos/as, titulados/as y otros actores clave, este plan enmarca nuestro trabajo hacia el logro de objetivos y metas compartidas.
Mirando hacia el futuro, identificamos siete desafíos que guiarán nuestro camino:
1. Innovación y digitalización: Incorporar tecnologías digitales en nuestros procesos educativos y administrativos para mejorar la eficiencia y calidad de la educación, alineándonos con las revoluciones 4.0 y 5.0.
2. Vinculación con la comunidad y el sector empresarial: Fortalecer los lazos con nuestro entorno, anticipándonos a sus necesidades y sirviendo como una institución abierta y comprometida con el desarrollo social y económico.
3. Descentralización de procesos: Potenciar el espíritu de comunidad y el talento único de cada colaborador, promoviendo una colaboración horizontal que refleje el esfuerzo colectivo en nuestros logros.
Observatorio Duoc UC / Anuario 2024 / página 23
Observatorio de la Educación Superior Técnico Profesional - Producción y gestión del conocimiento
4. Modernización académica: Actualizar y renovar nuestras carreras para enfrentar con éxito los cambios tecnológicos y las demandas de nuevos perfiles de egreso, manteniendo la relevancia y pertinencia de nuestros programas de estudio.
5. Capacitación permanente de docentes: Apoyar continuamente a nuestros educadores en el qué y el cómo enseñan, fortaleciendo sus conocimientos y conexión con el mundo laboral.
6. Formación humana y ética: Reafirmar nuestra identidad católica, promoviendo valores como la libertad, solidaridad, colaboración y dignidad, para formar personas dispuestas a servir a otros con excelencia y humildad.
7. Inspiración del Papa Francisco: Seguir el llamado a educar con una mirada amplia y formar “poetas sociales” y “coreógrafos sociales”, personas capaces de imaginar lo inédito y contribuir a la danza colectiva donde nadie es excluido. Asimismo, sentirnos orgullosos de nuestra identidad católica y de contar con el apoyo permanente de San José.
Estos desafíos, simultáneos y complementarios, reflejan nuestra convicción de que somos más que presente: somos pasado y futuro. Nos impulsa el deseo de servir a Chile en cada momento histórico, siendo fieles a nuestra misión y visión educativa. Estamos abriendo caminos que no se detienen, expandiendo nuestra influencia y compromiso.
En Duoc UC, miramos hacia adelante con optimismo y determinación, orgullosos de nuestro legado y conscientes de nuestra responsabilidad en la formación de las futuras generaciones. Renovamos nuestro compromiso de ofrecer una educación de excelencia, adaptada a los tiempos y necesidades de nuestra sociedad, contribuyendo al progreso y bienestar de todos.
El miércoles 13 de noviembre nos juntaremos a expresar con alegría y orgullo: ¡Feliz cumpleaños N°56 Duoc UC!
11 de noviembre de 2024
Equipo Editorial del Observatorio Duoc UC
Observatorio Duoc UC / Anuario 2024 / página 24
Observatorio de la Educación Superior Técnico Profesional - Producción y gestión del conocimiento
El nacimiento y evolución del modelo
formativo basado en competencias en Duoc UC entre 1998-2013
Duoc UC nace en 1968 con el nombre de Departamento Universitario Obrero Campesino (DUOC), bajo el alero de la Pontificia Universidad Católica de Chile (PUC). Este hito fundacional surge como una respuesta concreta a la necesidad de extender la labor universitaria hacia sectores campesinos y obreros que, habitualmente, no disponían de oportunidades de acceder a la educación superior. Con la participación de estudiantes universitarios, docentes y sindicatos, DUOC comenzó a impartir capacitación técnica a personas que aspiraban a mejorar sus condiciones de vida y sus perspectivas laborales.
Con el tiempo, y viendo el rápido crecimiento de esta iniciativa, la Pontificia Universidad Católica decidió otorgarle mayor autonomía, entregándole una estructura jurídica y de gestión que le permitiera a Duoc UC sostenerse con eficacia, motivos suficientes para crear la Fundación DUOC y ser aprobada por el Ministerio de Justicia en 1974. Este cambio institucional consolidó su razón de ser, siempre en coherencia con la vocación de servicio y el horizonte evangelizador de la Iglesia.
La relación con la Pontificia Universidad Católica no fue solo un respaldo formal, sino la fuente de un sello educativo distintivo. Duoc UC orientó sus esfuerzos a la formación integral de sus estudiantes, comprendiendo que la técnica y la ética pueden y deben convivir. Así, la Educación Superior Técnico Profesional que ofrece, a inicios del siglo XXI, se sustenta no únicamente en los conocimientos técnicos científicos o humanistas, sino también en una preparación práctica que forma profesionales competentes, con un fuerte sentido de la responsabilidad social.
El desafío de una formación Técnico Profesional
La Educación Superior Técnico Profesional se distingue de la formación universitaria tradicional porque pone énfasis en la intervención efectiva en la realidad, a través de técnicas, habilidades y actitudes. Para Duoc UC no bastaba con la comprensión teórica de los fenómenos del entorno: se requería la capacidad de resolver problemas concretos y tangibles en el ámbito productivo y de servicios, integrando la práctica con un sello ético y de trascendencia.
El hito del cumpleaños N°30 de Duoc UC y la pregunta sobre cuál debía ser el modelo
Uno de los acontecimientos que marcó la evolución institucional futura, fue un discurso pronunciado por el Rector de la Pontificia Universidad Católica de Chile, Juan de Dios Vial Correa, el 30 de octubre de 1998. En su discurso, Vial dejó instalada en Duoc UC la idea de que la principal contribución al país y a la educación que la institución podía hacer era la de convertirse en un modelo de lo que debía ser la formación técnica.
A partir de esta aseveración, Vial se planteó una gran interrogante y que fue escuchada por los directivos de Duoc UC: ¿Cómo convertirse en un referente nacional de la formación técnica, sin caer en ser otra
Observatorio Duoc UC / Anuario 2024 / página 25
Observatorio de la Educación Superior Técnico Profesional - Producción y gestión del conocimiento
universidad o en transformarse en una institución de segunda categoría, pero conservando, a la vez, el mismo sello de calidad y trascendencia que la PUC? Esta reflexión iluminó las decisiones académicas futuras y la búsqueda de nuevas rutas formativas para Duoc UC[1].
La búsqueda de referentes y la inspiración australiana
En la tarea de dar respuesta a esa pregunta, Duoc UC emprendió una búsqueda de experiencias tanto nacionales como internacionales. A escala global, la institución se interesó por la trayectoria de la educación vocacional en Australia, particularmente en la red de centros TAFE (Technical and Further Education), que se había convertido en referente mundial por su énfasis en la formación práctica y la sólida articulación con la industria.
El modelo TAFE ilustraba cómo se podía diseñar un currículo basado en competencias laborales claramente definidas y validar los aprendizajes de los estudiantes de manera coherente con las exigencias del mercado. Este referente internacional reforzó la idea de que la ruta correcta para Duoc UC pasaba por adoptar un enfoque por competencias que uniera teoría y práctica, garantizando resultados tangibles y una alta empleabilidad de sus egresados.
El impulso nacional de Chile
Califica
y la definición de la identidad
Paralelamente al estudio de referentes internacionales, en Chile se dieron algunos intentos por impulsar la formación por competencias. El primer impulso a nivel nacional para incorporar modelos basados en competencias fue a través del Programa Chile Califica (2002), iniciativa conjunta de los ministerios de Economía, Educación y Trabajo, financiada al 50% por el Estado y al 50% por un préstamo del Banco Mundial, alcanzando los US$150.000.000. Este programa tuvo una duración de seis años y, pese a su pertinente diagnóstico sobre la necesidad de mejorar la equidad, la competitividad y la empleabilidad, no logró generar el impacto esperado.
En este escenario, Duoc UC, por instrucciones de su Rector Marcelo Von Chrismar, ya había decidido encaminar su proyecto educativo hacia la formación por competencias de manera independiente. La institución había identificado dos posibles vías para la educación superior:
Una orientación formativa hacia las ciencias, con un perfil profesional definido por una “comunidad académica” experta en la disciplina (propio de las universidades).
Una orientación técnica, con un perfil basado en el conocimiento práctico y el quehacer propio del trabajo, pero que exigía la definición de un perfil de desempeño ajustado a estándares sectoriales o nacionales (aún no claros ni sistematizados en ese tiempo en Chile).
La conducción de Duoc UC hacia la segunda vía —el modelo de competencia para el trabajo— se sustentaba en la convicción de que requería una metodología singular, distinta de la formación de base científica. Surgían así tres problemas que la institución quería enfrentar el 2002, en opinión de su Vicerrector
[1] https://observatorio.duoc.cl/archivo_historico/discurso-juan-de-dios-vial-correa-30-anos-duoc-uc/
Observatorio Duoc UC / Anuario 2024 / página 26
Observatorio de la Educación Superior Técnico Profesional - Producción y gestión del conocimiento
Académico Juan Cristóbal Silva Labbé:
- Diferenciarse en un sistema de educación superior heterogéneo y diversificado.
- Superar la concepción elitista de la educación superior.
- Romper con la primacía del modelo académico tradicional como única opción formativa[2].
En un documento de trabajo de la época se resaltaba que por su “singularidad funcional”, Duoc UC requería diseñar o adoptar una metodología de evaluación y de planes de estudio basados en competencias laborales, en sintonía con estándares internacionales de formación para el trabajo. Se expresaba además que la “sintonía con las tendencias imperantes en los procesos de certificación de calidad de la industria” facilitaría la asociación entre la misión institucional y la necesidad de aumentar la competitividad de las empresas, haciendo énfasis en la productividad de la mano de obra.
La instalación del modelo de formación por competencias en Duoc UC
Bajo estas premisas, Duoc UC, a fines de los años noventa y comienzos de los 2000, consolidó un sistema de desarrollo curricular que integraba el concepto de competencias. Entre las medidas concretas aplicadas, destacaron:
Creación de las escuelas (1999): Unidades que coordinarán académicamente carreras y programas afines, y que liderarán el diseño y la actualización de los planes de estudio.
Definición de la misión y valores institucionales: Reafirmando su foco en la Formación Técnico Profesional, con sólidas bases éticas y el sello cristiano[3]. La misión ahora será “La formación de personas en el área Técnico Profesional con una sólida base ética, capaces de actuar con éxito en el mundo laboral y comprometidas con el desarrollo del país” (19982011).
Sistema estructurado de desarrollo curricular: Aplicado hasta el 2013, permitió la identificación de competencias, el diseño de asignaturas y la evaluación de los resultados de aprendizaje.
Proceso CAPE (desde 2014): La Creación y Actualización de Planes de Estudio, que vino a refinar y modernizar los mecanismos de análisis de pertinencia, diseño curricular y validación de competencias con el entorno productivo.
[2] Presentación del Vicerrector Académico Juan Cristóbal Silva a los directivos de Duoc UC en la Convención de Marbella, 2002.
[3] En 1998 el Consejo Directivo aprueba el nuevo concepto de misión de Duoc UC. Marcelo Von Chrismar, Rector entre los años 1998 y 2010, la presentó a los directivos y la comunidad en reunión realizada en el Hotel Reñaca Conference Town el mismo año.
Observatorio Duoc UC / Anuario 2024 / página 27
Observatorio de la Educación Superior Técnico Profesional - Producción y gestión del conocimiento

Sistema estructurado de desarrollo curricular de Duoc UC. Fue la matriz hasta el 2013.
Para sistematizar este trabajo, el Vicerrector Académico de Duoc UC Juan Cristóbal Silva, creó y desarrolló un esquema, empleado hasta 2013, que ordenaba la tarea de levantar las competencias requeridas por el mercado laboral, traducirlas en perfiles de egreso y articularlas curricularmente. A partir de 2014, este esquema fue modificado y actualizado con el levantamiento del proceso CAPE, manteniendo la lógica de estructurar la formación desde un enfoque por competencias en constante revisión.
Por tanto, La decisión de Duoc UC de asumir un modelo educativo basado en competencias respondió a una confluencia de factores: la exploración y deseo de tener de identidad distinta a la formación universitaria clásica, la necesidad de equidad y búsqueda de pertinencia laboral para sus perfiles de egreso, mejorar la movilidad social para sus estudiantes y el aprendizaje de referentes internacionales como el sistema TAFE en Australia.
Lo que se persiguió con el modelo de formación basado en competencias: 2002-2013
Adoptar un currículo por competencias no solo respondía al propósito de diferenciar a Duoc UC en un sistema de educación superior dominado por el modelo universitario tradicional. También se perseguía:
Asegurar que la pertinencia laboral de las carreras se reflejara en la inserción y trayectoria de sus egresados.
Resguardar la calidad del proceso formativo desde su propia validación interna, superando la dependencia de examinaciones institucionales externas.
Favorecer la movilidad social, gracias a carreras que se ajustan a demandas reales de la industria.
Contribuir activamente al desarrollo del país, conjugando formación práctica y principios éticos que se materializan en el desempeño profesional.
Observatorio Duoc UC / Anuario 2024 / página 28
Observatorio de la Educación Superior Técnico Profesional - Producción y gestión del conocimiento
De esta forma, la calidad dejó de medirse solo por indicadores académicos clásicos para contemplar la efectividad con que los titulados se insertaban en el mundo del trabajo, la valoración que las empresas daban a su desempeño y la cohesión entre la formación recibida y las reales necesidades productivas de Chile.
El concepto de competencia en acción
Duoc UC concibe las competencias, en estos años, como la convergencia de conocimientos, habilidades, destrezas y actitudes, observables en el desempeño que realizan los estudiantes en contextos laborales reales o simulados. De ahí se deriva una metodología de enseñanza centrada en el “aprender haciendo”, que valora el trabajo colaborativo, la resolución de problemas y la incorporación temprana de prácticas y laboratorios que preparan para la realidad productiva.
Todo esto implica, además, la definición detallada de perfiles de egreso por carrera, que establecen los resultados de aprendizaje esperados y las evidencias de logro. Este rigor metodológico le permite a Duoc UC vincular su oferta formativa con las exigencias del mercado laboral y, en última instancia, con los procesos de competitividad y productividad que dan sustento al desarrollo económico y social.
En definitiva, la experiencia de Duoc UC en estos años es la mejor prueba de que la formación técnica y profesional, alineada con los requerimientos productivos y sustentada en una sólida base ética, puede transformarse en un poderoso instrumento de movilidad social y en un motor de crecimiento. Su modelo de competencias, heredero del espíritu PUC y de la inspiración australiana, sigue perfeccionándose y proyectándose, demostrando que la Educación Superior Técnico Profesional constituye un camino de alta relevancia para el país y para quienes buscan un progreso real en sus vidas y en las comunidades que integran.
30 de diciembre de 2024
Equipo Editorial del Observatorio Duoc UC
Observatorio Duoc UC / Anuario 2024 / página 29
Observatorio de la Educación Superior Técnico Profesional - Producción y gestión del conocimiento
Expansión territorial, excelencia
académica y compromiso integral (1998-2012)
De 1998 hasta 2012, Duoc UC experimentó una notable transformación y crecimiento, marcada por cambios significativos en su estructura organizativa, su modelo académico y su imagen institucional. Este período se caracterizó por un liderazgo visionario encabezado por Marcelo Von Chrismar, quien asumió el cargo de rector en este lapso y trajo consigo una serie de innovaciones que redefinieron profundamente el rumbo de la institución.
Uno de los cambios más destacados durante este período fue la transición de la marca “DUOC” a “Duoc UC”, con el propósito de asociar la institución de manera más estrecha con la Universidad Católica y así fortalecer su prestigio y reconocimiento a nivel nacional. Este cambio no solo representó una evolución en términos de identidad institucional, sino que también reflejó una estrategia de posicionamiento en el mercado educativo chileno.
El crecimiento territorial y de la matrícula fueron aspectos notables de este período. Duoc UC experimentó una expansión significativa, tanto en el número de sedes como en la cantidad de estudiantes. Desde el año 1998 hasta 2010, la institución pasó de albergar 14.000 estudiantes a tener una matrícula de 56.000 alumnos. Esta expansión se vio reflejada en la creación de nuevas sedes en diversas ubicaciones estratégicas, como Plaza Vespucio, Plaza Oeste, Concepción, Melipilla, Puente Alto y Maipú, así como la restauración del emblemático edificio Cousiño.
Además del crecimiento cuantitativo, Duoc UC también experimentó avances significativos en términos de calidad académica y acreditación institucional. La implementación del Modelo Formativo basado en competencias, liderado por el Vicerrector Académico Cristóbal Silva Labbé, marcó un hito importante en la historia de la institución. Este enfoque innovador en la enseñanza y el aprendizaje se tradujo en una oferta académica más relevante y actualizada, en línea con las demandas del mercado laboral.
En el ámbito de la acreditación, Duoc UC obtuvo importantes reconocimientos por parte de organismos evaluadores del país. La institución logró acreditarse por seis años en gestión institucional y docencia pregrado con la CNAP en 2004, y posteriormente obtuvo siete años de acreditación con la Comisión Nacional de Acreditación CNA en 2010. Estos logros evidenciaron el compromiso de Duoc UC con la excelencia académica y la mejora continua de sus estándares de calidad.
La implementación del Crédito con Aval del Estado (CAE) en 2005 representó un importante impulso para el acceso a la educación superior en Chile. Este sistema de financiamiento favoreció a un amplio espectro de estudiantes, incluyendo aquellos de instituciones técnico-profesionales como Duoc UC. El aumento en la matrícula, impulsado en parte por la disponibilidad de financiamiento a través del CAE, contribuyó al crecimiento y la diversificación de la población estudiantil de la institución.
Observatorio Duoc UC / Anuario 2024 / página 30
Observatorio de la Educación Superior Técnico Profesional - Producción y gestión del conocimiento
Además de su enfoque en la formación técnico-profesional, Duoc UC también se comprometió con la formación integral de sus estudiantes. Se crearon nuevas Direcciones y Programas destinados a fortalecer aspectos como la formación ética, el inglés, el lenguaje, matemática, incentivar el emprendimiento estudiantil, la pastoral católica, y el apoyo estudiantil en sus diversas necesidades integrales. Estas iniciativas reflejaron el compromiso de la institución con el desarrollo de sus alumnos y alumnas, más allá de su necesaria formación académica.
En estos años Duoc UC tuvo una etapa de crecimiento y consolidación institucional, marcada por avances significativos en términos de expansión territorial, calidad académica y oferta formativa. Bajo el liderazgo de Marcelo Von Chrismar y posteriormente Jaime Alcalde, la institución logró establecerse como un referente en la Educación Técnico Profesional en Chile, preparando a sus estudiantes para enfrentar los desafíos del mundo laboral con excelencia y compromiso.
6 de mayo de 2024
Equipo Editorial del Observatorio Duoc UC
Observatorio Duoc UC / Anuario 2024 / página 31
Observatorio de la Educación Superior Técnico Profesional - Producción y gestión del conocimiento
Inspiración, innovación y
compromiso en los 56 años de Duoc UC
La conmemoración de los 56 años de Duoc UC, celebrada con solemnidad el miércoles 13 de noviembre, marca un momento clave para reflexionar sobre el pasado, el presente y el futuro de nuestra institución.
El acto de conmemoración de los 56 años de vida institucional de Duoc UC tuvo lugar en el piso 15 del edificio de la Casa Central a las 14:30 horas, extendiéndose hasta las 17:00 horas. La ceremonia comenzó con una misa solemne presidida por el Capellán General Francisco Llanca, marcando un momento de reflexión y gratitud por la trayectoria y los éxitos de la institución.
Posteriormente, se proyectaron videos que ilustraron la evolución y los hitos más significativos en la historia de Duoc UC, permitiendo a los presentes recorrer el camino que ha consolidado a esta institución a ser un referente en la Educación Técnico Profesional chilena. Acto seguido, el Rector Ignacio Sánchez Díaz tomó la palabra para reiterar las ideas fundamentales que, durante más de una década, ha compartido en sus visitas y colaboraciones con Duoc UC, ya sea para sus años académicos, cuentas anuales o el cumpleaños institucional.
El Rector Carlos Díaz Vergara, máxima autoridad de Duoc UC, continuó la ceremonia con un discurso centrado en los pilares del actual Plan de Desarrollo Institucional, destacando los logros alcanzados gracias al esfuerzo conjunto de toda la comunidad. En sus palabras, agradeció profundamente la reciente reacreditación institucional por un período de 7 años, la más alta distinción que Duoc UC ha obtenido por tercera vez consecutiva, reafirmando su excelencia y liderazgo en Chile.
Uno de los momentos más emotivos de la jornada fue el anuncio del homenaje al Rector Ignacio Sánchez Díaz, en reconocimiento a sus 14 años de apoyo incondicional a Duoc UC. A lo largo de este período, Sánchez no solo aportó con su liderazgo y acciones concretas, sino también con su sincero cariño hacia la institución. En este contexto, se presentó un video que reunió testimonios de diversas autoridades internas y externas, quienes valoraron su visión estratégica y su dedicación desde la Pontificia Universidad Católica, siempre respaldando el desarrollo de Duoc UC.
La ceremonia culminó con las palabras del presidente del Consejo de la Fundación Duoc UC, Patricio Donoso Ibáñez, quien destacó el esfuerzo y compromiso de toda la comunidad para mantener a la institución en un alto nivel de excelencia. Asimismo, hizo un llamado a seguir trabajando unidos, reafirmando la misión de servir al país y aportar al desarrollo integral de Chile.
Al término del acto oficial, los asistentes fueron invitados a un cóctel en el patio de la sede Antonio Varas, cerrándose la jornada en un ambiente de camaradería y celebración.
Observatorio Duoc UC / Anuario 2024 / página 32
Observatorio de la Educación Superior Técnico Profesional - Producción y gestión del conocimiento
Ideas centrales del Rector Ignacio Sánchez Díaz en sus visitas a Duoc UC: 2010-2024
En esta ocasión, queremos rendir un homenaje al legado del Rector Ignacio Sánchez Díaz, destacando las ideas y principios que, durante 14 años, ha transmitido a Duoc UC. Su visión, basada en la excelencia, la innovación, el compromiso con la comunidad y la inclusión, constituye un faro que seguirá inspirando a la institución en los años venideros.
La ocasión fue más que un aniversario: Fue un espacio para reafirmar la misión de Duoc UC como un referente en calidad educativa, innovación, inclusión y compromiso social. Las palabras y las ideas de Ignacio Sánchez, pronunciadas durante más de una década de visitas y colaboraciones, nos ofrece una hoja de ruta clara para seguir avanzando con excelencia y humanidad en la ETP.
Innovación como pilar del desarrollo educativo
Una de las ideas centrales del legado de Ignacio Sánchez ha sido el llamado a la innovación constante en la ETP. Duoc UC, según sus palabras, debe mirar más allá de sus fronteras, aprender de otras realidades y adaptarse continuamente a los cambios que exige un mundo dinámico. Este enfoque ha permitido que la institución se mantenga como un modelo de referencia, liderando desarrollos significativos en metodologías docentes, transferencia tecnológica y emprendimiento.
Sánchez destacó la necesidad de avanzar en la investigación aplicada, formando estudiantes que no solo adquieran conocimientos técnicos, sino que también se cuestionen la realidad y propongan soluciones innovadoras. Este énfasis en la flexibilidad y la creatividad ha posicionado a Duoc UC como un actor clave en la formación de profesionales preparados para enfrentar los desafíos de una sociedad en constante transformación. La incorporación de mejores prácticas, tanto en la docencia como en la gestión institucional, ha sido un factor clave en el éxito de Duoc UC. Este enfoque ha permitido que la institución lidere la agenda educativa en Chile y Latinoamérica, demostrando que la calidad y la innovación pueden ir de la mano con un compromiso profundo con la identidad y los valores católicos.
Compromiso con la calidad educativa y la capacitación
El fortalecimiento de la calidad educativa ha sido otro de los ejes fundamentales del liderazgo de Ignacio Sánchez. Bajo su visión, Duoc UC no solo ha renovado su acreditación con la máxima calificación por tercera vez consecutiva, sino que también ha elevado los estándares de enseñanza en la ETP, beneficiando a todo el sistema educativo chileno.
El rector Sánchez subrayó, en múltiples oportunidades, la importancia de identificar y desarrollar las mejores competencias para los estudiantes, asegurando que estén equipados no solo para el mercado laboral, sino también para contribuir al desarrollo del país. Este compromiso se extiende a la formación continua de los profesores, reconociendo su papel central en la calidad educativa.
Sánchez destacó además el impacto del crecimiento institucional de Duoc UC, con más de 108,000 estudiantes en 19 sedes. Este avance representa no solo un logro numérico, sino un desafío para mantener la calidad y mejorar la retención de estudiantes, asegurando que un mayor número de ellos alcance la titulación y se convierta en agentes de cambio en la sociedad.
Observatorio Duoc UC / Anuario 2024 / página 33
Observatorio de la Educación Superior Técnico Profesional - Producción y gestión del conocimiento
Identidad y misión compartida con la Universidad Católica
Desde sus inicios en 1968 como una iniciativa de estudiantes y profesores de la Pontificia Universidad Católica de Chile, Duoc UC ha mantenido un fuerte vínculo con esta institución, compartiendo su misión de servicio educativo y compromiso con la sociedad.
Ignacio Sánchez siempre enfatizó la importancia de fortalecer esta identidad UC, adaptándola a las realidades y demandas actuales del país. Este enfoque ha permitido a Duoc UC mantenerse fiel a sus principios y valores, mientras responde de manera efectiva a las necesidades de sus estudiantes y comunidades.
La colaboración entre ambas instituciones ha sido clave para desarrollar programas conjuntos de formación, proyectos de investigación aplicada y actividades de transferencia tecnológica. Este modelo de trabajo ha demostrado ser un ejemplo exitoso de cómo la educación universitaria y técnico profesional pueden complementarse para generar un impacto significativo en el país.
Compromiso social y participación activa
El compromiso con la sociedad ha sido un tema recurrente en las reflexiones de Ignacio Sánchez sobre Duoc UC. La institución ha trabajado incansablemente para establecer un diálogo bidireccional con la comunidad, participando activamente en políticas públicas y adaptándose a los debates nacionales más relevantes.
Durante la pandemia de COVID-19, este compromiso se evidenció en la colaboración activa de Duoc UC con la comunidad nacional. La institución implementó soluciones innovadoras para enfrentar los desafíos de la crisis sanitaria, desde la adecuación de sus actividades prácticas hasta el apoyo a estudiantes y profesores afectados por las restricciones y dificultades de la pandemia.
Sánchez instó a Duoc UC a mantener este enfoque en el futuro, participando en los debates principales del país y contribuyendo con propuestas que reflejen su misión y valores. Este compromiso social no solo fortalece a la institución, sino que también la posiciona como un referente en la construcción de una sociedad más equitativa y cohesionada.
La inclusión como una tarea identitaria y un camino a la equidad
El Rector Sánchez en reiteradas oportunidades se refirió a la inclusión, entendida como un compromiso genuino con la dignidad y el desarrollo integral de todas las personas, y que se erige como un sello identitario esencial en la construcción de una sociedad más equitativa. Promover la igualdad de oportunidades entre hombres y mujeres no solo implica garantizar los mismos derechos, sino también fomentar un entorno donde ambos géneros puedan desplegar sus talentos y capacidades plenamente. Este esfuerzo se amplía al apoyo a las personas con discapacidades, valorando su contribución única y rompiendo las barreras que limitan su participación en la vida social, educativa y laboral.
Observatorio Duoc UC / Anuario 2024 / página 34
Observatorio de la Educación Superior Técnico Profesional - Producción y gestión del conocimiento
El llamado a ser una comunidad inclusiva también implica abrir las puertas a los inmigrantes y a aquellos que enfrentan todo tipo de pobreza o exclusiones. La integración de personas de distintas culturas, contextos y realidades no solo enriquece nuestra sociedad, sino que responde al mandamiento cristiano de acoger al prójimo con amor y respeto. De igual manera, la inclusión debe enfocarse en quienes han tenido menos oportunidades, garantizando que el acceso a la educación, al trabajo y al desarrollo personal no dependa de las circunstancias de nacimiento, sino del esfuerzo compartido por construir un mundo más justo y solidario.
Esta vocación de inclusión también nos llama a cultivar una cultura del respeto y la tolerancia hacia el otro, reconociendo en la diversidad una fortaleza y no un obstáculo. Inspirados en las enseñanzas de Jesucristo, la aceptación y el diálogo son valores esenciales para superar las divisiones y trabajar en la construcción de una convivencia armónica. Este compromiso no solo transforma vidas individuales, sino que fortalece el tejido social, creando una comunidad basada en la compasión, la justicia y el amor al prójimo.
Hacia un futuro con esperanza y responsabilidad
El aniversario número 56 de Duoc UC no solo celebra una historia de logros, sino que también marca un punto de partida para enfrentar los desafíos del futuro con esperanza y determinación. Las palabras de Ignacio Sánchez, recopiladas a lo largo de sus años de colaboración con la institución, ofrecen una guía inspiradora para continuar avanzando en áreas clave como la innovación, la calidad educativa, la inclusión y el compromiso social.
En un contexto de cambios acelerados y demandas crecientes, Duoc UC está llamada a liderar con un enfoque integral que combine excelencia técnica, valores éticos y una visión de futuro. Este aniversario no solo recuerda el camino recorrido, sino que reafirma el propósito de seguir construyendo una institución que inspire, transforme y contribuya al desarrollo de Chile.
El desafío es claro: Seguir sembrando con fe y esperanza, adaptándose a los cambios, pero siempre fiel a la misión y los principios que han guiado a Duoc UC desde su fundación. En esta tarea, las ideas y el legado de Ignacio Sánchez serán una luz que orientará a la comunidad hacia nuevos horizontes de excelencia y humanidad.
18 de noviembre de 2024
Equipo Editorial del Observatorio Duoc UC
Observatorio Duoc UC / Anuario 2024 / página 35
Observatorio de la Educación Superior Técnico Profesional - Producción y gestión del conocimiento
Un Duoc UC insertado en un contexto
de ingentes cambios culturales y que se prepara para responder a las demandas del siglo
XXI
Duoc UC es una institución de educación superior chilena que ha tenido un desarrollo impresionante en los últimos años. Fue fundado en 1968, y para el 2013 ya contaba con cerca de 4.000 docentes y 80.000 estudiantes en 16 sedes, lo que la convertía en una de las instituciones educativas más importantes de Chile.
Estos últimos 10 años han sido una etapa de cambios importantes para la institución y de gran impacto futuro. En 2012, asumió como rector Bernardo Domínguez, ingeniero civil UC, quien lideró la institución hasta el 2014, iniciando un avance en la calidad institucional y el crecimiento con más sentido del por qué se creará cada una de las sedes del futuro.
Uno de los hitos más relevantes de esta etapa fue el nuevo rol del Consejo de la Fundación y el cambio de estatutos en 2013, que implicó la creación de un directorio de cinco miembros nombrados por el Honorable Consejo Superior de la Universidad, los mismos que forman el directorio de IP y CFT. Con esta medida, se buscó fortalecer la gobernanza de Duoc UC y mejorar la toma de decisiones estratégicas, acompañando y apoyando más de cerca a la Dirección Ejecutiva.
En 2013, la institución ya contaba con cerca de 4.000 docentes y 80.000 estudiantes en 16 sedes. En este contexto, surgieron nuevas sedes en San Bernardo y Plaza Norte en Duoc UC, lo que permitió a la institución ampliar su cobertura y llegar a más estudiantes. Esta estrategia de crecimiento, que ya venía desde la gestión de Marcelo von Chrismar fue fundamental para consolidar a Duoc UC como una de las principales instituciones educativas con más presencia territorial en Chile, sobre todo en la Quinta y Octava región, además de la Región Metropolitana.
En 2015, asumió como rector Ricardo Paredes (ingeniero comercial de la Universidad de Chile) y que subrayó los focos en el mejoramiento de la oferta académica, identidad y misión, vinculación con el medio y un rol más activo en proponer políticas públicas. En este contexto, se trabajó en actualizar el Proyecto Educativo y en establecer principios institucionales como integridad, calidad, respeto y compromiso, que son orientaciones de conductas internas. Los focos estratégicos de la institución fueron: vínculos significativos con la sociedad; oferta académica flexible centrada en el aprendizaje, cobertura y desarrollo institucional; gestión institucional con foco en la excelencia y formación humana integral y distintiva.
Uno de los hitos más relevantes de este período fue la creación del Campus Arauco en 2016. Esta iniciativa se llevó a cabo en asociación con empresas Arauco e introducción del sistema dual. El objetivo de esta estrategia fue fortalecer la vinculación de Duoc UC con el mundo empresarial y ofrecer una formación más práctica y aplicada a las necesidades del mercado laboral.
El 2020 en el mes de enero asume como nuevo Rector Carlos Díaz Vergara, Ingeniero Comercial de la UC. A su llegada comenzó a trabajar en el Plan de Desarrollo 2021-2025 y a dos meses de asumir tuvo que enfrentar la Pandemia COVID-19, situación absolutamente inédita para Duoc UC, que significó enormes esfuerzos para toda la comunidad para continuar con sus actividades administrativas y académicas regulares.
Observatorio Duoc UC / Anuario 2024 / página 36
Observatorio de la Educación Superior Técnico Profesional - Producción y gestión del conocimiento
Respecto a lo primero invitó a toda la comunidad a construir en conjunto el Plan, y respecto a lo segundo, tomar todas las medidas para enfrentar la Pandemia y reorganizar toda la actividad académica y administrativa a fase remota.
El Plan de Desarrollo, por primera vez, fijó un propósito institucional: “Formamos personas para una sociedad mejor”. Se hizo “para que los colaboradores pudieran retener en su mente una frase sintética que les respondiera una pregunta esencial: El por qué todos y todas trabajamos aquí en Duoc UC. Esta es inspiradora y nos impulsa a la acción con un sentido permanente y profundo. Es una síntesis de nuestra hermosa misión institucional y es fácil de memorizar”, nos expresó el Rector Díaz.
La Dirección Ejecutiva desea hoy nuevas ideas, más innovación y que en el ADN de la institución esté la digitalización. Esto tiene que ver con la revolución 4.0 y 5.0 en desarrollo y con los efectos de estas en la cultura. La Pandemia llegó con un efecto colateral: Incentivar a las instituciones a que trabajen sistemática y arduamente en sus procesos de modernización. Es un tiempo de cambios permanentes y que debemos conjugarlos armónicamente con nuestra identidad. Se trata de responder a las nuevas preguntas emergentes desde nuestro faro que es la misión institucional.
También se desea fortalecer los contactos con la comunidad y con las empresas. Saber a tiempo lo que necesita el país y sus habitantes. La institución tiene un marcado rol público y se existe para servir a Chile. Es lo que en estos últimos cuatro años ha potenciado comunicacionalmente el Rector Díaz.
También se avanza en una descentralización de los procesos administrativos y académicos. Se trata de aprovechar el talento individual de los colaboradores y que este florezca en los distintos espacios institucionales que hoy y en el futuro existirán. Que sientan los docentes, administrativos y estudiantes que, si Duoc UC obtiene éxitos, es consecuencia de un trabajo colaborativo horizontal, porque cada uno hizo algo positivo para que se produjera esta realidad virtuosa y apreciada.
El Rector Díaz potencia el aporte a la comunidad más allá de la docencia. Es un foco estratégico del actual Plan de Desarrollo. “Se trata de abrir e integrar a Duoc UC a la comunidad, y que las personas que viven en las cercanías a las sedes sientan que nuestra institución tiene las puertas abiertas y que ofrece cotidianamente no solo carreras de estudios, sino también numerosos aportes en investigación aplicada, difunde cultura, momentos de catequesis, exposiciones, conferencias, seminarios, arte, música, un sinfín de posibilidades de extensión. Una institución siempre abierta y culturalmente activa, con claridad y consciente de su rol de servidora pública” ha expresado el Rector Díaz.
El Rector Díaz también señala que “nuestra principal ocupación es fortalecer nuestra calidad académica. Qué duda cabe que el corazón de la institución es toda su actividad académica. Debemos actualizar todo aquello que sea necesario para abordar con éxito las revoluciones 4.0 y 5.0 en marcha. Para poder enfrentar estos cambios, necesitamos carreras vigentes actualizadas y estar abiertos a generar nuevas respuestas a demandas de perfiles de egreso que emerjan como necesidades urgentes desde la sociedad. En tal sentido, la VRA está trabajando arduamente para prepararse para los nuevos desafíos. Y todas las demás áreas administrativas aportando todo su soporte tan necesario para que la educación que entreguemos sea la más eficaz posible, y logremos que nuestros estudiantes obtengan un merecido éxito en sus distintas ocupaciones laborales futuras, como también en las familias que libremente construyan”.
Observatorio Duoc UC / Anuario 2024 / página 37
Observatorio de la Educación Superior Técnico Profesional - Producción y gestión del conocimiento
Dado el foco esencial ya mencionado, se considera muy importante capacitar permanentemente a nuestros docentes. Es un apoyo continuo en el qué y el cómo se enseña, fortaleciendo sus conocimientos disciplinarios. Para lograr todos nuestros objetivos, los docentes son absolutamente esenciales. Son ellos la cara inmediata y más visible de la institución y por ello debemos apoyarlos en todo lo que necesiten. Por tanto, el Centro de Formación Docente se elevó a la categoría de Dirección Central.
Cuando hablamos de construir una comunidad de personas, no es una frase o muletilla de uso habitual, nos expresaba el Rector Díaz: “Es la convicción de que todos deben sentir que son esenciales para la institución. Que los necesitamos a todos, y que cuando trabajamos bien es porque estamos aportando nuestros talentos, y que el éxito institucional no es de pocos, es de muchos. Este es un cambio cultural acorde con las exigencias del tiempo presente, que se fundamenta en nuestra identidad católica más profunda y que recoge nuestra concepción de la libertad, solidaridad, colaboración, dignidad y de un sentido profundo del trabajo bien hecho y de excelencia, para que siempre y humildemente estemos dispuestos a servir a otros. Por tanto, trabajar en Duoc UC siempre será una oportunidad para ser una mejor persona y para desplegar ampliamente nuestros talentos personales. Es nuestro sueño y queremos que sea el de todos”.
Finalmente, la actual Dirección Ejecutiva está liderando un cambio de la cultura organizacional, una profunda transformación digital, fortaleciendo la calidad académica y poniendo el foco en lograr más aprendizajes en los estudiantes.
13 de mayo de 2024
Equipo Editorial del Observatorio Duoc UC
Observatorio Duoc UC / Anuario 2024 / página 38
Observatorio de la Educación Superior Técnico Profesional - Producción y gestión del conocimiento
Acreditación y
aseguramiento de la Calidad
Observatorio Duoc UC / Anuario 2024 / página 39
Observatorio de la Educación Superior Técnico Profesional - Producción y gestión del conocimiento
Duoc UC: Una historia de excelencia
y compromiso con la calidad educativa en Chile
El 16 de octubre de 2024 quedará grabado en la memoria de Duoc UC como un día de júbilo y reconocimiento. Al mediodía la comunidad se enteró que la Comisión Nacional de Acreditación (CNA) confirmó lo que toda nuestra comunidad educativa esperaba con ansias: Obtener por tercer periodo consecutivo, la acreditación máxima de 7 años. Este logro no es simplemente una cifra, ya que es el reflejo de 21 años de liderazgo nacional y dedicación incansable a la excelencia académica. Desde aquel 23 de agosto de 2004, cuando voluntariamente nos sometimos al primer proceso de acreditación institucional con la CNAP y obtuvimos 6 años, hemos demostrado consistentemente nuestro compromiso con la calidad. Las acreditaciones posteriores en 2010[1] y 2017[2], ambas obtenidas con el máximo de 7 años, consolidaron nuestra posición como institución de excelencia en Chile. Asimismo, el actual logro nos señala que continuamos siendo fieles a nuestros estudiantes, a nuestra historia y a las generaciones pasadas de la institución.
Un hito sin precedentes
Hoy Duoc UC se enorgullece de ser pionera en el país al acreditarse en la dimensión de Investigación, Creación e Innovación. Pero, además, se sometió a los nuevos criterios y estándares que la CNA, por fruto de su evolución y trabajo razonado de la educación superior y buscando lo mejor para el país, en adelante solicitará a todas las instituciones del subsector Técnico Profesional. Las áreas acreditadas incluyeron:
Docencia y resultados del proceso de formación
Gestión estratégica y recursos institucionales
Aseguramiento interno de la calidad
Vinculación con el medio
Investigación, creación e innovación
La reciente acreditación máxima de Duoc UC en las cinco áreas evaluadas por la Comisión Nacional de Acreditación (CNA) es un hito que tiene un profundo impacto en la institución, los administrativos, docentes, estudiantes y el país, en general. Es indudable que el reconocimiento obtenido beneficia a todos y todas.
[1] Acuerdo N°104 de la CNA del 25 de agosto de 2010, en que Duoc UC se acreditó en Gestión Institucional y Docencia de Pregrado.
[2] Acta N° 1131 del 9 de agosto de 2017, en que Duoc UC obtiene 7 años de acreditación en Gestión Institucional, Docencia de Pregrado y en Vinculación con el Medio.
Observatorio Duoc UC / Anuario 2024 / página 40
Observatorio de la Educación Superior Técnico Profesional - Producción y gestión del conocimiento
Los 7 años y la acreditación de excelencia implican obtener la confianza de la CNA respecto que Duoc UC es una institución que es capaz de mirarse a sí misma críticamente. Sabe de dónde viene, reconoce las brechas que debe abordar y tiene un proyecto claro para hacerlo. La CNA reconoce que somos una institución madura, con capacidad de autorregulación y que tiene desafíos y los medios para financiar su desarrollo, para seguir avanzando hacia el futuro. La CNA no certifica instituciones perfectas, sino que da garantía pública de instituciones sólidas que tienen claridad respecto de donde están y hacia dónde quieren moverse.
Celebrando juntos este logro
Las celebraciones en nuestras 19 sedes y campus reflejan la alegría y el orgullo compartido. No podía ser de otra manera: Son años de un trabajo arduo y sistemático para responder con calidad y excelencia a las demandas educativas de nuestros estudiantes y del país en su conjunto, que entiende cada día más la importancia sustancial de la Educación Técnico Profesional.
Lograr esta acreditación de siete años nos pone contentos porque al producirse, como ya lo hemos señalado, beneficia ampliamente a aquellos que son el centro indudable de todo nuestro trabajo profesional y técnico: Nuestros estudiantes. Estos captarán que pertenecen a una institución que hace bien su trabajo y que solo espera mejorar la vida presente y futura de todos ellos.
Este hito nos motiva a seguir adelante con más fuerza y convicción. Sabemos que la excelencia es un camino constante, y estamos comprometidos a recorrerlo juntos, fortaleciendo nuestra misión de ofrecer una educación de calidad que contribuya al desarrollo personal y profesional de nuestros estudiantes y al progreso de toda la sociedad chilena. Finalmente, esto es lo que espera Jesucristo de nuestra institución: “Encomienda al Señor tu camino; confía en Él, y Él hará…” Salmo 37.5.
29 de octubre de 2024
Equipo Editorial del Observatorio Duoc UC
Observatorio Duoc UC / Anuario 2024 / página 41
Observatorio de la Educación Superior Técnico Profesional - Producción y gestión del conocimiento
Editorial Boletín N°65
Observatorio Duoc UC
La elaboración de un Informe de Autoevaluación Institucional con el objeto de ser presentado a la Comisión Nacional de Acreditación, es un hito de alta envergadura para cualquier institución de educación superior. En este evento participan numerosas personas que recogen, ordenan, sistematizan datos y conocimientos de las fuentes más diversas y las plasman en un informe final que da luces razonadas sobre lo que ha sido, es y lo que pretende ser la institución educativa.
El Boletín N°65 conversó con distintas personas que ocuparon roles de liderazgo en la elaboración del Informe de Autoevaluación Institucional de Duoc UC 2024. Queríamos saber su opinión sobre lo que les significó personalmente participar directa o indirectamente en la elaboración y nos explicaran la construcción de este Informe.
De la lectura de las columnas se pueden obtener varias conclusiones y consensos comunes:
a. El cumplimiento de la Misión Institucional por parte de Duoc UC. Se observa que el Proyecto y Modelo Educativo y el Plan de Desarrollo, son documentos esenciales e iluminan el accionar educativo y la gestión institucional.
b. La participación amplia en la elaboración del Informe. Autoridades, docentes, administrativos, egresados y empresas, fueron consultados ampliamente para darle forma y contenido al Informe
c. La formación integral como gran objetivo a alcanzar. El centro de toda la actividad académica es el estudiante y se busca una formación amplia de estos en lo intelectual, valórico e incentivo del cuidado del bien común de la sociedad. Se trata de formar personas para una sociedad mejor.
d. Una alta valoración de todas las personas que trabajan en la institución y de sus incentivos para lograr el bienestar de todos/as.
e. El cumplimiento de toda la legislación chilena vigente y su rápida aplicación interna.
f. La conexión activa con el entorno y la promoción de la innovación. Duoc UC asume su vinculación con el medio desde 1968, y en estos años ha fortalecido los incentivos para innovar y potenciar la investigación aplicada institucional, con alicientes visibles a sus docentes, administrativos y estudiantes.
Desde el 2017 la institución inició sistemáticamente la acumulación de información y evidencias que mostrara sus avances año tras año. Por tanto, todo ese trabajo acumulado ayudó a Duoc UC a que, desde fi nes del 2022, empezara un profundo auto análisis de su quehacer, para levantar un Informe
Observatorio Duoc UC / Anuario 2024 / página 42
Observatorio de la Educación Superior Técnico Profesional - Producción y gestión del conocimiento
que fuera muy representativo de su realidad educativa y de la vigencia visible y demostrable de sus exigentes políticas de calidad.
De las columnas se infiere que este texto logró aunar voluntades y consensos en torno al concepto de qué hemos sido, somos hoy y cuáles son los espacios de mejora continua que tenemos y hacia dónde queremos avanzar.
Luego del minucioso y prolongado trabajo, Duoc UC ha culminado la redacción de un texto que muestra sus múltiples fortalezas y avances, y es transparente en mostrar los espacios de mejora encontrados los que serán su tarea para los próximos años. El Informe de Autoevaluación elaborado da muestras de la madurez institucional que sustenta el liderazgo de Duoc UC en el subsistema de educación técnico profesional. Ahora nos preparamos para recibir la visita del Comité de Pares Evaluadores a quienes confía en demostrar la coherencia entre lo incluido en el Informe y la realidad diaria del quehacer institucional. En esta etapa del proceso la importancia del compromiso y disposición de cada uno de los miembros de la comunidad Duoc UC será esencial.
Revisa este Boletín en https://observatorio.duoc.cl/boletin/boletin-65-diversas-miradas-a-la-elaboracion-del-informe-de-autoevaluacion-2024/
8 de abril de 2024
Equipo Editorial del Observatorio Duoc UC
Observatorio Duoc UC / Anuario 2024 / página 43
Observatorio de la Educación Superior Técnico Profesional - Producción y gestión del conocimiento
Momento de acreditación:
Un hito para mostrar la calidad en Duoc UC
Estamos a días para recibir a los pares evaluadores enviados por la CNA para examinar el estado institucional de Duoc UC “en las dimensiones de docencia y resultados del proceso de formación; gestión estratégica y recursos institucionales; aseguramiento interno de la calidad y vinculación con el medio”[1]. Además, la institución buscará acreditarse en la dimensión de investigación, creación e innovación. Sin duda, un momento esencial para toda la comunidad de Duoc UC.
Es de consenso nacional que la CNA con sus exámenes y evaluaciones a las instituciones, ha contribuido desde el 2004, con su predecesora CNAP[2], a que las instituciones de educación superior mejoren su quehacer educativo. La mirada externa, siempre profesional de los pares evaluadores, ha sido beneficiosa en la tarea de que las instituciones crezcan en calidad, que se beneficien los estudiantes con más aprendizajes logrados y, como consecuencia, el país con personas más calificadas mejorando la empleabilidad.
En el caso de Duoc UC, siempre ha obtenido importantes logros en sus acreditaciones; no solo por la cantidad de años obtenidos, sino también porque las evaluaciones de la CNA la han ayudado a mejorar su calidad, incentivando la elaboración de planes de mejora respecto a las observaciones recibidas.
Si leemos el Informe de Autoevaluación Interna, construido con amplia participación de la comunidad, observamos que en estos años hemos realizado esfuerzos permanentes para mantener nuestra excelencia educativa, para ser fieles a lo que Chile espera de la institución.
Duoc UC cumple su misión institucional y se observa que el Proyecto y Modelo Educativo y el Plan de Desarrollo, son documentos esenciales que iluminan el accionar educativo y la gestión institucional.
La formación integral es un objetivo importante a alcanzar. El centro de toda la actividad académica es el estudiante, y se busca una formación amplia de estos en lo intelectual, valórico, espiritual e incentivo del cuidado del bien común de la sociedad. Se trata de formar personas para una sociedad mejor.
Se ha avanzado con coherencia y sistematicidad en la vinculación con el medio. Duoc UC asume su vinculación con el medio desde 1968, dado que su origen es una respuesta de la comunidad UC a las necesidades educativas y de empleabilidad de la sociedad chilena de fines de los sesenta. Luego se nutre de la sociedad, con sus requerimientos y la contratación de múltiples profesionales para que impartan su saber aplicado en la formación de los nuevos estudiantes del subsector Técnico Profesional.
[1] Artículo 1 del Reglamento sobre dimensiones de acreditación para el subsistema Técnico Profesional. Aprobado en sesión Ordinaria N° 2.397 del 13 de julio de 2023.
[2] Comisión Nacional de Acreditación de Pregrado, que desde 1999 hasta el 2007 sentó las bases de para evaluar la calidad de la educación superior en Chile.
Observatorio Duoc UC / Anuario 2024 / página 44
Observatorio de la Educación Superior Técnico Profesional - Producción y gestión del conocimiento
En estos años la institución ha fortalecido los incentivos para potenciar la investigación aplicada e innovación, con alicientes visibles a sus docentes, administrativos y estudiantes. Muestra de ello son las numerosas columnas que se han escrito para el Observatorio, evidenciando la existencia de múltiples proyectos en desarrollo con aportes reales para distintos públicos de Chile.
También se ha trabajado con ahínco durante estos años en mejorar las debilidades o espacios de mejora planteadas por la CNA a Duoc UC el 2017. Y se han obtenido resultados positivos, como lo evidencia el Informe de Autoevaluación.
El Informe de Autoevaluación elaborado refleja la madurez institucional que respalda el liderazgo de Duoc UC en el subsistema de Educación Técnico Profesional. Ahora nos preparamos para recibir la visita del Comité de Pares Evaluadores, confiando en demostrar la coherencia entre lo expuesto en el Informe y la realidad cotidiana de nuestras actividades. En esta fase del proceso, el compromiso y la disposición de cada miembro de la comunidad de Duoc UC serán fundamentales.
3 de junio de 2024
Equipo Editorial del Observatorio Duoc UC
Observatorio Duoc UC / Anuario 2024 / página 45
Observatorio de la Educación Superior Técnico Profesional - Producción y gestión del conocimiento
Rumbo a la excelencia: Duoc UC
terminando su proceso de autoevaluación para la acreditación 2024
El compromiso de Duoc UC con la calidad educativa ha sido una constante desde aquel hito histórico en el 2004 cuando se firmó el primer acuerdo de acreditación institucional con la CNAP. Desde entonces, la institución ha demostrado su dedicación a la mejora continua y la excelencia académica, obteniendo acreditaciones exitosas en el 2004, 2010 y 2017. Estos procesos representan la voluntad decidida de Duoc UC de someterse a evaluaciones rigurosas para avanzar sistemáticamente en calidad.
Recordemos que, en el 2004, el acuerdo de acreditación voluntaria al que invitó la CNAP, donde se obtuvieron 6 años, marcó el inicio de un compromiso profundo con la calidad educativa. Este acto demostró la convicción en Duoc UC de que estos procesos eran beneficiosos tanto para el sistema de educación superior como para la institución en sí. Las acreditaciones del 2010 y 2017, ambas exitosas y alcanzando la máxima excelencia posible, han sido testimonio de la dedicación de la institución a la mejora continua y al avance de la calidad en sus procesos internos.
Desde el 2017 se iniciaron procesos de autoevaluación permanente, que culminaron en octubre del 2022 en que se comienza a consolidar la redacción de un nuevo Informe de Autoevaluación Interna para el nuevo proceso de acreditación 2024. Este proceso no solo representa un examen interno crítico, sino también un compromiso con la transparencia y la rendición de cuentas ante la sociedad. La institución busca otorgar garantía pública de calidad, demostrando que cuenta con los medios humanos y materiales para cumplir con su misión de manera excepcional.
La autoevaluación institucional es un proceso altamente participativo que implica un examen crítico de todos los aspectos internos de Duoc UC. Este proceso no solo se basa en criterios y estándares conocidos, sino que también recoge evidencia sólida para respaldar las afirmaciones y demostrar la veracidad de lo que la institución hace. La participación de docentes, administrativos, estudiantes, titulados y empresas es esencial para proporcionar información verídica sobre el accionar de nuestra institución y la calidad demostrada en estos años.
En el Informe final de autoevaluación, se destacarán las evidencias y análisis de dimensiones clave, incluyendo docencia y resultados del proceso de formación, gestión estratégica y recursos institucionales, aseguramiento interno de la calidad, vinculación con el medio, investigación aplicada, creación e innovación. Estos criterios y estándares serán evaluados por la CNA, considerando la misión y el proyecto institucional de Duoc UC.
Desde el 2017, Duoc UC ha avanzado significativamente, manteniendo fortalezas y mejorando debilidades. El proceso actual representa una oportunidad para verificar el trabajo acumulativo, revisar fortalezas, detectar avances y abordar nuevas debilidades con profesionalismo. Este período de revisión es crucial para presentar a Chile y al mundo que nosotros continuamos realizando un trabajo de excelencia educativa en beneficio de todos los que confían en su quehacer educativo.
Observatorio Duoc UC / Anuario 2024 / página
Observatorio de la Educación Superior Técnico Profesional - Producción y gestión del conocimiento
En el camino hacia la acreditación 2024, la institución reafirma su compromiso con la excelencia educativa. La entidad busca demostrar que no solo ha mantenido sus estándares de calidad, sino que ha evolucionado y mejorado para enfrentar los desafíos cambiantes. En las próximas semanas terminará su autoevaluación interna y luego la enviará a la CNA. El paso siguiente es recibir a los pares evaluadores para verificar en terreno la calidad de Duoc UC y emitir su informe de la visita.
La colaboración de toda la comunidad educativa y la transparencia en el proceso de autoevaluación son esenciales para garantizar la validez y la confiabilidad de los resultados. Duoc UC se prepara para recibir a los pares evaluadores con honestidad, objetividad y confiabilidad, reafirmando su posición como líder en la educación técnica y superior en Chile.
8 de enero de 2024
Equipo Editorial del Observatorio Duoc UC
Observatorio Duoc UC / Anuario 2024 / página 47
Observatorio de la Educación Superior Técnico Profesional - Producción y gestión del conocimiento
Formación integral,
identidad católica y valores institucionales
Observatorio Duoc UC / Anuario 2024 / página 48
Observatorio de la Educación Superior Técnico Profesional - Producción y gestión del conocimiento
Ceremonia de categorización docente

Me complace especialmente poder participar de esta importante ceremonia[1]. Luego de un largo proceso, 72 docentes alcanzan una nueva categoría docente y lo más relevante: con ello logran un merecido reconocimiento a su trabajo. Este proceso, para cada uno de los reconocidos, no comenzó hace un par de meses con la postulación correspondiente, más bien empezó al momento de comenzar su vida académica en Duoc UC. Sin duda ha sido un largo camino de aprendizaje y de compromiso con nuestros estudiantes y también con nuestro Proyecto Educativo. Por todo ello les extiendo mi mayor felicitación y agradecimiento.
En esta significativa ceremonia me interesa abordar dos temas que, en mi opinión, son esenciales en el marco de una reflexión sobre el rol del docente en una institución de la Educación Superior Técnico Profesional católica en la perspectiva de una formación integral del estudiante.
El primero dice relación con ¿quién es el sujeto de la formación integral? ¿Se trata de un ideario centrado en la persona? ¿En qué persona? Estas preguntas encierran una problemática mayor, es decir, ¿quién es el principio, sujeto y fin de todas las instituciones humanas? ¿La persona o el individuo? ¿La persona o el colectivo? ¿La persona o el Estado? ¿La persona o el mercado?
Cuando hablamos de formación integral estamos hablando, al mismo tiempo, del sujeto de dicha formación quien en el ejercicio de su libertad aspira a su desarrollo, un desarrollo que debiera ser integral. Pues bien, quiero pensar que quien está en el fundamento de ese desarrollo es la persona humana, aquel que en el antiguo decir de Boecio y luego tomado por Santo Tomás de Aquino, es: “substancia individual de naturaleza racional”.
[1] Ceremonia de categorización docente. Efectuada en el Salón de Honor de la sede Antonio Varas de Duoc UC el 6 de junio de 2024.
Observatorio Duoc UC / Anuario 2024 / página 49
Observatorio de la Educación Superior Técnico Profesional - Producción y gestión del conocimiento
Es decir, cada ser humano es un sujeto racional y libre. Al acentuar con tanta fuerza ese hecho, quiero contraponer esa idea a la del hombre y de la sociedad actual que se inclina por la exaltación del individuo. Cuando dejamos de considerar a la persona como un fin en sí mismo, el Estado y el Mercado se perfilan en el contexto social como los sujetos que le otorgarían significado y sentido a su propia presencia en el mundo. De ese modo, el orden natural de las cosas ya no sería tal, esto es, la persona estaría en riesgo de existir para el Estado o la persona podría adecuarse a un Mercado concebido como un fin en sí mismo.
Me parece que lo que se olvida, es que el desarrollo, antes que ser una categoría económica o política, es esencialmente una categoría ética. Esto quiere decir que solamente tiene sentido cuando se refiere a la persona.
Como lo señaló, Pablo VI en Populorum Progressio: “El desarrollo no se reduce al simple crecimiento económico. Para ser auténtico debe ser integral, es decir, promover a todos los hombres y a todo el hombre. Con gran exactitud ha subrayado un eminente experto: ‘Nosotros no aceptamos la separación de la economía de lo humano, el desarrollo de las civilizaciones en que está inscrito. Lo que cuenta para nosotros es el hombre, cada hombre, cada agrupación de hombres, hasta la humanidad entera’”.
La segunda reflexión que quiero compartir con ustedes en esta importante ocasión, se refiere al rol del docente de una institución de Educación Superior Técnico Profesional católica. La figura del educador se encuentra asociada a la idea de maestro, la cual es indisociable del principio de autoridad entendido este último como una facultad moral.
“Los jóvenes necesitan auténticos maestros; personas abiertas a la verdad total en las diferentes ramas del saber, sabiendo escuchar y viviendo en su propio interior ese diálogo interdisciplinar; personas convencidas, sobre todo, de la capacidad humana de avanzar en el camino hacia la verdad. La juventud es tiempo privilegiado para la búsqueda y el encuentro con la verdad.” (S.S. Benedicto XVI).
¿Qué se entiende por maestro? Maestro es ciertamente, el que enseña, es decir, el que muestra el conocimiento y las formas de vida en las que se aplica. En sentido amplio, el que muestra el camino de la ciencia, del arte, del bien; de las virtudes que enriquecen la vida humana. Y cuando esto ocurre, cuando no solo “muestra” el saber, sino que orienta para aplicarlo y motiva para amarlo, hacerlo propio y enriquecerlo, traspasa la línea del saber para abrir la del ser. Es entonces cuando el docente se transforma en educador, es decir, en aquel que guía el crecimiento personal de los alumnos, y promueve el desarrollo integral de las personas.
¿A quién enseña? Keith Bain, en su libro “Lo que hacen los mejores profesores de universidad”, 2007, afirma: “Los momentos del aula deben pertenecer al estudiante –no a los estudiantes sino al auténtico estudiante indivisible–. No enseñas a una clase. Enseñas a un estudiante”.
Es conveniente recalcar aquí, una vez más, la importancia del ideal simbólico del docente como maestro; es decir, como aquel que transmite sus conocimientos y sabiduría al educar, y no solo como un guía que orienta. Esta transmisión es la base de todo progreso cultural.
Observatorio Duoc UC / Anuario 2024 / página 50
Observatorio de la Educación Superior Técnico Profesional - Producción y gestión del conocimiento
La cultura se construye sobre los conocimientos alcanzados hasta el momento. Pero no solo esto; a nivel personal esta transmisión juega un papel muy importante, no solo para obtener conocimiento, sino como requisito previo para que el educado pueda, llegado su momento, optar y tomar decisiones serias en su vida. Por esta razón, el docente no transmite el saber como si fuera un objeto de uso y consumo, sino que establece ante todo una relación sapiencial, de sabiduría, que se convierte en palabra viva antes que en transmisión de nociones.
El educador es siempre un modelo que seguir, lo busque o no. Sus obras y manera de ser influyen más en el estudiante que cualquier palabra, consejo o lección que dé. Por esta razón el testimonio de vida resulta fundamental en cualquier tipo de educación. La coherencia de vida en el docente es clave para el alumno o alumna. Muchas gracias
17 de junio de 2024
Observatorio Duoc UC / Anuario 2024 / página 51
Observatorio de la Educación Superior Técnico Profesional - Producción y gestión del conocimiento
Educar con
inmanencia y trascendencia
Desde la Declaración de la Sorbona en 1998, Europa decidió potenciar el conocimiento como instrumento y fin decisivo para incrementar la calidad de vida de sus ciudadanos. Dicha declaración nos recuerda que toda institución de educación superior debe hacer lo posible para formar hacia el empleo y la inserción laboral plena. Sin embargo, aspiramos a que la educación vaya mucho más allá de lo planteado en ese texto: en lo posible, debe formar además personas integrales. Porque cuando hablamos de educar personas, este desafío es mucho más amplio y profundo que simplemente instruir estudiantes para tareas laborales concretas.
Cuando una institución se compromete a educar, en dicha afirmación subyace una visión antropológica de cómo esta se sitúa en el pasado, el presente y el futuro, tanto en el plano terrenal como en una dimensión trascendente que supera la materialidad. No es lo mismo educar solo para lo inmanente al mundo (materialismo) que educar de manera que integre inmanencia y trascendencia; es decir, para el mundo y para la búsqueda y encuentro de Dios.
Cuando hablamos de que el acto educativo mejora la calidad de vida del estudiante, lo que tratamos de decir es que toda institución educativa debe ayudar a lograr aquellos aprendizajes que permitan que sus estudiantes puedan realizarse plenamente como personas, con diversidad de visiones sobre el mundo, pero con una sustancia común originaria, respetando identidades y promoviendo valores universales. Y respecto de aquellos que buscan incansablemente a Dios, Duoc UC crea y mantiene los lugares y las instancias que favorezcan este encuentro libre y significativo entre un docente, administrativo o estudiante con Jesucristo.
Las personas tienen necesidades de toda índole, no solo materiales o las propias de los empleados que están orientadas hacia la productividad económica. Necesitamos formar personas que no solo sean expertos técnicos, que apliquen eficazmente la razón instrumental en los distintos espacios laborales, sino que también sean un ejemplo como seres humanos, y que posean plena comprensión de que el valor profundo de ellas no depende solo de su mayor o menor productividad, sino del simple hecho de ser personas, y personas de bien.
Toda persona necesita saber, como ya lo hemos señalado, que su valoración no proviene únicamente de su productividad laboral, por muy importante que sea su ejercicio profesional para toda empresa. En esta materia es relevante no confundirse. La dignidad de la naturaleza humana no se origina en el actuar, sino esencialmente en el ser. Y esta verdad irrefutable necesitamos comunicarla y transferirla como una directriz profunda de enseñanza educativa.
Observatorio Duoc UC / Anuario 2024 / página 52
Observatorio de la Educación Superior Técnico Profesional - Producción y gestión del conocimiento
La Educación Superior Técnico Profesional, cuyos perfi les de egreso nos indican que forma hacia el trabajo, no debe olvidar que si bien transfi ere competencias duras indispensables para el saber hacer, debe enseñar también valores y actitudes que, integrados con las competencias específi cas de la disciplina o técnica, presentan a la sociedad personas que entienden que trabajan con un sentido profundo, buscando no solo el propio desarrollo y proyección, y la de la organización donde trabajan, sino también el bien común.
La calidad de vida como ciudadanos, que es una legítima aspiración humana, se puede lograr en la medida en que educamos más allá de una enseñanza técnica específica. Formamos personas para vivir en el mundo, sin parcelas delimitadas y restringidas, sino para todos los ámbitos de la existencia humana. En esta tarea, todo docente podría tener como ideal ir más allá de la formación, para aspirar a la educación más integral del ser humano. En tal sentido, no solo debería instruir para un desempeño sobresaliente en las tareas concretas y específicas, sino educar, en la medida de lo posible, para la integralidad de hechos, valores y sentimientos que se manifiestan o pueden manifestarse en los diferentes momentos laborales. Hoy, en que estamos bajo la presión de ser productivos y de que nuestra valoración o reconocimiento se reduzca a nuestro aporte material a los índices macro y microeconómicos o financieros, es indispensable no convertir esta necesidad de aportar materialmente en un único fin, ni siquiera en un fin en sí mismo. Debemos destacar la importancia del esfuerzo, del trabajo honesto, de la generosidad, de la alegría para enfrentar las dificultades, de la actitud positiva y proactiva, y, por supuesto, de la contribución al bien común en general.
La encíclica Gaudium et Spes, promulgada por el Papa Pablo VI en 1965, nos brinda luces profundas sobre la espiritualidad del trabajo: “La actividad humana, así como procede del hombre, así también se ordena al hombre. Pues éste, con su acción, no solo transforma las cosas y la sociedad, sino que se perfecciona a sí mismo. Aprende mucho, cultiva sus facultades, se supera y trasciende. Tal superación, rectamente entendida, es más importante que las riquezas exteriores que pueden acumularse… Por tanto, ésta es la norma de la actividad humana que, de acuerdo con los designios y voluntad divinos, sea conforme al auténtico bien del género humano y permita al hombre, como individuo y miembro de la sociedad, cultivar y realizar íntegramente su plena vocación” (GS 35).
El trabajo no solo vale por su productividad material, sino también porque a través de él logramos desarrollarnos, superarnos, participar en el mundo, tener dignidad y, finalmente, todo esto se sintetiza en la posibilidad cierta de ser personas integrales, plenamente abiertas a la trascendencia, a Cristo. Este es un desafío educativo fundamental para Duoc UC.
24 de septiembre de 2024
Equipo Editorial del Observatorio Duoc UC
Observatorio Duoc UC / Anuario 2024 / página 53
Observatorio de la Educación Superior Técnico Profesional - Producción y gestión del conocimiento
El aborto y la eutanasia,
dilemas sobre el derecho a la vida
El martes 3 de septiembre, en el piso 15 de la Casa Central, se realizó la presentación del libro “Aborto y eutanasia, dilemas sobre el derecho a la vida”, cuyos editores son Jorge Acosta y Francisca Reyes Arellano. El libro tuvo su origen en el Instituto Res Publica y la Fundación ChileSiempre, que han mostrado su compromiso con la vida humana desde su concepción hasta la muerte natural.
El acto fue presidido por el Rector de Duoc UC Carlos Díaz Vergara quien expuso algunas palabras de bienvenida y manifestó su compromiso con la identidad de Duoc UC que defiende la vida desde la concepción hasta la muerte natural, y también estuvo presente, como panelista, el Rector de la Universidad Católica Ignacio Sánchez Díaz, mostrando con su presencia y palabras su adherencia al contenido del libro, en el cual también participó como coautor. Como sabemos Duoc UC posee dos esencialidades: Su adherencia católica y que el centro de toda su actividad y trabajo es para sus estudiantes, que son el centro de su quehacer. En cuanto católica la institución, esta defenderá siempre la vida de todo ser humano, porque no podría hacer lo contrario sin atentar gravemente su identidad. El libro es muy interesante porque aborda conceptos y preguntas claves para el debate nacional sobre el aborto y la eutanasia, y lo hace con gran éxito y será de gran utilidad para muchos lectores. Participaron 37 autores que contestaron 127 preguntas, todas de alta relevancia. A cada una de las preguntas se le asignó 2 páginas, escritas con una pedagogía elogiable, tanto como la precisión de su contenido para interrogantes de subrayada dificultad. En el acto, a uno de los panelistas el texto le recordó el estilo de Santo Tomás de Aquino sobre la metodología utilizada, y compartimos dicha aseveración. El capítulo 1 abordó el valor de la vida humana, contestando 12 preguntas; el capítulo 2 cuyo título es el inicio de la vida humana y el aborto: Dilemas éticos, médicos y jurídicos, se hizo cargo de 56 preguntas; el capítulo 3 que afrontó el término de la vida humana y la eutanasia: Dilemas éticos, médicos y jurídicos, respondió 40 y, el capítulo 4 trató sobre los dilemas compartidos entre aborto y eutanasia, al que dedicó 17 preguntas.
Los editores del libro en su prólogo nos expresan: “Con iniciativas como esta, creemos que es posible aclarar varias dudas que -frente a eslóganes simplistas- pueden terminar confundiendo a importantes sectores de la población. Esta obra pretende contribuir a asentar una cultura de valoración de la persona por lo que es y no por lo que tiene, quiere ser un aporte en la construcción de una sociedad verdaderamente humana, una donde los derechos de quienes se encuentran en una especial situación de vulnerabilidad, como la madre embarazada y su hijo por nacer o el paciente gravemente enfermo y su familia, pueden ser protegidos en cada momento y no estén amenazados por su propia sociedad, que los mire como desechables y prescindibles por un aparente bienestar. Por el contrario, estamos convencidos de que una sociedad más humana será aquella donde se brinde especial protección a los más débiles”. Recomendamos con entusiasmo su lectura, tanto para aquellos firmes defensores de la vida, como también para aquellos que son partidarios del aborto y de la eutanasia. El libro solo intenta iluminar nuestra razón, y es un honesto e inteligente intento de los 37 autores por ayudar a que nuestras decisiones y opciones estén suficientemente informadas sobre las 127 preguntas que son y serán de alta complejidad para el debate público.
9 de septiembre de 2024
Equipo Editorial del Observatorio Duoc UC
Observatorio Duoc UC / Anuario 2024 / página 54
Observatorio de la Educación Superior Técnico Profesional - Producción y gestión del conocimiento
El nacimiento de Jesús en tiempos
de transformaciones tecnológicas y esperanza eterna
Al aproximarnos al 25 de diciembre, fecha en que la cristiandad celebra el nacimiento de Jesús, nos encontramos rodeados de un contexto marcado por vertiginosos avances tecnológicos y científicos que parecen poner en entredicho la necesidad de lo trascendente. Nuestra época se distingue por la posibilidad de modificar el ADN, intervenir procesos biológicos con una precisión inimaginable décadas atrás y planear, incluso, la creación de especies “superiores”, reeducación de células (gametogénesis in vitro), vida eterna digital en avatares, etc. Frente a este panorama, surge con más fuerza la idea de que el ser humano podría ser autosuficiente y soberano de su propio destino, alimentando una actitud de soberbia que se expande con rapidez. En esta atmósfera de cambios e invenciones, para muchos se hace cada vez más difusa la presencia de Dios, y la fe en Él se resiente ante la ilusión de una humanidad que cree tenerlo todo bajo control[1].
No obstante, también presenciamos el arraigo firme de aquellos que conservan una fe inquebrantable. Personas que, en medio de las tentaciones del dominio tecnológico, no alucinan con la promesa de perfeccionamiento humano ilimitado ni ven en la ciencia un sustituto automático de la trascendencia. En ellos permanece viva la convicción de que Jesús vino a mostrar la senda de la humildad y la sencillez, valores que no pueden ser reemplazados por ningún logro científico, por espectacular que sea. La conmemoración del nacimiento del Salvador, en ese sentido, sirve como recordatorio de un hecho histórico que transformó la vida de miles de millones de personas en el curso de los siglos.
Las Escrituras nos recuerdan que Dios, en su infinito amor, decidió hacerse hombre en la figura de Jesús. Con este acontecimiento —el de la Encarnación— se inició un movimiento capaz de reorientar los valores del mundo, iluminando aquello que de verdad importa y marcando un antes y un después en la relación entre la humanidad y su Creador. El Antiguo Testamento ya anunciaba la llegada de un Mesías que pondría lo esencial por encima de lo superfluo, y el momento cumbre de ese anuncio se concretó en un humilde pesebre de Belén. No estuvo rodeado de esplendores palaciegos ni de grandes honores, sino del cariño de unos pocos y de la sencillez propia de la vida rural.
En su libro “La infancia de Jesús”, el Papa Benedicto XVI describe con detalle la dimensión humilde de este episodio. El Salvador del mundo vino a nacer en un pesebre, sin gozar de privilegios ni de honores ostentosos. Esta humildad no es simplemente anecdótica: corresponde a la cosmovisión que Jesús instauraría, una visión contraria al despliegue excesivo de poder y a la vanagloria que tanto seducen hoy en día. La imagen del pesebre revela una humanidad que ha de acoger el amor de Dios en lo pequeño,
[1] La editorial es el producto de una extensa conversación mantenida con distintas IA sobre ciencia, biología, tecnología, genética, transhumanismo, para relacionarlas con la venida de Jesús al mundo y, en este contexto, que pasaba con el sentido misional de Duoc UC. Resultó significativo cómo las IA, sin predisposición prejuiciosa a las preguntas y contra preguntas que se les hizo, mostraron inclinación a entender el sentido profundo del nacimiento de ese niño en Belén, poniendo límites al exceso de fe en las capacidades humanas y en reorientarlas a comprender que estas no nos convierten en dioses, sino en meros cocreadores de la obra divina en curso durante la historia.
Observatorio Duoc UC / Anuario 2024 / página 55
Observatorio de la Educación Superior Técnico Profesional - Producción y gestión del conocimiento
en la sencillez del día a día, sin caer en la tentación de creer que todo se puede controlar o manipular a conveniencia.
“La Carta a los Romanos”, a través de Pablo de Tarso, subraya la figura de Jesús como “el primogénito de muchos hermanos”. Con su muerte y resurrección, Él inaugura una nueva humanidad y abre la posibilidad de que todos los que deseen morir con Él y resucitar con Él lo hagan, transformando así su propio destino. Cuando se habla de muerte, la fe cristiana no la entiende como el final sin retorno, sino como ese paso por el que la vida terrenal da paso a una vida eterna en comunión con Dios. De ahí la esperanza profunda del creyente: La certeza de que el nacimiento de Cristo señala el principio de una liberación global que solo se ve consumada en la resurrección y en la promesa de la vida futura.
Esta esperanza va ligada a la libertad humana. Como explica Benedicto XVI, la respuesta a la pregunta “¿a quién ama Dios?” pasa por aquello que se puso de manifiesto en el bautismo de Jesús: El Padre ama a quien vive en comunión con Él, a quien orienta su voluntad en sintonía con la divina. Pero el amor de Dios no se impone: El ser humano elige, en cada acto de su existencia, si se abre a la gracia o la rechaza. Cada día es un ejercicio de libertad, una decisión consciente o inconsciente de amar y honrar al Creador, o bien de refugiarse en la autosuficiencia de nuestros logros materiales, científicos o tecnológicos.
En el fondo, el nacimiento de Jesucristo simboliza la paz y la reconciliación que el mundo, con todos sus adelantos, no puede ofrecer por sí mismo. Se trata de una paz que nace de saberse amados por un Dios hecho hombre, un Dios que compartió las limitaciones humanas y ofreció una salvación que culmina, ya no en la caducidad de nuestros días, sino en la vida eterna. Para los creyentes, esta promesa otorga sentido a la existencia misma, pues, si la última palabra no la tiene la muerte, entonces el hoy adquiere un propósito mucho más trascendente. Las preocupaciones cotidianas, los avances científicos y las metas profesionales toman un cariz distinto cuando se viven a la luz de una eternidad que ya inició, y que palpita en la historia a través de la presencia de Cristo.
En este contexto, resulta especialmente significativo que instituciones como Duoc UC, pese a su carácter dedicado a la Educación Técnico Profesional, no renuncien a su dimensión espiritual. La celebración de la Navidad mediante una misa especial refleja que, para muchos de los integrantes de su comunidad, la fe y la formación no son ámbitos contrapuestos, sino partes complementarias de una educación integral. El desarrollo de competencias técnicas y profesionales sin un fundamento moral y trascendente corre el riesgo de volverse un mero ejercicio de habilidad, desprovisto de la grandeza del amor, la justicia y la caridad infinita.
Al proponer el encuentro con el “Dios de la eterna verdad”, Duoc UC asume que el anhelo profundo del ser humano no se sacia solo con logros materiales o conocimientos prácticos. El corazón aspira a una convergencia entre el intelecto y la sabiduría espiritual. Un profesional que vive los valores anunciados por Jesús no solo se distinguirá por su pericia técnica, sino por una altura moral que aporta paz y beneficios a la sociedad entera.
Decidir vivir con los valores cristianos no implica renunciar a la innovación ni al empuje tecnológico. Al contrario, un científico o un profesional de la técnica que funda su actuar en la ética del Evangelio contribuirá aún más a la dignificación de la persona y al bien común. Cuando desde Duoc UC se afirma que el propósito es “formar personas para una sociedad mejor”, subyace la alegría de constatar que muchos integrantes de la comunidad, libre y conscientemente, eligen profundizar en su fe, dando un sentido trascendente a su propio desarrollo profesional y humano.
Observatorio Duoc UC / Anuario 2024 / página 56
Observatorio de la Educación Superior Técnico Profesional - Producción y gestión del conocimiento
En un panorama histórico que vuelve a mostrar la necesidad de sabiduría y prudencia ante la soberbia de creernos dueños de todo proceso biológico, es un alivio recordar la enseñanza simple y luminosa que nace de un pesebre. Allí se nos recuerda que incluso en la pequeñez y la vulnerabilidad de un recién nacido puede manifestarse la grandeza más sublime de Dios. Cuando ponemos en perspectiva los avances científicos y los confrontamos con la humildad de Belén, descubrimos que no somos omnipotentes. Siguen existiendo preguntas sin respuesta, anhelos que la materia no satisface y horizontes que la técnica por sí sola no logra alcanzar.
Por eso, la Navidad no se reduce a una tradición cultural ni a una festividad meramente religiosa. Es la invitación a volver a la raíz, a recuperar la presencia divina en nuestro andar cotidiano. Se trata de un tiempo para reencontrarnos con la alegría profunda de quien sabe que Dios lo ama, un tiempo para renovar la esperanza en la victoria de la vida sobre la muerte. Y es, también, una oportunidad para reflexionar sobre la fragilidad humana, la necesidad de un amor y una verdad que trascienden nuestra capacidad de crear y transformar. En tal sentido, El Papa Francisco, en la bula Spes non confundit “La esperanza no defrauda”[2], nos convoca al Jubileo Ordinario de 2025 centrando su mensaje en la esperanza cristiana. El Papa nos recuerda la importancia de la esperanza como fundamento de la fe y aliento para los creyentes. Este jubileo comenzará el 24 de diciembre de 2024 con la apertura de la Puerta Santa en la Basílica de San Pedro y concluirá el 6 de enero de 2026. En este período nos está invitando a los fieles a ser signos de esperanza para los demás, especialmente para los pobres, refugiados, jóvenes, presos y ancianos, promoviendo una cultura de encuentro y solidaridad que refleje el amor de Dios en el mundo. Y podríamos agregar, que también Dios nos dé la esperanza de creer que los líderes y los científicos no enfrentarán al hombre contra Dios, sino que sus inteligencias solo buscarán maximizar el bienestar humano y el bien común. Al acercarnos a la celebración del 25 de diciembre, contemplemos al Niño que vino a este mundo con la mansedumbre de un Dios que habla desde la sencillez. Con humildad miremos a nuestro alrededor y preguntémonos si nuestros avances y descubrimientos continúan siendo herramientas al servicio del bien común, o si se han convertido en fines en sí mismos. A la luz de la fe cristiana, recordemos que el mayor proyecto de Dios para la humanidad sigue siendo la comunión con Él, esa que nace en el corazón de la persona y se prolonga hasta la eternidad. Esa comunión se hace palpable en la experiencia de Belén, donde la ternura divina se manifiesta en un recién nacido, invitándonos a unirnos, desde lo más hondo de nuestra libertad, a la historia de amor que Dios ha soñado para cada uno de nosotros.
23 de diciembre de 2024
Equipo Editorial del Observatorio Duoc UC
[1] https://www.vatican.va/content/francesco/es/bulls/documents/20240509_spes-non-confundit_bolla-giubileo2025.html
Observatorio Duoc UC / Anuario 2024 / página 57
El sentido de la
educación integral en Duoc UC
Desde la Declaración de la Sorbona en 1998, Europa trazó un rumbo decidido hacia el fortalecimiento del conocimiento como herramienta esencial para mejorar la calidad de vida de sus ciudadanos. La premisa de formar hacia el empleo y la plena inserción laboral, expresada en dicha declaración, resuena en el compromiso de instituciones educativas como Duoc UC de querer ir más allá y aspirar a la formación integral de personas. Este enfoque no es una simple instrucción para tareas laborales concretas, ya que busca trascender los límites de lo inmanente al mundo material y conectar con la trascendencia, guiando a los estudiantes hacia la búsqueda del significado y el encuentro con lo divino.
La visión antropológica subyacente en la afirmación de educar implica una comprensión del individuo en relación con el pasado, el presente y un futuro terrenal y trascendental. La educación no se reduce a un mero materialismo; aspira a ser copulativa con la inmanencia y la trascendencia, buscando el equilibrio entre la formación técnica y la conexión con dimensiones más profundas de la existencia. El desafío, entonces, va más allá de la formación técnica ya que implica plasmar en los estudiantes el ideario de la institución y proyectar su misión en el mundo.
La mejora de la calidad de vida del estudiante, en términos educativos, va más allá de la mera adquisición de conocimientos técnicos. Requiere que las instituciones los ayuden a lograr aprendizajes que les permitan realizarse como personas con diversidad de visiones, pero con una evidente sustancia común originaria. Este enfoque reconoce que las personas tienen necesidades diversas, no solo de índole material o ligadas a la productividad económica. Se trata de formar individuos que sean expertos técnicos eficaces, pero también ejemplos de personas con una comprensión profunda de su valor intrínseco, independientemente de su productividad laboral.
La dignidad de la naturaleza humana no se origina únicamente en el actuar, sino fundamentalmente en el ser. Este principio irrefutable debe ser comunicado y transferido como una directriz profunda en la enseñanza educativa. La Educación Superior Técnico Profesional, que se enfoca en la formación hacia el trabajo, debe recordar que la transferencia de competencias duras no debe prescindir de la enseñanza de valores y actitudes. La integración de competencias técnicas con valores éticos ya sabemos que busca el beneficio de la comunidad en general, con personas que son y actúan.
La calidad de vida como ciudadanos, una legítima aspiración humana, se logra cuando la educación trasciende la enseñanza técnica específica. La formación integral de personas implica preparar a los estudiantes para vivir en el mundo en todos sus ámbitos, sin restricciones parceladas. En este contexto, los docentes tienen la responsabilidad de ir más allá de la simple formación técnica y aspirar a la educación integral del ser humano. Instruir para un desempeño excepcional en tareas específicas es necesario, pero educar para la integralidad de hechos, valores y sentires que se manifiestan en diferentes momentos laborales es un ideal que cada docente debería abrazar.
Observatorio Duoc UC / Anuario 2024 / página 58
Observatorio de la Educación Superior Técnico Profesional - Producción y gestión del conocimiento
En una época en la que la presión por la productividad y la valoración individual se vinculan estrechamente con aportes materiales a indicadores económicos, es crucial evitar la reducción de esta necesidad a un único fin. Se debe destacar la importancia del esfuerzo, el trabajo honesto, la generosidad y la alegría para enfrentar las dificultades, junto con actitudes positivas y proactivas, y la contribución al bien común, se vuelve cada día en más esencial. La encíclica Gaudium et Spes del Papa Pablo VI proporciona una perspectiva sobre la espiritualidad del trabajo, enfatizando que el trabajo no solo vale por su productividad material, sino también porque a través de él, nos desarrollamos, superamos y participamos en el mundo. El desafío educativo fundamental para Duoc UC, considerando su misión y propósito, proyecto y modelo educativo, radica en lograr la integralidad de la formación técnica y la educación en valores, trascendiendo la mera productividad para enfocarse en el desarrollo humano más insigne. La aspiración de formar personas integrales, plenamente abiertas a la trascendencia, requiere un compromiso constante con la enseñanza y la transferencia de valores que vayan más allá de la eficiencia laboral. He aquí la peculiaridad de nuestra misión.
En este contexto, la educación no solo es un medio para mejorar la calidad de vida material, sino un camino hacia la plenitud humana y la contribución al bien común. En el siglo XXI y desde su fundación en 1968, la misión de Duoc UC va más allá de la formación técnica: Se trata de forjar ciudadanos que hayan tenido la oportunidad de conocer a Jesucristo y abiertos a su trascendencia, su modelo de vida y comprometidos con el desarrollo integral de la sociedad, mostrando asimismo con su ejercicio laboral todas sus competencias de excelencia.
15 de enero de 2024
Equipo Editorial del Observatorio Duoc UC
Observatorio Duoc UC / Anuario 2024 / página 59
Observatorio
Trascendiendo la educación:
Una mirada desde Duoc UC
Desde la emblemática Declaración de la Sorbona en 1998, Europa se ha comprometido con el impulso del conocimiento como un medio y un fin para enriquecer la calidad de vida de sus ciudadanos. Esta declaración marcó un hito al instar a las instituciones de educación superior a formar hacia la inserción laboral plena. Sin embargo, hoy nos planteamos un desafío aún más ambicioso: educar para la integralidad del ser humano. No es que antes no se haya hecho, pero hoy pasa a ser más demandante para los proyectos educativos de las distintas instituciones educativas. La educación busca dotar a cada individuo con los aprendizajes necesarios para su realización personal y profesional. Esto implica reconocer la diversidad de visiones sobre el mundo, mientras se preserva una esencia común que respeta las identidades individuales. Esta cuestión es esencial porque no todo lo moral y éticamente evoluciona, sino solo algunos aspectos del comportamiento humano que ha merecido ser mejorado para construir una mejor sociedad y el respeto a la dignidad humana. Hoy se viven momentos complejos con una sociedad líquida en pleno desarrollo y con un debate amplio entre diversas opciones antropológicas. Esto ha generado gran confusión y el surgimiento de visiones que pugnan con la que ha tenido desde hace siglos la sociedad occidental. En este escenario, es importante tener claridad de lo permanente en las personas, de aquello que cambia en concordancia con las opciones libres que las personas de distintas épocas asumen.
Cuando una institución se embarca en la misión de educar, se adentra en un ámbito antropológico que trasciende el mero acto de instruir para el trabajo. Es un compromiso que abarca el pasado, el presente y el futuro de las personas, tanto en el ámbito terrenal como en el espiritual. En este sentido, la visión de Duoc UC destaca la importancia de plasmar en los estudiantes el ideario que fundamenta la institución y que proyecta su misión. Por otro lado, es imperativo comprender que las personas tienen necesidades que van más allá de lo material y lo laboral. La formación técnica y profesional debe ir de la mano con la transmisión de valores y actitudes que contribuyan al bienestar individual y colectivo. Este enfoque integral es esencial para que los estudiantes comprendan el valor intrínseco de su humanidad y trasciendan la mera productividad laboral. La encíclica Gaudium et Spes nos brinda una perspectiva valiosa sobre la espiritualidad del trabajo, destacando que la actividad humana no solo transforma la sociedad, sino que también enriquece al individuo en su camino de desarrollo y trascendencia. El ejercicio laboral dignifica, las personas se sienten útiles, se sienten parte activa del mundo. En un mundo obsesionado con la productividad y el rendimiento económico, es vital recordar que el trabajo no solo aporta materialmente, sino que también contribuye al desarrollo personal, la participación social y la realización espiritual. Este desafío educativo representa el corazón de la misión de Duoc UC y nos invita a trascender hacia una educación que forme personas integrales, plenamente abiertas a la trascendencia y al encuentro con lo divino. Esto si es esencial para ser fieles a las razones que explican el por qué existimos como institución: para ofrecer una antropología cristiana, una invitación a conocer a Jesucristo y el formar personas para que, con su trabajo especializado y técnico sumado a su despliegue personal, formen una mejor sociedad.
15 de abril de 2024
Equipo Editorial del Observatorio Duoc UC
Una perspectiva cristiana sobre la dignidad humana y la cultura del
respeto en Duoc UC
En el transcurso de la historia, la Iglesia Católica ha defendido inquebrantablemente la dignidad de la persona humana, fundamentando su convicción y enseñanzas en que cada individuo es creado a imagen y semejanza de Dios. Esta verdad profunda y tan relevante, nos llama a cultivar una cultura del respeto y del reconocimiento de la dignidad inherente de cada ser humano. Hoy, nos encontramos ante una oportunidad significativa para reflexionar sobre estos principios, a la luz de la reciente promulgación de la Ley Karin, destinada a promover espacios laborales seguros y libres de violencia.
En tal sentido, Duoc UC tiene por tradición la cultura del respeto. Valoramos al otro u otra como una persona que posee una dignidad esencial que nos obliga a estimarlo y considerarlo. La institución representa muy bien a Chile en cuanto a que sus estudiantes provienen de todos los segmentos socioeconómicos, y esto nos da una posibilidad de integración de los alumnos y alumnas que nos enorgullece. Por esto, que una ley apoye estos valores, es una buena noticia para la institución.
La Ley Karin, recientemente implementada, refuerza la importancia de un ambiente laboral en el que prevalezca el respeto y la dignidad de cada persona. En Duoc UC, nos unimos a este llamado, reconociendo que la creación de un entorno de trabajo que refleje estos valores es no solo un deber legal, sino una responsabilidad moral. Como institución educativa de inspiración cristiana, estamos profundamente comprometidos con la implementación de estas nuevas medidas, que no solo protegen a nuestros colaboradores y estudiantes, sino que también promueven una comunidad de trabajo justa y solidaria.
La cultura del respeto y la dignidad humana
El respeto por la dignidad humana es un principio cardinal de la doctrina social de la Iglesia. San Juan Pablo II, en su encíclica Centesimus Annus (1 de mayo de 1991), nos recuerda que “el trabajo es una dimensión fundamental de la existencia del hombre en la tierra”. En este sentido, la Ley Karin nos invita a reexaminar cómo, en nuestra comunidad educativa, valoramos y protegemos a cada persona en su trabajo diario. En tal sentido, esta ley establece la obligación de prevenir cualquier forma de acoso laboral, acoso sexual y violencia en el trabajo, poniendo un énfasis particular en la inclusión de la perspectiva de género y la no discriminación.
La introducción de nuevas defi niciones, como la eliminación de la necesidad de reiteración para identifi car el acoso laboral y el reconocimiento de la violencia ejercida por terceros ajenos a la relación laboral, amplía nuestra comprensión de los riesgos y desafíos en el entorno laboral. Como comunidad cristiana, estamos llamados a acoger estas defi niciones con seriedad, reconociendo en cada uno de nuestros colaboradores la imagen de Dios, y asegurando que todos sean tratados con el respeto y la dignidad que merecen.
Observatorio de la Educación Superior Técnico Profesional - Producción y gestión del conocimiento Observatorio Duoc UC / Anuario 2024 / página
Observatorio de la Educación Superior Técnico Profesional - Producción y gestión del conocimiento
La responsabilidad de prevenir y proteger
El mandato de implementar un protocolo de prevención del acoso laboral y/o sexual y la violencia en el trabajo, siguiendo las directrices de la Superintendencia de Seguridad Social (Suseso), subraya la importancia de una acción preventiva. En Duoc UC, este compromiso se traduce en un esfuerzo conjunto para crear y mantener un ambiente en el que todos los miembros de la comunidad se sientan seguros y valorados.
La prevención es más que un conjunto de procedimientos: Es una cultura que debe ser vivida y promovida en todos los niveles de nuestra institución. Como católicos, creemos que cada persona tiene un valor inestimable y que nuestra labor no es solo proteger, sino también promover el desarrollo integral de cada individuo. Esto incluye el fomento de un ambiente de trabajo donde las diferencias en talentos sean respetadas y celebradas, y donde cada persona pueda contribuir plenamente con sus dones únicos a la causa común.
Procesos justos y transparentes
La Ley Karin también introduce nuevos estándares en los procesos de denuncia, investigación y sanción, asegurando que estos sean efectivos y justos. En consonancia con los principios de justicia y caridad cristiana, es esencial que estos procesos sean transparentes y accesibles para todos. En Duoc UC, estamos dedicados a garantizar que cualquier denuncia de acoso o violencia laboral sea tratada con la seriedad y la confidencialidad que merece, asegurando una respuesta adecuada, oportuna, verdadera y justa.
El respeto por la dignidad de cada persona exige que se aborden las quejas y conflictos con equidad, buscando siempre el bien común y la reconciliación. La justicia en el ámbito laboral no es solo una cuestión de legalidad, sino una expresión de nuestro compromiso cristiano con la verdad y el amor por la persona.
Una comunidad comprometida
En este contexto, Duoc UC invita a todos sus colaboradores a familiarizarse con las nuevas disposiciones y a seguir participando activamente en la creación de un espacio de trabajo respetuoso y libre de acoso y violencia. Esta invitación no es meramente administrativa: Es una llamada a la acción en consonancia con nuestra fe. La dignidad humana y el respeto por el prójimo son valores que deben permear todas nuestras acciones, tanto dentro como fuera del lugar de trabajo. Revisar el nuevo Reglamento Interno de Orden, Higiene y Seguridad y colaborar con los Generalistas de Personas en nuestras sedes, campus y Casa Central, es parte de este compromiso. La participación activa de cada uno es crucial para construir una cultura institucional basada en el respeto que sea reflejo de nuestros valores cristianos que tanto impulsa nuestra misión institucional. En un mundo donde la dignidad de las personas a menudo es vulnerada, estamos llamados a ser un testimonio vivo de los valores cristianos, creando espacios seguros y acogedores para todos. Este es un camino que recorremos juntos, como comunidad educativa y como seguidores de Cristo, buscando siempre el bien de nuestros hermanos y hermanas. La cultura del respeto y la dignidad humana no es solo una aspiración, ya que es una realidad que debemos construir día a día, en cada interacción y decisión que tomamos.
12 de agosto de 2024
Equipo Editorial del Observatorio Duoc UC
Observatorio Duoc UC / Anuario 2024 / página 62
Observatorio de la Educación Superior Técnico Profesional - Producción y gestión del conocimiento
Investigación aplicada,
innovación y transferencia tecnológica
Observatorio Duoc UC / Anuario 2024 / página 63
Observatorio de la Educación Superior Técnico Profesional - Producción y gestión del conocimiento
Construyendo Puentes:
Investigación aplicada, innovación y transferencia en Duoc UC

Catalina Petric Araos Directora de Investigación Aplicada, Innovación y Transferencia de Duoc UC.
La Dirección de Investigación Aplicada, Innovación y Transferencia (DIAIT) de Duoc UC tiene como misión contribuir al desarrollo de la sociedad en el ámbito técnico profesional mediante la investigación aplicada, innovación y transferencia tecnológica. En esa labor, una tarea de suma importancia es la comunicación y difusión de las instancias, proyectos y resultados obtenidos desde esta Dirección.
Por esta razón, estamos complacidos de publicar, a contar de hoy y las siguientes semanas, una serie de columnas en el Observatorio Duoc UC, donde los líderes de proyectos financiados y apoyados por DIAIT relatan en primera persona su experiencia trabajando en investigación aplicada e innovación, apoyados por estudiantes y en articulación con los sectores productivos del país.
Previamente, en la edición N°39 del Boletín del Observatorio Duoc UC, en el año 2019, fueron destacados dieciséis proyectos de investigación en curso, abarcando una amplia gama de áreas innovadoras. Entre ellos se incluyen iniciativas como la creación de instrumentos de alerta temprana para áreas verdes; el desarrollo de un revestimiento acústico utilizando algas (Algústica); sistemas integrados de cultivo de alimentos en zonas de catástrofes (AYA); tecnología adaptativa para personas con discapacidad múltiple; la valorización de desechos; programas de estimulación física adaptados para escolares con sobrepeso y obesidad (Ludocriollo); archivos digitales de sonoterapia y musicoterapia; clúster turístico inteligente (Smart Concón); robots agrícolas con inteligencia artificial; depuración biológica de aguas residuales; inteligencia artificial fotovoltaica; estudio de la viabilidad de incorporar materiales reciclados en la normativa de construcción chilena; un tensiómetro musical para agricultura; sistemas de interacción inteligente basados en EEG; agricultura urbana fotovoltaica y sistemas de diseño y fabricación digital para la industria del calzado en colaboración con Guante-Gacel. Estos proyectos reflejan el compromiso de Duoc UC con la investigación aplicada y la innovación en diversas áreas de relevancia social y económica.
Observatorio Duoc UC / Anuario 2024 / página 64
Observatorio de la Educación Superior Técnico Profesional - Producción y gestión del conocimiento
Mirando la historia de esta Dirección, podemos recordar que entre 2017 y 2020, Duoc UC asentó de manera definitiva su interés por implementar un área especializada en investigación aplicada, innovación, transferencia e innovación corporativa. De esta forma, en 2017, en el documento del Plan de Desarrollo 2016-2020, se formuló la primera política del área, implementada completamente a partir de 2021, formalizando estos cambios oficialmente.
En el marco de la actualización de la Política institucional en 2022, se introdujo el Reglamento General de Investigación Aplicada e Innovación de Duoc UC, estableciendo las normativas y procedimientos para dirigir la gestión y aplicación de esta política, así como el Instructivo de Investigación Aplicada e Innovación. Este último comunica a todas las unidades, escuelas y sedes de Duoc UC sobre los distintos instrumentos de investigación asociativa reconocidos dentro de la institución. Además, en 2023 se implementó el Instructivo de Afiliación Duoc UC para producción científica, cuyo propósito es orientar a los investigadores sobre la correcta afiliación institucional en sus publicaciones científicas, capítulos de libros, entre otros. Las escuelas, bajo la supervisión de la Vicerrectoría Académica (VRA), tienen la responsabilidad de proponer y validar las líneas prioritarias de investigación disciplinarias.
Modelo de gestión y Políticas de I+D+i+TT
Duoc UC se ha comprometido a mejorar y optimizar las políticas, modelos de gestión, procesos y mecanismos para facilitar la investigación aplicada, la innovación, el emprendimiento y la transferencia de conocimiento de manera eficiente. Para lograr este objetivo, se están llevando a cabo las siguientes acciones:
– Actualización de políticas, reglamentos e instructivos relacionados con I+D+i+TT: Se busca mantener actualizados todos los documentos relacionados con estas áreas, definiendo claramente sus aspectos, alcances y lineamientos.
– Diseño e implementación de modelos de gestión de I+D+i+TT: Estos modelos deben considerar tanto las áreas internas como las externas de Duoc UC, favoreciendo la colaboración y contribución a la solución de problemas productivos y sociales.
– Actualización e implementación de procesos necesarios para llevar a cabo I+D+i+TT: El objetivo es esquematizar y unificar los procesos operativos en Duoc UC para facilitar su secuencia y funcionamiento, así como establecer procedimientos para el resguardo de la información y datos de los proyectos.
– Establecimiento de indicadores de proceso, resultados y seguimiento: Se implementarán indicadores para evaluar los procesos, iniciativas y resultados de la investigación aplicada, el desarrollo experimental, la innovación, el emprendimiento y la transferencia de tecnología y conocimiento.
– Homologación de la implementación de desarrollos tecnológicos y gestión de proyectos: Se implementarán desarrollos tecnológicos para el registro, control y seguimiento sistemático de la información a través de plataformas específicas.
– Comunicación de actividades y resultados de I+D+i+TT: Se busca posicionar a Duoc UC a través de una hoja de ruta que permita comunicar iniciativas y resultados hacia los diferentes públicos objetivos.
Observatorio Duoc UC / Anuario 2024 / página 65
Observatorio de la Educación Superior Técnico Profesional - Producción y gestión del conocimiento
Modelo de Transferencia
Simultáneamente, se implementó el Modelo de Transferencia en 2023, el cual busca optimizar la gestión del proceso de transferencia tecnológica y de conocimiento hacia el sector social y productivo, así como hacia la docencia, utilizando los resultados de la investigación, desarrollo e innovación (I+D+i). Este modelo también aborda la protección de activos intangibles, como derechos de autor, modelos de utilidad y marcas. Asimismo, promueve la comunicación y coordinación interna entre las distintas unidades, sedes y escuelas para sincronizar los calendarios académicos con los del entorno externo (social y productivo), facilitando así una mayor agilidad y eficiencia en los procesos.

Formación y diplomado
En otro ámbito, la Dirección de Investigación Aplicada, Innovación y Transferencia de Duoc UC ha alcanzado importantes logros en el desarrollo de programas formativos que potencian las capacidades de sus docentes en el ámbito de la investigación aplicada. Un ejemplo destacado es el “Diplomado de Metodologías Innovadoras con mención en Investigación Aplicada”, cuya primera versión se diseñó en 2019 como parte de la ruta formativa de la institución.
Inicialmente dirigido exclusivamente a docentes interesados en aplicar conceptos e investigaciones aplicadas para abordar problemas específicos, este diplomado constaba de cinco cursos con una duración de 110 horas. La primera edición se realizó en 2020, con 36 docentes seleccionados según criterios como el Índice de Desempeño Docente y la experiencia en investigación aplicada.
Observatorio Duoc UC / Anuario 2024 / página 66
Observatorio de la Educación Superior Técnico Profesional - Producción y gestión del conocimiento
Tras la primera versión, se realizó un rediseño en 2021, revisando contenidos y metodologías para responder a las necesidades y sugerencias de los participantes. El objetivo principal se centró en fortalecer las capacidades en I+D+i+TT dentro de la formación técnico profesional. El programa mantuvo su estructura de cinco cursos, ahora ofrecidos en modalidad online asincrónica, e incorporó metodologías ágiles para el desarrollo de proyectos de investigación aplicada e innovación.
El 74% de los docentes participantes en el diplomado lo aprobaron entre 2020 y 2023, lo que representa un desafío para la institución para fortalecer los mecanismos de acompañamiento para aumentar la tasa de finalización satisfactoria. La meta institucional es alcanzar un 75% de aprobación, consolidando así el impacto positivo de esta iniciativa en el desarrollo profesional de los docentes de Duoc UC.
Mecanismos
Actualmente, desde la DIAIT tenemos convocatorias que fomentan el Desarrollo Experimental, Escalamiento y Transferencia, Innovación Corporativa, Fondo de Congresos Nacionales e Internacionales, Publicaciones Científicas, Innovación Social, Artículos Científicos en Educación, Ventanilla Abierta y Matching Funds destinados a colaborar codo a codo con la industria. Otro mecanismo relevante es la entrega de apoyo, asesoría y seguimiento a postulaciones de proyectos de innovación a fondos externos de agencias públicas e instituciones privadas.
Las convocatorias de la Dirección de Investigación Aplicada, Innovación y Transferencia (DIAIT) las lideran docentes de Duoc UC y, según las bases, se requiere la participación de estudiantes como asistentes de investigación. De esta forma, los estudiantes pueden participar en la resolución de problemáticas y desafíos del mundo real presentes en la industria, mediante convocatorias, apoyo directo y diversas instancias formativas de investigación aplicada, innovación y transferencia.

Imagen N°2: Mecanismos DIAT
Observatorio Duoc UC / Anuario 2024 / página 67
Observatorio de la Educación Superior Técnico Profesional - Producción y gestión del conocimiento
Proyectos destacados DIAIT
En los últimos años, Duoc UC ha realizado actividades innovadoras que fomentan la colaboración entre estudiantes, profesores, graduados y empresas locales relevantes. Estas iniciativas han creado proyectos emblemáticos, algunos ya se han destacado en otras publicaciones e instancias como el informe de autoevaluación para el proceso de acreditación 2024.
Uno de los proyectos emblemáticos es el Hospital de Quillota, implementado por la Escuela de Comunicaciones en 2018. Este proyecto introduce un sistema de audio digital sonoterapéutico y musicoterapéutico en cirugías, con el objetivo de reducir la necesidad de sedantes y mejorar la experiencia de los pacientes.
Asimismo, el Water Membrane, desarrollado por la Escuela de Diseño en colaboración con Aguas Andinas en 2018, destaca por su enfoque en la precisión en la fabricación de productos a escala real a través de un prototipo virtual.
Otro proyecto relevante es el TAPI, liderado por la Escuela de Ingeniería en 2018, que se enfoca en la creación de recursos tecnológicos adaptativos para niños y jóvenes con discapacidad múltiple, promoviendo su inclusión y calidad de vida.
La transferencia de tecnologías sustentables para la producción de alimentos en situaciones de crisis es el objetivo del proyecto AYA Tecnologías, liderado por la Escuela de Diseño en 2018. Este proyecto tiene un impacto significativo en comunidades locales e internacionales.
La investigación sobre la viabilidad de incorporar materiales reciclados en la construcción, llevada a cabo por las Escuelas de Construcción y Comunicación en 2018 con el proyecto Ecoladrillos, es otro ejemplo destacado de innovación en Duoc UC.
El Guante POMO, desarrollado por las Escuelas de Diseño, Informática y Telecomunicaciones en 2020, es reconocido internacionalmente por su innovación en la rehabilitación de pacientes con lesiones cerebrales.
Además, proyectos como el Panel CLT de la Escuela de Construcción en 2021, el Modelo para instalar el sello humano y ético en Enfermería de la Escuela de Salud en 2022, y la implementación de módulos de la aplicación Cronapp en entornos de atención médica por parte de la Escuela de Salud en 2023, demuestran el compromiso de Duoc UC con la innovación en áreas diversas y relevantes para la sociedad actual.
Estos proyectos abordan una amplia gama de temas, desde la salud hasta la sostenibilidad, y destacan la importancia de la innovación en Duoc UC para abordar desafíos contemporáneos y generar impacto tanto a nivel local como internacional.
Transferencia desde la educación superior técnico profesional Finalmente, otra parte muy relevante del trabajo de DIAIT es la transferencia tecnológica y de conocimientos desde la Educación Superior Técnico Profesional hacia la docencia, la industria y la sociedad. En primer lugar, esta transferencia permite que las últimas investigaciones, metodologías y tecnologías desarrolladas en las instituciones educativas sean aplicadas en el entorno industrial, lo que contribuye a mejorar la competitividad y la capacidad de innovación de las empresas.
Observatorio Duoc UC / Anuario 2024 / página 68
Observatorio de la Educación Superior Técnico Profesional - Producción y gestión del conocimiento
Este ciclo de transferencia es el paso final de los procesos de investigación aplicada e innovación, donde se analizan y extraen tecnologías y conocimientos que sean útiles y relevantes para generar herramientas como recursos y materiales de aprendizaje propios de cada disciplina y escuela, que luego se insertan en las asignaturas y programas formativos que ofrece la institución. De esta forma, las mejoras en prácticas docentes y adaptaciones de la oferta formativa impactan de manera positiva en todos los estudiantes de la institución.
Además, la transferencia de conocimiento facilita la actualización de las habilidades y competencias de los trabajadores de la industria, lo que les permite adaptarse a los cambios tecnológicos y mejorar su desempeño laboral. Esto es especialmente relevante en un entorno en constante evolución, donde las empresas necesitan estar al día con las últimas tendencias y avances tecnológicos para mantener su relevancia en el mercado.
Por otro lado, la transferencia de conocimiento también promueve la colaboración y el trabajo en equipo entre la academia y la industria, lo que puede conducir a la generación de nuevas ideas y soluciones innovadoras. Esta colaboración puede manifestarse en la realización de proyectos de investigación conjuntos, programas de pasantías y prácticas profesionales, o en la participación de expertos de la industria en actividades educativas, como charlas y seminarios.
La transferencia de conocimiento desde la Educación Superior Técnico Profesional hacia la industria es fundamental para impulsar la innovación y el desarrollo tecnológico en el contexto actual. No solo permite aprovechar el potencial creativo y el conocimiento experto de las instituciones educativas, sino que también fortalece la capacidad de las empresas para adaptarse y prosperar en un entorno competitivo y en constante cambio.
20 de mayo de 2024
Observatorio Duoc UC / Anuario 2024 / página 69
Observatorio de la Educación Superior Técnico Profesional - Producción y gestión del conocimiento
Converge iCorp 24
Al culminar este ciclo académico, la experiencia vivida en Converge iCorp 24, el jueves 28 de noviembre, revela una de las fortalezas más significativas de Duoc UC: la capacidad de innovar al interior de la propia institución, impulsando ideas generadas por colaboradores que conocen el pulso de cada sede, cada proceso y cada desafío formativo. Este encuentro, realizado en Casa Central bajo el liderazgo del rector Carlos Díaz, y con la participación de autoridades como Catalina Petric, directora de Investigación Aplicada, Innovación y Transferencia, Paola Araya directora de la sede Viña del Mar de Duoc UC, la asistencia de múltiples autoridades relevantes de la institución, y con la charla para finalizar el Seminario de Marcos Singer, director del MBA UC y Profesor Titular de la Escuela de Administración de la Pontificia Universidad Católica de Chile, dejó de manifiesto que la creatividad es un recurso latente en nuestra organización, un potencial que, bien canalizado, puede traducirse en mejoras sustanciales y cambios duraderos en la experiencia educativa.
La presencia de autoridades clave reforzó el mensaje de que la innovación no es exclusiva de un área, sino que emerge desde diversos ámbitos. Esta dispersión creativa, en lugar de fragmentar esfuerzos, enriquece la visión institucional, abriendo caminos que permiten aprovechar las múltiples perspectivas, conocimientos y experiencias que convergen en Duoc UC.
La innovación al interior de la institución no solo habilita la optimización de procesos o la adopción de nuevas herramientas digitales; también construye y consolida una cultura donde la creatividad se instala como un hábito. Cada idea novedosa, cada proyecto mejorado, cada desafío resuelto con ingenio, refuerza la noción de que Duoc UC puede y debe seguir avanzando con agilidad y firmeza hacia los horizontes que demanda la Educación Técnico Profesional contemporánea.
En este sentido, los resultados recientes de los proyectos de Innovación Corporativa dejan clara la magnitud de este esfuerzo. Duoc UC, acreditada por tercera vez consecutiva con el máximo nivel entregado por la CNA, se erige como la primera institución de Educación Superior Técnico Profesional chilena reconocida por la CNA en investigación, creación e innovación. Esta distinción se traduce en logros concretos: La digitalización de más de 92 tareas operativas, el ahorro de 747 horas en reprocesos y la reducción de más de 90 mil hojas impresas, lo que confirma el compromiso con la sustentabilidad y la eficiencia. Además, la cantidad de proyectos impulsados ha pasado de 166 en 2022 a 272 en 2024, al tiempo que la participación de colaboradores aumentó de 264 a 809, evidenciando un crecimiento orgánico de esta cultura innovadora.
Esta dinámica interna, forjada en la conjunción de talento, experiencia y visión estratégica, no se limita a la obtención de resultados operativos: Se extiende hasta el modelo educativo, el ambiente laboral, la interacción con el entorno y la calidad de la formación que ofrecemos. Así, Converge iCorp 24 fue mucho más que un hito aislado: Actuó como catalizador para situar la innovación y la creatividad en el centro de nuestra identidad institucional, recordándonos que, al valorarlas, potenciarlas y compartirlas, garantizamos la capacidad de adaptación, excelencia y trascendencia que nos distingue.
Observatorio Duoc UC / Anuario 2024 / página 70
Observatorio de la Educación Superior Técnico Profesional - Producción y gestión del conocimiento
De este modo, Duoc UC asume el liderazgo que corresponde a una institución comprometida con su tiempo y su entorno, dispuesta a explorar nuevas rutas sin apartarse de su misión fundamental: Formar profesionales capaces de enfrentar el futuro con solvencia, ingenio y criterio. La innovación interior, tejida a partir del aporte de cada uno de sus actores, surge como el verdadero motor que impulsa su constante crecimiento, consolidando su posición como referente en la Educación Técnico Profesional y proyectándola hacia oportunidades que aún están por descubrirse.
9 de diciembre de 2024
Equipo Editorial del Observatorio Duoc UC
Observatorio Duoc UC / Anuario 2024 / página 71
Observatorio de la Educación Superior Técnico Profesional - Producción y gestión del conocimiento
Editorial I+D+i+TT
en Duoc UC

Carlos Díaz Vergara Rector Duoc UC
Hoy las instituciones educativas enfrentan el desafío constante de adaptarse y evolucionar para preparar a sus estudiantes de manera efectiva. Es un tiempo dinámico, de cambios rápidos, que requieren de estrategias sostenibles. Duoc UC lo ha trazado desde 2007, con una trayectoria en formación en competencias básicas de innovación y emprendimiento para la totalidad de sus estudiantes, a través del Programa de Innovación y Emprendimiento que conduce la Vicerrectoría Académica.
A partir de 2016, y en el marco de un proceso reflexivo y de recopilación de nuestro quehacer, Duoc UC decidió avanzar en constituirse en un actor relevante para desarrollar innovación, investigación aplicada y transferencia. La institución ha definido y madurado políticas y mecanismos que orientan y priorizan los esfuerzos en la materia, así como un enérgico fomento en la innovación corporativa.
Los diversos proyectos e iniciativas de aplicación de la política y estrategia institucional de I+D+i+TT se encaminan a la generación de capacidades y articulación con organizaciones significativas de un ecosistema en formación.
Sin perjuicio de lo anterior, en los próximos años Duoc UC se propone aumentar en volumen, calidad y contribución de las actividades de I+D+i+TT, ampliar la generación de capacidades en docentes, ser parte del ecosistema para estrechar lazos con empresas, fortalecer el liderazgo de las escuelas para un mayor desarrollo disciplinar de proyectos asociados, y luego traspasar todo este conocimiento a la docencia.
Observatorio Duoc UC / Anuario 2024 / página 72
Observatorio de la Educación Superior Técnico Profesional - Producción y gestión del conocimiento
¿Por qué potenciar las funciones de I+D+i+TT?
Duoc UC ha diseñado una política institucional, acompañada de una estrategia y gobernanza que buscan impulsar y articular la innovación, el emprendimiento, la investigación aplicada y la transferencia tecnológica, desde una lógica de vinculación con el entorno social y productivo, e integrado al ecosistema de innovación y emprendimiento. Todo este esfuerzo se basó en un diagnóstico, construido colectivamente, que apunta a superar estados incipientes de desarrollo en algunos aspectos que son condiciones básicas habilitantes para un mayor crecimiento y avance:
Falta de claridad respecto de las capacidades y recursos académicos para desarrollar I+D+i+TT, incluyendo el potencial de nuestros docentes y áreas de interés donde realizar estas actividades.
Conveniencia de definir áreas prioritarias de desarrollo para un posicionamiento diferenciador en el ecosistema.
Necesidad de activar e impulsar una red de contactos y alianzas con empresas u otras organizaciones que estimularan una participación activa de Duoc UC en concursos y plataformas de financiamiento público-privadas.
Se observaba una baja sistematización de los resultados y contribuciones de los proyectos e iniciativas de I+D+i+TT desarrollados por la institución a la fecha.
Baja participación de Duoc UC en los ecosistemas de I+D+i+TT y, con ello, el desaprovechamiento de vínculos naturales con académicos y centros de la Universidad Católica.
El tamaño de Duoc UC había hecho priorizar la inversión en un mayor volumen de cursos de formación en competencias básicas en innovación y emprendimiento para estudiantes, en desmedro de la capacidad para identificar acciones de alto impacto como contribución a la sociedad.
Este diagnóstico se cristalizó en una insuficiente estructura organizacional (inexistencia de una unidad interna a cargo), falta de objetivos de I+D+i+TT en los planes de las escuelas, y junto a ello, un marco de soporte institucional (políticas, mecanismos, apoyos e incentivos) no apropiado para promover con mayor intensidad la I+D+i+TT en Duoc UC.
¿Cuáles han sido las principales acciones estratégicas para potenciar la I+D+i+TT?
Actualización de estructura, lineamientos y gobernanza
Duoc UC actualizó la Política de Investigación Aplicada e Innovación (2022) para alinearla al Modelo Educativo y Plan de Desarrollo 2021-2025. Este instrumento proporciona los lineamientos transversales para el desarrollo de I+D+i+TT, buscando enriquecer la propuesta formativa, potenciando la vinculación con el sector productivo, con el fin de responder problemáticas tecnológicas y sociales que provengan del medio.
Observatorio Duoc UC / Anuario 2024 / página 73
Observatorio de la Educación Superior Técnico Profesional - Producción y gestión del conocimiento
Destacan como acciones:
Creación de una nueva unidad especializada en I+D+i+TT, dependiente de Rectoría para agilizar su funcionamiento y apoyar el desarrollo de las escuelas en la materia.
Reenfoque de la gobernanza vigente, incorporando la innovación corporativa como eje estratégico de desarrollo. Se definieron formalmente modelos de gestión y transferencia de I+D+i+e+TT, considerando las áreas internas y externas y secciones habilitadoras que permitan dinamizar el ecosistema Duoc UC.
Establecimiento claro de roles al interior del ecosistema creado, cuya unidad facilite el trabajo con las escuelas y sus docentes en detectar necesidades del sector social y productivo con el fin de dar soluciones a problemáticas reales del entorno relevante, aprovechando los vínculos con la Universidad Católica.
Activación del ecosistema, mediante convocatorias internas de financiamiento, acompañamiento técnico en postulaciones, constitución y funcionamiento de Comité I+D+i+TT, y aumento del portafolio de emprendedores, entre otras acciones.
Promoción y liderazgo de las escuelas en el desarrollo de la I+D+i+TT, por medio de los/ as docentes, de manera que el área central sea un soporte en la facilitación de alianzas, búsqueda de financiamiento externos, difusión y comunicación de resultados.
Inversión de más de 300 millones en Plan de Desarrollo durante 2023 y 2024 para la implementación de iniciativas estratégicas de promoción de la investigación aplicada e innovación interna.
Formación de capacidades
Duoc UC ha destinado esfuerzos y recursos en conocer en profundidad y capacitar a sus docentes, junto con promover concursos y proyectos específicos que nos han planteado algunas empresas u organizaciones, para ir generando capacidades e ir visualizando dónde pareciera ser más conveniente continuar profundizando en el futuro. Se trata de sembrar con amplitud para cosechar con mayor especificidad, al objeto de acotar áreas y temas de interés.
Destacan como acciones:
Creación de trayectoria formativa para docentes, fomentando el desarrollo de competencias y capacidades asociadas a la investigación aplicada e innovación.
Perfiles docentes asociados a investigación aplicada, desarrollo experimental, innovación y transferencia: a medida que las direcciones de las escuelas han ido incorporando en sus equipos directores con perfil de investigación, se les ha ido solicitando que propongan temáticas o áreas de interés para seguir explorando áreas donde podamos lograr concentrar esfuerzos.
Dedicación horaria y remunerada de docentes para realizar actividades de I+D+i+TT.
Cursos y talleres relacionados con I+D+i+e+TT, buscando reforzar los conocimientos de los/as docentes en temáticas que son importantes para el desarrollo de proyectos de investigación aplicada, desarrollo experimental, innovación, emprendimiento y transferencia.
Observatorio Duoc UC / Anuario 2024 / página 74
Observatorio de la Educación Superior Técnico Profesional - Producción y gestión del conocimiento
Priorización de escuelas y líneas de investigación
Frente a recursos limitados, se ha implementado un mecanismo de priorización de escuelas, que busca alinear los esfuerzos y recursos institucionales para resolver desafíos del entorno social y productivo asociados disciplinariamente.
La definición de áreas preliminares con algunas escuelas se ha realizado sobre la base de criterios como:
Los resultados de proyectos de I+D+i+TT adjudicados por Escuelas con financiamiento externo.
Aquellos temas donde hay mayor interés por parte de empresas u otras organizaciones para desarrollar un trabajo colaborativo.
La evaluación previa de las capacidades y recursos docentes.
Las escuelas priorizadas tienen acceso preferencial a los fondos internos entregados por Duoc UC mediante concursos de I+D+i+TT y, a su vez, son beneficiarias principales de los fondos externos adjudicados por la institución. Respecto de las horas asignadas para actividades de I+D+i+TT, dentro del perfil docente investigador, la selección de ellos/as pondera su pertenencia a las escuelas priorizadas.
¿Cuáles son los resultados que buscamos con la I+D+i+TT?
Aportar al bienestar y desarrollo productivo de la sociedad
El mayor aporte que podemos ofrecer a la sociedad por medio de la investigación aplicada, la innovación y la transferencia, es descubrir nuevas formas de hacer, y que distintas organizaciones que componen la sociedad funcionen y se desarrollen mejor, ofreciendo un nuevo conocimiento en el uso de técnicas y servicios que contribuyan en su progreso integral y de excelencia.
Nuestros docentes buscan mantenerse al día en lo que está sucediendo en sus áreas en distintos países del mundo. Entre otras cosas, esto les permite identificar tecnologías que se están utilizando y que no se han aplicado en Chile. A través de la transferencia tecnológica, lo que se logra es apoyar a empresas y otras organizaciones, públicas y privadas, a usar estas tecnologías de vanguardia en sus procesos, productos y servicios, y con ello incrementar su productividad y el bienestar de los usuarios.
Hoy en el mundo existe una enorme cantidad de investigación básica en diversas ciencias que, por medio de publicaciones y seminarios de difusión, se encuentran disponibles para que cualquier persona acceda a ella. Este conocimiento constituye la base a partir de la cual se desarrolla la investigación aplicada, que busca utilizar parte de este conocimiento para comprender y resolver problemas específicos. Si bien el nuevo conocimiento que se genera queda circunscrito a un caso en particular, luego éste se puede hacer extensible a otras problemáticas similares. Por medio de la innovación, queremos contribuir a la detección de oportunidades de aporte a la sociedad, desarrollando proyectos innovadores que agreguen valor a contextos sociales y productivos, a la vez que generan alternativas de modelos de negocios, introduciendo o mejorando significativamente bienes y servicios en empresas, organizaciones y comunidades, haciéndonos cargo de desafíos de futuro.
Observatorio Duoc UC / Anuario 2024 / página 75
Observatorio de la Educación Superior Técnico Profesional - Producción y gestión del conocimiento
Potenciar el desarrollo académico de los docentes
La realización de cualquiera de estas actividades de I+D+i+TT potencia al docente en:
Mantenerse al día en el nuevo conocimiento que se genera y que permite la actualización de sus diversos campos de especialización técnica.
Crear redes de contacto con docentes e investigadores de otras instituciones académicas o de investigación.
Le ayuda a nutrir su experiencia práctica por medio de la aplicación de nuevo conocimiento a la resolución de casos y desafíos reales de empresas y otras organizaciones.
Incrementa sus redes de contacto con diversas empresas e instituciones, lo que a su vez genera un círculo virtuoso toda vez que lo invitan a seguir colaborando en el futuro y así se va compartiendo nuevo conocimiento y nuevas aplicaciones.
El nuevo conocimiento adquirido por algunos docentes es socializado con otros docentes a través del trabajo que sea realiza a nivel de líneas de conocimiento.
Aportar al aprendizaje y empleabilidad de nuestros estudiantes
Los resultados de los proyectos de I+D+i+TTse ven reflejados en:
Mejora en las clases impartidas al tener docentes que están en la vanguardia del conocimiento y de la experiencia práctica.
Los resultados obtenidos de los casos particulares de I+IA+TT dan lugar a material de estudio y aplicaciones en diversos cursos por medio de su integración en las maletas didácticas.
Aunque no es masivo, en ocasiones hay estudiantes que participan como ayudantes en alguno de estos proyectos.
Mientras más redes tengan los docentes, mejores serán los desafíos reales que pueden traer a sus clases para que sus estudiantes puedan trabajar en ellos junto a ejecutivos de empresas o instituciones.
A mayor prestigio y calidad de los docentes se puede esperar una mejor empleabilidad de sus egresados, ya sea por contacto directo por medio de recomendaciones, como por prestigio académico.
El conocimiento que adquieren los docentes les permite proponer y aportar a la generación de nueva oferta de carreras técnicas o profesionales así también la creación de nuevas certificaciones o diplomados de educación continua.
Observatorio Duoc UC / Anuario 2024 / página 76
Observatorio de la Educación Superior Técnico Profesional - Producción y gestión del conocimiento
Cumplir con la misión de una institución de educación superior católica
Una institución de educación superior católica, concebida desde el corazón de la Iglesia, siempre se ha destacado como un centro incomparable de creatividad y de irradiación del saber en benefi cio de la humanidad[1].
Toda investigación aplicada e innovación, ya sea en tecnología, procesos, programas de estudio, talleres prácticos, ideas u otros ámbitos, implica un cambio significativo destinado a renovar o revitalizar algo. Duoc UC se encuentra inmerso en la sociedad, y en su compromiso de servicio a la Iglesia, se le exige ser un instrumento eficaz de progreso en el conocimiento disciplinar y cultural, tanto para las personas como para la sociedad, dentro de su ámbito de competencia. En este sentido, y tal como señala la Constitución Apostólica Ex Corde Ecclesiae de 1990[2], los esfuerzos de Duoc UC en el campo de la investigación aplicada, la innovación y la transferencia tecnológica deben abarcar el estudio de los problemas graves que afectan a la sociedad contemporánea. Entre ellos se encuentran cuestiones como la dignidad de la vida humana, la promoción de la justicia para todos, la mejora de la calidad de vida individual y familiar, la protección del medio ambiente, la búsqueda de la paz y la estabilidad política, el crecimiento económico, una distribución más equitativa de los recursos a nivel global, y una visión de sociedad que sirva mejor a la comunidad humana tanto a nivel nacional como internacional. El espíritu cristiano de servicio a los demás en la promoción de la justicia social reviste particular importancia para cada institución de educación superior católica y debe ser compartido por los docentes y fomentado entre los estudiantes[3] .
En esta urgencia por el prójimo es que Duoc UC, puede hacer que el creciente acervo de conocimientos humanos y una comprensión siempre mejor de la fe puedan ponerse a disposición no solo de la comunidad educativa, sino de un público más amplio extendiendo los servicios más allá de los límites propiamente académicos, permitiendo a los docentes estar disponibles para servicios de asesoría, sirviéndose de los modernos medios de comunicación y en varios otros modos. Recientemente, el Papa Francisco expresó que, si tuviera que traducir la palabra ‘misión’ al ámbito académico, utilizaría el término ‘investigación’. El investigador posee una mentalidad y un corazón misioneros. No se conforma con lo que sabe, va en busca de nuevos conocimientos. Reconoce la importancia de estar abierto y sorprenderse por lo que descubrirá. Esta tensión entre el saber y el desconocimiento impulsa su avance y lo protege de la presunción de creer que lo sabe todo. Así mismo, el investigador debe estar dispuesto a salir y dejarse enseñar. En última instancia, el Papa Francisco invita a las instituciones de educación superior católicas a convertirse en reconocidos y valorados centros de investigación en el mundo, ya que de esta manera también se formarán mentes misioneras[4] .
[1] Cfr. Constitución Apostólica Ex Corde Ecclesiae, 1 también la formación ética, ciudadana y social de los individuos.
[2] La Constitución Apostólica Ex Corde Ecclesiae fue publicada en agosto de 1990 por el Pontífice San Juan Pablo II y aborda aspectos fundamentales del quehacer de las instituciones de educación superior católicas.
[3] Cfr. Constitución Apostólica Ex Corde Ecclesiae, 33.
[4] Papa Francisco, 4 de mayo 2023, Discurso a los participantes en el congreso de la Organización de Universidades Católicas de América Latina y el Caribe (Oducal).
Observatorio Duoc UC / Anuario 2024 / página 77
Observatorio de la Educación Superior Técnico Profesional - Producción y gestión del conocimiento
En la misma línea, el Papa Francisco, en su último encuentro con los rectores de universidades católicas de América Latina y el Caribe, hace un llamado a seguir colaborando con ideas y proyectos inspirados en el Pacto Educativo Global[5] como un signo de la catolicidad de la mente, del corazón y de las manos.
Aportar a la Visión, reconocimiento y prestigio de Duoc UC
Mientras mayor sea la calidad académica de sus docentes en términos de nuevo conocimiento y su aplicación, mayor será el prestigio y reconocimiento de Duoc UC, mejorando la posibilidad de alcanzar su visión de ser reconocida del ámbito técnico profesional para la formación de personas, distinguida por la pertinencia de su preparación disciplinar, humana y ética, e inspirada en la identidad católica”. Esto indica que la institución tiene un compromiso con la excelencia académica y busca ser un referente en sus áreas técnicas y profesionales.
Para mantenernos a la vanguardia, es imperativo abrazar un enfoque integral que promueva la innovación, de manera de estar abiertos a aprender y a utilizar todo avance científi co y tecnológico que nos permita más aprendizajes logrados en nuestros estudiantes y una creciente excelencia en nuestras tareas académicas y administrativas.
La promoción de la innovación, investigación aplicada y transferencia tecnológica, se constituyen en pilares fundamentales de nuestra comunidad educativa. Más aprendizaje práctico en investigación, mayor la colaboración entre escuelas y nuevas alianzas estratégicas con la industria, permitirán no solo mantenernos actualizados sino también liderar el camino hacia el futuro.
27 de mayo de 2024
[5] El Pacto Educativo Global es una iniciativa propuesta por el Papa Francisco y respaldada por la Santa Sede, con el objetivo de promover la solidaridad y la colaboración internacional en el ámbito de la educación. Fue lanzado oficialmente el 15 de octubre de 2020. Busca renovar el compromiso de la comunidad internacional con la educación, reconociendo su importancia para el desarrollo integral de las personas y para construir un mundo más justo y fraterno. Propone un enfoque holístico de la educación que abarque no solo la transmisión de conocimientos, sino también la formación ética, ciudadana y social de los individuos.
Observatorio Duoc UC / Anuario 2024 / página 78
Observatorio de la Educación Superior Técnico Profesional - Producción y gestión del conocimiento
Innovación en las sedes de Duoc UC:
Impulsando la excelencia educativa
La innovación es una práctica que impulsa a Duoc UC hacia la excelencia educativa, reafirmando nuestro compromiso con la formación técnico profesional de nivel superior. En este boletín N°67, destacamos cómo nuestra institución se adapta y evoluciona, promoviendo prácticas innovadoras en su quehacer y soluciones tecnológicas que impactan directamente en el proceso educativo y la comunidad nacional.
En tal sentido, Roberto Ríos nos expresa en su columna: “Si queremos, en Duoc UC, hablar de creatividad, de innovación o de generación de ideas, necesariamente volvemos nuestra mirada a quien inspira este Proyecto Educativo, miramos a Dios, nuestro Creador, pues la creatividad es un don de Dios. Desde esta perspectiva, la capacidad de imaginar, crear y desarrollar ideas es una manifestación del espíritu divino en el ser humano”.
En Duoc UC, la innovación no es solo una palabra de moda: Es una estrategia fundamental que permea todos los niveles de nuestra institución. Nuestra misión se centra en proporcionar a los estudiantes un entorno de aprendizaje integral, multidisciplinario y con sentido trascendente. Este enfoque se manifiesta en diversas iniciativas que abarcan desde la digitalización de prácticas académicas, más vinculación con el medio, ayudar a la Educación Media y hasta la implementación de metodologías interactivas.
Dado lo anterior, los coordinadores zonales Pedro Troncoso y Rodrigo Lagos que escriben la columna introductoria y conceptual del Boletín, nos expresan: “La innovación debe ser parte integral de nuestra cultura organizacional. Esto significa que cada miembro de nuestra comunidad educativa, desde estudiantes y profesores, hasta el personal administrativo, debe sentirse empoderado para proponer y experimentar nuevas ideas. Fomentar un ambiente donde la creatividad y la colaboración sean valores fundamentales es clave para mantenernos a la vanguardia y, de esta manera, entregar una educación superior integral y de excelencia”.
La vinculación con el medio es un aspecto crucial en nuestro Modelo Educativo. Esta conexión permite a nuestros estudiantes aplicar sus conocimientos en contextos reales, fomentando la responsabilidad social y el compromiso con la comunidad. La vinculación con el medio no solo enriquece la experiencia educativa, sino que también fortalece el tejido social, creando un impacto positivo en las comunidades locales y en la sociedad en general.
La colaboración entre diferentes Unidades y la inclusión de enfoques creativos y tecnológicos en el aula aseguran que nuestros egresados estén preparados para enfrentar los desafíos del mundo laboral. La educación dual y los programas de acompañamiento académico son ejemplos claros de cómo la teoría y la práctica se unen para formar profesionales competentes y adaptables. La educación dual, en particular, permite a los estudiantes combinar su formación académica con experiencias prácticas en empresas, lo que les proporciona una visión más completa y realista del entorno laboral.
Observatorio Duoc UC / Anuario 2024 / página 79
Observatorio de la Educación Superior Técnico Profesional - Producción y gestión del conocimiento
El espíritu de innovación en Duoc UC no solo mejora la calidad educativa, sino que también fortalece los lazos comunitarios, promoviendo un entorno donde la creatividad, el esfuerzo y la excelencia académica son reconocidos y valorados. Este espíritu se refleja en la implementación de programas experimentales en innovación educativa que preparan a los docentes para enfrentar los desafíos de las nuevas generaciones, como la generación alpha, y en el desarrollo de herramientas tecnológicas que facilitan la gestión y el aprendizaje.
Invitamos a toda nuestra comunidad a conocer estas experiencias escritas en el Boletín N°67, y a seguir construyendo juntos un futuro lleno de oportunidades y logros. Con estas iniciativas, reafirmamos nuestra identidad católica y nuestro compromiso de colocar al estudiante en el centro de todas nuestras actividades, fomentando un aprendizaje significativo y una formación integral que trasciende las aulas. La identidad cristiana de Duoc UC impregna todas nuestras acciones y decisiones, guiándonos en nuestra misión de formar profesionales íntegros y comprometidos con el bienestar de la sociedad.
Ver Boletín 67 en https://observatorio.duoc.cl/boletin/boletin-n67-algunas-innovaciones-en-las-sedes-de-duoc-uc/
5 de agosto de 2024
Equipo Editorial del Observatorio Duoc UC
Observatorio Duoc UC / Anuario 2024 / página 80
Observatorio de la Educación Superior Técnico Profesional - Producción y gestión del conocimiento
La Educación Superior Técnico Profesional
(ESTP) en el contexto actual y futuro
Observatorio Duoc UC / Anuario 2024 / página 81
Observatorio de la Educación Superior Técnico Profesional - Producción y gestión del conocimiento
Aprendizaje permanente:
El rol esencial de las instituciones educativas en la era digital
Desde hace algunas décadas, el concepto de “aprendizaje a lo largo de la vida” ha ganado prominencia en seminarios y la literatura especializada. Este enfoque reconoce la diversidad de formas en que las personas adquieren conocimientos y competencias, distinguiendo entre el aprendizaje formal, no formal e informal. Se entiende que aprender no se limita a los entornos académicos tradicionales, sino que ocurre en la vida familiar, social y en diversos contextos educacionales e institucionales.
En 1970, la Unesco declaró ese año como el “Año Internacional de la Educación” y presentó por primera vez el concepto de “life long integrated education”, traducido como “educación permanente”. Posteriormente, en 1996, la Unión Europea adoptó el término “aprendizaje a lo largo de la vida” y dedicó ese año a promoverlo. El Consejo Europeo de Lisboa, en marzo del 2000, reafirmó que el conocimiento sería la base para transformar Europa en un continente fuerte y dinámico. En junio de ese mismo año, el Consejo Europeo de Feira instó a los Estados miembros a definir estrategias coherentes y medidas prácticas para fomentar la educación permanente para todos. Europa aspiraba a liderar mediante una economía competitiva basada en el conocimiento, capacitando a sus ciudadanos para trabajar en cualquier país de la Comunidad Europea.
Desde el Consejo Europeo de Lisboa en 2000, se entiende que el aprendizaje permanente abarca toda la vida de una persona, desde la etapa gestacional hasta la jubilación. Este aprendizaje se categoriza en tres tipos: formal, no formal e informal. El aprendizaje formal se obtiene en centros educativos establecidos y reconocidos, donde existe una sistematización del acto de enseñar y una certificación al finalizar. El aprendizaje no formal, aunque puede ocurrir en instituciones formales, no necesariamente resulta en una certificación. Por último, el aprendizaje informal se produce en cualquier ambiente no institucionalizado, como la familia, el trabajo y la vida cotidiana, y se adquiere de manera natural al convivir y participar en una cultura.
La distinción entre estos tipos de aprendizaje, junto con los avances tecnológicos y las diversas plataformas disponibles, nos lleva a reconocer la multiplicidad de espacios e instrumentos para aprender. Surge entonces la pregunta ¿cómo deben actualizarse las instituciones educativas para enfrentar no solo las competencias tradicionales, sino también aquellas emergentes en el entorno digital? Las instituciones educativas mantienen su relevancia decisiva en el desarrollo de la empleabilidad futura de los educandos, ofreciendo aprendizajes estructurados y certificaciones que validan lo aprendido, respaldadas por el prestigio y la tradición institucional.
En esta concepción profunda del aprendizaje a lo largo de la vida, las instituciones técnico-profesionales pueden desempeñar un papel crucial y multifacético. No se trata solo de ofrecer títulos técnicos o profesionales post educación media, sino también de profundizar en el reconocimiento de aprendizajes obtenidos en entornos informales. Instituciones sólidas y de calidad pueden ofrecer servicios de validación de estudios y competencias adquiridas de manera autónoma por empresas, configurándose como aliadas capacitadoras que acreditan y transfieren competencias a lo largo de la vida laboral de las personas.
Observatorio Duoc UC / Anuario 2024 / página 82
Observatorio de la Educación Superior Técnico Profesional - Producción y gestión del conocimiento
Y dado que hoy nos encontramos en la era digital y con una velocidad de cambios tecnológicos nunca antes observados en la historia, la pregunta es: ¿cómo enfrentamos hoy el aprendizaje a lo largo de la vida?
Las instituciones técnico-profesionales están adaptando sus enfoques educativos para responder a la velocidad sin precedentes de los cambios tecnológicos. La integración de herramientas digitales avanzadas como las plataformas de aprendizaje en línea, inteligencia artificial y realidad aumentada, permite una personalización del proceso educativo que se ajusta a las necesidades individuales de los estudiantes. Estas tecnologías no solo facilitan el acceso a recursos educativos desde cualquier lugar y en cualquier momento, sino que también fomentan métodos de enseñanza interactivos y colaborativos que mejoran la retención de conocimientos y la aplicación práctica de competencias.
Se están revisando y actualizando constantemente sus currículos para incluir habilidades y competencias emergentes que son esenciales en el mercado laboral actual. Programas de reciclaje profesional y formación continua se han convertido en pilares fundamentales, ofreciendo cursos cortos, certificaciones digitales y talleres especializados que permiten a los profesionales en activo actualizar sus conocimientos sin interrumpir su carrera. Al colaborar estrechamente con la industria y el sector privado, las instituciones aseguran que sus programas educativos estén alineados con las demandas reales del mercado.
Parece necesario una actualización significativa de las habilidades y conocimientos de los docentes no solo como una responsabilidad exclusiva de las instituciones, sino también como una autorregulación profesional de cada uno de estos. Estos deben estar informados y capacitados en las innumerables posibilidades que hoy nos proporcionan las distintas herramientas tecnológicas para lograr en los estudiantes más y mejores aprendizajes. Además, es tan significativo el cambio ad portas, que se requiere una reflexión sustancial de cómo debería ser el aprendizaje permanente dado todos los instrumentos que hoy tenemos a nuestra disposición. Los temas cruciales son cómo respondemos a las necesidades de aprendizaje para el futuro y de cómo tenemos que convivir con los avances extraordinarios que hoy observamos. Por último, es necesario transmitir la idea y convicción que todo instrumento debe estar siempre al servicio de la persona y sus valores humanos y no las personas al servicio de las cosas.
7 de octubre de 2024
Equipo Editorial del Observatorio Duoc UC
Observatorio Duoc UC / Anuario 2024 / página 83
Observatorio de la Educación Superior Técnico Profesional - Producción y gestión del conocimiento
Boletín N°69 Observatorio Duoc UC:
Algunas estrategias metodológicas activas para el aprendizaje que hoy se aplican en Duoc UC
La Educación Técnico Profesional (ETP) enfrenta el desafío de formar técnicos y profesionales que no solo respondan a las demandas del entorno laboral actual, sino que también sean capaces de anticiparse a los cambios y adaptarse a un futuro incierto. En este contexto, las estrategias metodológicas activas han emergido como herramientas clave, promoviendo un aprendizaje significativo y centrado en el estudiante.
La reciente recopilación de experiencias en Duoc UC, plasmada en este Boletín N°69, demuestra cómo estas estrategias han transformado los procesos de enseñanza-aprendizaje. Al incorporar metodologías como el Aprendizaje Basado en Proyectos (Abpro), la Simulación, y el Análisis de Casos, entre otras, se ha logrado crear un entorno en el que el estudiante no solo adquiere conocimientos técnicos, sino que también desarrolla competencias transversales, esenciales para el mundo laboral.
Agradecemos toda la colaboración de la Dirección de Formación y Desarrollo Docente liderado por Sebastián Sánchez Díaz, y la Subdirección de Formación Docente con Ricardo Zagal, Carmen Barría, Karina Carrasco y Óscar Sepúlveda, que realizaron un aporte relevante en el acompañamiento a los distintos columnistas para explicarles el sentido, las características del nuevo Boletín y siempre dispuestos para ayudarlos en lo que necesitaran. Asimismo, los columnistas nos muestran con su experiencia que las estrategias activas para lograr aprendizajes son muy variadas en Duoc UC, y ellos nos aportan su experiencia individual en los distintos espacios de aprendizajes en la institución.
A juicio del Vicerrector Académico de Duoc UC, Kiyoshi Fukushi Mandiola: “Las estrategias metodológicas activas implementadas en la institución, además de impartir conocimientos técnicos, también desarrollan habilidades y valores que permitan a los estudiantes contribuir de manera significativa a la sociedad. Al promover el aprendizaje activo y el desarrollo de competencias transferibles, Duoc UC cumple con su misión de formar técnicos y profesionales altamente capacitados, comprometidos y éticos”.
El Aprendizaje Basado en Proyectos destaca por su capacidad de vincular a los estudiantes con problemas reales del entorno laboral. Esta estrategia permite que enfrenten desafíos auténticos, promoviendo el pensamiento crítico, la creatividad y la resolución de problemas complejos. Por otro lado, la Simulación ofrece una experiencia controlada pero realista, en la que los estudiantes pueden aplicar sus conocimientos en contextos similares a los que enfrentarán en sus futuras profesiones.
Un punto crucial en estas metodologías es su capacidad para integrar valores éticos y sociales en el proceso educativo. El Aprendizaje + Servicio, por ejemplo, conecta el aprendizaje académico con el compromiso comunitario, fomentando en los estudiantes una conciencia ética y social alineada con los valores institucionales. Este enfoque no solo prepara a los estudiantes para ser profesionales competentes, sino también ciudadanos responsables.
Observatorio Duoc UC / Anuario 2024 / página 84
Observatorio de la Educación Superior Técnico Profesional - Producción y gestión del conocimiento
La implementación efectiva de estas estrategias requiere un compromiso colectivo. Autoridades académicas, docentes y estudiantes trabajan de manera colaborativa para asegurar que estas metodologías no solo sean adoptadas, sino también adaptadas a las necesidades específicas de cada contexto educativo. La capacitación docente, la adecuación de infraestructuras y el diseño curricular en Duoc UC se alinean con este enfoque centrado en el estudiante.
Los egresados de programas que implementan metodologías activas no solo poseen competencias técnicas, sino también habilidades interpersonales, adaptabilidad y una mentalidad innovadora. Estas cualidades, creemos, podrían posicionarlos como profesionales altamente valorados en un mercado laboral en constante evolución.
Las estrategias metodológicas activas representan una evolución necesaria en la ETP. Al colocar al estudiante en el centro del proceso de aprendizaje, no solo se transforma la experiencia educativa, sino que también se contribuye al desarrollo de técnicos y profesionales capaces de liderar el cambio en sus respectivas áreas. Este enfoque, alineado con el modelo educativo de Duoc UC, reafirma el compromiso institucional con la formación integral y la excelencia académica.
Ver Boletín N°69: https://observatorio.duoc.cl/boletin/boletin-n69-diciembre-2024/
3 de diciembre de 2024
Equipo Editorial del Observatorio Duoc UC
Observatorio Duoc UC / Anuario 2024 / página 85
Observatorio de la Educación Superior Técnico Profesional - Producción y gestión del conocimiento
Competencias, capacidades y
empleabilidad: Lo que las empresas hoy buscan
En el dinámico y cambiante mundo laboral del siglo XXI, las competencias y capacidades de los trabajadores han cobrado una relevancia sin precedentes. Las empresas ya no solo buscan empleados con títulos y diplomas, sino personas capaces de adaptarse, resolver problemas y aprender de manera continua. Este cambio de enfoque ha impactado de manera directa tanto en el mercado laboral como en los sistemas educativos, que han tenido que replantear sus estrategias formativas para preparar a individuos que respondan a estas nuevas demandas.
El modelo educativo tradicional centrado principalmente en la transmisión de conocimientos ha demostrado ser insuficiente para enfrentar los desafíos actuales. Hoy más que nunca se pone énfasis en las competencias, entendidas como la capacidad de aplicar los conocimientos y habilidades en situaciones concretas, y en las capacidades, es decir, en los atributos de libertad y de realización personal que permiten a una persona desenvolverse en un entorno laboral cada vez más incierto y complejo.
La idea de que las competencias son clave para un buen desempeño laboral no es nueva. Desde mediados del siglo XX, los estudios sobre psicología laboral en Estados Unidos empezaron a cuestionar la eficacia de medir a los trabajadores solo en función de su inteligencia o su personalidad. Investigadores como David McClelland, en la década de 1970, fueron pioneros en proponer que lo realmente relevante para las empresas era la capacidad de las personas para crear, hacer y resolver problemas en sus respectivos trabajos. Así surgió el modelo por competencias, que hoy en día es un pilar fundamental tanto en la formación técnica como profesional.
Este modelo ha cobrado mayor relevancia en las últimas décadas, impulsado por la necesidad de crear sistemas educativos y laborales más alineados. En Europa, a partir de la Declaración de Bolonia en 1999, se promovió un enfoque que buscaba homologar las titulaciones y hacerlas comparables entre los países del continente. El objetivo era asegurar que los egresados no solo adquirieran conocimientos académicos, sino también competencias prácticas que pudieran ser evaluadas, certificadas y, sobre todo, reconocidas en diferentes mercados laborales. Se trataba de lograr que no importara el país en que te formaras, porque con lo aprendido podrías desempeñarte en cualquier parte del planeta.
En este contexto, las competencias se dividen en tres grandes categorías: básicas, específicas y genéricas. Mientras que las competencias básicas y genéricas, como la capacidad de trabajar en equipo o la habilidad para resolver problemas son transferibles entre diferentes empleos, las competencias específicas se refieren a habilidades técnicas directamente relacionadas con una profesión o industria particular. Estas competencias son cada vez más valoradas por las empresas, que buscan empleados capaces de aportar valor desde el primer día de trabajo.
Lo que las empresas buscan hoy: Competencias comprobables
La transformación digital, la globalización y la automatización han impactado profundamente en las demandas del mercado laboral. Hoy las empresas se enfrentan a la necesidad de adaptarse a un entor-
Observatorio Duoc UC / Anuario 2024 / página
Observatorio de la Educación Superior Técnico Profesional - Producción y gestión del conocimiento
no cambiante y cada vez más competitivo. Como resultado, buscan empleados que no solo tengan los conocimientos teóricos necesarios, sino que también cuenten con las competencias prácticas que les permitan enfrentarse a los desafíos reales en el día a día.
Los empleadores valoran particularmente las habilidades transversales, aquellas que son aplicables a diversas funciones y roles. Entre estas destacan la resolución de problemas, la adaptabilidad, la capacidad de trabajo en equipo, el liderazgo y la comunicación efectiva. Estas competencias se vuelven esenciales en un entorno laboral donde las tareas son cada vez más interdisciplinarias y donde los equipos de trabajo son dinámicos y están formados por personas de diversas especialidades.
Un ejemplo claro de esta tendencia es el crecimiento de los puestos de trabajo en la industria 4.0, que abarca la integración de la automatización, la inteligencia artificial y el análisis de datos en las operaciones diarias de las empresas. En sectores como la manufactura avanzada, los empleados ya no solo necesitan saber cómo operar máquinas, sino también cómo programarlas, interpretarlas y mejorar sus procesos de manera continua.
En este contexto, la Educación Técnico Profesional (ETP) se ha convertido en un vehículo esencial para formar a los trabajadores que las empresas buscan. Instituciones como Duoc UC han abrazado el enfoque por competencias y el de capacidades como una forma efectiva de preparar a sus estudiantes para el mundo laboral. Estos programas están diseñados en estrecha colaboración con las empresas, lo que garantiza que las competencias adquiridas por los estudiantes respondan directamente a las necesidades del mercado.
Un aspecto fundamental de este enfoque es la creación de programas que integren experiencias laborales reales tales como prácticas profesionales, proyectos de consultoría y trabajo en conjunto con la industria. Estas experiencias no solo permiten a los estudiantes aplicar lo que han aprendido en un entorno práctico, sino que también les brindan la oportunidad de demostrar sus competencias a los futuros empleadores.
Además, la evaluación de las competencias se realiza de manera continua a lo largo del programa formativo, a través de simulaciones, estudios de caso, proyectos y exámenes prácticos. De esta manera, se asegura que los estudiantes no solo dominen los conceptos teóricos, sino que también estén preparados para aplicar sus habilidades en situaciones laborales reales.
Capacidades: Un enfoque desde Amartya Sen y Martha Nussbaum
En este debate sobre competencias y empleabilidad, es relevante incorporar el enfoque de capacidades propuesto por los académicos Amartya Sen y Martha Nussbaum. Este enfoque añade una dimensión ética y humanista al concepto de competencia, al destacar que el verdadero desarrollo de una persona no se mide solo por lo que sabe o lo que puede crear o hacer, sino también por su capacidad de elegir y vivir la vida que valora. Para Amartya Sen las capacidades son las libertades reales que las personas tienen para llevar adelante su vida y lograr bienestar. Estas capacidades van más allá de las habilidades técnicas, e incluyen la posibilidad de elegir entre diferentes formas de vida, lo que tiene un profundo impacto en el ámbito laboral. Desde esta perspectiva, las competencias no son solo herramientas para la empleabilidad, sino medios para ampliar las libertades de los individuos, permitiéndoles adaptarse a nuevas oportunidades y situaciones en constante cambio.
Observatorio Duoc UC / Anuario 2024 / página 87
Observatorio de la Educación Superior Técnico Profesional - Producción y gestión del conocimiento
El enfoque de capacidades de Sen y Nussbaum complementa el modelo por competencias al reconocer que el desarrollo humano y laboral no puede reducirse a una mera lista de habilidades técnicas. En lugar de ello, debe incluir el desarrollo integral de la persona, asegurando que cada individuo tenga las oportunidades y libertades para prosperar tanto en su vida laboral como personal. Este enfoque también resalta la importancia de la formación ética y humanista en la Educación Técnico Profesional, un aspecto que cada vez cobra más relevancia en un mundo globalizado e interconectado. Esto explica la decisión de Duoc UC de incorporar a su modelo el enfoque por capacidades.
El desafío de la medición de competencias y capacidades
Sin embargo, uno de los mayores retos que ha enfrentado y enfrenta el modelo por competencias es su medición. Mientras que los conocimientos pueden evaluarse fácilmente a través de pruebas estandarizadas, las competencias y capacidades, especialmente las habilidades blandas como el liderazgo o la resolución de conflictos son más difíciles de cuantificar. Para abordar este problema, las instituciones educativas deben desarrollar métodos de evaluación más complejos y multifacéticos, que incluyan observaciones directas, retroalimentación de compañeros y superiores, y el uso de simulaciones realistas.
La colaboración con las empresas es también fundamental en este proceso. Al trabajar directamente con el sector productivo, las instituciones pueden asegurarse de que las competencias evaluadas sean relevantes y estén alineadas con lo que los empleadores necesitan. Por ello, la certificación de competencias se ha convertido en una herramienta cada vez más valiosa, ya que permite a los trabajadores demostrar de manera objetiva sus capacidades en áreas clave.
Preparar para el futuro del trabajo
El mundo del trabajo ha cambiado radicalmente, y lo seguirá haciendo. Las competencias y capacidades que hoy buscan las empresas son solo un reflejo de la velocidad con la que la tecnología y la globalización están transformando las dinámicas laborales. En este contexto, el modelo basado en competencias y capacidades no es solo una opción, sino una necesidad para garantizar la empleabilidad de los trabajadores del futuro. Como nos recuerdan Sen y Nussbaum, el verdadero desarrollo va más allá de la técnica. Las capacidades humanas, esas libertades que permiten a las personas llevar la vida que valoran, son tan importantes como las competencias técnicas para asegurar que los trabajadores puedan prosperar en sus vidas personales y profesionales.
El éxito de este modelo radica en su capacidad de adaptarse y evolucionar, de la mano tanto del sector educativo como del empresarial. El futuro del trabajo será de aquellos que sepan aprender, adaptarse y hacer, y las competencias junto con las capacidades, serán el lenguaje común que conecte la educación con el empleo. Por último, la necesidad estratégica de poder hacer más y en menos tiempo, dominando rápidamente toda nueva tecnología que surja es tarea inmediata, para así mejorar ostensiblemente nuestras competencias y capacidades laborales y, de este modo, lograr que el bienestar humano crezca a niveles desconocidos hasta ahora.
30 de septiembre de 2024
Equipo Editorial del Observatorio Duoc UC
Observatorio Duoc UC / Anuario 2024 / página 88
Observatorio de la Educación Superior Técnico Profesional - Producción y gestión del conocimiento
Del aprender haciendo al aprender a innovar
El futuro para la Educación Técnico Profesional
La Educación Superior Técnico Profesional (ESTP) ha consolidado su reputación en sus procesos de enseñanza y aprendizaje, a lo largo de los años, gracias a su enfoque en el aprender haciendo, un modelo que ha demostrado su eficacia, en el pasado y hoy, en la preparación de estudiantes para un mercado laboral que ha tenido cambios, pero no de la envergadura que hoy observamos y que, en el futuro, estimamos, será más dinámico y presuntamente más disruptivo. Este enfoque, centrado en la adquisición de habilidades prácticas y concretas ha permitido que varias generaciones de técnicos se inserten de manera rápida y efectiva en el mundo del trabajo. Ha sido un modelo exitoso, qué duda cabe.
Sin embargo, en un contexto global marcado por los avances acelerados que experimentamos en la digitalización, automatización e inteligencia artificial, entre otros fenómenos disruptivos, el aprender haciendo ya no basta para asegurar la competitividad y relevancia de nuestros técnicos y profesionales. Hoy se requiere un salto cualitativo relevante hacia el aprender a innovar.
El camino del aprender haciendo al aprender a innovar no es solo un simple cambio metodológico, ya que se trata de una evolución que exige una transformación profunda en la actual concepción de la Educación Técnico Profesional. Ya no es suficiente preparar a los estudiantes para ejecutar ciertas tareas repetitivas, mecánicas y con destreza: Hoy es crucial que desarrollen la capacidad de crear, adaptarse y liderar en un entorno laboral caracterizado por la incertidumbre y el cambio constante. En este contexto, lograr la capacidad de innovación como aprendizaje, ha pasado a ser un pilar fundamental a lograr en la formación técnica y profesional de los alumnos y alumnas.
La integración de tecnologías avanzadas en los programas de estudio emerge como un elemento esencial para esta transición. Instituciones como el Senai en Brasil ya están dando pasos significativos en esta dirección, incorporando robótica e inteligencia artificial en sus currículos técnicos. Estas herramientas no solo permiten que los estudiantes adquieran competencias en automatización industrial, sino que también los capacitan para innovar dentro de esos sistemas, optimizando procesos y resolviendo problemas complejos. De manera similar, Singapore Polytechnic ha integrado la enseñanza de tecnologías emergentes como el Internet de las Cosas (IoT) y la ciberseguridad, preparando a los estudiantes para enfrentar los desafíos de la Cuarta Revolución Industrial, donde la capacidad de innovar es tan crucial como la habilidad técnica específica o dura.
Festo Didactic en Alemania, que utiliza gemelos digitales para simular sistemas complejos en tiempo real, ilustran cómo el aprender innovando no solo involucra el manejo de nuevas tecnologías, sino también una comprensión profunda de sistemas complejos y la capacidad para mejorarlos. Esta metodología permite a los estudiantes experimentar en entornos seguros y controlados, fomentando una mentalidad innovadora desde el primer día de formación. En TAFE Queensland, Australia, la adaptación de los currículos para incluir tecnologías de la información y comunicación (TIC), como el diseño asistido por computadora (CAD), refleja un compromiso con la digitalización y la preparación para un mercado laboral cada vez más dependiente de las competencias digitales.
Observatorio Duoc UC / Anuario 2024 / página 89
Observatorio de la Educación Superior Técnico Profesional - Producción y gestión del conocimiento
Estos ejemplos demuestran que el aprender a innovar ya es una realidad en muchas instituciones alrededor del mundo, y que la ESTP no solo puede, sino que debe adoptar este enfoque para mantenerse relevante y eficaz. Para enfrentar el futuro la Educación Técnico Profesional necesita priorizar la integración de competencias digitales avanzadas, fomentando una cultura de innovación en todas sus dimensiones. Esto no solo implica la actualización de currículos, sino también la transformación de la mentalidad institucional hacia una que valore y promueva la creatividad y la capacidad de adaptación en sus estudiantes. Esto último no es tarea fácil y requiere de tiempo porque es un cambio sustancial de su cultura académica.
La vinculación con la industria sigue siendo fundamental; pero en este nuevo paradigma se convierte en un motor de innovación. Manteniendo un diálogo constante con las empresas, las ETP puede garantizar que sus programas no solo respondan a las necesidades actuales del mercado, sino que también anticipen las futuras demandas y oportunidades. La colaboración con la industria debe extenderse más allá de la simple actualización curricular, para incluir la co-creación de soluciones innovadoras que beneficien tanto a los estudiantes como a las empresas.
Lo sustancial para una institución educativa técnica de nivel superior que desea aprender a innovar, en comparación con el aprendizaje innovador en una universidad, radica en su enfoque de aplicación práctica inmediata. La innovación está directamente vinculada a la resolución de problemas concretos y a la mejora de procesos actuales en los entornos laborales. La enseñanza se orienta hacia los aprendizajes de habilidades técnicas que los estudiantes puedan aplicar de manera inmediata en sus lugares de trabajo, y que les sirvan para abordar eventuales problemas emergentes.
Además, las instituciones educativas técnicas son más adaptables y flexibles en sus currículos. Estas han demostrado ser más ágiles en los cambios que las universidades, ya que integran rápidamente las nuevas tecnologías y tendencias industriales en sus programas de estudio. Esta adaptabilidad es crucial para mantener la relevancia de la formación técnica. Solo que ahora pasa a ser una necesidad más dinámica y estratégica.
Asimismo, las instituciones educativas técnicas, como lo hemos señalado, tienen una conexión más directa y constante con la industria. Estas buscan soluciones innovadoras que tengan un impacto inmediato en el entorno laboral. En este sentido, están más orientada hacia la aplicación práctica y el desarrollo de soluciones específicas que mejoren la productividad y competitividad de las empresas. Por esto, la alianza entre las empresas y la ETP es estratégica y beneficiosa para ambas.
El trabajo formativo de la ETP se orienta hacia la empleabilidad inmediata. Esto implica que la innovación que incentiva en sus alumnos y alumnas no solo se busca por su valor académico, sino también por su capacidad para preparar a los estudiantes para desempeñarse con éxito en el mercado laboral desde el primer día. Esta cuestión es central.
Los programas en las instituciones educativas técnicas suelen ser más cortos y específicos que en las universidades. Por tanto, la innovación en este contexto TP debe ser rápida y enfocada, asegurando que los estudiantes adquieran las competencias necesarias en un tiempo reducido. Tarea no fácil pero necesaria para la futura empleabilidad de los estudiantes.
Observatorio Duoc UC / Anuario 2024 / página 90
Observatorio de la Educación Superior Técnico Profesional - Producción y gestión del conocimiento
En el caso de Duoc UC está fomentando la innovación en forma amplia en toda la institución, invitando a administrativos y docentes a presentar ideas, proyectos que mejoren o propongan una manera nueva de hacer o de solucionar un problema específico o una manera de hacer las cosas. Asimismo, incentiva la investigación aplicada y está movilizando a la institución para aportar en este sentido. Estas acciones significan asumir una tendencia mundial y entender a cabalidad que estamos en los inicios de un nuevo paradigma para la ETP.
Dicho todo lo anterior, pareciera ser que la Educación Técnico Profesional está, por su peculiar naturaleza, más abierta y receptiva a promover el aprender a innovar para lograr que su formación rápidamente sea beneficiosa para el crecimiento económico del país, así como el de dar más empleabilidad a sus estudiantes. Es necesario entonces apoyarse en las nuevas tecnologías emergentes y con el apoyo de estas, dar el salto cuántico que solo beneficiará a nuestros estudiantes actuales y futuros.
26 de agosto de 2024
Equipo Editorial del Observatorio Duoc UC
Observatorio Duoc UC / Anuario 2024 / página 91
Observatorio de la Educación Superior Técnico Profesional - Producción y gestión del conocimiento
La capacitación laboral en la era de la innovación tecnológica
Vivimos años caracterizados por significativos avances científicos y tecnológicos sin precedentes, situando la capacitación de los colaboradores en una encrucijada crucial. La rápida aparición de nuevas tecnologías y conocimientos obliga a las empresas e individuos a adaptarse continuamente para mantener su competitividad y relevancia en el mercado laboral. Esta realidad nos lleva a preguntarnos ¿cómo será la capacitación de los colaboradores en los próximos años y qué enfoques serán necesarios para abordar los desafíos emergentes?
La adopción de tecnologías como la inteligencia artificial (IA), la realidad virtual (RV) y la realidad aumentada (RA) está revolucionando los métodos de formación. La IA permite crear programas de capacitación personalizados, ajustados al ritmo y estilo de aprendizaje de cada colaborador. Mediante algoritmos y análisis de datos, es posible identificar áreas de mejora y ofrecer contenidos específicos para fortalecer competencias. Por su parte, la RV y la RA brindan experiencias de aprendizaje inmersivas, especialmente valiosas para entrenamientos técnicos o de alto riesgo, permitiendo a los empleados practicarlas en entornos simulados y sin consecuencias reales.
En este contexto, el concepto de aprendizaje a lo largo de la vida adquiere una relevancia aún mayor. Los colaboradores deben actualizar constantemente sus habilidades para adaptarse a las nuevas herramientas, procesos y conocimientos. Las certificaciones específicas y las micro credenciales que reconocen competencias en áreas emergentes se popularizan, facilitando la especialización y adaptabilidad de la fuerza laboral.
La capacitación se ajusta cada vez más a las necesidades y horarios de los colaboradores, reconociendo la diversidad de sus circunstancias cotidianas. El e-learning y las plataformas digitales permiten acceder a contenidos desde cualquier lugar y, en cualquier momento, facilitando el equilibrio entre el trabajo y formación. Además, el micro aprendizaje, implementado a través de módulos breves y enfocados, permite a los colaboradores asimilar información de manera eficiente, adaptándose a agendas ocupadas. En cuanto a las competencias técnicas más valiosas en el futuro, e importantes como contenido de una capacitación, serán aquellas relacionadas con las tecnologías avanzadas y aplicadas a todas las disciplinas y saberes. El dominio de áreas como la inteligencia artificial, el aprendizaje automático y la ciencia de datos se convertirán en un requisito fundamental en diversos campos laborales. La ciberseguridad adquirirá una importancia crítica, dada la creciente dependencia de sistemas digitales y la necesidad de proteger información sensible. Gestionar sistemas automatizados, comprender la robótica y la biotecnología, competencias en programación, desarrollo de software y manejo de plataformas digitales avanzadas serán clave para mantenerse competitivo en un mercado laboral en constante evolución.
Observatorio Duoc UC / Anuario 2024 / página 92
Observatorio de la Educación Superior Técnico Profesional - Producción y gestión del conocimiento
Asimismo, se potenciará la necesidad de adquirir habilidades blandas y adaptativas. El pensamiento crítico, la resolución de problemas, la creatividad y la innovación son esenciales para enfrentar desafíos complejos y tomar decisiones informadas. La colaboración y la comunicación efectiva resultan imprescindibles en entornos de trabajo cada vez más interconectados y multidisciplinarios. Este énfasis refleja la comprensión de que la tecnología, aunque poderosa, es una herramienta que requiere del ingenio humano para ser aplicada de manera efectiva. Los colaboradores deben ser capaces de adaptarse rápidamente a los cambios y desempeñarse en roles multifacéticos.
Las alianzas entre instituciones educativas y empresas se fortalecerán para cerrar brechas de habilidades y asegurar la pertinencia de la formación. Se desarrollarán programas conjuntos y currículos alineados con las necesidades del mercado laboral y las competencias demandadas. La formación dual, que combina educación teórica y experiencia práctica en el entorno laboral real, se consolidará como una estrategia efectiva para preparar a los empleados de manera integral.
Esta colaboración no solo garantiza que la educación responda a las demandas actuales y futuras de la industria, sino que también facilita la transición de los estudiantes al mundo laboral y promueve la actualización constante de las competencias de los empleados. Mirando hacia adelante, es fundamental que tanto las empresas como los individuos abracen estos cambios y se comprometan con un aprendizaje continuo. Solo así podremos enfrentar con éxito los desafíos que plantea la evolución científica y tecnológica, construyendo un futuro en el que el desarrollo profesional y el progreso social vayan de la mano. Qué duda cabe: Estamos en el inicio de un cambio paradigmático.
4 de noviembre de 2024
Equipo Editorial del Observatorio Duoc UC
Observatorio Duoc UC / Anuario 2024 / página 93
Observatorio de la Educación Superior Técnico Profesional - Producción y gestión del conocimiento
La Educación Superior Técnico
Profesional (ESTP): Un pilar para el futuro de
Chile
La Educación Superior Técnico Profesional (ESTP) ha sido tradicionalmente vista como una vía formativa orientada al trabajo. Esta percepción, aunque correcta, es limitada, pues la ESTP tiene un rol mucho más complejo y crucial en la configuración del sistema educativo y el desarrollo económico y social de un país. Su especificidad radica en su capacidad para adaptarse rápidamente a las demandas del mercado laboral, pero también en su potencial para fomentar la innovación, la inclusión y la investigación aplicada, así también para mejorar las posibilidades de empleabilidad de un importante número de ciudadanos. En un contexto global, donde la digitalización y la globalización están redefiniendo las competencias necesarias para el éxito profesional, la ESTP debe ser reconocida no solo como una educación para el trabajo, sino también como un motor de desarrollo integral relevante para los países.
La Naturaleza de la ESTP: Más que una formación para el trabajo
Históricamente la ESTP ha sido vista como una educación práctica, diseñada para preparar a los estudiantes en competencias específicas que les permitan ingresar rápidamente al mercado laboral. En Chile, figuras como Domingo Faustino Sarmiento y Abdón Cifuentes fueron pioneros en la promoción de este tipo de educación, reconociendo la necesidad de formar a amplios sectores de la población en oficios que les aseguraran una renta estable y contribuyeran al crecimiento del país. Esta visión sigue siendo relevante, pero es fundamental expandirla.
La Educación Técnico Profesional no debe limitarse a ser una vía rápida al empleo, sino que debe ser vista como una educación con valor propio, que forma a profesionales capaces de adaptarse y liderar en un mundo laboral en constante cambio. El enfoque en competencias prácticas es, sin duda, una de sus fortalezas, como también lo son las competencias técnicas transversales, tales como la resolución de problemas, el trabajo en equipo, y la adaptabilidad. Estas habilidades, que trascienden las ocupaciones específicas, son cruciales en el siglo XXI, donde la automatización y la inteligencia artificial están transformando radicalmente las industrias.
La ESTP en un contexto global
Para entender mejor el potencial de la ESTP, es útil compararla con modelos exitosos en otros países. En Alemania, por ejemplo, el sistema dual combina formación en el aula con experiencia laboral en empresas, lo que ha demostrado ser altamente efectivo en la reducción del desempleo juvenil y en la alineación de las competencias educativas con las necesidades del mercado. Este modelo ya es una fuente de inspiración para Chile, donde la integración entre la educación y el trabajo todavía enfrenta desafíos significativos. En el caso de Duoc UC tenemos a los Campus Arauco y Nacimiento que aplican este modelo.
Observatorio Duoc UC / Anuario 2024 / página 94
Observatorio de la Educación Superior Técnico Profesional - Producción y gestión del conocimiento
En Finlandia, otro ejemplo destacado, la formación profesional está altamente integrada con la educación general y goza de un estatus igual al de la educación académica. Esta integración no solo mejora la percepción social de la ESTP, sino que también asegura que los estudiantes tengan una formación más completa, preparándolos tanto para el trabajo como para la vida. En Chile, a lo mejor, este enfoque podría ayudar a romper con la dicotomía que aún existe entre la educación universitaria y lo técnico profesional, para construir un sistema educativo más cohesivo y equitativo.
Desafíos y oportunidades de la ESTP en Chile
Existen varios desafíos que enfrenta la ESTP en Chile. En nuestra opinión, la falta de una definición clara y la necesidad de una mayor participación de la industria en el diseño curricular son, sin duda, aspectos críticos, pero es importante también identificar y aprovechar las oportunidades que se presentan en el contexto actual.
La digitalización, por ejemplo, ofrece una oportunidad única para la ESTP. Las nuevas tecnologías están creando demandas para competencias que no existían hace una década, y la ESTP está en una posición privilegiada para responder a estas demandas de manera ágil y eficiente. Sin embargo, esto requiere una actualización constante de los programas de estudio y una colaboración más estrecha con la industria para asegurar que la formación que se ofrece esté alineada con las necesidades del mercado.
Además, la ESTP tiene un papel crucial en la promoción de la inclusión y la equidad social. En un país como Chile, donde las desigualdades sociales y económicas son profundas, la ESTP puede ofrecer oportunidades educativas y laborales a sectores de la población que podrían no acceder a la educación universitaria. Fortalecer este rol inclusivo requiere políticas educativas y laborales que reconozcan y apoyen la importancia de la ESTP como una vía de movilidad social.
Investigación aplicada y vinculación con el medio: Claves para el futuro
Respecto al papel de la investigación aplicada en la ESTP, a diferencia de la investigación teórica, más común en las universidades, la investigación aplicada en la ESTP tiene el potencial de ofrecer soluciones concretas a problemas reales en la industria y la sociedad. Fomentar esta área no solo elevaría el estatus de la ESTP, sino que también demostraría su relevancia y capacidad para contribuir al desarrollo económico y social del país.
En el caso de Duoc UC, la institución ha estimulado consistentemente la investigación aplicada, y el Observatorio dedicó varias semanas en los meses de mayo y junio para informar sobre sus avances y logros valorados por la comunidad interna y externa. Los invitamos examinar en esta web algunas de las columnas que nos explican sobre los avances y proyectos específicos en innovación e investigación aplicada en la institución.
Observatorio Duoc UC / Anuario 2024 / página 95
Observatorio de la Educación Superior Técnico Profesional - Producción y gestión del conocimiento
La vinculación con el medio es otro pilar fundamental para el futuro de la ESTP. Esta vinculación no debe limitarse a la inserción laboral de los egresados, sino que debe incluir la colaboración continua con empresas, comunidades, y otros actores sociales para asegurar que la formación que se ofrece responda a las necesidades reales del país. Esto también implica una mayor participación de estos actores en el diseño curricular y en la evaluación de los programas de estudio.
Duoc UC en los últimos años ha continuado potenciando su vinculación con el medio. Es parte esencial de su quehacer y de hecho las sedes y escuelas han estimulado de manera creciente los vínculos bidireccionales con distintos entes de la sociedad. Además, el Observatorio Duoc UC publicó un Boletín dedicado a informar sobre variadas actividades de vinculación con el medio que hoy se realizan en la institución. Pueden verlo aquí: https://observatorio.duoc.cl/boletin/boletin-n66-conectados-al-territorio-experiencias-de-vcm-en-duoc-uc/
La ESTP como motor de desarrollo integral
La Educación Superior Técnico Profesional tiene el potencial de ser mucho más que una formación para el trabajo. En un mundo laboral cada vez más complejo y dinámico, la ESTP puede y debe ser un motor de desarrollo integral, que forme a profesionales no solo competentes en sus áreas técnicas, sino también capaces de adaptarse, innovar y liderar en un entorno cambiante. Para lograr esto, es necesario un esfuerzo concertado por parte de todos los actores involucrados, desde las instituciones educativas hasta la industria y los formuladores de políticas. Solo así la ESTP podrá ocupar el lugar que le corresponde en el sistema educativo y en el desarrollo futuro de Chile.
En el caso de Duoc UC, la formación integral también toca aspectos de trascendencia y de invitación libre a conocer a Jesucristo, su oferta moral y ética, de sentido de vida y que nos da respuesta sobre el de dónde venimos, qué hacemos y hacia dónde vamos. La institución se alegra de entregar este mensaje a sus estudiantes, ofreciendo su mayor riqueza a todos aquellos que de buena voluntad desean acercarse y profundizar su fe, como también de aquellos estudiantes que, con afanes de cultura general, desean conocer la antropología cristiana tan importante en occidente los últimos dos milenios.
19 de agosto de 2024
Equipo Editorial del Observatorio Duoc UC
Observatorio Duoc UC / Anuario 2024 / página 96
Observatorio de la Educación Superior Técnico Profesional - Producción y gestión del conocimiento
La IA como asistente de las personas:
Desafíos
y
oportunidades para la Educación Técnico Profesional
Imaginemos un mundo donde cada ser humano, sin importar su profesión o nivel educativo, cuente con un asistente de Inteligencia Artificial (IA) personalizado. Un entorno en el que la IA no es solo una herramienta técnica, sino un socio cotidiano que optimiza tareas, facilita decisiones y permite a las personas centrarse en aspectos más creativos, estratégicos y emocionales de su trabajo. Este escenario ya no es ciencia ficción, ya que es una posibilidad real que se vislumbra en un futuro muy próximo, impulsada por los avances tecnológicos que transforman el mundo laboral a una velocidad no conocida antes en la historia de la humanidad.
¿Cómo se integraría cada persona con la IA? ¿Qué implicaría esto para la formación de los estudiantes de carreras técnicas y profesionales no universitarias, aquellos que forman parte de la columna vertebral de la economía y el progreso de nuestras sociedades?
En un mundo donde la IA está integrada en todos los aspectos de la vida profesional, el primer cambio profundo radicaría en la redefinición del papel, el sentido, el aporte concreto del trabajador humano para la evolución de la economía y la productividad de toda empresa. Las tareas rutinarias y mecánicas, aquellas que solían consumir tiempo y recursos, estarían mayormente automatizadas. Desde el procesamiento de datos hasta la gestión logística, la IA asumiría un rol predominante en la ejecución eficiente de estas actividades. En sectores técnicos como la administración, la manufactura, la salud, el turismo, la comunicación, el diseño y la gastronomía y tantas otras disciplinas, la IA actuaría como un “asistente invisible”, gestionando tareas administrativas, anticipando problemas y proporcionando soluciones en tiempo real. Respecto a las ingenierías y la informática, se estima que la IA provocará cambios distópicos, acelerando las capacidades de estos profesionales y técnicos.
En este contexto, el ser humano estimamos se enfocaría en las tareas que requieren creatividad, juicio crítico, inteligencia emocional, habilidades interpersonales para trabajar en equipo con la IA. Por ejemplo, un técnico en mantenimiento industrial podría usar IA para diagnosticar fallos en una maquinaria de manera rápida y precisa, pero sería su capacidad de tomar decisiones basadas en la experiencia y su intuición la que determinaría las acciones a seguir. Un chef podría utilizar IA para optimizar el uso de insumos y prever la demanda de ciertos platos, pero la creación de nuevos menús seguiría siendo una labor creativa y humana, así como la personalización de la preparación de la comida y lo bebestible.
La integración de la IA en la vida profesional de cada persona no será homogénea. Cada sector y cada profesión experimentarán esta transformación de manera distinta, pero en términos generales, la IA se convertirá en una extensión de las capacidades del trabajador. Esto ya es una realidad, y se producirá el efecto que no tendrán empleabilidad aquellas personas que no aumentan sus capacidades con la IA y que tiendan a resistir el cambio. Es un cambio de mentalidad muy profundo y una democratización de la extensión de las competencias humanas para todos aquellos que asuman rápido esta nueva realidad tecnológica. Las empresas, como ya hemos señalado, preferirán a aquellos que tengan asumida en su saber esta nueva tecnología, ya que es la nueva alfabetización obligatoria para continuar participando en el nuevo mundo.
Observatorio Duoc UC / Anuario 2024 / página 97
Observatorio de la Educación Superior Técnico Profesional - Producción y gestión del conocimiento
El gran desafío para esta integración será asegurar que todos los trabajadores, independientemente de su nivel educativo, tengan acceso equitativo a las tecnologías de IA y a la formación necesaria para utilizarlas. Esto requiere no solo infraestructura tecnológica, sino también una cultura de la formación continua. Las empresas deberán asumir un papel clave en la capacitación de sus empleados, y las instituciones de formación técnico-profesional actualizar sus programas constantemente para incluir módulos de IA, no solo desde una perspectiva técnica, sino también desde una óptica ética y crítica.
También la IA se integrará en la vida no laboral de las personas. Fuera del entorno laboral, la IA ya actúa como asistente en nuestras vidas cotidianas, ayudándonos a gestionar nuestro tiempo, nuestras finanzas, es nuestra fuente de respuesta para preguntas repentinas que tenemos, nuestras decisiones de consumo e incluso nuestra primera aproximación a temas de salud. En el futuro, esta interacción será más fluida y omnipresente, lo que requerirá que los individuos desarrollen un conjunto de habilidades para navegar en un entorno donde la IA está presente en casi todas las facetas de la vida. Así también, las personas deberán estar conscientes de que deben preservar su autonomía y juicio crítico y que no sea la IA quien les gobierne sus vidas.
La pregunta entonces es, en este escenario, qué deben hacer los IP y CFT con sus estudiantes. Según la IA GPT, utilizada como asistente para esta editorial, nos respondió:
“La integración efectiva de la IA en el mundo profesional requiere una formación sólida que permita a los estudiantes de carreras técnicas comprender, utilizar y aplicar estas tecnologías en su vida profesional y personal. Para formar a estos estudiantes, es crucial que las instituciones técnico-profesionales diseñen currículos que combinen habilidades técnicas con una comprensión integral del funcionamiento y las implicaciones de la IA. Este proceso de formación debe basarse en tres pilares fundamentales:
Comprensión Técnica: Los estudiantes de carreras técnicas deben recibir una formación básica en las tecnologías de IA que afectan a su campo profesional. Esto implica enseñarles cómo funcionan los algoritmos de aprendizaje automático, cómo se procesan los datos y cómo se utilizan herramientas específicas de IA en su industria. En sectores como la administración, la ingeniería, la salud y la informática, esta formación es esencial para que los futuros profesionales comprendan cómo la IA puede automatizar procesos, optimizar recursos y mejorar la eficiencia operativa.
Aplicación Práctica: Más allá de la teoría, los estudiantes deben aprender a aplicar estas tecnologías en escenarios reales. La IA tiene el potencial de transformar la forma en que se llevan a cabo los trabajos técnicos, por lo que es fundamental que los estudiantes practiquen el uso de estas herramientas en contextos prácticos. Simulaciones, estudios de caso y proyectos colaborativos pueden ayudar a los estudiantes a entender cómo la IA puede ser utilizada para resolver problemas concretos en su campo. Por ejemplo, un estudiante de turismo podría usar IA para analizar datos de comportamiento de clientes y así ofrecer experiencias más personalizadas.
Ética y Pensamiento Crítico: Aunque la IA ofrece muchas ventajas, también plantea preguntas éticas fundamentales. Los estudiantes deben ser formados para utilizar la IA de manera responsable, comprendiendo los límites de esta tecnología y las implicaciones de su uso en la sociedad. En campos como la salud o la comunicación, donde la IA podría influir en decisiones críticas, es esencial que los profesionales técnicos desarrollen un pensamiento crítico y una conciencia ética sólida sobre cuándo y cómo utilizar la IA.
Observatorio Duoc UC / Anuario 2024 / página 98
Observatorio de la Educación Superior Técnico Profesional - Producción y gestión del conocimiento
Además de estos tres pilares, es crucial fomentar una mentalidad de aprendizaje continuo. La tecnología de IA está en constante evolución, y los estudiantes deben comprender que su formación no termina al obtener un título. Deberán estar preparados para actualizar sus conocimientos y habilidades a medida que la tecnología avance. En este sentido, las instituciones de formación técnico-profesional deben ofrecer oportunidades de formación continua y reciclaje, en colaboración con las industrias que utilizan IA”.
De acuerdo con esta respuesta, el uso de la IA nos ofrece enormes oportunidades como también siderales desafíos. Respecto a las primeras, sin duda mejora nuestra efi ciencia, hace posible la personalización del saber y que, además, ahora podemos entender aquello que nos resultaba complejísimo.
En relación a los desafíos, son muchos, pero al menos dos son irrefutables: Aquellos que no estén capacitados para utilizar la IA podrían quedar relegados en el mercado laboral. Para evitar esto, es esencial que las instituciones educativas y los gobiernos trabajen juntos para democratizar el acceso a la formación en IA y garantizar que nadie se quede atrás.
La IA también generará una creciente demanda de profesionales con habilidades interdisciplinares. A medida que la IA se expanda a todas las áreas de la vida, será crucial que los técnicos no solo dominen las herramientas tecnológicas, sino que también comprendan sus implicaciones sociales, culturales y éticas. La educación en carreras TP deben prepararlos para este desafío, fomentando una visión holística del impacto de la tecnología en la sociedad y en especial los alcances y posibilidades de la IA.
14 de octubre de 2024
Equipo Editorial del Observatorio Duoc UC
Observatorio Duoc UC / Anuario 2024 / página 99
Observatorio de la Educación Superior Técnico Profesional - Producción y gestión del conocimiento
La inteligencia artificial y su impacto
en la educación: una oportunidad, un desafío y un llamado ético
En las últimas décadas la educación se ha enfrentado a transformaciones profundas, pero pocas han sido tan disruptivas como la irrupción de la inteligencia artificial (IA). Este avance tecnológico ha desatado una oleada de desconciertos y reflexiones entre docentes, estudiantes y líderes educativos. Entre el entusiasmo por su potencial y el temor a sus consecuencias no deseadas, la IA plantea desafíos que van mucho más allá de lo técnico ya que toca los fundamentos éticos y pedagógicos de la enseñanza misma[1].
El sistema educativo de cualquier institución formativa está, sin lugar a duda, en una encrucijada histórica. La IA con su capacidad para generar textos, resolver problemas complejos y personalizar experiencias de aprendizaje, puede ser un aliado invaluable. Sin embargo, si no se maneja con responsabilidad y visión, podría debilitar competencias humanas esenciales y perpetuar desigualdades. Como, por ejemplo, quién sepa utilizar con talento la IA, se distanciará en su productividad a niveles insospechados respecto a los demás. Este momento exige una reflexión seria, una planificación rigurosa y, sobre todo, una acción ética.
La inteligencia artificial ofrece emocionantes posibilidades para mejorar la calidad del aprendizaje. Herramientas como los sistemas adaptativos, las plataformas de tutoría virtual y los asistentes de escritura han demostrado su capacidad para identificar las fortalezas y necesidades de los estudiantes, adaptando las experiencias educativas a su ritmo y estilo de aprendizaje. Estas tecnologías no solo facilitan la personalización, sino que también democratizan el acceso a recursos de alta calidad que antes eran privilegio de unos pocos. Por esto hoy es tan importante alfabetizar en IA a nuestros docentes y estudiantes. Sin embargo, este potencial no está exento de riesgos. Existe una creciente preocupación de que, al depender excesivamente de la IA, los estudiantes pierdan la oportunidad de desarrollar habilidades críticas como la creatividad, el pensamiento analítico, el saber escribir o hablar, entre otras. En lugar de fomentar el esfuerzo cognitivo, existe el peligro de que estas herramientas promuevan una búsqueda de soluciones rápidas y superficiales. Ante este panorama, la pregunta central no es si debemos integrar la IA en la educación, sino cómo hacerlo de una manera que complemente, y no reemplace, el aprendizaje humano. En el cómo respondamos a esta pregunta y ejecutemos la respuesta, nos estaremos jugando la excelencia institucional y la empleabilidad futura de nuestros estudiantes.
[1] Esta editorial se elaboró utilizando como método el diálogo socrático con chat GPT, Gemini, Microsoft Copilot, Claude 3.5 en torno a las oportunidades, problemas éticos y maneras de enfrentar las nuevas relaciones educativas futuras entre los docentes y estudiantes, respecto al uso y los efectos de la IA en los procesos de enseñanza y aprendizaje. La selección de las ideas fue hecha por nosotros, escogiendo aquellas que nos parecieron más relevantes y sugerentes para la educación TP.
Observatorio Duoc UC / Anuario 2024 / página 100
Observatorio de la Educación Superior Técnico Profesional - Producción y gestión del conocimiento
Uno de los aspectos más complejos de esta transformación tecnológica es la evaluación del aprendizaje en los estudiantes, ¿cómo medir el progreso de estos en un contexto donde las herramientas de IA pueden generar trabajos completos, resolver problemas matemáticos y responder preguntas de manera autónoma? Este desafío pone en tela de juicio los métodos tradicionales de evaluación, que históricamente han privilegiado los productos tangibles por sobre los procesos de enseñanza y aprendizaje.
Para responder a este reto, es necesario repensar los enfoques de evaluación, priorizando metodologías que permitan observar y valorar el proceso de aprendizaje. Estrategias como el aprendizaje basado en proyectos, las evaluaciones orales y las actividades colaborativas pueden ofrecer una perspectiva más integral del desempeño estudiantil. Asimismo, es fundamental fomentar la transparencia y el diálogo con los estudiantes sobre el uso ético de la IA en sus trabajos, promoviendo la honestidad y la autorreflexión como valores esenciales.
La incorporación de la IA en la educación no puede desligarse de un análisis ético riguroso. Es imprescindible establecer límites claros que prevengan su mal uso, desde la dependencia excesiva, su mal uso que puede provocar mucha maldad hacia otras personas e instituciones, hasta la reproducción de sesgos inherentes a los algoritmos. Aquí, el papel del docente se vuelve crucial. El docente ya no es solo un mero transmisor de conocimiento, los educadores deben asumir el papel de guías éticos, ayudando a los estudiantes a comprender las implicancias sociales, económicas y culturales del uso de la tecnología.
Además, las instituciones educativas tienen la responsabilidad de promover la equidad en el acceso a estas herramientas, asegurando que todos los estudiantes, independientemente de su contexto socioeconómico, puedan beneficiarse de su potencial.
La inteligencia artificial, por más sofisticada que sea, no puede replicar, hasta ahora, las cualidades que nos hacen humanos: La empatía, el juicio crítico, la creatividad y la capacidad de adaptarnos a circunstancias complejas. Por ello, el reto no es solo incorporar la tecnología en el aula, sino hacerlo de manera que potencie estas habilidades y prepare a los estudiantes para liderar en un mundo donde la tecnología y la humanidad coexistan de manera armoniosa y colaborativa.
La educación debe seguir siendo un espacio de reflexión crítica, donde el aprendizaje se construye en torno a valores éticos y sociales. La IA, con todas sus promesas y desafíos, debe ser vista como un aliado que, correctamente utilizado, puede ayudarnos a superar barreras históricas y crear un sistema educativo más inclusivo, equitativo, efectivo y, obviamente, creando más bienestar para la humanidad.
El momento actual exige una visión clara y valiente para todas las instituciones educativas. La inteligencia artificial, más que un simple recurso tecnológico, representa una oportunidad para redefinir la educación, priorizando tanto el desarrollo de habilidades humanas como el aprovechamiento de las herramientas tecnológicas. Lograr este equilibrio no será fácil, pero es imprescindible.
El sistema educativo tiene ante sí una tarea monumental: Guiar a las futuras generaciones hacia un aprendizaje integral, ético y transformador. En este camino, la IA puede ser un aliado poderoso, siempre que recordemos que su propósito no es sustituir al ser humano, sino potenciar su capacidad de aprender, crear y construir un mundo mejor.
25 de noviembre de 2024
Equipo Editorial del Observatorio Duoc UC
Observatorio Duoc UC / Anuario 2024 / página 101
Observatorio de la Educación Superior Técnico Profesional - Producción y gestión del conocimiento
La naturaleza actual de la Educación
Técnico Profesional chilena y su necesidad de transformación
La esencia de la ETP ha estado siempre ligada a su capacidad para formar a técnicos y profesionales capaces de ejecutar tareas específicas con eficiencia. Este enfoque en la formación práctica ha sido uno de los mayores atributos del modelo ETP, destacando su fuerte y siempre presente vinculación con el mundo laboral. Algunas de las características esenciales de la ETP hoy son:
Enfoque práctico y aplicado: La ETP se distingue de otras modalidades de educación superior por su énfasis en la aplicación inmediata de los conocimientos. Los estudiantes no solo aprenden teorías o principios, sino que también desarrollan habilidades concretas y específicas que pueden utilizar de manera inmediata en el entorno laboral.
Vinculación con la industria: Uno de los mayores puntos fuertes de la ETP es su conexión directa con las necesidades de las industrias. En muchos países, los programas de ETP son diseñados en colaboración con empresas, lo que asegura que los estudiantes egresen con competencias que son demandadas por el mercado.
Flexibilidad y adaptabilidad: A diferencia de las universidades, que suelen tener programas más largos y teóricos, los institutos técnicos profesionales y centros de formación técnica pueden adaptar sus currículos con mayor rapidez, integrando nuevas tecnologías y adaptándose a las tendencias emergentes del mercado laboral.
Competencias basadas en el mercado laboral: La ETP ha adoptado un modelo de formación basado en competencias, centrado en la adquisición de habilidades prácticas y capacidades específicas que son esenciales para el buen desempeño en los sectores productivos.
Acceso y equidad: En muchos países, la ETP ha sido una herramienta clave para mejorar la equidad educativa, proporcionando oportunidades de formación a grupos sociales que históricamente han tenido menos acceso a la educación superior, y permitiendo que estos grupos logren una rápida integración laboral y, por supuesto, más alta empleabilidad.
El reto de la transformación
Aunque la ETP ha demostrado su eficacia a lo largo de los años, el avance de la Cuarta Revolución Industrial marcada por la digitalización, la automatización, la inteligencia artificial y el cambio constante en las necesidades laborales, está desafiando la capacidad de la ETP para seguir siendo un motor clave de empleabilidad. En este contexto, las instituciones de Educación Técnico Profesional enfrentan la urgencia de transformarse para seguir siendo relevantes y garantizar que sus egresados tengan las competencias y habilidades transversales necesarias para enfrentar los desafíos de un mercado laboral en rápida evolución.
Observatorio Duoc UC / Anuario 2024 / página 102
Observatorio de la Educación Superior Técnico Profesional - Producción y gestión del conocimiento
El reto no es solo actualizar los currículos, sino redefinir el enfoque mismo de la ETP. La educación técnica no puede limitarse a formar trabajadores que sepan ejecutar solo tareas específicas, ya que debe evolucionar hacia la formación de técnicos capaces de innovar, adaptarse a nuevos contextos y liderar procesos de transformación en sus áreas de especialización.
¿Cómo transformarse?
Para que la ETP logre una verdadera transformación, es necesario que sus instituciones tomen una serie de pasos fundamentales:
Fomentar una cultura de la innovación: El aprender haciendo sigue siendo relevante, pero debe complementarse con un enfoque que promueva la creatividad y la innovación. Los estudiantes de la ETP no solo deben aprender a ejecutar tareas, sino también a mejorar procesos, identificar oportunidades de innovación y adaptarse rápidamente a nuevas tecnologías y métodos de trabajo.
Integración de tecnologías avanzadas: Las tecnologías emergentes como la inteligencia artificial, la automatización, el Internet de las Cosas (IoT), la robótica y los sistemas de gemelos digitales, se sugiere integrarse en cada uno de los programas de estudio. Esto no solo permitirá a los estudiantes adquirir competencias técnicas avanzadas, sino también desarrollar una comprensión profunda de los sistemas complejos en los que trabajarán.
Formación en competencias transversales: Además de las competencias técnicas específicas, se cree necesario que los estudiantes sean formados en habilidades blandas y transversales como el pensamiento crítico, la resolución de problemas, la adaptabilidad y la capacidad de trabajar en equipo. Estas competencias son cada vez más valoradas en el mercado laboral, ya que permiten a los trabajadores adaptarse a un entorno de trabajo cambiante y lleno de incertidumbre.
Vinculación con el mundo laboral como co-creadores: La vinculación con la industria ha sido un eje central de la ETP, pero debe profundizarse para convertirse en una verdadera co-creación. Las instituciones de educación técnica no solo deben actualizar sus currículos basados en las demandas del mercado, sino que deben trabajar junto a las empresas en la creación de soluciones innovadoras que beneficien tanto a los estudiantes como a las industrias.
Adaptabilidad institucional: Las instituciones de ETP deben ser más ágiles y flexibles, no solo en sus currículos, sino también en sus estructuras y formas de trabajo. La capacidad de adaptarse rápidamente a los cambios tecnológicos y a las necesidades del mercado será clave para mantener la relevancia de la ETP en el futuro. Por ejemplo, dominar el uso de la IA parece ser urgente ya que hoy se está demandando el buen dominio de esta para todo tipo de trabajos.
Hacia una nueva definición de la ETP
Por tanto, la transformación de la ETP debe partir de una nueva definición que la posicione no solo como una educación para el trabajo, sino como una educación para la innovación. En este sentido, la ETP debe evolucionar de ser una plataforma que prepara a los estudiantes para empleos existentes, a una que los
Observatorio Duoc UC / Anuario 2024 / página 103
Observatorio de la Educación Superior Técnico Profesional - Producción y gestión del conocimiento
capacite para crear, liderar y adaptarse a los empleos del futuro. Esto requiere una visión más amplia y estratégica, en la que las instituciones de ETP se conviertan en actores clave en la creación de conocimiento aplicado y en el desarrollo de soluciones que impulsen la competitividad de las industrias y la economía.
El futuro de la ETP
El futuro de la ETP estará definido por su capacidad para adaptarse y transformarse. Si bien la ETP ha sido históricamente una vía para la formación técnica de calidad para trabajos concretos y repetitivos, ahora debe convertirse en una vía para la formación de innovadores y líderes técnicos. La integración de tecnologías avanzadas, el fomento de una cultura de innovación, la adaptación a las nuevas demandas del mercado laboral y la co-creación con la industria son los elementos clave para asegurar que la ETP siga siendo relevante en las próximas décadas, acompañando el desarrollo económico de Chile.
16 de septiembre de 2024
Equipo Editorial del Observatorio Duoc UC
Observatorio Duoc UC / Anuario 2024 / página 104
Observatorio de la Educación Superior Técnico Profesional - Producción y gestión del conocimiento
Transformación de la Educación
Técnico Profesional: Imperativos para el siglo XXI
En las últimas dos décadas, la educación superior en América Latina ha experimentado una serie de transformaciones que han redefinido su estructura y propósito. Estos cambios han sido impulsados por un entorno de creciente globalización, la evolución en la participación estatal y el fortalecimiento de la gestión privada en las instituciones educativas. En este contexto, las demandas del mercado laboral exigen técnicos y profesionales con competencias más complejas y un nivel avanzado de alfabetización tecnológica. Al mismo tiempo, el rápido surgimiento de nuevos oficios y carreras vinculadas a sectores emergentes, junto con la expansión sostenida de la matrícula en la educación superior, han generado desafíos significativos en términos de retención estudiantil, para imaginar nuevas carreras y en la capacidad de las instituciones para cumplir con las promesas de empleabilidad hecha a sus estudiantes. Hoy, en el siglo XXI, los desafíos se han intensificado y diversificado, requiriendo respuestas aún más ágiles y estratégicas. El avance de la inteligencia artificial, la automatización y la economía digital ha creado una demanda sin precedentes por habilidades tecnológicas y adaptabilidad. Las instituciones de Educación Técnico Profesional (ETP) deben responder no solo a las necesidades actuales, sino anticipar las futuras, integrando tecnología y sostenibilidad en sus currículos y prácticas.
Las tendencias contemporáneas en la educación superior muestran una expansión continua en la matrícula, acompañada por una oferta educativa cada vez más diversificada. Esta diversidad incluye un estudiantado con una amplia gama de antecedentes culturales, sociales y económicos, lo que plantea el desafío de crear modelos educativos inclusivos y equitativos. Además, se observa un aumento en la responsabilidad y transparencia (accountability), un proceso de internacionalización más profundo y una creciente demanda de egresados de la ETP por parte de las industrias. Sin embargo, el desafío central radica en mantener la relevancia de las formaciones académicas en un entorno laboral en rápida evolución, donde las habilidades blandas y la capacidad de adaptación son tan cruciales como las competencias técnicas.
La educación superior, y en particular la ETP, tiene un papel crucial en tres dimensiones fundamentales: potenciar la productividad y competitividad de las naciones, ampliar las oportunidades individuales fomentando la movilidad social, y fortalecer la gobernabilidad democrática, esencial para la cohesión y sostenibilidad de cualquier sociedad. En este sentido, la ETP no puede limitarse a la formación técnica: Es deseable también cultivar ciudadanos globales, comprometidos con los desafíos sociales y ambientales de nuestro tiempo.
Objetivos estratégicos para la Educación Superior Técnico Profesional en el contexto actual
a) Impulsar la transformación digital y la sostenibilidad: En un mundo cada vez más digitalizado y consciente del cambio climático, la ETP debe priorizar la formación en tecnologías emergentes y prácticas sostenibles. Esto incluye la incorporación de competencias en inteligencia artificial, automatización, economía circular y energías renovables, preparando a los estudiantes para ser líderes en la transición hacia una economía más respetuosa del medio ambiente y conocedores de la oferta tecnológica vigente y de sus posibilidades de aplicación.
Observatorio Duoc UC / Anuario 2024 / página 105
Observatorio de la Educación Superior Técnico Profesional - Producción y gestión del conocimiento
b) Promover la equidad e inclusión en la educación: La ETP debe ser un motor de equidad social, asegurando que todos los estudiantes, independientemente de su origen, tengan acceso a una educación de calidad que les permita desarrollar su máximo potencial. Esto implica diseñar currículos inclusivos, implementar políticas de apoyo financiero y desarrollar programas que atiendan las necesidades de los grupos más vulnerables.
c) Fomentar la empleabilidad en un entorno laboral cambiante: La empleabilidad en la era digital requiere una combinación de competencias técnicas, habilidades blandas y una mentalidad de aprendizaje continuo. La ETP debe fomentar la adaptabilidad, la innovación, el pensamiento crítico y la capacidad de los estudiantes para adquirir nuevas competencias de forma autónoma, respondiendo a las exigencias de un mercado laboral en constante cambio.
d) Reforzar la educación continua y el aprendizaje a lo largo de la vida: El concepto de educación a lo largo de la vida es más relevante que nunca. La ETP debe equipar a los estudiantes con la habilidad de “aprender a aprender”, permitiéndoles adaptarse y evolucionar en sus carreras profesionales, así como responder a los desafíos tecnológicos y laborales que surjan a lo largo de su vida.
e) Innovar en modelos educativos y flexibilidad curricular: En un contexto donde el cambio es la única constante, la ETP debe aumentar su amistad con los modelos educativos innovadores que integren aprendizaje híbrido, experiencias laborales, y una mayor flexibilidad curricular. Esto permitirá a las instituciones adaptarse rápidamente a las demandas del mercado y ofrecer una formación pertinente y de calidad.
Finalmente, La Educación Superior Técnico Profesional no debe ser vista simplemente como un mecanismo para satisfacer solo las demandas del mercado laboral para una mera productividad económica. En su esencia, la ETP tiene la responsabilidad de formar personas integrales, ciudadanos globales que no solo posean competencias técnicas, sino que también estén comprometidos con la sostenibilidad, la equidad y el bienestar social del mundo. Las instituciones educativas deben enfocarse en desarrollar individuos que puedan contribuir de manera significativa a sus comunidades y al mundo, asegurando que su impacto trascienda el ámbito económico para incluir la promoción de valores éticos y un compromiso profundo con los desafíos sociales y ambientales de nuestro tiempo.
Si examinamos el actual Plan de Desarrollo de Duoc UC 2021-2025, comprobaremos que varias de las ideas expresadas en esta editorial, están presente en el espíritu y tácticas que hoy se desarrollan en la institución. Como lo hemos expresado en editoriales anteriores, estamos en el inicio de un cambio paradigmático que nos está modificando sustancialmente nuestra velocidad para atender a las demandas actuales de una mejor educación y más logros de aprendizajes.
Todo se ha vuelto dinámico y diverso. La evolución de la historia, con su actual espiritualidad y materialidad, nos obliga a salir de nuestra zona de confort y comprender que Duoc UC debe asumir el ritmo, el color y la textura de las innovaciones en desarrollo en el mundo. En esto está hoy la institución, escuchando los sonidos del tiempo, mirando las nuevas carreteras del conocimiento técnico profesional y, lo que es más saludable y reconfortante, entendiendo que sus estudiantes necesitan una institución actualizada, con claridad de futuro y que tiene un mensaje trascendente que transmitir: Una invitación abierta y libre para conocer a Jesucristo, razón esencial que explica el origen, permanencia y futuro de la institución.
2 de septiembre de 2024
Equipo Editorial del Observatorio Duoc UC
Observatorio Duoc UC / Anuario 2024 / página 106
Observatorio de la Educación Superior Técnico Profesional - Producción y gestión del conocimiento
Un presente bisagra,
entre la permanencia y el cambio urgente
El desarrollo científico y tecnológico está transformando el panorama laboral en todas las profesiones, sean estas universitarias o técnicas. Esto explica el por qué todas las instituciones están estudiando el futuro con más dedicación reflexiva, ya que nunca antes los cambios que observamos se aceleraron y se dinamizaron tanto en un corto período de tiempo. De hecho, hasta fines del siglo XX, se estimaba necesaria la actualización permanente de conocimientos, pero sin dramatismo ni presión. Hoy es todo lo contrario: Existe la convicción que ya no basta estudiar un pregrado, sino que será indispensable volver a capacitarse continuamente en las novedades emergentes, con cursos específicos diseñados para proporcionar el conocimiento y dominio de los avances específicos en las tareas laborales realizadas por las diversas profesiones.
En materia de automatización y robotización, sabemos que muchas tareas repetitivas y manuales están siendo automatizadas, lo que puede reducir la demanda de ciertos trabajos técnicos como de hecho ya está sucediendo. Por tanto, los trabajadores hoy necesitan nuevas habilidades y conocimientos para manejar, programar y mantener sistemas automatizados.
Tecnologías como la inteligencia artificial, el Internet de las Cosas (IoT) y la impresión 3D están creando nuevos tipos de trabajos y cambiando los existentes. De tal modo que se requiere formación en estas nuevas tecnologías para que los trabajadores sigan siendo relevantes en el mercado laboral.
Hoy el énfasis está puesto en las habilidades blandas como la comunicación, trabajo en equipo, resolución de problemas, entre otras, y las habilidades digitales se están volviendo tan importantes como las habilidades técnicas tradicionales. Ello implica que las instituciones están hoy arduamente trabajando en cómo lograrlas como aprendizajes en sus estudiantes.
En este escenario los departamentos de educación continua tienen un enorme desafío: cómo lograr el aprendizaje continuo y la actualización constante de las habilidades requeridas por los trabajadores. Reeducar hoy es una normalidad educativa. Es observable y deseable entonces el crear oportunidades y cursos para que los trabajadores regresen a la educación superior para actualizar sus habilidades. Hoy es perceptible que las instituciones educativas, en todo el mundo, están potenciando el currículum adaptativo y flexible. Se trata de actualizar continuamente los programas de estudio para incluir las últimas tecnologías y prácticas del sector laboral a las cuales apuntan las distintas carreras. Ejemplo de esto es la incorporación de módulos sobre IA, IoT, ciberseguridad y sostenibilidad en un número creciente de carreras.
También son interesantes los avances en las llamadas habilidades transferibles. Entendemos por estas las que sean aplicables en múltiples industrias y roles, como lo son por ejemplo la gestión de proyectos y el análisis de datos. Por esto hoy es normal que las instituciones educativas estén ofreciendo cursos sobre competencias digitales básicas y avanzadas, así como la formación intensiva en habilidades blandas.
Observatorio Duoc UC / Anuario 2024 / página 107
Observatorio de la Educación Superior Técnico Profesional - Producción y gestión del conocimiento
La pertinencia de los estudios es otro eje de trabajo que se ha subrayado en las instituciones de formación. Se trata de establecer alianzas con empresas para garantizar que los programas educativos estén alineados con las necesidades reales y presentes del mercado laboral. Esto implica fomentar programas de pasantías, prácticas profesionales y colaboración en proyectos de investigación aplicada.
Destaca y se ha incentivado en las instituciones educativas la actualización constante de los programas de estudio (incorporar última tecnología); avances en infraestructura tecnológica (invertir en laboratorios y equipos tecnológicos de última generación); capacitación permanente de sus docentes (proporcionar formación continua a los docentes para que estén al día con las últimas tecnologías y métodos pedagógicos); incentivo a los programas de apoyo y mentorías (becas, tutorías personalizadas y programas de orientación profesional); y fomento del emprendimiento (centros de innovación e incubadoras de startups dentro de las instituciones).
Las instituciones educativas de educación superior tienen un papel crucial en preparar a los estudiantes para el futuro del trabajo, adaptando sus programas, colaborando con la industria y fomentando el aprendizaje continuo. Al hacerlo, pueden garantizar que incluso aquellos sectores más desfavorecidos tengan acceso a las habilidades y conocimientos necesarios para prosperar en un mundo laboral en constante cambio. Para una institución profesional como Duoc UC, son demandas presentes y futuras, y se informa sobre estos temas para mantener su calidad educativa.
24 de junio de 2024
Equipo Editorial del Observatorio Duoc UC
Observatorio Duoc UC / Anuario 2024 / página 108
Observatorio de la Educación Superior Técnico Profesional - Producción y gestión del conocimiento
Gestión institucional, procesos
y Vinculación con el Medio (VcM)
Observatorio Duoc UC / Anuario 2024 / página 109
Observatorio de la Educación Superior Técnico Profesional - Producción y gestión del conocimiento
Agilidad y mejora continua
de nuestros procesos en Duoc UC
En la reciente reunión “Agilidad y mejora continua en nuestros procesos”, Duoc UC ha demostrado una vez más su compromiso por emprender una ruta hacia la excelencia, buscando un modelo de gestión más ágil, efi ciente y centrado en las personas, sean estas estudiantes, docentes, administrativos o aliados estratégicos. Este encuentro no solo repasó avances, sino que delineó con nitidez la senda a seguir para consolidar una cultura organizacional abierta a la innovación, el diálogo permanente y la acción proactiva.
La jornada, llevada a cabo en modalidad on line el jueves 12 de diciembre, contó con expositores clave tales como el Rector Carlos Díaz, Velko Petric, María José Rojas, Ximena Sibils, Rodrigo Lagos, Gastón Ramos y Pía Valenzuela. Todos, desde su posición, contribuyeron a dibujar un panorama de acciones concretas en ámbitos tan diversos como el manejo de documentos, la incorporación de herramientas digitales, la mejora en procesos de compras y contratación, la optimización del registro académico y la gestión de desempeño de los colaboradores. Lejos de declaraciones retóricas, se mostraron resultados tangibles y metas claras, dando una sensación de realismo y firmeza a este ejercicio de reflexión colectiva.
El Rector Carlos Díaz enfatizó la relevancia de promover una organización más ágil y dinámica, capaz de responder con prontitud a las demandas de un entorno cambiante. Insistió en que la mirada ha de dirigirse tanto a nuestros estudiantes, a quienes buscamos ofrecer servicios educativos de calidad, como a nuestros colaboradores, quienes requieren procesos internos sencillos, transparentes y útiles. Su mensaje resultó claro: Una institución solo mejora si es capaz de escuchar atentamente las voces de todos sus integrantes y comunidades. Por ello, la iniciativa “Sigamos Conversando” fue uno de los pilares centrales de esta reunión, pues encarna la idea de una escucha activa, sistemática y continua. Según lo expuesto por el Director de la sede San Joaquín y Coordinador zonal, Rodrigo Lagos, esta segunda versión de “Sigamos Conversando” reunió a 2.355 personas, entre estudiantes, docentes y administrativos, y permitió vislumbrar oportunidades de mejora en ámbitos claves como procesos académicos, plataformas digitales, procesos administrativos y comunicaciones internas.
Estas conversaciones, realizadas en múltiples sedes y con diferentes estamentos, aportan un diagnóstico profundo y plural. Los estudiantes señalaron la necesidad de optimizar la inscripción de asignaturas, aclarar criterios de justificación de inasistencias y mejorar la coherencia de las plataformas digitales. Por su parte, los docentes y administrativos subrayaron las oportunidades para agilizar procesos de compra, contratación y gestión documental. Todo ello refleja no solo la magnitud de los desafíos, sino también la determinación institucional de responder con soluciones concretas. De este modo, la presentación de iniciativas ya en curso —como la mejora de la plataforma de “Vivo Duoc”, la creación de un nuevo manual de compras, la estandarización de procesos en Dirección Jurídica, la optimización del portal de calificaciones y la modernización de la gestión de cuentas administrativas— dejó en evidencia que la institución no está parada frente a los retos, sino avanzando con paso firme.
Observatorio Duoc UC / Anuario 2024 / página 110
Observatorio de la Educación Superior Técnico Profesional - Producción y gestión del conocimiento
En el plano de las compras y la relación con proveedores, el Vicerrector Económico y de Gestión, Velko Petric, expuso el trabajo realizado para reducir tiempos, burocracia y complejidad. Gracias a un nuevo manual de compras, la validación de proveedores y la adopción de plataformas más integradas, se espera disminuir de 45 a 31 días el tiempo promedio de todo el ciclo de compra y recepción, mejorando la eficiencia y garantizando un uso más responsable de los recursos.
Por su parte, la Dirección Jurídica, a través de la abogada Pía Valenzuela, explicó cómo se está trabajando en la automatización y simplificación del proceso de gestión de contratos. Se ha logrado reducir etapas y centralizar el acompañamiento, con la meta de acortar de 23 a 12 días o menos la tramitación de un contrato. Esto no solo libera tiempo, sino que también entrega certidumbre, transparencia y trazabilidad en un ámbito donde la seguridad jurídica y el cumplimiento normativo son esenciales.
La Dirección General de Servicios Digitales, liderada por Ximena Sibils, se abocó a mostrar cómo la digitalización de procesos permite un círculo virtuoso de mejoras. Al automatizar la creación de cuentas administrativas, integrar plataformas, brindar canales únicos de atención y consolidar tableros de control, se facilita el trabajo diario y se deja atrás la duplicidad de esfuerzos. La mejora continua es un camino en constante construcción y las métricas que hoy se obtienen —tiempos de respuesta, valoración de usuarios, trazabilidad de solicitudes— serán la base para nuevas iteraciones más avanzadas y efectivas. En materia de gestión de desempeño, María José Rojas, Directora General de Personas, detalló un rediseño del proceso para el año 2025. De un sistema complejo y rígido, con múltiples etapas, se pasa a uno más simple, flexible y enfocado en la retroalimentación continua. Con solo tres fases principales: fijación de objetivos, evaluación final y retroalimentación; se busca que las conversaciones sobre desempeño surjan de forma más natural durante todo el año, reduciendo trámites y formularios, y privilegiando la calidad por sobre la cantidad. Así, la gestión del desempeño deja de ser un ejercicio burocrático para convertirse en un espacio de desarrollo humano y profesional.
Si algo demostró la reunión “Agilidad y mejora continua en nuestros procesos” es que la institución entiende el cambio como un ciclo permanente de escucha, acción, medición y ajuste. Ya no se trata de implementar mejoras aisladas, sino de generar un entorno cultural en el que la mejora sea parte intrínseca de la vida institucional. Estas transformaciones no son exógenas ni impuestas por una instancia superior, sino surgen del diálogo, la observación y la voluntad de todos de encontrar mejores caminos. El esfuerzo conjunto de las áreas, la adopción de metodologías ágiles, la automatización y digitalización de procesos, el énfasis en la comunicación y la promoción de una cultura proactiva constituyen la base de una institución robusta, preparada para enfrentar los desafíos del presente y del futuro.
Es fundamental reconocer que la agilidad no se limita a la reducción de tiempos o la simplificación de formularios. La agilidad implica una mentalidad organizacional que coloca el interés de nuestros estudiantes y colaboradores al centro, dispuesta a revisar cada engranaje y, si es preciso, reconstruirlo. Una mentalidad que entiende el error no como una falla, sino como una oportunidad para refinar el proceso, y el hallazgo de nuevos caminos no como amenaza, sino como una opción de crecimiento y consolidación.
En el mes de abril del próximo año, habrá una segunda reunión en que se presentarán las modificaciones más relevantes para incrementar la agilidad y simpleza en los procesos académicos de Duoc UC. En esto está trabajando la rectoría y la vicerrectoría académica para ofrecer a la institución propuestas cualitativas y organizacionales que harán que la actividad académica, tan esencial para la institución, dé
Observatorio Duoc UC / Anuario 2024 / página 111
Observatorio de la Educación Superior Técnico Profesional - Producción y gestión del conocimiento
un salto de calidad hacia el futuro, entendiendo y asumiendo que estamos en el inicio de un cambio de época, considerando los avances científicos y tecnológicos en pleno desarrollo que nos impulsa y mueve a reacciones y cambios más rápidos.
Al concluir esta reflexión, queda la certeza de que no se trata de un cierre ni de un balance final, sino de un hito más en un largo trayecto que hemos comenzado a recorrer hace 56 años. La reunión ha sido una prueba tangible de que, con dedicación, colaboración y apertura al cambio, podemos afrontar cada reto y convertirlo en una oportunidad. De esta manera, continuamos avanzando hacia un Duoc UC más ágil, eficiente y humano, capaz de generar satisfacción y orgullo a quienes lo integran y, sobre todo, el de aportar con solidez al futuro de la sociedad y las personas a las que nos debemos.
Recibamos entonces este impulso con ánimo renovado, conscientes de que la tarea continúa y de que el camino no está exento de dificultades. Es justamente en esa perseverancia, en esa intención de mejorar, de ser más creativos, innovadores y solidarios, donde reside la esencia de lo que aspiramos a ser: una institución que no solo se adapta al cambio, sino que lo impulsa y lo encauza con sabiduría y sentido de misión. Finalmente, su inspiración y sustento cristiano, nos obliga a ser fieles a nuestros talentos y a desplegarlos para lograr formar personas para una sociedad mejor.
16 de diciembre de 2024
Equipo Editorial del Observatorio Duoc UC
Observatorio Duoc UC / Anuario 2024 / página 112
Observatorio de la Educación Superior Técnico Profesional - Producción y gestión del conocimiento
Boletín N°66:
Conectados al territorio: Experiencias de VcM
Duoc UC nació como una experiencia educativa que buscaba ser exitosa respecto a la inclusión de personas tradicionalmente postergadas en su acceso a estudios posteriores a la educación media. Los estudiantes de la UC, apoyados por la rectoría de la Universidad Católica, crearon una institución que salía a buscar otro público masivo no universitario, con el objetivo de mejorar sus aprendizajes y darles un oficio que les diera más empleabilidad y oportunidades a muchos chilenos y chilenas.
En su crecimiento exponencial por todo Chile, mostró su deseo de vincularse ampliamente con el medio. Creó múltiples iniciativas para responder a las enormes necesidades sociales educativas. Buscó bidireccionalidad, aprendiendo de muchas personas deseosas de aprender y aportó nuevos docentes jóvenes a la comunidad.
El Modelo Educativo de Duoc UC promueve experiencias de aprendizaje innovadoras, que no solo facilitan una inserción laboral oportuna, sino que también contribuyen a la formación integral de los estudiantes, permitiendo a la institución desempeñar un papel activo en el desarrollo sostenible de la sociedad. Este enfoque se refleja en la misión de Duoc UC: formar técnicos y profesionales capaces de aportar positivamente a la sociedad.
En este Boletín, invitamos a la Dirección de Vinculación e Integración Institucional de Duoc UC, para que nos escribieran varias experiencias exitosas que están en pleno desarrollo en la institución. En 2023, la VcM en Duoc UC ha mostrado un notable crecimiento y consolidación. Las iniciativas registradas en la plataforma CRM se duplicaron, alcanzando los 1.300 casos.
En opinión de la directora Marcela Arellano: “Considerando la trayectoria de Duoc UC en el desarrollo de esta función misional y el impulso que representa la actualización de la Política de VcM, en enero de 2024 celebramos el Primer Congreso de Vinculación con El Medio: CREA+ Vínculos, una instancia donde más de 300 académicos, directivos, colaboradores y aliados externos confluimos en nuestra sede Padre Alonso de Ovalle de la comuna de Santiago, para compartir buenas prácticas y analizar los aportes de 21 iniciativas seleccionadas de un total de 100 presentadas por equipos de sedes, campus y escuelas”.
Una selección de este Congreso es lo que mostramos en este Boletín N°66. De esta manera buscamos dar a conocer los proyectos y los aprendizajes obtenidos. También conocer opiniones diversas de los mismos y de la amplia valoración positiva que poseen las diversas iniciativas. Por último, también invitamos a Roberto Ríos, como Director de Pastoral, a que nos explicara el sentido de las misiones solidarias de Duoc UC, actividad de gran relevancia y de un rico y generoso impacto social para las comunidades que más necesitan ayuda y momentos para conversar sobre Jesucristo, y así alimentar a las personas con el tesoro que posee la institución: Su fe y el deseo de compartirla con todas las personas que habitan nuestro país. Ver Boletín N°66: https://observatorio.duoc.cl/boletin/boletin-n66-conectados-al-territorio-experiencias-de-vcm-en-duoc-uc/
10 de junio de 2024
Equipo Editorial del Observatorio Duoc UC
Observatorio Duoc UC / Anuario 2024 / página 113
Observatorio de la Educación Superior Técnico Profesional - Producción y gestión del conocimiento
Boletín N°68 del Observatorio Duoc UC:
Instalación, resultados y desafíos de la Dirección de Gobierno de Datos y Análisis Institucional para decidir con convicción y actuar con agilidad en Duoc UC
En la actualidad, los datos y la información se han erigido como uno de los bienes más valiosos de nuestra sociedad. Desde las transacciones financieras hasta las interacciones personales en redes sociales, la información fluye de manera incesante, alimentando la innovación y el progreso. Sin embargo, esta abundancia de datos también revela una realidad preocupante: su vulnerabilidad. Las instituciones, conscientes de esta dualidad, están intensificando sus esfuerzos para proteger la información personal, mientras que las personas exigen cada vez más garantías sobre la seguridad de sus datos.
Los datos son el corazón palpitante de la economía digital. La tecnología hoy permite administrar ingentes cantidades de información para tomar decisiones estratégicas, personalizar servicios y optimizar operaciones. Asimismo, hoy se logra anticipar tendencias, mejorar la eficiencia y ofrecer productos y servicios adaptados a las necesidades específicas de la sociedad.
El Observatorio Duoc UC creyó necesario mostrar qué está haciendo la institución en esta materia. Como lo expresa Ghia Gajardo Pineda, Directora de Gobierno de Datos y Análisis Institucional de Duoc UC: “los datos son un activo institucional que debemos gestionar y proteger, dando acceso, pero garantizando la calidad y la seguridad”… Y en el caso de Duoc UC: “hay una Dirección de Gobierno de Datos y Análisis Institucional que propone dominios de datos y dueños de esos dominios, define administradores de datos, quienes son los responsables funcionales de la calidad de estos, define estándares de completitud, consistencia y coherencia, y perfiles de acceso a los datos bajo su responsabilidad, pero es una Dirección que tiene como labor acompañar el proceso de transformación, madurez y adopción, y su medición”.
El Capellán General de Duoc UC Francisco Llanca Zuazagoitía, observando el tema eje del Boletín, nos expresó: “Por ser una institución católica, queremos poner todo el potencial de la ética al servicio del bien común, poniendo al centro la persona, por ser imagen de Dios, y por eso su cuidado, su valoración, la delicadeza de trato. Esto implican los datos, ya que una encuesta no es solo responder algo, es alguien que se comunica, que expresa, que muestra su ser íntimo y personalísimo”.
El Boletín nos trae diversas columnas escritas por colaboradores que trabajan todos los días recogiendo, cuidando, administrando y velando por la calidad de los datos institucionales. También se incorporan las opiniones de autoridades relevantes que utilizan la información que provee esta Dirección Central de Gobierno de Datos y Análisis Institucional.
Se agruparon las columnas en tres partes: instalación de Gobierno de Datos, resultados durante el proceso formativo y resultados al finalizar el proceso formativo. Creemos que de esta manera ayudamos a los lectores a comprender mejor lo que Duoc UC está haciendo en esta materia de tanta importancia estratégica.
Observatorio Duoc UC / Anuario 2024 / página 114
Observatorio de la Educación Superior Técnico Profesional - Producción y gestión del conocimiento
Hoy los datos y la información representan un tesoro moderno que impulsa el desarrollo económico y social. No obstante, su vulnerabilidad exige una atención constante y un compromiso colectivo para protegerlos. Las instituciones deben adoptar una postura proactiva, implementando políticas de seguridad robustas y fomentando una cultura de la protección de datos. Al mismo tiempo, es fundamental responder a las demandas de la sociedad por mayor transparencia y control sobre la información personal.
Ver Boletín N°68: https://observatorio.duoc.cl/boletin/boletin-n68-instalacion-resultados-y-desafi os-de-la-direccion-de-gobierno-de-datos-y-analisis-institucional-para-decidir-con-conviccion-y-actuarcon-agilidad-en-duoc-uc/
21 de octubre de 2024
Equipo Editorial del Observatorio Duoc UC
Observatorio Duoc UC / Anuario 2024 / página 115
Observatorio de la Educación Superior Técnico Profesional - Producción y gestión del conocimiento
Discurso del Rector Carlos Díaz Vergara
con motivo de la Cuenta Anual 2023 de Duoc UC

Quiero saludar al Rector de la Pontificia Universidad Católica de Chile, Señor Ignacio Sánchez, al Obispo auxiliar de Santiago, Monseñor Alberto Lorenzelli, al presidente del Consejo Directivo de Duoc UC y Prorrector de gestión institucional de la Pontificia Universidad Católica de Chile, señor Patricio Donoso.
También al Consejo Directivo, a los miembros de la Dirección Ejecutiva, a los socios estratégicos, al director de la sede San Joaquín que hoy nos recibe para realizar la Cuenta Anual, a nuestros estudiantes, docentes, administrativos, a todos quienes se han conectado a través de la transmisión online y, muy especialmente, a los estudiantes, docentes y administrativos que hoy serán distinguidos.
Deseo comenzar agradeciendo a la Virgen y San José, por su intercesión y que, a través de su ejemplo, releva el trabajo realizado con cariño para lograr un propósito superior que, en nuestro caso, es “formar personas para una sociedad mejor”.
También quiero agradecer, a nombre de Duoc UC y en el mío propio, al Rector de la Pontificia Universidad Católica de Chile, señor Ignacio Sánchez Díaz, por su cariño, permanente preocupación y apoyo, y por desafiarnos de manera continua a seguir avanzando, a trabajar intensamente y así alcanzar metas cada vez más altas en todos los ámbitos. Los logros que ha alcanzado la UC a nivel internacional nos llenan de orgullo y de alegría, y a la vez nos animan a ponernos metas ambiciosas y a no conformarnos con lo que hacemos ¡Muchas gracias Rector!
También agradecer al presidente del Consejo Directivo de Duoc UC, Patricio Donoso Ibáñez, y a todos los demás miembros del Consejo, con quienes trabajamos de manera conjunta para lograr el cumplimiento de nuestra hoja de ruta que es el Plan de Desarrollo 2021-2025. Asimismo, por intermedio de ellos también quisiera agradecer al Consejo Superior de la UC, Vicerrectores, Decanos y equipos por el trabajo conjunto que venimos realizando en los últimos años ¡Somos parte de la Universidad y así lo sentimos y vivimos!
Observatorio Duoc UC / Anuario 2024 / página 116
Observatorio de la Educación Superior Técnico Profesional - Producción y gestión del conocimiento
Nuestros socios estratégicos también cumplen un importante rol en nuestra misión de formar personas, en el ámbito técnico y profesional, con una sólida base ética inspirada en los valores cristianos, capaces de aportar de manera significativa al mundo laboral y comprometidos con el desarrollo de la sociedad. En especial a Empresas Arauco y Empresas CMPC, con quienes hemos llevado adelante alianzas estratégicas con proyectos de primer nivel en zonas como Arauco y Nacimiento, orientados a brindar una educación de calidad en base a un modelo dual, emplazado en zonas alejadas de las grandes urbes, lo que ha llevado educación técnica a casi 1.000 estudiantes entre ambos campus.
Por último, deseo fervientemente agradecer a toda la comunidad de Duoc UC que trabajó arduamente los últimos años en prepararnos para el proceso de Acreditación 2024. Imposible no mencionar que hace un par de semanas recibimos la visita de los pares acreditadores en varias de nuestras sedes. El proceso se desarrolló conforme al programa definido por la Comisión Nacional de Acreditación con un total de 42 reuniones y la participación de más de 1.000 personas entre estudiantes, docentes, titulados, administrativos y empleadores. Ahora nos queda esperar la llegada del Informe y luego la decisión final. Como siempre, le pedimos a nuestro Patrono San José que nos eche una mano.
Sean muy bienvenidos y bienvenidas a esta instancia en donde damos, como su nombre lo indica, cuenta sobre el estado de la planificación estratégica, el avance y cumplimiento de las metas que nos propusimos para el período 2023.
Duoc UC cuenta con propósitos institucionales claros que le dan sentido a nuestro trabajo todos los días, siempre guiados por nuestra identidad y misión. Un camino que puede presentar grandes desafíos, éxitos y por qué no decirlo, traspiés que nos obliguen a repensar la ruta y reflexionar sobre cuál podría ser el camino para lograr nuestros objetivos.
Por eso, nuestro Plan de Desarrollo 2021-2025 es tan relevante. Es un modo de hacer realidad y de encarnar las grandes definiciones y lineamientos en la vida cotidiana de la comunidad Duoc UC. Como saben, nuestro Plan de Desarrollo establece cinco grandes objetivos estratégicos que orientan nuestra gestión:
1. Incrementar la progresión, titulación y empleabilidad.
2. Mejorar el aprendizaje y la experiencia de los y las estudiantes.
3. Aportar al desarrollo de las comunidades y la sociedad más allá de la docencia.
4. Fortalecer la formación humana, ética y espiritual.
5. Fortalecer y evolucionar la cultura organizacional. Como comunidad educativa aspiramos a formar técnicos y profesionales que realicen su trabajo con una visión ética, con dedicación y cariño, y que además puedan cumplir sus metas familiares y profesionales en base a los valores que como Duoc UC queremos relevar. También buscamos que ojalá muchos de nuestros estudiantes y colaboradores conozcan y encuentren el sentido de su vida junto a Jesucristo. Los desafíos son inmensos, pero tenemos el espíritu y la voluntad de lograr ser un aporte real a la sociedad. Somos una institución educativa que nació hace 56 años desde la Pontificia Universidad Católica de Chile y que hoy cuenta con más de 108 mil estudiantes que esperan lo mejor de nosotros. Sean muy bienvenidos y bienvenidas a esta instancia en donde damos cuenta sobre el estado de la planificación estratégica, el avance y cumplimiento de las metas que nos propusimos para el período 2023.
Observatorio Duoc UC / Anuario 2024 / página 117
Observatorio de la Educación Superior Técnico Profesional - Producción y gestión del conocimiento
Cuenta Anual Duoc UC 2023
El año 2023, celebramos con orgullo, el impacto y el crecimiento continuo que hemos logrado en el ámbito educativo. En el proceso de Admisión 2023, cumplimos con la meta en un 102%. Nuestra matrícula alcanzó la cifra de 104.107 estudiantes, destacando la diversidad de perfiles y trayectorias que conforman nuestra comunidad.
Del total de matrículas, el 35% corresponde a carreras técnicas, mientras que el 65% opta por carreras profesionales, reflejando nuestra oferta educativa variada y adaptada a las necesidades del mundo laboral.
Es importante resaltar que el 70,3% de nuestros estudiantes elige la modalidad diurna, el 29,4% la vespertina, y un 0,3% la modalidad online, demostrando nuestra flexibilidad para atender las distintas realidades y necesidades de nuestros estudiantes.
En Duoc UC, la acreditación ha sido una constante durante los últimos 20 años, marcando hitos significativos en su calidad educativa. Este año, en particular, la institución se enfrenta a un proceso obligatorio de acreditación, que permite certificar la pertinencia y excelencia de la formación de los estudiantes, además de verificar el cumplimiento de los objetivos institucionales y servir como referencia en la regulación de aranceles, acceso a financiamiento y beneficios para los estudiantes y titulados.
Durante el 2023, Duoc UC logró importantes avances en su proceso de acreditación, destacándose el lanzamiento, la recopilación de información oficial, la implementación de encuentros ampliados en las sedes, el trabajo de comisiones y subcomisiones, entre otros. Se destaca la alta convocatoria, con más de 30.000 participaciones, incluyendo la colaboración de estudiantes, titulados, docentes y administrativos en sesiones de trabajo híbridas, encuentros participativos ampliados y consultas virtuales de autoevaluación.
Estos esfuerzos culminaron en la redacción del Informe de Autoevaluación Institucional y la consolidación de resultados participativos, marcando un hito en el compromiso de la comunidad educativa con la calidad y mejora continua.
A continuación, analizaremos el año 2023 en función de cada uno de los objetivos del Plan de Desarrollo.
Objetivo 1: Incrementar la progresión, titulación y empleabilidad
¡Nuestro foco es claro! Seguimos avanzando en consolidar y cumplir con nuestro Plan de Desarrollo 2021-2025. Iniciativa que tiene como principal misión ser nuestra hoja de ruta que nos guiará hacia dónde queremos ir como Institución, bajo el alero de nuestra identidad católica.
El primer eje del Plan de Desarrollo es: incrementar la progresión estudiantil, titulación y empleabilidad, que busca que nuestros titulados cuenten con mejores alternativas laborales.
Es por eso que durante el primer semestre de 2023 se implementó una estrategia de Progresión Estudiantil en 5 sedes y se dispuso, como marcha blanca, al resto de las sedes logrando 9.000 gestiones realizadas, como, por ejemplo, llamados para orientaciones y derivaciones a programas especiales.
Para el segundo semestre, la estrategia se extendió al resto de las sedes y alcanzó 20.000 gestiones realizadas, logrando así un sistema de registro institucional que permite tener trazabilidad e historial de los estudiantes.
Observatorio Duoc UC / Anuario 2024 / página 118
Observatorio de la Educación Superior Técnico Profesional - Producción y gestión del conocimiento
Durante el año pasado se diseñó e implementó una estrategia para propiciar el reintegro de nuestros ex-estudiantes y favorecer su progresión y titulación. En 2023 logramos reintegrar a más de 1.200 de ellos, debido a la identificación de falencias en términos de falta de apoyo, falta de claridad en convalidaciones y avance curricular, entre otros, logrando importantes progresos en este sentido. Además, se descubrieron perfiles y necesidades típicas de los estudiantes que reingresaron, implementando así una estrategia más focalizada.
Nuestra plataforma Duoc Laboral, registró un total de 12.843 estudiantes inscritos y casi 700 titulados. En esta misma línea se llevó a cabo la Feria Virtual, con más de 300 empresas participantes que ofrecieron 1.400 vacantes de trabajos y prácticas para nuestros estudiantes y titulados. Más de 5 mil estudiantes recibieron apoyo y asesoría, postulando también a las ofertas recibidas.
Un 82,1% de los titulados Duoc UC está trabajando al primer año de titulado versus un 57% que es la tasa de ocupación nacional según el Instituto Nacional de Estadística. El salario mensual bruto promedio de nuestros titulados al primer año de egreso, es de $803.863 pesos, situándose dentro del mismo rango nacional real según la Encuesta Suplementaria de Ingresos 2022.
Según la plataforma del Ministerio de Educación Mi Futuro, Ingeniería en Informática es la carrera con mayor empleabilidad al primer año con un 82,21%, mientras que la carrera con menor empleabilidad al primer año de titulación es Actuación con un 17,86%.
A continuación, quiero mencionar algunos de los principales resultados asociados a este objetivo. Si bien la retención de primer año está bajo la meta, el mismo indicador, pero del segundo año, está sobre la meta fijada dentro del Plan de Desarrollo. En cuanto a la titulación oportuna de las carreras técnicas, estamos bajo la meta establecida con un 23,3% frente a la meta de 33,3%, pero en este mismo ítem, en carreras profesionales estamos por sobre la meta establecida con un 38,4% versus un 37,3%.
Tenemos un gran desafío por delante. Debemos seguir avanzando en la actualización constante de nuestras carreras, adaptándolas a las demandas cambiantes de la sociedad y la industria, mejorando la calidad y pertinencia académica para lograr una mejor retención y empleabilidad para nuestros titulados.
Objetivo 2: Mejorar el aprendizaje y la experiencia de los/as estudiantes
Trabajamos arduamente el año pasado, para cumplir los pasos que nos permitan diseñar rutas formativas con un aprendizaje más personalizado que responda a las distintas etapas de la vida respecto a los conocimientos adquiridos.
Más de 1.600 titulados se inscribieron en un programa de Educación Continua, de los cuales un 68% lo hizo en diplomados, con un crecimiento del 55,2%.
Apoyamos, a través del programa “Puesta a Punto”, a más de 700 titulados a reforzar competencias y recuperar aprendizajes a través de cursos online.
Implementamos un nuevo modelo de contratación y selección docente en línea con lo que exige nuestro Modelo Educativo, que contó con la participación directa de las escuelas. Durante el año pasado, aplicamos este modelo como piloto para la Escuela de Administración y Negocios incorporando 93 nuevos docentes.
Observatorio Duoc UC / Anuario 2024 / página 119
Observatorio de la Educación Superior Técnico Profesional - Producción y gestión del conocimiento
Llevamos a cabo un trabajo inédito de análisis de pertinencia de los conocimientos disciplinares de nuestros docentes con las asignaturas que imparten, significando una inversión de casi $400 millones de pesos en el que abarcamos 2.434 docentes. ¿Qué medimos en este análisis? Experiencia profesional, títulos, grados y tiempo transcurrido desde su última experiencia práctica, entre otros índices.
En nuestro afán de seguir fortaleciendo a nuestros docentes es que más de 2.600 realizaron diversas capacitaciones. 710 docentes se certificaron en conocimientos que fortalecen la empleabilidad de nuestros estudiantes y más de 90 de ellos participaron activamente en proyectos de Investigación Aplicada. Lo anterior, representó una inversión de 957 millones de pesos.
Con el fin de potenciar docentes insertos en la industria, durante 2023, continuamos con el programa Cross Training y Proyecto Sync, además de sumar pasantías de larga estancia en la Escuela de Administración y Negocios que impactaron a 10 docentes en distintas empresas durante 6 meses.
Si hablamos de potenciar las tecnologías educativas y experiencias de aprendizaje, estamos orgullosos de contarles que el proyecto de Metaverso impactó a 160 estudiantes. C1DO1, esta es una moderna tecnología educativa que facilita el aprendizaje práctico en forma remota y asincrónica y que ha llegado a más de 20 mil estudiantes, ya que permite generar una retroalimentación efectiva entre ambos. Otra tecnología educativa que hemos adaptado es Kaltura, una plataforma que permite crear, administrar y gestionar material audiovisual de manera efi ciente para generar experiencias de aprendizaje, en la que se han capacitado 745 docentes.
Hemos realizado un esfuerzo importante para actualizar las carreras y nuestras maletas didácticas, lo que implica una cobertura de 16.259 secciones hasta la actualidad, impactando en el año a casi 46 mil estudiantes y más de 2 mil docentes.
En cuanto a la representación estudiantil, durante el año pasado, logramos un aumento considerable en la postulación de candidatos y votantes, logrando conformar 388 consejos de carrera con 1.162 candidatos electos lo que representa un 97% de cobertura de las carreras vigentes.
Implementamos el programa “Embajadores del Bienestar y la Salud Mental”, plataforma de entrenamiento en habilidades básicas para brindar apoyo, no especialista, a personas que están sufriendo una crisis emocional o que están sufriendo un trastorno de salud mental. Se capacitaron como embajadores del bienestar y la salud mental 271 personas.
Si hablamos de nuevas formas de aprender, debemos mencionar sin duda nuestro Campus Virtual, que el año pasado sumó 4 carreras a la oferta en línea, matriculando casi 400 estudiantes. Obtuvimos la certificación Quality Matters y Exemplary Course Program Award, en el curso “Introducción al diseño centrado en el usuario” de la carrera Desarrollo y Diseño Web, lo que da cuenta de la importancia de la calidad de nuestra oferta académica remota.
Estamos bajo la meta establecida en cuanto a la aprobación de asignaturas con un 83,7% respecto a lo que debiésemos llevar, 84,5% y estamos trabajando en revertir la tendencia. También estamos levemente bajo la meta que nos propusimos en el índice Recomendación neta de estudiantes con un 44% en relación al 44,6%, pero hemos cumplido con la meta establecida en el índice de Vinculación e Integración Académica con los estudiantes.
Observatorio Duoc UC / Anuario 2024 / página 120
Observatorio de la Educación Superior Técnico Profesional - Producción y gestión del conocimiento
Si bien trabajamos arduamente en este objetivo, tenemos que seguir generando mejores prácticas y convalidaciones. Debemos desarrollar rutas formativas con aprendizajes más personalizados que respondan a las distintas necesidades según la etapa de vida de nuestros estudiantes.
Sé que no es fácil hacer lo que estamos haciendo. Tenemos que lograr movilizar a una gran institución, pero con el trabajo de todas y todos podremos alcanzar grandes cosas. De eso estoy seguro.
Objetivo 3: Aportar al desarrollo de las comunidades y la sociedad
Las relaciones institucionales y la generación de vínculos con la sociedad y la industria han sido uno de los pilares de trabajo para nuestra comunidad. Durante el 2023, realizamos una serie de proyectos y programas que nos han permitido afianzar relaciones en pos de un mejor aprendizaje práctico, a través de la promoción e integración de métodos innovadores, enriqueciendo la experiencia práctica para estudiantes, docentes y comunidades. Un ejemplo de esto es la creación de “Circulab”, laboratorio para la práctica de estudiantes de la escuela de Diseño, y los torneos basados en desafíos.
Uno de los hitos más destacados fue el inicio de clases en nuestro Campus Nacimiento con 220 estudiantes, donde se combinan ambientes de aprendizaje con formación en el mundo académico y profesional. El campus, cuenta con 3.500 metros cuadrados que buscan potenciar el bienestar de la comunidad que lo rodea y ser un centro de encuentro social y cultural. Espacio similar a nuestro Campus Arauco, inaugurado años atrás, que durante el mismo período recibió a 767 estudiantes en sus aulas.
Además, realizamos trabajo territorial incorporando un nuevo sistema de medición de las actividades de Vinculación con el Medio logrando un retorno social mayor en proyectos como Más Mujeres en las TiCs, Quillota Respira y Operación Renta. También, perfeccionamos el sistema de formación docente para la implementación de acciones de vinculación, con 271 docentes participantes en talleres presenciales y más de 700 en talleres asincrónicos a través del Centro de Formación Docente.
La articulación con liceos técnicos de especialidad y carreras de Duoc UC nos permitió que cerca de 1.000 jóvenes estudiantes se involucraran con nuestra oferta académica y que casi 80 estudiantes del Liceo Politécnico Andes ingresaran y convalidaran asignaturas con algunas de las carreras de Duoc UC. Estamos convencidos que la generación de lazos con la comunidad que nos rodea es muy relevante, aportando con ello a su desarrollo integral más allá de nuestros servicios educativos, a través de actividades culturales, de formación y el traspaso de valores institucionales y de nuestra identidad católica. Por lo anterior, es que realizamos 961 actividades de Extensión y en las que participaron más de 75.000 personas. Y porque la cultura no es la única forma en la que nos vinculamos con nuestro entorno y comunidades, el año 2023 pusimos foco especial en relacionarnos con el ecosistema de innovación: 126 proyectos se ejecutaron con la participación de más de 200 docentes y 500 estudiantes. Esto, gracias a la adjudicación de 9 fondos externos entre el 2022 y 2023.
Además, trabajamos en la convocatoria de Innovación Social a través de la cual hoy día existen 6 proyectos ejecutándose con un problema identificado y una solución propuesta desde la innovación social y sustentable. También, presentamos la segunda versión del Desafío de Innovación Corporativa y co-organizamos con la Pontificia Universidad Católica, el Festival de Innovación y Futuro, FIF.
Observatorio Duoc UC / Anuario 2024 / página 121
Observatorio de la Educación Superior Técnico Profesional - Producción y gestión del conocimiento
No puedo dejar de mencionar la adjudicación del Centro de Escalamiento y Nuevos Negocios entorno a Tecnologías 5G, también junto a la Universidad Católica de Chile, que busca promover y facilitar la creación y el desarrollo de negocios basados en aplicaciones con esa tecnología, y que se emplazará en nuestras dependencias. Y los 21 proyectos que desarrolló el Centro de Innovación y Transferencia Tecnológica, como el Hotel Virtual, el programa Certifika, o la Inauguración del Centro de Negocios Duoc UC, donde 78 estudiantes, acompañados por 20 tutores, trabajaron en casos reales de 5 empresas asociadas.
Durante el año pasado participamos activamente en los Diálogos Constituyentes sobre el futuro de la educación en Chile, organizados por el Consejo de Rectores de IP y CFT Acreditados-Vertebral y la Secretaría Ejecutiva de Participación Ciudadana de la Universidad de Chile y la Pontificia Universidad Católica.
Superamos nuestra meta inicial al llevar a cabo casi 830 diálogos, con la participación de más de 4.300 miembros de nuestra institución. Este logro nos enorgullece porque nos permitió contribuir significativamente con nuestra voz en temas cruciales para la educación nacional.
Si revisamos los indicadores respecto a este objetivo podemos decir que vamos sobre la meta establecida respecto al Índice de confianza reputacional con un 44% sobre al 41% que nos habíamos fijado. En contra parte, vamos bajo la meta establecida en el indicador de Satisfacción de estudiantes con actividades de vinculación con el medio, pero sobre la meta respecto a las actividades de Extensión con 961 frente a las 300 fijadas.
Objetivo 4: Fortalecer la formación humana, ética y espiritual
Uno de los objetivos del Plan de Desarrollo Duoc UC 2021-2025 es fortalecer la formación humana, ética y espiritual.
Es así como el 2023 más de 1.000 estudiantes y colaboradores participaron en las Misiones Solidarias de verano e invierno. También, 563 de nuestros alumnos y alumnas participaron en el Encuentro Nacional de Pastoral y otros 36 viajaron a Portugal a la Jornada Mundial de la Juventud, en la ciudad de Lisboa.
Por otra parte, 5.633 colaboradores, administrativos, docentes y titulados participaron en diversas acciones pastorales, que nos permitieron desplegar en el país nuestro proyecto con un sello ético-cristiano, ofreciendo espacios para que los estudiantes y colaboradores descubran el sentido pleno de su vida.
También, diseñamos y desarrollamos el curso de Convivencia, Inclusión y Equidad de Género, realizado en conjunto con otras instituciones del Consejo de Rectores de IP y CFT Acreditados, Vertebral, que a partir del año 2025 será obligatorio para todos los estudiantes de inicio.
Siguiendo nuestra línea de compromiso con la inclusión, hemos colaborado estrechamente con la Pontificia Universidad Católica de Chile en dos importantes iniciativas. La primera es Eleduc, un proyecto innovador destinado a mujeres privadas de libertad, para potenciar sus habilidades educativas. Este programa tiene como objetivo proporcionarles nuevas oportunidades al término de su condena, facilitando así su reintegración social. El segundo acuerdo es con el Centro UC Síndrome de Down, también creado por la Universidad Católica, con el fin de brindar a las personas con Síndrome de Down las herramientas necesarias para su desarrollo integral en la sociedad.
Observatorio Duoc UC / Anuario 2024 / página 122
Observatorio de la Educación Superior Técnico Profesional - Producción y gestión del conocimiento
Quiero dar cuenta de los resultados de los principales indicadores de este objetivo. por lo que me centraré en la Permeabilidad de valores institucionales en titulados con un 63,2% por sobre la meta establecida del 61,3%. Si nos referimos a los estudiantes que participan en actividades con comunidades, también nos situamos por sobre la meta establecida, así como también si nos enfocamos en la permeabilidad de valores institucionales en estudiantes.
Objetivo 5: Fortalecer y evolucionar la cultura organizacional
Hace algunos años, nos propusimos reforzar nuestra identidad y seguir evolucionando. Parte de este trabajo se ha enfocado, entre otras cosas, en potenciar la cultura organizacional de Duoc UC, que se fundamenta en la promoción y difusión de sus valores institucionales y que guían el comportamiento y las acciones de su comunidad.
Este enfoque integral busca que las personas estén en el centro y donde, a través de una transformación digital, avancemos a ser una organización más inclusiva y ágil, abarcando la promoción de la innovación y transferencia tecnológica, así como el fortalecimiento de la formación humana, ética y espiritual de nuestros estudiantes.
Un ejemplo de esto es la automatización de procesos, mejorando la eficiencia y productividad de ciertos procesos simples, livianos y autogestionables, y las 15 mesas de trabajo que realizamos para el diseño de estrategias del plan de Evolución Cultural.
El 2023 incluimos a los docentes en nuestro programa Valora Duoc UC y logramos que 3.325 colaboradores sean reconocidos a través de la plataforma, siendo la colaboración y el compromiso el valor más reconocido.
Además, se dio inicio al nuevo modelo de competencias y sistema de gestión de Formación y Desempeño, proceso que tuvo un 96% de colaboradores con reunión inicial de fijación de objetivos y/o competencias. Además, 1.426 colaboradores administrativos participaron de los talleres de formación.
Implementamos el cuestionario CEAL SM de Ambientes Laborales a 7.203 administrativos y docentes. En él pudimos conocer que un 83% de ellos declara sentirse “satisfecho“ y “muy satisfecho” con su trabajo actual.
Tras esto se gestionaron acciones transversales para las dimensiones que, de manera general obtuvieron bajos resultados, como la carga de trabajo, el desarrollo profesional, las exigencias emocionales, entre otros, y se buscó una plataforma para la gestión auto reportable de los planes de acción que se definan, permitiendo así una menor manualidad en la data y mayor visibilidad del avance en las áreas.
Paralelamente, durante el año, nos propusimos conocer cómo la salud mental estaría afectando al bienestar, a través de variables organizacionales representadas en un Estudio de Salud Mental, donde obtuvimos 2.887 respuestas, que corresponde a un 45% del universo total de la organización. Esto, nos permitió realizar un seguimiento y desarrollo de propuestas que actualmente se están ejecutando.
En el programa de Liderazgo Inclusivo, participaron 280 directores y subdirectores, lo que les permitió desarrollar habilidades y competencias para liderar equipos de manera efectiva en entornos diversos, fomentando una cultura inclusiva. Además, presentamos el Curso de Diversidad e Inclusión, que hoy cuenta con 770 personas capacitadas con herramientas efectivas para contribuir en el desarrollo de buenas prácticas laborales.
Observatorio Duoc UC / Anuario 2024 / página 123
Observatorio de la Educación Superior Técnico Profesional - Producción y gestión del conocimiento
Por esta y otras razones, fuimos la primera institución de Educación Superior reconocida con el premio de Entidades Inclusivas de la Asociación Chilena de Seguridad.
Destacamos la importancia de promover una cultura del respeto y la sana convivencia dentro de nuestra comunidad educativa, y reconocemos la dignidad de cada individuo como un valor central en todas las interacciones. Por esto, realizamos cerca de 100 iniciativas con más de 500 acciones de convivencia e inclusión, desarrolladas por distintas áreas, contenidas en el Informe Anual de Convivencia e Inclusión 2023.
La institución reconoce los desafíos continuos y se compromete a seguir avanzando en la promoción de una cultura del respeto y la excelencia humana.
Por último, me gustaría destacar la publicación de la Política Institucional de Sostenibilidad, la constitución del Comité Consultivo de Sostenibilidad y el Reporte de Sostenibilidad bajo estándares Resies de la red de campus sustentables que realizamos el 2023, además de importantes acciones desde las sedes como la medición de su huella de carbono, el plan de gestión de residuos y las 5 toneladas recicladas de aparatos eléctricos y electrónicos.
La satisfacción de los estudiantes con servicios tecnológicos cuenta con un 46,3% de cumplimiento por sobre la meta establecida de un 41,1%. La Percepción favorable de estudiantes sobre digitalización también se encuentra por sobre la meta establecida en un 70,5% sobre un 63,8%. Lamentablemente vamos bajo la meta establecida respecto a la percepción favorable de estudiantes sobre inclusión y diversidad. Tenemos grandes desafíos con respecto a lo que viene para el futuro. Sabemos que adaptarse y evolucionar es indispensable para abordar con éxito los desafíos futuros, por esto debemos seguir trabajando en conjunto para crear herramientas y experiencias en torno a la gestión de procesos ágiles y expeditos de nuestra institución.
Además, como institución católica de educación superior, debemos avanzar en nuestro compromiso de la formación integral de personas, técnicos y profesionales, imbuidos en una ética cristiana y orientados hacia el bien común, y en la promoción de una sana convivencia, contribuyendo así a una sociedad mejor.
Para dar cierre a esta Cuenta Anual, quiero agradecer el trabajo realizado por toda nuestra comunidad y por supuesto, felicitar a quienes serán distinguidos con el reconocimiento Espíritu Duoc UC, eje central de esta ceremonia. Son ustedes quienes, día a día, a través de su trabajo, estudio y colaboración con la comunidad, evidencian nuestros valores centrales: integridad; respeto y tolerancia; calidad; colaboración y compromiso; espíritu de servicio.
Agradezco profundamente a toda nuestra comunidad, a nuestros socios estratégicos y especialmente a nuestro patrono San José, por acompañarnos en la entrega de lo mejor de cada uno, con el fin de cumplir nuestro propósito: “Formar personas para una sociedad mejor”.
Muchas gracias.
9 de julio de 2024
Observatorio Duoc UC / Anuario 2024 / página 124
Observatorio de la Educación Superior Técnico Profesional - Producción y gestión del conocimiento
Jornada de inclusión:
Discurso del Vicerrector Académico, Kiyoshi Fukushi Mandiola

Muy buenos días a todas y todos[1] y un especial saludo a las autoridades y amigos que nos acompañan. Muchas gracias por darse el tiempo para participar de esta nueva Jornada de Asesores de Inclusión que se ha intitulado “Fortaleciendo el rol docente para la promoción de la participación de estudiantes con discapacidad en la Educación Superior Técnico Profesional”.
La invitación que subyace en esta jornada es a seguir trabajando colaborativamente, buscando espacios de mejora que permita abordar integralmente el proceso formativo de estudiantes que requieren de mecanismos adecuados para hacer viable su trayectoria formativa. Para el logro de este objetivo no se logrará si es que no contamos con docentes capacitados, comprometidos y también con la fundamental buena disposición de los “otros estudiantes”, sus compañeros, para apoyar este proceso.
La pregunta que surge es qué podemos hacer para favorecer la creación de ese ambiente propicio. Ese desafío será, sin lugar a dudas, una de las líneas de trabajo que debiese considerarse en esta Jornada. Claramente no basta con disponer de los recursos para contar con las tutorías académicas adecuadas. Es necesario capacitar, crear conciencia, abrir los espacios.
Creo importante enfatizar sobre el avance institucional respecto del acceso y permanencia de los estudiantes con discapacidad. Hemos dado pasos muy importantes como la creación de la Unidad de Inclusión Educativa lo que ha implicado un relevante fortalecimiento del equipo, la adjudicación de proyectos de Mineduc, incremento sustantivo de los recursos económicos destinados a los apoyos para los estudiantes, esto es Tutorías en inclusión. Pero también, participación activa en congresos, seminarios y en la mesa educativa que lidera la Sofofa junto a la Red de Empresas Inclusivas Rein.
[1] Discurso pronunciado en el aula Magna de la sede Antonio Varas de Duoc UC, el jueves 1 de julio de 2024.
Observatorio Duoc UC / Anuario 2024 / página 125
Observatorio de la Educación Superior Técnico Profesional - Producción y gestión del conocimiento
La cantidad de estudiantes con alguna discapacidad se ha más que duplicado este último año respecto del 2022 llegando a 888 estudiantes inscritos en Paedis. Tenemos muchos desafíos frente a cada uno de estos y quiero recalcar que frente a los otros estudiantes también, entre estos desafíos tenemos:
1.- Propiciar un ambiente de acogida en el que todos se sientan parte.
2.- Lograr que la trayectoria de cada uno de estos estudiantes sea viable, que encuentre un sentido más allá de nuestras aulas.
3.- Potenciar aún más la participación de los estudiantes con discapacidad en todos los ámbitos de la vida estudiantil.
4.- Acompañar y capacitar a cada docente para que pueda desempeñar su rol.
5.- Crear conciencia entre todos los estudiantes.
Seguramente se me queda alguno olvidado, pero lo que me interesa relevar es que este es un desafío mayor y en el que cada uno de ustedes tiene mucho que aportar.
Termino estas ideas recordando a Benedicto XVI quien con ocasión de la XXVI Jornada Mundial de la Juventud, celebrada en Madrid el año 2011 señaló: “Ninguna aflicción es capaz de borrar esta impronta divina grabada en lo más profundo del hombre”. Quiero recordar esta hermosa cita porque todos hemos estado afligidos, esa no es una condición de la cual uno se pueda escapar: y todos hemos necesitado apoyos. Ver en cada persona el rostro de Cristo y actuar en consecuencia esa debería ser la norma para una institución cuya identidad es la que tiene Duoc UC.
Muchas gracias y buenos días.
22 de julio de 2024
Observatorio Duoc UC / Anuario 2024 / página 126
Observatorio de la Educación Superior Técnico Profesional - Producción y gestión del conocimiento
La evolución de la Subdirección de
Procesos Académicos: innovación y efi ciencia en Duoc UC
En el dinámico entorno educativo de Duoc UC, la Subdirección de Procesos Académicos (SDPA) que depende de la Vicerrectoría académica, ha emprendido una reestructuración institucional significativa, especialmente tras el término de la Dirección de Docencia y la Dirección de Operaciones. Esta evolución ha otorgado a la SDPA nuevas responsabilidades y desafíos que redefinen su papel esencial dentro de la organización. La SDPA, ahora, no solo analiza y evalúa los procesos académicos existentes, sino que también redefine los perfiles y descriptores de cargos de su personal, ajusta funciones y tareas, y supervisa la planificación semestral del área. Este enfoque busca generar confianza y motivación entre los miembros del equipo, alineándose estrechamente con la misión institucional para asegurar la continuidad operativa y la mejora continua de los procesos académicos.
Redefiniendo la esencia de la SDPA:
La SDPA se encarga de diseñar, implementar y supervisar procesos relacionados con la gestión académica. Su esencia radica en crear procesos eficientes y coherentes con las actividades académicas realizadas en las escuelas y sedes, asegurando una operación fluida y eficaz. En este contexto, el rediseño estructural no solo es una respuesta a los cambios organizacionales sino también una oportunidad para innovar y mejorar.
Gestión e implementación de procesos académicos:
La gestión e implementación de procesos académicos implica coordinar actividades que aseguren el correcto funcionamiento de planes y programas. Desde una dimensión operativa, esto incluye la creación de normativas, instructivos y protocolos, así como el acompañamiento y capacitación de los distintos roles en las sedes. Este trabajo es esencial para mantener la coherencia y calidad en la ejecución de las actividades académicas, permitiendo que tanto docentes como estudiantes cuenten con el soporte necesario para su desarrollo.
Procesos académicos sustanciales:
La planificación académica, registros académicos, exámenes transversales, inscripción de asignaturas, admisión especial, prácticas y portafolios constituyen los pilares de los procesos académicos. Cada uno de estos procesos es fundamental para el desarrollo académico de los estudiantes, proporcionando estructura y claridad en su recorrido educativo. Además, la SDPA proporciona soporte técnico y administrativo a través de diversas plataformas tecnológicas, facilitando herramientas y apoyo para una ejecución correcta. Estas plataformas no solo optimizan los procesos, sino que también mejoran la experiencia del usuario, haciendo más accesibles y eficientes las tareas administrativas.
Observatorio Duoc UC / Anuario 2024 / página 127
Observatorio de la Educación Superior Técnico Profesional - Producción y gestión del conocimiento
Apoyo a docentes:
La SDPA brinda apoyo a los docentes mediante asesoría y soporte administrativo para plataformas como RAGC, el portal de calificaciones y SAP. También gestiona trámites administrativos y resuelve problemas operativos que puedan afectar la docencia. Este respaldo es crucial para que los docentes puedan centrarse en su labor educativa, contando con el soporte necesario para superar cualquier obstáculo administrativo que pueda surgir.
Apoyo a estudiantes:
Para los estudiantes, la SDPA resuelve casos relacionados con todos los procesos académicos, ofreciendo orientación en la sede y respondiendo a sus requerimientos. Además, proporciona asesoría y soporte administrativo en plataformas de registros académicos y el portal de calificaciones, asegurando que los problemas operativos no interfieran con su experiencia educativa. Este apoyo no solo facilita su recorrido académico, sino que también les brinda una red de seguridad ante cualquier eventualidad, permitiendo que su enfoque principal sea el aprendizaje.
La importancia de la innovación continua
El compromiso de la SDPA con la mejora continua y la innovación es una muestra del dinamismo y adaptabilidad de Duoc UC. La constante revisión y mejora de los procesos aseguran que la institución no solo mantenga su calidad educativa, sino que también esté a la vanguardia en la implementación de nuevas tecnologías y metodologías.
Dado estos hechos, la Subdirección de Procesos Académicos de Duoc UC se ha transformado en un pilar esencial para la operación y gestión académica de la institución. Su rol en la creación de procesos eficientes, el apoyo a docentes y estudiantes, y la implementación de innovaciones continuas asegura que Duoc UC siga siendo una institución líder en la Educación Técnico Profesional. Esta transformación refleja un compromiso con la excelencia y la mejora continua, asegurando que cada miembro de la comunidad educativa cuente con el soporte y las herramientas necesarias para alcanzar su máximo potencial.
15 de julio de 2024
Equipo Editorial del Observatorio Duoc UC
Observatorio Duoc UC / Anuario 2024 / página 128
Observatorio de la Educación Superior Técnico Profesional - Producción y gestión del conocimiento
La Oficina de Títulos
y Certifi cados en Duoc UC
La innovación y la excelencia educativa son pilares fundamentales en Duoc UC, y un componente esencial para garantizar estos valores es la Oficina de Títulos y Certificados (OTC). Dependiente de la Secretaría General de Duoc UC, la OTC tiene la misión crítica de asegurar la integridad y validez de los documentos emitidos por nuestra institución, reflejando el compromiso con la fe pública que la sociedad deposita en las instituciones de educación superior.
En el contexto educativo chileno, la responsabilidad de certificar y titular a los estudiantes recae directamente en las instituciones. Este sistema implica una obligación significativa para Duoc UC, donde los títulos otorgados tienen validez de por vida, subrayando la necesidad de procesos rigurosos y confiables. La OTC supervisa las actividades relacionadas con la titulación en todas las sedes de Duoc UC, asegurando que estos procesos se realicen de manera oportuna y conforme a los estándares establecidos.
La OTC gestiona la emisión de documentos oficiales que acreditan los estudios realizados por nuestros estudiantes, atendiendo a 18 sedes, la Sede de Educación Continua, y diversas solicitudes a través de plataformas CRM y correo electrónico. Además, la OTC colabora con empresas externas para validar la autenticidad de la documentación presentada por nuestros exalumnos/as, y facilita la obtención de documentos necesarios para trámites internacionales, como la apostilla de títulos ante el Ministerio de Educación.
La OTC cuenta con un vasto archivo histórico que abarca desde los inicios de Duoc UC, permitiendo generar certificados que acreditan los estudios desde los niveles de capacitación en los años 70 hasta los títulos técnicos y profesionales actuales. La integración con la Plataforma WES, una organización que proporciona evaluaciones de credenciales para estudiantes internacionales en EE. UU. y Canadá, es un ejemplo de cómo la OTC facilita el reconocimiento global de los títulos de nuestros estudiantes. Uno de los avances significativos de la OTC es la implementación de una plataforma en línea que permite a los titulados desde 2002 generar su documentación de forma digital. Estos certificados, que cuentan con firma electrónica avanzada y códigos QR para su validación, son aceptados por el Ministerio de Educación para apostillas y por notarías para legalización, simplificando y agilizando los procesos para nuestros ex-alumnos.
Los procesos de la OTC son meticulosos y están diseñados para asegurar la exactitud y veracidad de los documentos emitidos. Dos veces al año, las sedes envían expedientes de los posibles titulados para revisión. Solo tras la validación de esta documentación, los estudiantes pueden proceder a titularse. La OTC también maneja la reimpresión de diplomas por diversas razones, asegurando que todos los registros sean actualizados y precisos.
Observatorio Duoc UC / Anuario 2024 / página 129
Observatorio de la Educación Superior Técnico Profesional - Producción y gestión del conocimiento
Además, la OTC valida información a entidades externas y administra la plataforma de certificados en línea, facilitando el acceso a operadores DARA de las sedes para asegurar una gestión eficiente y efectiva de los certificados.
La Oficina de Títulos y Certificados de Duoc UC, cuyo equipo hoy lo conforman José Humberto Sepúlveda como Secretario General, Alicia Soto como jefa de la OTC y las colaboradoras Ana Jaque, Javiera López y Fernanda Céspedes, no solo garantiza la integridad y autenticidad de los documentos académicos, sino que también facilita la continuidad y reconocimiento internacional de la formación de nuestros estudiantes. Este compromiso con la excelencia y la innovación refleja los valores de Duoc UC, colocando siempre al estudiante en el centro de nuestras actividades y promoviendo una educación que trasciende las aulas y tiene un impacto duradero en la vida profesional y personal de nuestros titulados.
30 de julio de 2024
Equipo Editorial del Observatorio Duoc UC
Observatorio Duoc UC / Anuario 2024 / página 130
Observatorio de la Educación Superior Técnico Profesional - Producción y gestión del conocimiento
Titulados inspiradores de Duoc UC
En el marco del Plan de Desarrollo vigente, el año 2022 surgió la iniciativa “Titulados Inspiradores”, que responde a la necesidad y a la importancia de valorar la contribución de nuestros titulados a la sociedad, así como a la búsqueda de referentes que inspiren a futuras generaciones, colaboradores, otros titulados y la comunidad en general. Esta propuesta, más que un proyecto, es una manifestación del compromiso de Duoc UC con la excelencia y la formación integral de sus estudiantes, reflejando los valores y propósitos de nuestra institución en cada uno de nuestros egresados destacados.
“Titulados Inspiradores”[1]
Nace con el objetivo claro de reconocer y difundir la labor de las tituladas y titulados de Duoc UC que se destacan en diversas categorías, por su testimonio y por encarnar los valores y el propósito de nuestra institución. Esta iniciativa busca no solo identificar a aquellos que han llevado sus aprendizajes más allá del aula, sino también poner en relieve sus historias de éxito y compromiso, sirviendo como faros de inspiración para la comunidad educativa y la sociedad en general.
Desde sus inicios, este programa ha perseguido varios objetivos relevantes:
1) Reconocimiento Público: Destacar a los titulados que se han distinguido en sus campos, elevando sus logros y esfuerzos ante la comunidad.
2) Inspiración y Motivación: Crear modelos a seguir para los actuales estudiantes, demostrando que el éxito es alcanzable y que el esfuerzo y la dedicación rinden frutos.
3) Fortalecimiento del Vínculo: Reforzar el sentido de pertenencia y lealtad de los egresados hacia Duoc UC, asegurando un compromiso duradero con su alma mater.
Hasta la fecha, en sus tres ediciones, “Titulados Inspiradores”[2] ha reconocido a un total de 74 titulados de diferentes escuelas, sedes y años de titulación. Estos se reconocen en seis categorías: Evangelizadores, Emprendedores, Comprometidos, Formadores, Expertos e Innovadores. Alrededor de 250 nominados por año son seleccionados por sus respectivas sedes, y posteriormente, una comisión conformada por directores de las escuelas y otras autoridades elige a los ganadores. Este proceso riguroso y participativo ha posicionado a “Titulados Inspiradores” como un hito en Duoc UC, con su evento de reconocimiento convirtiéndose en uno de los más destacados de la institución.
Reconocer la labor y trayectoria de nuestros titulados es fundamental para generar lealtad y un profundo sentido de pertenencia hacia Duoc UC. Saber que su casa de estudios sigue sus pasos años después de su egreso refuerza su fidelidad y compromiso. Al recibir este reconocimiento, nuestros titulados sienten
[1] https://www.duoc.cl/vida-estudiantil/titulados/titulados-inspiradores/ [2] https://www.youtube.com/playlist?list=PLCt7oZdUU6CQaAf-jseujeHNfG8pAIe2-
Observatorio Duoc UC / Anuario 2024 / página 131
Observatorio de la Educación Superior Técnico Profesional - Producción y gestión del conocimiento
que tienen la misión de enaltecer el nombre de Duoc UC donde sea que vayan y se desempeñen. Este tipo de iniciativas no solo destaca el valor de su formación, sino que también fortalece el vínculo con nuestra institución, asegurando así su compromiso a largo plazo.
El impacto de “Titulados Inspiradores” en los actuales estudiantes es inmenso y 100% motivacional. Ver a titulados que se destacan en el mundo profesional genera un sentido de orgullo y aspiración dentro de toda la comunidad duocana. La frase “Si él puede, yo también lo lograré” resuena fuertemente entre los estudiantes, infundiéndoles la confianza de que, con esfuerzo y dedicación, ellos también pueden alcanzar el éxito. Este sentimiento de orgullo y motivación es compartido no solo por los estudiantes, sino también por los colaboradores y titulados de diferentes generaciones.
La importancia de reconocer y celebrar a los egresados destacados no es exclusiva de Duoc UC. Otras instituciones educativas en todo el mundo han implementado programas similares con notable éxito. Tres ejemplos destacados son:
1) Harvard University: El programa Harvard Alumni Achievement Awards reconoce a antiguos alumnos que han hecho contribuciones excepcionales en sus campos profesionales y a la sociedad. Este reconocimiento no solo honra a los individuos, sino que también destaca la excelencia de la educación de Harvard, inspirando a los actuales estudiantes a seguir sus pasos[3].
2) University of Oxford: El Oxford Alumni Awards celebra a exalumnos que han demostrado un impacto significativo en el mundo. Las historias de estos premiados se difunden ampliamente, sirviendo como una fuente de inspiración para la comunidad universitaria y reafirmando la calidad de la formación recibida en Oxford[4].
3) Massachusetts Institute of Technology (MIT): El MIT Alumni Leadership Awards reconoce a los exalumnos que han demostrado liderazgo y servicio excepcional. Este programa fortalece los lazos entre los exalumnos/as y la institución, y motiva a los estudiantes actuales a aspirar a altos estándares de excelencia y servicio[5].
La iniciativa “Titulados Inspiradores” de Duoc UC es un testimonio del compromiso de la institución con la excelencia y la formación integral de sus estudiantes. Al reconocer y celebrar a aquellos que llevan los valores de Duoc UC más allá del aula, se refuerza el sentido de comunidad, orgullo y pertenencia. Sigamos trabajando juntos para mejorar y expandir esta iniciativa, asegurando que continúe inspirando y motivando a futuras generaciones de duocanos. Invitamos a toda la comunidad de Duoc UC a participar activamente en esta iniciativa, nominando a titulados destacados y apoyando los eventos de reconocimiento. Juntos, podemos construir una red sólida de inspiración y éxito que refleje lo mejor de lo que nuestra institución tiene para ofrecer no solo a la sociedad chilena sino también a otros países.
1 de julio de 2024
Equipo Editorial del Observatorio Duoc UC
[3] https://www.alumni.hbs.edu/awards/Pages/default.aspx
[4] https://www.alumni.ox.ac.uk/distinguished-friends-of-oxford
[5] https://alum.mit.edu/alc/awards
Observatorio Duoc UC / Anuario 2024 / página 132
Observatorio de la Educación Superior Técnico Profesional - Producción y gestión del conocimiento
Un compromiso transformador
hacia la convivencia, inclusión y equidad de género
El pasado miércoles 10 de enero, el Consejo de Rectores de Institutos Profesionales y Centros de Formación Técnica (Vertebral) [1] dio un paso trascendental al lanzar el curso en línea “Convivencia, Inclusión y Equidad de Género”. Un hito educativo que cobra vida desde las entrañas de la innovación, el liderazgo y la inclusión, con Vertebral desempeñando un papel destacado en este proyecto vanguardista.
El Palacio Íñiguez de Duoc UC en Santiago Centro sirvió como epicentro para una jornada histórica, congregando a más de 200 invitados presenciales y 220 en línea. Entre los distinguidos asistentes figuraron nuestro Rector y Presidente de Vertebral, Carlos Díaz; la rectora de IP Culinary y Vicepresidenta de Vertebral, María Trinidad Riesco; el Superintendente de Educación Superior, José Miguel Salazar; el Jefe de la División de Educación Técnico Profesional, Gonzalo Donoso, así como rectores y líderes de instituciones comprometidas con la convivencia e inclusión.
La voz inaugural resonó con fuerza a través de nuestro Rector, Carlos Díaz Vergara, quien enfatizó la relevancia del contenido del curso en el contexto social actual del país. Este programa de estudios se presenta como un faro de cambio, con las instituciones de Educación Superior Técnico Profesional aportando activamente en la transformación hacia un panorama más justo y equitativo para Chile. Agradecimientos sinceros les dirigió a los rectores del Consejo de Rectores y a todos los colaboradores involucrados en la gestación de este innovador curso.
La presentación siguió con un video que desentrañó los entresijos de los cursos, ofreciendo una visión profunda del proceso de creación y compartiendo las reflexiones de los rectores que lideran esta novedosa y eficaz iniciativa.
En un gesto de agradecimiento y apoyo, el Superintendente de Educación Superior, José Miguel Salazar, elogió la visión de Vertebral al ofrecer estos valiosos contenidos de manera gratuita. Expresó su esperanza en que este esfuerzo conjunto contribuya a forjar una comunidad más justa y cohesionada. Gonzalo Donoso, Jefe de la División de Educación Superior TP, aludió a la importancia de dotar a las personas de herramientas que les permitan mejorar la convivencia. Subrayó la necesidad de brindar opciones educativas sin distinción, con el propósito de construir una sociedad más consciente y justa.
La Vicepresidenta de Vertebral y rectora de IP Culinary, María Trinidad Riesco, trajo a la luz la persistente dificultad que enfrentan las mujeres en su desarrollo educativo y laboral. Su discurso resaltó la urgencia de abordar cuestiones cruciales como la equidad de género. Como hemos destacado en columnas
[1] https://vertebralchile.cl/2024/01/11/con-presencia-de-autoridades-de-educacion-vertebral-lanza-curso-online-convivencia-inclusion-y-equidad-de-genero/
[2 ] https://observatorio.duoc.cl/opinion/curso-digital-sobre-convivencia-inclusion-y-equidad-de-genero/
Observatorio Duoc UC / Anuario 2024 / página 133
Observatorio de la Educación Superior Técnico Profesional - Producción y gestión del conocimiento
anteriores [2], este curso no solo aspira a realzar el valor inherente de la persona humana, sino que también se erige como un bastión en la formación comunitaria. Aborda temáticas fundamentales como la convivencia, el respeto, la dignidad humana, y la prevención del acoso sexual, la violencia de género y el consentimiento sexual.
Con una modalidad asincrónica en línea, con evaluaciones y registro del estudiante, y seis módulos de aproximadamente 25 minutos cada uno, este curso será un recurso gratuito disponible para todas las instituciones educativas asociadas a Vertebral a partir de fines de este mes.
Invitamos a explorar estos cursos tan pronto estén disponibles a través de Vertebral. Más que una propuesta educativa, es un llamado a asumir roles activos desde nuestras respectivas posiciones para construir una sociedad donde la dignidad humana no sea una mera promesa, sino una realidad tangible y perdurable.
23 de enero de 2024
Equipo Editorial del Observatorio Duoc UC
Observatorio Duoc UC / Anuario 2024 / página 134
Observatorio de la Educación Superior Técnico Profesional - Producción y gestión del conocimiento
PARTE II: COLUMNAS
de opinión
Observatorio Duoc UC / Anuario 2024 / página 135
Observatorio de la Educación Superior Técnico Profesional - Producción y gestión del conocimiento
Identidad, Cultura y
Vinculación Comunitaria
Observatorio Duoc UC / Anuario 2024 / página 136
Observatorio de la Educación Superior Técnico Profesional - Producción y gestión del conocimiento
Activando ACBD:
Revista Digital Buenas Prácticas en Aula

En el año 2016 Duoc UC actualizó su Modelo Educativo Institucional, fortaleciendo el marco académico para incorporar de manera integrada y coherente los desafíos que se plantean en el Proyecto Educativo y en el Plan Estratégico. En este contexto, la institución ha implementado la estrategia ACBD (Aprendizaje Colaborativo Basado en Desafíos), con el propósito de favorecer el desarrollo integrado de competencias de especialidad y de empleabilidad, mediante una metodología que promueve el aprendizaje activo, significativo, contextualizado y colaborativo. Asimismo, buscó fortalecer la autonomía de los estudiantes a través del desarrollo de soluciones a problemáticas provenientes del mundo profesional [1] .

[1] https://cfd.duoc.cl/recursos/estrategia-acbd/
Observatorio Duoc UC / Anuario 2024 / página 137
Observatorio de la Educación Superior Técnico Profesional - Producción y gestión del conocimiento
Acompañamiento ACBD
En la Unidad de Apoyo Pedagógico (UAP) contamos con el acompañamiento ACBD dirigido a duplas docentes con integración de la estrategia ACBD en sus asignaturas. El acompañamiento es un proceso formativo, realizado por asesores de la UAP, cuyo objetivo es fortalecer y potenciar la implementación y desarrollo de la estrategia, con el fin de aportar a la mejora continua de la práctica docente y a la experiencia del estudiante.
Durante el año pasado, se implementaron cambios significativos en el acompañamiento ACBD. Estos incluyeron la implementación de tres niveles: nivel inicial, nivel medio y nivel avanzado, respondiendo a la experiencia de la dupla docente y a la necesidad de apoyo por parte de los asesores de la UAP. Estos niveles establecieron una nueva forma de realizar el acompañamiento, haciendo más eficiente el proceso y considerando la cantidad de semestres que llevan los docentes implementando la estrategia en el aula. De esta manera, destacamos la experticia de los docentes más avanzados, ya que en este nivel comparten buenas prácticas enmarcadas en una fase o etapa de la rueda ACBD. Es en este contexto, en el que nos encontramos con material valioso para la práctica pedagógica, generándose una oportunidad de dar a conocer esta información a la comunidad.
Publicación Revista Buenas Prácticas en Aula ACBD
A partir de la información recopilada en el acompañamiento de nivel avanzado, surge la idea de hacer una publicación que reúna estas buenas prácticas para que los docentes compartan el material con sus pares (incluso con los que no implementan ACBD), y difundir el quehacer docente a toda la comunidad, destacando así la importancia de documentar el trabajo en el aula y hacer visible el aprendizaje.
Un mes antes de terminar el semestre, como equipo de UAP, nos reunimos para revisar el material, editarlo y ajustarlo al formato de revista digital. La revista se estructura como un catálogo donde se encuentran las buenas prácticas de las duplas docentes especificando la fase de la rueda de ACBD asociada a la actividad, los materiales que se necesitaron para realizarla, los objetivos que persigue dicha práctica, el desarrollo y el contexto del aula. Este formato permite leer cada práctica como si fuera una receta, para que cualquier docente pueda rescatarla y adaptarla a la realidad de su clase.
Finalmente, en diciembre del 2023, logramos tener nuestra primera versión de la revista “Buenas Prácticas en Aula ACBD”, que tal como hemos mencionado anteriormente, nace de enriquecedoras observaciones de clases y conversaciones sobre prácticas efectivas, reuniendo el valioso aprendizaje y conocimiento generado por docentes y estudiantes, posicionando así un nuevo espacio para el intercambio y la colaboración que esperamos tenga continuidad en el tiempo.
Los invitamos a explorar la revista, donde encontrarán ideas innovadoras y creativas para enriquecer las prácticas pedagógicas. Creemos que el intercambio de buenas prácticas y compartir distintas estrategias no solo fortalece nuestros vínculos como comunidad educativa, sino que también eleva la calidad de la educación que brindamos a nuestros estudiantes.
Observatorio Duoc UC / Anuario 2024 / página 138
Observatorio de la Educación Superior Técnico Profesional - Producción y gestión del conocimiento

Portada de la revista.
¡Nos vemos en la próxima edición!
https://uapsancarlos.notion.site/Repositorio-de-Contenidos-c3b66a2d644047bea07e654570418b0e?p=b26f7b466b3e49b299da19383593d0ce&pm=c
Esta columna de opinión fue publicada el 29 de abril de 2024
Observatorio Duoc UC / Anuario 2024 / página 139
Observatorio de la Educación Superior Técnico Profesional - Producción y gestión del conocimiento
Conoce las Innovaciones de la UAP
San Carlos de Apoquindo para fortalecer la Comunidad Docente


En la Unidad de Apoyo Pedagógico (UAP) de la sede San Carlos de Apoquindo, además de implementar distintos acompañamientos a docentes, nos encontramos desarrollando y efectuando proyectos para apoyar a nuestra comunidad docente. En esta columna, les invitamos a conocer cómo, por medio de la innovación, nos encontramos promoviendo la interacción y comunidad de nuestra Sede.
Newsletter y Comunidad Docente San Carlos de Apoquindo
“Newsletter y Comunidad Docente UAP San Carlos de Apoquindo” es una iniciativa de la UAP de nuestra Sede, que actualmente forma parte de los proyectos locales en ejecución de Innovación Corporativa, de la Dirección de Investigación Aplicada, Innovación y Transferencia. Su principal objetivo es promover la participación de docentes en la elaboración de contenidos digitales junto con la UAP, acercándolos a las TICs, a la educación inclusiva y a las buenas prácticas pedagógicas, a la vez que se promueve la interacción en comunidad. Para cumplir con el objetivo del proyecto, los asesores UAP invitan mensualmente a docentes de la Sede a participar y elaborar algún tipo de contenido, el cual luego es compartido por las redes sociales de la UAP (les invitamos a seguirnos en nuestro Instagram @uapsancarlos). A fin de mes, se envía un resumen de todos los contenidos por medio de un boletín electrónico institucional, el cual se denomina “Newsletter UAP San Carlos de Apoquindo”.
Los contenidos se distinguen por abordar diversas temáticas relacionadas con la educación: de esta manera podemos brindar información y herramientas a nuestros docentes desde múltiples perspectivas. Actualmente, tenemos distintas secciones de nuestros contenidos:
Observatorio Duoc UC / Anuario 2024 / página 140
Observatorio de la Educación Superior Técnico Profesional - Producción y gestión del conocimiento

Docentes junto a asesores UAP.
1. Tecnologías Educativas: “Aula TIC” consiste en recomendaciones de TICs para aplicar en clases.
2. Inclusión: “Un Podcast para la Inclusión” consiste en conversar temáticas de inclusión junto con docentes invitados en formato Podcast; “Tips DUA” consiste en infografías y cápsulas sobre el Diseño Universal de Aprendizaje.
3. Metodologías Pedagógicas: “Educa Tip”: consiste en infografías y cápsulas sobre metodologías de enseñanza-aprendizaje.
4. ACBD: “Activa ACBD”, consiste en breves sketch en los cuales se comparten buenas prácticas de duplas docentes para la implementación de la estrategia de Aprendizaje Colaborativo Basado en Desafíos (ACBD).
5. Libros: “Bibliodato” consiste en reseñas y recomendaciones de libros por parte de los docentes hacia la comunidad educativa.
Un espacio del Newsletter se utiliza para invitar a las actividades que organiza y realiza la UAP, como pueden ser talleres y charlas.
Entre los períodos 2022-1 y 2023-1 se registró una baja participación de los docentes en nuestros talleres, lo que se visualizó como una oportunidad de mejora por parte de nuestro equipo UAP; a partir de esto, hemos reformulado la forma de impartir talleres, y que lo detallamos a continuación.
Observatorio Duoc UC / Anuario 2024 / página 141
Observatorio de la Educación Superior Técnico Profesional - Producción y gestión del conocimiento
Sobre nuestros talleres UAP: Transmisiones en vivo por YouTube
“Talleres 3.0: Live en YouTube, una perspectiva de redes sociales aplicados a talleres UAP” es el nombre del 2do proyecto de Innovación Corporativa de la UAP San Carlos de Apoquindo que actualmente se encuentra en ejecución local. En 2023-2 se implementó el piloto, realizando 2 talleres presenciales que fueron transmitidos por YouTube:
1. Conversatorio ChatGPT – Una Aproximación a las Inteligencias Artificiales y su uso en la Docencia Universitaria”: taller realizado en conjunto con biblioteca de la sede San Carlos de Apoquindo, en el que se abordó el fenómeno de las inteligencias artificiales y su relación con la educación superior.
2. Taller de Retroalimentación Efectiva: taller realizado en período de exámenes, con la finalidad de dar herramientas de retroalimentación efectiva a los docentes.
El principal objetivo de transmitir los talleres en vivo por YouTube es facilitar y ampliar su alcance; de esta manera, pueden participar quienes no estarán físicamente en la Sede, y también podrán revisar la grabación quienes no coincidan con el horario en que se desarrolle el taller.
Desde el punto de vista técnico, este proyecto supone un doble desafío para el equipo de asesores UAP, ya que por un lado se debe elaborar el contenido del taller, con todas sus implicancias: la pertinencia, calidad, profundidad y material didáctico asociado; a la vez que se debe desplegar toda la capacidad técnica para transmitir por YouTube: sistema de audio, sistema de cámaras, creación de escenas en software de transmisión (OBS), conexión entre software OBS y plataforma de transmisión (YouTube), gráfica para la promoción del taller, etc. Es aquí donde cobra mucho valor la multidisciplinariedad de los asesores que conforman el equipo UAP, ya que cada uno puede aportar desde su disciplina y especialidad para llevar a cabo exitosamente el proyecto.
¿En qué más estamos trabajando?
Paralelamente a lo anterior, se implementó un espacio digital como Repositorio de Contenidos, en el que está alojado todo el material de versiones anteriores del Newsletter, para que los docentes puedan revisarlo si es que lo desean. Para ello, se utilizó la herramienta Notion, que permite organizar el material de forma dinámica y simple; además, cuenta con un buscador para que los usuarios lleguen a los materiales que desean utilizando palabras clave.
Por otro lado, en diciembre del 2023 realizamos la primera versión de la Revista Buenas Prácticas ACBD, que recopila buenas prácticas de las duplas docentes a través de actividades que son parte de los desafíos implementados en las clases. A partir del acompañamiento ACBD, las observaciones de clases y conversaciones sobre prácticas efectivas y exitosas, nace esta publicación que reúne aprendizajes y conocimiento de la práctica de docentes y estudiantes.
Observatorio Duoc UC / Anuario 2024 / página 142
Observatorio de la Educación Superior Técnico Profesional - Producción y gestión del conocimiento
Retrospectiva
Los proyectos “ Newsletter y Comunidad Docente UAP San Carlos de Apoquindo” y “Talleres 3.0: Live en YouTube, una perspectiva de redes sociales aplicados a talleres UAP” han significado para la UAP y las unidades académicas, el encuentro con el docente desde una nueva perspectiva: podemos apoyar incluso a aquellos que no cuentan con mucho tiempo para acercarse físicamente a la unidad, y, mejor aún, lo hacemos trabajando junto con rostros conocidos para ellos, sus colegas, aquellos que saludan día a día en los pasillos de la Sede. Creemos que el verdadero valor del proyecto está ahí, en que los docentes pueden ver cómo la UAP trabaja con sus pares y así valorar que de ellos también se puede aprender mucho, pues siempre tienen algo que compartir. Por supuesto, esto también ha conllevado el manejo de redes sociales, de identificar las estrategias óptimas para llegar a nuestra audiencia y analizar qué tipo de contenidos son los que más les interesa.
Los resultados han sido positivos, si nos basamos en las métricas que nos entregan las redes sociales: tenemos actualmente una tasa de engagement del 15% (como referencia, la tasa de engagement media de Instagram es del 3%). A su vez, los Live lograron un alcance significativamente mayor, contando con una media de 61 asistentes por taller (online y presencial). Además, la tasa de apertura de nuestro boletín mensual ronda en torno al 73%. Estos resultados nos indican que nuestra audiencia (docentes de la Sede) interactúan consistentemente con nuestro contenido.
Como perspectiva futura, esperamos que estas iniciativas se mantengan en el tiempo, creciendo e incorporando nuevas secciones y con un mayor alcance, involucrando a más de nuestros docentes y fortaleciendo nuestra comunidad.
Revisa nuestros contenidos:
Instagram UAP San Carlos: https://www.instagram.com/uapsancarlos/
Canal de YouTube (Live): https://www.youtube.com/@uapsancarlos
Un Podcast para la Inclusión: https://open.spotify.com/show/40ls6uyGkJtgA8Kp6xNKl4?si=18d0ce61829d4478
Revisa Buenas Prácticas ACBD: https://www.notion.so/uapsancarlos/Buenas-Pr-cticas-de-ACBD-b26f7b466b3e49b299da19383593d0ce?pvs=4
Observatorio Duoc UC / Anuario 2024 / página 143
Observatorio de la Educación Superior Técnico Profesional - Producción y gestión del conocimiento

Extracto Newsletter marzo 2023.
Esta columna fue publicada el 6 de mayo de 2024
Observatorio Duoc UC / Anuario 2024 / página 144
Observatorio de la Educación Superior Técnico Profesional - Producción y gestión del conocimiento
Curso Digital sobre Convivencia,
Inclusión y Equidad de Género

El curso digital sobre Convivencia, Inclusión y Equidad de Género surge de la preocupación transversal común sobre la necesidad de trabajar en una adecuada convivencia en los Institutos Profesionales y Centros de Formación Técnica pertenecientes a Vertebral.
El curso tiene como objetivo realzar el valor intrínseco de la persona humana, con la finalidad de dar sentido y promoción al trato respetuoso y la sana convivencia. De esta forma, se espera educar a la comunidad educativa en temáticas de convivencia, respeto y dignidad humana y a su vez en la prevención y erradicación del acoso sexual, violencia de género y consentimiento sexual. La modalidad del curso online asincrónico con evaluaciones y registro del estudiante tiene una duración estimada de 140 minutos en total y el estudiante podría hacerlo de manera segmentada.
El formato será en MP4, considerando una opción que pueda ser utilizada de manera transversal por los IP y CFT. Además, se dispondrá de un host virtual al cual podrán acceder aquellas instituciones que así lo requieran.
El curso está compuesto de una serie de videos, algunos en formato de programa de conversación y otros donde hay una persona que va relatando, algunas entrevistas breves, preguntas y en algunos casos, escenas simuladas con actores.
A continuación, se presenta la estructura del curso con sus respectivas temáticas.
Índice del Curso
Introducción
La introducción transmite la preocupación transversal de respetar a los otros, teniendo como base la dignidad humana. El objetivo es comenzar con temáticas transversales más amplias, para dar un sentido positivo a la convivencia, y luego adentrarse en temas a prevenir y abordar, tales como el acoso sexual, violencia y discriminación de género.
Observatorio Duoc UC / Anuario 2024 / página 145
Observatorio de la Educación Superior Técnico Profesional - Producción y gestión del conocimiento
Respeto, Convivencia
y Dignidad de la Persona
Propósito del curso
Temas
Aprendizajes esperados
Rescatar el valor de la persona y promover una convivencia positiva en las personas que conforman la comunidad educativa de las instituciones de educación superior pertenecientes a Vertebral, así como también de sus familias y/o cercanos.
- Qué nos distingue como personas.
- Qué implica la dignidad humana en nuestra relación con otros.
- La importancia de una adecuada convivencia.
- Actitudes y acciones que promueven una sana convivencia.
- Elementos que dificultan la convivencia.
Identificar los elementos que nos distinguen como personas. Recalcar la relevancia sobre la persona como ser único con dignidad. Ahondar en las implicancias que tiene la dignidad. humana en la autopercepción y en la relación con los demás. Conocer qué significa vivir en sociedad. Identificar actitudes y acciones que promueven una sana convivencia. Identificar las acciones que dificultan la convivencia. Reflexionar sobre la importancia de una sana convivencia, teniendo a la base el respeto a la dignidad de cada persona.
Formato
Duración
Derechos Humanos
Propósito del curso
Temas
Aprendizajes esperados
Programa de conversación
30 minutos
Formato
Duración
Conocer y comprender el concepto de derechos humanos y su origen, y reflexionar sobre los principios de igualdad y no discriminación.
El concepto de derechos humanos y su origen. El fundamento de los derechos humanos y sus características. Los límites y deberes que imponen los derechos humanos derivados de la vida en comunidad y el reconocimiento constitucional de los derechos humanos. Los principios de igualdad y no discriminación como elementos en los que se funda el derecho internacional de los derechos humanos.
Comprender el origen de los derechos humanos. Qué significa que estos sean inherentes a la persona humana. Cuál es la diferencia conceptual entre derechos humanos y derechos fundamentales. Cuáles son las características de los derechos humanos. Reflexionar sobre el reconocimiento constitucional de los derechos humanos. La relevancia del principio de igualdad y no discriminación.
Programa de conversación
20 minutos.
Observatorio Duoc UC / Anuario 2024 / página 146
Observatorio de la Educación Superior Técnico Profesional - Producción y gestión del conocimiento
Diversidad
Propósito del curso
Temas
Aprendizajes esperados
Formato
Duración
Acoso Sexual
Propósito del curso
Temas
Entender qué es la diversidad junto con sus desafíos, y entregar herramientas para la vida en comunidades diversas.
Definición de Diversidad. Desafíos para la vida en Diversidad. Herramientas para lidiar con los desafíos de la vida en comunidades diversas.
Entender el concepto de diversidad y sus implicancias. Comprender el valor de la diversidad. Obtener herramientas para los desafíos de la vida en comunidades diversas.
Programa de conversación
20 minutos
Aprendizajes esperados
Formato
Duración
Este curso se compone de dos unidades, donde profundiza sobre definición y características del acoso sexual y las prácticas constitutivas del acoso sexual y las manifestaciones físicas de acoso.
Definición y características del acoso sexual. Las prácticas constitutivas del acoso sexual y las manifestaciones físicas del acoso.
Definir qué es el acoso sexual y sus principales características, de acuerdo a la legislación vigente. Distinguir las diversas prácticas constitutivas de acoso sexual y manifestaciones físicas de acoso.
Escenas actuadas
19 minutos
Observatorio Duoc UC / Anuario 2024 / página 147
Observatorio de la Educación Superior Técnico Profesional - Producción y gestión del conocimiento
Consentimiento Sexual
Propósito del curso
Temas
Aprendizajes esperados
Este curso tiene dos unidades donde profundiza sobre: La importancia de la dignidad, la prudencia y el respeto a la libertad personal y el consentimiento sexual. La importancia de la dignidad, la prudencia y el respeto a la libertad personal. El consentimiento sexual.
Ser capaz de reconocer la importancia y comprender lo que significa el respeto a la dignidad humana de todas las personas. Conocer sobre lo que significa el respeto a la libertad personal. Comprender la virtud de la prudencia a la hora de tomar decisiones con respecto a la sexualidad. Aprender qué es el consentimiento sexual, cuáles son sus alcances, cuándo lo hay y cuándo éste está viciado.
Formato
Duración
Escenas actuadas
16 minutos
Violencia Sexual, Violencia y Discriminación de Género
Propósito del curso
Temas
Aprendizajes esperados
Formato
Duración
Cierre del Curso
Este curso se compone de un foro y un storyline, donde profundiza sobre: la definición de discriminación de género, definición de violencia de género y la definición de violencia sexual.
¿Qué es la discriminación de género? Estereotipos de género. Violencia de género y sexual.
Distinguir la discriminación de género. Identificar diferencias entre igualdad y equidad de género. Consecuencias de la discriminación de género. Reflexionar sobre los estereotipos de género. Reflexionar sobre actos de violencia de género y sexual según Ley 21.369.
Foro y storyline
20 minutos
Video de 2 minutos en que se exponen las ideas centrales del curso, poniendo especial énfasis en el valor de la convivencia, la dignidad de la persona y la excelencia, con una mirada positiva y motivadora.
Esta columna de opinión fue publicada el 15 de enero de 2024
Observatorio Duoc UC / Anuario 2024 / página 148
Observatorio de la Educación Superior Técnico Profesional - Producción y gestión del conocimiento
Día del Técnico Profesional:
82 Años de progreso y desafíos

Durante años la educación, buenamente, se tomó del debate público. Con una política pública expansiva, Chile se convirtió en el país de Latinoamérica con las mejores tasas de cobertura y años de formación apostando en la educación, el desarrollo y progreso de toda una sociedad y de una generación. Hoy, como cada 26 de agosto, celebramos el día de la Educación Técnico Profesional, sector que ha aportado signifi cativamente en la obtención de ese reconocimiento. En Chile, 1.277.000 personas estudian en alguna institución de educación superior, y cerca del 45% de ellas lo hace en una Institución Técnico Profesional.
En nuestra región más de 46.700 estudiantes son parte del sector TP en la educación superior, desarrollándose en alguna de las múltiples carreras y disciplinas altamente vinculadas con la industria y con una fuerte vocación por el aprendizaje práctico y contextualizado. Alcanzada la cobertura, debemos ir más allá.
Los desafíos del mercado laboral, los cambios de los entornos sociales y las nuevas oportunidades que se presentan gracias a los impresionantes avances tecnológicos nos hacen pensar en cómo enfrentaremos la nueva era en la que estamos. La práctica docente está evolucionando hacia nuevos estados donde las herramientas de IA se deberán incorporar en su quehacer, teniendo como desafío el docente el poder ser un diseñador de experiencias de aprendizajes yendo más allá de la formación tradicional que conocemos. Y en este nuevo escenario, el mundo TP lleva la vanguardia.
La formación por competencias y capacidades, con un alto contenido práctico, permite que los estudiantes puedan adoptar de mejor manera las nuevas tecnologías que se desarrollan en el aula. Este aprendizaje contextualizado y dinámico será fundamental para poder adaptarse a un mundo laboral
Observatorio Duoc UC / Anuario 2024 / página 149
Observatorio de la Educación Superior Técnico Profesional - Producción y gestión del conocimiento
cada vez más cambiante. Pero en esta línea, no basta con las capacidades de las instituciones de adecuar sus planes formativos. Así como la cobertura fue parte de la estrategia de Chile en materia educacional, hoy la política pública debe estar orientada a incentivar que la flexibilidad y las diferentes modalidades de aprendizaje para todas las instituciones que pretendan liderar la educación superior en nuestro país.
Lamentablemente los incentivos están puestos justamente en rigidizar cada vez más un sistema que necesita cambiar para generar un salto en calidad. Chile, un largo país de más de 4.000 km. de largo debe aprovechar las bondades que la tecnología nos entrega para poder llegar a cada lugar con planes flexibles y con alta calidad. Recientemente desde Duoc UC, en colaboración con el TEC de Monterrey, lanzamos la herramienta “Docente Holograma”, una tecnología que nos permite acercar a los mejores docentes de la industria con nuestros estudiantes en cualquier rincón de nuestro país rompiendo las barreras de la distancia. La tecnología está, razón por la cual se hace imperativo modifi car nuestras políticas de educación superior para poder expandir con fuerza este tipo de iniciativas y no estancarnos en una legislación no acorde con los nuevos tiempos.
Hoy a 82 años de aquel 26 de agosto de 1942, día en el que se dio por primera vez reconocimiento ofi cial al sector TP, soñamos con la construcción de una visión de futuro que nos permita seguir aportando para el desarrollo de una sociedad mejor. ¡Feliz día del Técnico Profesional!
Esta columna fue publicada el 2 de septiembre de 2024
Observatorio Duoc UC / Anuario 2024 / página 150
Observatorio de la Educación Superior Técnico Profesional - Producción y gestión del conocimiento
Discurso Cuenta Anual
2023 de Duoc UC

Un saludo a las autoridades del Directorio de la Fundación Duoc UC, al rector Díaz y su equipo de directivos, también y de manera especial al cuerpo académico y a los estudiantes[1]. Saludo a Monseñor Alberto Lorenzelli, le agradezco su presencia.
Quisiera extender mis más sinceras felicitaciones a todos aquellos que hoy recibirán premios y reconocimientos en los ámbitos administrativo, docente y estudiantil. Esta iniciativa de premiar a estudiantes que representan con éxito nuestros valores institucionales es de particular importancia, como también lo son los tradicionales reconocimientos institucionales a los docentes y administrativos más destacados en cada una de las sedes el año 2023.
Juntos, como indica nuestro himno de Duoc UC, caminamos y sembramos una semilla para el futuro. El himno que inspira nuestra misión en Duoc UC, con fe y esperanza, resume de manera integral lo que deseamos para esta gran institución.
Permítanme hoy destacar cuatro aspectos que son clave en nuestro proyecto:
Primero, quisiera expresar mi más sincero agradecimiento. En marzo del próximo año cumpliré quince años como rector de la UC, y esta será mi última participación en una cuenta anual en Duoc UC. Aunque participaré en otras actividades hasta marzo, quiero agradecerles y felicitarlos efusivamente desde lo personal e institucional. He sido testigo del significativo crecimiento de nuestra institución en estos
[1] Pronunciado el día jueves 4 de julio en el campus san Joaquín de Duoc UC.
Observatorio Duoc UC / Anuario 2024 / página 151
Observatorio de la Educación Superior Técnico Profesional - Producción y gestión del conocimiento
quince años, no solo en términos de estudiantes y sedes, sino también en calidad, pertinencia y bienestar estudiantil. Hemos avanzado curricularmente, consolidando un cuerpo académico comprometido y viendo cómo nuestras sedes a lo largo del país interactúan y trabajan en diversos territorios. Es importante reflexionar y dar gracias a Dios por este crecimiento, ya que detrás de cada egresado hay un progreso significativo para una familia y una mejora en su estándar de vida. Este crecimiento es un esfuerzo comunitario que siembra esperanza para el futuro del país y de nuestros ciudadanos.
En segundo lugar, quiero felicitar al rector, al vicerrector académico y a toda la comunidad por el excelente trabajo en el proceso de acreditación institucional. Aunque aún no tenemos el resultado final, el Informe de salida es muy positivo, al igual que la evaluación de la comunidad y el Informe de Autoevaluación institucional. Estoy convencido de que obtendremos un gran resultado final y creo que es oportuno reconocer el extraordinario trabajo realizado. Reitero, es toda la comunidad la que merece este reconocimiento.
Tercero, me llena de alegría ver los proyectos conjuntos entre la Universidad y Duoc UC. Mañana, por ejemplo, participaremos en una iniciativa de reciclaje de artículos electrónicos y eléctricos, importante para nuestra sostenibilidad y compromiso con el carbono neutralidad. Este es solo un ejemplo de los muchos proyectos en los que trabajamos juntos, como en programas para niños y jóvenes con Síndrome de Down, el programa ELEDUC para reclusas en proceso de libertad, articulación para programas de formación general y la organización del Festival de Innovación y Futuro. Estos esfuerzos los que se han presentado en el Festival muestran nuestro compromiso con la innovación, el emprendimiento y la inclusión, integrando a personas con discapacidad visual y contribuyendo sustancialmente al país. Hay mucha creatividad e innovación que se demuestra en este Festival.
Finalmente, quiero destacar la importancia del futuro, un futuro con fe y esperanza, como dice nuestro himno. Ambas instituciones, la Universidad en el ámbito universitario y Duoc UC en la Educación Técnico Profesional, tenemos la misión de liderar desarrollos significativos en innovación docente y nuevas metodologías. Es crucial mantener la relación personal entre el profesor y el estudiante, recordando que la educación es un encuentro personal que saca y entrega lo mejor de cada uno para el servicio de los demás. Además, debemos enfocarnos en la internacionalización de nuestro quehacer para participar de un mundo global, la ética aplicada en nuestra formación, aspecto fundamental en la formación de nuestros estudiantes y la interculturalidad en nuestro país para poder ampliar oportunidades a nuestros pueblos originarios y población indígena. Es fundamental que nuestras instituciones se abran a la diversidad y aprendan de aquellos que eligen nuestro país para desarrollar su vida.
Tenemos grandes desafíos y la responsabilidad de comprometernos con el desarrollo de nuestra nación, compartiendo e irradiando lo mejor de nuestras prácticas. Que nuestro Señor Jesucristo y nuestro Patrono San José nos acompañen en este camino y que la identidad católica de nuestras instituciones se fortalezca cada día para servir mejor a los chilenos y chilenas. Muchas gracias y que tengamos una excelente jornada.
Esta columna fue publicada el 8 de julio de 2024
Observatorio Duoc UC / Anuario 2024 / página 152
Observatorio de la Educación Superior Técnico Profesional - Producción y gestión del conocimiento
Discurso de finalización de la Jornada de jefes de UAP 2023

Sebastián Sánchez Díaz. Director de Formación y Desarrollo Docente de Duoc UC.
Un atento saludo para cada una de las personas presentes en esta veraniega tarde santiaguina. Es para mí muy satisfactorio poder estar con ustedes, una vez más, en el marco de estas jornadas presenciales que tanto bien nos hacen y que queremos mantener, al menos una vez al año.
¡Gracias! Muchas veces muchas gracias por el trabajo, disposición, esfuerzo, compromiso, desafíos emprendidos y logros alcanzados.
Un especial reconocimiento para la UAP de Valparaíso, Plaza Norte y el Equipo Central por su participación en el reciente ECAD. Del mismo modo, es preciso destacar el aporte de la UAP Viña del Mar al publicar junto con Carmen Luz Barría y Karina Carrasco, una resumida historia de estas unidades de apoyo en el Boletín Digital número 62 del Observatorio de la ESTP de Duoc UC de septiembre pasado.
Al respecto una primera solicitud: Escriban. Dejen por escrito lo que hacen, participen en congresos, seminarios, publicaciones. Tenemos mucho que aportar desde las experiencias que se desarrollan en cada una de las sedes. Compartámoslo. Quisiera ver, por lo menos, durante el año 2024 la participación del 75% de las UAP en diferentes eventos académicos y, a la totalidad, generando artículos sobre su quehacer. Es parte importante de nuestra responsabilidad.
Dentro de los objetivos trazados para la presente jornada se han expuesto las acciones realizadas por las UAP, los logros más destacados y, también, se han planteado proyecciones. Creo que al escuchar lo realizado habrán podido sentir un sano orgullo por lo efectuado y la amplitud de ello.
Hoy, también han trabajado sobre el modelo de evaluación de desempeño de los asesores de las Unidades de Apoyo Pedagógico, aspecto que también está conectado con los itinerarios formativos de cada persona que cumple las funciones de asesoría y las respectivas implicancias que tiene para su desarrollo profesional como personal.
Observatorio Duoc UC / Anuario 2024 / página 153
Observatorio de la Educación Superior Técnico Profesional - Producción y gestión del conocimiento
Asimismo, han podido seguir acercándose a temas de los cuales ustedes no podrán obviar ni deben evitar: La Inteligencia Artificial Generativa. Ustedes alcanzarán a vivir situaciones de demasiada ficción hasta hace poco: por ejemplo, la introducción de un dispositivo en la corteza frontal del cráneo que significará una comunicación no verbal entre las personas, o bien la discusión que ya se está dando en Corea del Sur, sobre los derechos de los llamados robots.
Más allá de las evidentes consecuencias que se tienen y tendrán en los espacios laborales y en los tipos de trabajo, el asunto tiene una fuerte carga ética: ¿Es posible que las máquinas alcancen más conocimiento que los humanos? ¿Es imaginable la imaginación en la robótica? ¿Cómo el humano será más humano? ¿Cómo será la legislación para carreteras colmadas de vehículos sin conductor? Debemos pensar en cómo integramos los avances tecnológicos al proceso de aprendizaje enseñanza. ¿Será necesario aprender todo o solo lo sustancial y el resto que quede alojado en máquinas? En fin, ustedes me entienden… La idea al final es ¿cómo podemos aprender de estos temas para poder compartirlos con el estamento estudiantil?
Sin duda la educación está cambiando. Un problema y un sentido puedo observar con claridad. El problema: la escasa agilidad y rapidez con que se dan los cambios educacionales, si es que se dan. El sentido: no solo se trata de cambiar, se requiere que lo hagamos bien.
Claramente cambiar es difícil. Al menos se necesitan tres elementos: creer que el cambio es necesario, querer hacerlo y saber hacerlo.
Antes de comenzar un proceso de transformación hay que convencer a quienes van a protagonizarlo, o a sufrirlo, de la necesidad de hacerlo. John Kotter señala que el error principal que se comete cuando se quiere cambiar una organización es «lanzarse a ello sin establecer un consenso suficiente sobre su urgencia».
Otras veces, la necesidad de cambio se atribuye a motivos socio económicos. Hemos entrado en la sociedad del conocimiento, que necesita mano de obra muy cualificada para progresar. Está ya demostrado que cualquier progreso tecnológico exige un nivel nuevo de educación. Según el Foro Europeo desde ahora al año 2030, Europa necesita crear 46 millones de puestos de trabajo de alto nivel. Si Europa no es capaz de hacerlo, lo hará China o India.
¿Y en Chile? ¿Cuántos puestos de trabajo, de alto nivel, serán ocupados por personas que estudian en Duoc UC?
Según el estudio reciente de McKinseyen la gente joven tiene tres veces más posibilidades que sus padres de estar en estado de cesantía.
Una de las disfunciones más graves de nuestro sistema educativo es que se está convirtiendo en una fábrica de cesantes. Por otra parte, el ritmo de desarrollo de la tecnología y su aplicación al aprendizaje están creando nuevas posibilidades que simplemente se desarrollarán fuera de la educación superior y solo para algunos. Surgiría así una nueva separación de clases sociales, y de hecho ya ha comenzado a ocurrir. Me crean o no, el poder del conocimiento está abandonando las instituciones de educación superior y se está centrando en las grandes empresas del conocimiento, llámese Google, Meta, Microsoft, etc.
También McKinsey, pero hace ya más de treinta años, publicó un libro titulado “La guerra por el talento.” Su tesis era que entrábamos en una era en que el talento iba a ser la gran riqueza de las personas y de las naciones, que era un bien escaso, y que iba a comenzar una guerra por atraer y conservar el talento. En aquel momento, los autores no se percataron de que el talento no es un bien natural, como el cobre, ni innato,
Observatorio Duoc UC / Anuario 2024 / página 154
Observatorio de la Educación Superior Técnico Profesional - Producción y gestión del conocimiento
como el color de los ojos, sino el resultado de la educación, que se convierte así en gran generadora de talento. Las naciones inteligentes se han dado cuenta de que poseen gigantescos yacimientos de talento que tienen que poner en explotación. ¿Y nosotros en Duoc UC?
Por otra parte, hemos de saber desarrollar la motivación del conjunto estudiantil. Hay que despertar emociones, hacer atractivos los fines, manejar los incentivos necesarios —y en ocasiones también las sanciones—, eliminar miedos, convencer de la posibilidad del éxito. Y, como última gran motivación, hay que afirmar la imperiosa obligación ética que debe impulsarnos. Sin embargo, la motivación sirve de muy poco sino existen objetivos claros y metas definidas a las que dirigirse.
Como dijo Antoine de Saint- Exupéry: «No podemos dar soluciones, pero podemos despertar las fuerzas que las encuentren».
Lo que vamos señalando nos obliga a repensar la educación y cómo hacemos educación. En nuestros días, es un hecho que todos los ciudadanos, todas las profesiones y sectores sociales van a tener que aprender a lo largo de toda su vida. Por eso es por lo que ya no hablamos de la sociedad de la información, o de la sociedad del conocimiento, ya que los estudios más recientes nos localizan en la sociedad del aprendizaje. La escuela tendrá que asumir un papel nuevo para ayudar a constituirla, porque deberá preparar a sus alumnos y alumnas para estar en condiciones de aprender siempre. La educación terciaria se ha de renovar en forma permanente y así también serán sus exalumnos/as, alumnos y alumnas permanentes. Así el sistema educativo en su conjunto podrá verse beneficiado pues la sociedad entera valorará el aprendizaje.
Irán comprendiendo el enorme desafío que hemos de plantearnos como Unidades de Apoyo Pedagógico y particularmente ustedes como responsables de aquellas: Despertar el interés por la formación de nuestros docentes, mostrarles esta sociedad del aprendizaje en la que todos los individuos se desarrollen, despertar e incentivar el deseo de aprender, favorecer los modos existentes de formación y proponer otros nuevos.
En la sociedad de aprendizaje que esbozamos, también las organizaciones aprenden, el concepto se acuña dado que más importante que el aprendizaje individual resulta ser el del colectivo organizacional que, normalmente, es mayor a la suma de los aprendizajes individuales.
Para Mayo y Lanck el concepto de las organizaciones que aprenden puede llegar a comprenderse si compartimos que: “la supervivencia en un mundo rápidamente cambiante depende de la adaptabilidad, la adaptabilidad depende de la capacidad de aprender, y la capacidad de aprender depende de la motivación para el aprendizaje continuo de todo el personal de una organización en un entorno de apoyo al aprendizaje.”
Como se puede ir concluyendo, nosotros aprendemos, Duoc UC aprende, en la medida que va aumentando sus niveles de colaboración y autonomía; cuando comienza a superar los estándares prescritos y en el momento en que sus miembros comienzan a dialogar, debatir y consensuar su quehacer profesional.
Antonio Bolívar nos ayuda cuando señala: “es sólo cuando los profesores están continuamente aprendiendo y pensando sobre cómo mejorar su práctica cuando pueden colectivamente crear las óptimas condiciones para el aprendizaje de los estudiantes”. También es elocuente el mensaje de Paulo Freire, hace ya medio siglo, cuando invitaba a los profesores a desarrollar “la práctica de analizar la práctica”. Es lo que hacemos y lo que debemos hacer.
Sobre la base de los elementos mencionados podemos ir delineando los contornos de una comunidad de aprendizaje donde se analizará, discutirá y reflexionará acerca del quehacer práctico, compartirá sus
Observatorio Duoc UC / Anuario 2024 / página 155
Observatorio de la Educación Superior Técnico Profesional - Producción y gestión del conocimiento
experiencias y definirá su nueva práctica; en un proceso de carácter cíclico que continuamente estará entregando nuevos recursos al diálogo que serán procesados en común para generar, por medio de la deliberación, nuevos productos que al ser utilizados regresarán en forma de recurso a la discusión profesional.
Muy respetadas y respetados responsables de la Unidades de Apoyo Pedagógico, vaya para ustedes la segunda solicitud: les invito y a la vez les pido, encarecidamente, que en el año 2024 se constituyan en el mejor ejemplo de comunidad de aprendizaje. Este es el gran aporte que les insto a realizar para Duoc UC durante el próximo año, de conformidad a ello, el 2025, podremos ir constituyendo estas comunidades en cada una de las sedes.
Carmen Luz Barría, Karina Carrasco, soy consciente de todo el arduo trabajo que han realizado desde Casa Central, sé bien que se han dado pasos, ahora tenemos que consolidarlos. Necesitaremos de una férrea rigurosidad por parte de cada cual, del mayor de los compromisos, involucramiento y participación.
Requerimos de cada jefatura de UAP que crean y se jueguen por este objetivo. Es la gran tarea que les pido. Tengo claro de que no es la única; también han de realizar los acompañamientos al estamento docente con la mayor prolijidad; han de implementar la evaluación de pares como parte de la evaluación del desempeño; han de articularse con directores de carrera, jefes de programas transversales y autoridades de la sede; han de promover buenas prácticas entre los docentes y considerar el perfil vigente y el nuevo Plan de Formación. De la misma forma, ustedes han de autorregularse y generar sus propias actividades formativas.
Como ustedes saben, en Duoc UC, creemos en la centralidad del estudiante. Al mismo tiempo, sabemos que nada puede reemplazar el importantísimo papel que tiene el estamento docente en el proceso de aprendizaje estudiantil; es por ello por lo que nos queremos movilizar hacia espacios reflexivos y autocríticos, comprensivos, inclusivos y no solo integradores, equitativos y no igualitarios, atentos a la diversidad, plurales, competentes y no competitivos, comprometidos con el entorno y la mejora social. Teniendo siempre presente que Duoc UC es una institución católica y aquello es central en su identidad. Ello significa una decidida opción por el Evangelio, es decir, siempre abiertos a invitar a la comunidad a conocer a Cristo.
Ya casi finalizando, permítanme citar a Andy Hargreaves y Michael Fullan cuando señalan: “Es imposible llevar a cabo las metas más profundas del aprendizaje de los estudiantes sin que los profesores sean aprendices también continuamente. Para que los alumnos lleguen a ser mejores aprendices, los profesores deben aprender también como llegar a ser mejores aprendices. Los estudiantes llegan a ser buenos aprendices cuando están en clases de profesores que son buenos aprendices”.
Termino recordándoles mis dos solicitudes para el año 2024:
Primero: Participen en eventos académicos y escriban.
Segundo: Conviértanse en un ejemplo de comunidad de aprendizaje.
Esta columna de opinión fue publicada el 8 de enero de 2024
Observatorio Duoc UC / Anuario 2024 / página 156
Observatorio de la Educación Superior Técnico Profesional - Producción y gestión del conocimiento
Docentes y titulados de
Duoc UC al rescate de nuestro patrimonio

En el mes del Patrimonio cultural, como Escuela de Comunicación, nos resulta relevante destacar el trabajo profesional que realizan nuestros docentes y titulados de la carrera de Actuación de la sede San Carlos de Apoquindo. Las profesoras Carolina Rebolledo y Carolina Araya, ambas actrices y directoras teatrales formadas en la Universidad Católica, han creado la compañía de teatro “La Dramática Nacional” que se ha destacado por su compromiso con la preservación y difusión del patrimonio cultural de Chile a través de la puesta en escena de obras teatrales de gran relevancia histórica y social. Esta compañía ha logrado no solo mantener viva la tradición teatral chilena, sino también incluir en la compañía rotativamente y, como elenco estable, a 6 titulados de la carrera de Actuación, fomentando así su desarrollo profesional al colaborar con actores profesionales de reconocida trayectoria artística como Hugo Medina e Iñigo Urrutia, entre varios otros.
La Compañía de Teatro “La Dramática Nacional” ha generado un proyecto multidisciplinario, ganador de FONDART en varias oportunidades (años 2014, 2015, 2016, 2017, 2023, 2024), cuyo objetivo principal es poner en escena textos clásicos de la historia teatral chilena. Los contenidos histórico-sociales y folclóricos son asesorados por el Premio Nacional de Historia Gabriel Salazar y por el destacado Folclorista nacional Osvaldo Cádiz.
La apuesta artística la realiza un elenco numeroso que integra actuación, canto, bailes tradicionales, música en vivo y pantalla cinematográfica con imágenes de archivo histórico. La relevancia de estas producciones se centra además en el objetivo de asegurar que se mantengan fieles a las raíces culturales y patrimoniales de las historias que representan.
Observatorio Duoc UC / Anuario 2024 / página 157
Observatorio de la Educación Superior Técnico Profesional - Producción y gestión del conocimiento

Obras patrimoniales de Chile
La compañía ha elegido obras que son pilares del patrimonio teatral chileno, tales como “Chañarcillo”, “Chiloé cielos Cubiertos”, “La Canción Rota” y “Almas Perdidas”. Cada una de estas obras aborda aspectos fundamentales de la identidad y la historia chilena.
“Chañarcillo”, escrita por Antonio Acevedo Hernández, es una obra que explora la vida en las minas de plata en el norte de Chile durante el siglo XIX. Muestra la dureza de la vida minera y la lucha por la supervivencia y la dignidad humana.
“Chiloé cielos Cubiertos”, de María Asunción Requena, lleva al público a la mágica isla de Chiloé, explorando las leyendas, las tradiciones y la vida cotidiana de sus habitantes, con un acercamiento profundo a las raíces folclóricas y mitológicas de esta región.
“La Canción Rota”, de Luis Rivano, se centra en la vida urbana y las complejidades sociales de Santiago en la segunda mitad del siglo XX. La obra examina los desafíos de la vida en la ciudad y las aspiraciones y tensiones que marcan la dinámica urbana.
“Almas perdidas”, del dramaturgo chileno Antonio Acevedo Hernández, se centra en la vida de un grupo de personajes marginales en un barrio pobre de Santiago a principios del siglo XX. Expone las realidades de los sectores más desprotegidos de la sociedad chilena.
Observatorio Duoc UC / Anuario 2024 / página 158
Observatorio de la Educación Superior Técnico Profesional - Producción y gestión del conocimiento

Integración de actores profesionales y titulados
Uno de los aspectos más notables de las producciones de “La Dramática Nacional” es la colaboración entre actores profesionales y actores titulados de la carrera de Actuación de Duoc UC. Esta integración es beneficiosa en múltiples niveles. Para los actores titulados, trabajar junto a profesionales experimentados les permite adquirir habilidades prácticas y conocimiento del oficio que son esenciales para su desarrollo profesional. A su vez, los actores profesionales se benefician de la energía, la frescura y las nuevas perspectivas que los jóvenes actores aportan al proceso creativo.
Éxito de público e impacto educativo y cultural para la comunidad
Las obras han sido exhibidas en diferentes y reconocidos teatros de nuestro país como Anfiteatro Bellas Artes, Centro Cultural M100, Teatro Nacional Chileno, Teatro San Ginés, Parque Cultural Valparaíso, entre muchos otros. Además, han realizado giras artísticas por diversas regiones de Chile presentándose en los mejores teatros del norte de nuestro país. Respecto del público que ha visto sus creaciones, han obtenido un éxito tan considerable que han logrado ser la obra más vista durante el año del Teatro Matucana 100. Además, han formado parte de la Festival Santiago Off que los ha programado anualmente en los Ciclos y Festivales teatrales nacionales en diversos territorios. Hasta hoy llevan más de 100 funciones realizadas con un mínimo de 200 espectadores por función, lo que suma más de 20.000 espectadores.
Reconocimiento de la crítica: Innovación en la preservación del patrimonio
El trabajo de la Compañía es reconocido por la crítica especializada, que ha publicado en diversos medios de prensa (como Artes y Letras de El Mercurio, La Nación, Biobío Chile, Universidad de Chile entre otros y
Observatorio Duoc UC / Anuario 2024 / página 159
Observatorio de la Educación Superior Técnico Profesional - Producción y gestión del conocimiento

en distintos medios regionales) que la combinación de métodos tradicionales de actuación con técnicas y enfoques contemporáneos es otro aspecto destacable del trabajo de La Dramática Nacional. La crítica destaca la innovación en la manera en que la compañía presenta estas obras patrimoniales pues incorpora elementos contemporáneos en la puesta en escena logrando hacer que estas historias sean accesibles y relevantes para el público actual, sin perder de vista su esencia histórica y cultural.
Desafíos y logros
Dirigir una compañía de teatro que se dedica a obras patrimoniales implica una serie de desafíos. Entre ellos, la necesidad de investigar y comprender a fondo el contexto histórico y social de cada obra, así como la responsabilidad de representar de manera auténtica y respetuosa las diversas culturas y comunidades que se retratan. La compañía, formada por docentes y titulados de Duoc UC, han demostrado ser capaces de enfrentar estos desafíos con éxito, logrando producciones que son tanto educativas como emocionalmente resonantes. Sus logros en este ámbito son numerosos. Han logrado producir obras que no solo entretienen, sino que también educan e inspiran al público, invitándolo a reflexionar sobre su identidad y su historia. Además, han creado un espacio de aprendizaje y crecimiento para los titulados de Actuación, dándoles la oportunidad de trabajar en un entorno profesional y adquirir experiencias valiosas que les servirán a lo largo de sus carreras. La compañía no solo ayuda a preservar importantes obras de teatro chilenas, sino que también promueve un sentido de identidad y pertenencia en el público. Al destacar las historias y las voces que han dado forma a la nación, “La Dramática Nacional” asegura que el patrimonio cultural de Chile continúe vivo y vibrante, inspirando a futuras generaciones a valorar y celebrar su rica herencia cultural.
Observatorio Duoc UC / Anuario 2024 / página 160
Observatorio de la Educación Superior Técnico Profesional - Producción y gestión del conocimiento


Esta columna fue publicada el 17 de junio de 2024
Observatorio Duoc UC / Anuario 2024 / página 161
Observatorio de la Educación Superior Técnico Profesional - Producción y gestión del conocimiento
El Poder del Podcast:
Potenciando habilidades y conocimiento en la sede Plaza Norte


En el vertiginoso mundo de la tecnología y la comunicación, la educación superior debe mantenerse a la vanguardia para ofrecer a sus estudiantes herramientas y experiencias que potencien sus habilidades y competencias. En la sede Plaza Norte, hemos adoptado esta premisa y la hemos llevado a la práctica a través de iniciativas innovadoras como nuestro proyecto de podcast “A Micrófono Abierto”.

Observatorio Duoc UC / Anuario 2024 / página 162
Observatorio de la Educación Superior Técnico Profesional - Producción y gestión del conocimiento
“A Micrófono Abierto” es mucho más que un simple podcast: es una plataforma dinámica donde convergen el conocimiento, la creatividad y la tecnología para proporcionar a nuestros estudiantes una experiencia enriquecedora y profesional, por medio de las comunicaciones. Este programa, concebido para explorar temas de interés público, desde la ciencia y la tecnología hasta la cultura y la innovación, ha sido una herramienta crucial para mejorar las habilidades comunicacionales de nuestros estudiantes, permitiéndoles participar activamente en discusiones relevantes y actuales.
El formato del programa es simple pero efectivo: un moderador del equipo de comunicaciones de la sede, un estudiante del área de interés y un invitado experto en el tema. Esta configuración asegura que la conversación fluya de manera óptima y que los estudiantes tengan la oportunidad de interactuar directamente con profesionales, enriqueciendo su comprensión y apreciación de los temas tratados.

Durante la primera temporada, abordamos temas tan variados como “¿Qué es la Sociedad 5.0?” con el Vicerrector Académico Kiyoshi Fukushi, “Los retos y oportunidades de los e-sports”, “El uso de la inteligencia artificial”, y “El camino del emprendimiento”, entre otros. Cada episodio reflejó el entusiasmo y el compromiso de nuestros estudiantes, quienes se involucraron profundamente en cada producción, demostrando su capacidad para investigar, analizar y comunicar de manera efectiva.
Impacto estadístico y posicionamiento
Desde octubre de 2023 hasta febrero de 2024, “A Micrófono Abierto” logró más de 4.630 reproducciones en sus 14 episodios, una cifra que subraya el éxito y la aceptación de este proyecto entre nuestro público. Además, este podcast ha contribuido significativamente a posicionar a la sede Plaza Norte en la creciente comunidad de YouTube, aumentando nuestra visibilidad y crecimiento en número de seguidores.
Observatorio Duoc UC / Anuario 2024 / página 163
Observatorio de la Educación Superior Técnico Profesional - Producción y gestión del conocimiento

Beneficios para los Estudiantes
Participar en este tipo de proyectos ofrece innumerables beneficios para los estudiantes de educación superior. Primero, mejora sus habilidades comunicacionales y de pensamiento crítico, competencias esenciales en el mundo laboral actual (como lo menciona la estudiante Yuyunis Mardones de la carrera de mecánica en el capítulo 9 de la primera temporada). Segundo, les brinda una plataforma para expresar sus ideas y conocimientos, fomentando la confianza y la creatividad. Finalmente, les proporciona una experiencia práctica con equipos y formatos de producción de alta calidad, acercándolos a los estándares profesionales y preparándolos mejor para sus futuras carreras.
Para concluir
En la sede Plaza Norte creemos firmemente en el poder transformador de la tecnología en la educación. Iniciativas como “A Micrófono Abierto” no solo mejoran la experiencia de aprendizaje de nuestros estudiantes, sino que también los preparan para enfrentar los desafíos del futuro con confianza y habilidad. Al integrar herramientas tecnológicas de vanguardia y fomentar una cultura de innovación y calidad, seguimos comprometidos con la formación de profesionales íntegros y competentes, capaces de hacer una diferencia significativa en la sociedad.
Esta columna fue publicada el 22 de julio de 2024
Observatorio Duoc UC / Anuario 2024 / página 164
Observatorio de la Educación Superior Técnico Profesional - Producción y gestión del conocimiento
Entrevista al sacerdote
Pablo Leiva Rojas
¿Cómo describiría la experiencia de visitar Lourdes y cómo influyó en su identidad sacerdotal?
Fue una experiencia hermosa y enriquecedora ya que me permitió “saborear” la fe sencilla del pueblo de Dios y vivir un momento muy profundo, desde la fe en un lugar tan particular y querido de la Iglesia.
Para mi identidad sacerdotal fortalecer el amor y compañía de la Virgen María en mi ministerio y vida sacerdotal, reconociéndola como Madre y compañera de camino.
¿Cómo percibió el amparo mariano durante su visita a Lourdes?
Valorar la cercanía de María, como madre de la Iglesia y auxilio de los cristianos.
¿Hubo algún momento en Lourdes que haya tenido un impacto particular en su vocación?
Las dos procesiones: La de los enfermos, a los que debo acompañar en mi vida sacerdotal; y la de las velas, recordándome que estoy llamado a ser luz de Cristo en el mundo.
Retiro en Ars:
¿Qué diferencias notó entre la experiencia en Lourdes y el retiro en Ars en términos de fortalecimiento de tu identidad sacerdotal?
En Lourdes la fuerte invitación a vivir reconociéndome hijo de María, acompañado por ella y en Ars el tremendo testimonio del santo Cura de Ars.
¿Cómo influyó la dirección de un sacerdote español en el retiro en Ars?
Fue muy importante, él con su cercanía y dedicación nos ayudó a vivir muy bien los días de retiro.
¿Puede compartir alguna enseñanza específica que haya recibido durante el retiro en Ars?
Fidelidad a Jesucristo, amor a la Iglesia y comprender el ministerio sacerdotal desde el servicio, especialmente a los caídos en el camino, los pobres y sufrientes.
La importancia de la fraternidad:
¿Cómo se manifestó el tema de la fraternidad durante el viaje, especialmente en Lourdes?
Acompañándonos, compartiendo, dialogando, caminando juntos.
Observatorio Duoc UC / Anuario 2024 / página 165
Observatorio de la Educación Superior Técnico Profesional - Producción y gestión del conocimiento

¿Puede compartir alguna experiencia significativa relacionada con la fraternidad durante el retiro en Ávila?
El diálogo fraterno, la amistad sencilla, caminado juntos y compartiendo la vida.
¿De qué manera la fraternidad fortaleció su identidad sacerdotal durante el viaje?
Creo que sentir el aprecio, el afecto fraternal de los otros sacerdotes participantes fortaleció mi vida sacerdotal.
Encuentros y puesta en común:
¿Cómo influyeron los encuentros con otros sacerdotes durante el viaje en la percepción de su propia vocación?
El compartir con otros sacerdotes siempre es una muy buena oportunidad para crecer. Insisto que el diálogo y compartir la amistad, la reflexión en torno a las temáticas del retiro y las diversas peregrinaciones y visitas a lugares emblemáticos siempre ayuda.
Observatorio Duoc UC / Anuario 2024 / página 166
Observatorio de la Educación Superior Técnico Profesional - Producción y gestión del conocimiento
¿Hubo momentos de puesta en común que le hayan impactado particularmente?
En el retiro y en la peregrinación a Lourdes se dieron instancias de mucho diálogo y oración. Dos momentos muy relevantes fueron las Misas en Ars, junto a la tumba del Santo Cura y la Misa en el Santuario de Lourdes, donde los cuatro sacerdotes que viajamos vivimos una especial comunión de fe y de amistad sacerdotal y creo que nuestro sacerdocio salió muy fortalecido.
¿Cómo la experiencia de compartir vivencias fortaleció la unidad entre los sacerdotes participantes?
Se creó un muy buen ambiente. De respeto, cariño y ayuda mutua en los diversos momentos del viaje.
Aspectos espirituales:
¿Cómo integró los aspectos espirituales en ambos lugares, Lourdes y Ars, para fortalecer la identidad sacerdotal?
En la oración diaria, en el compartir fraterno, valorando el ser sacerdote desde el servicio y para el servicio. Agradeciendo la oportunidad brindada.
Reflexiones personales:
¿Cómo ha cambiado su perspectiva sobre la fraternidad y la identidad sacerdotal después de este viaje?
La fraternidad sacerdotal es siempre una preocupación en mi caso. Creo que pasar tiempo juntos ayudó mucho. No siento que haya cambiado, sino más bien la ha reforzado. Siempre he valorado la fraternidad sacerdotal y creo que debemos buscar espacios para eso. Agradezco a Duoc UC esta oportunidad y la preocupación por sus Capellanes.
¿Puede destacar algún momento de reflexión personal que haya surgido durante su estadía en Lourdes o Ars?
Fue muy significativo el retiro en Ars. Meditar en torno a la figura del Santo Cura de Ars, San Juan María Vianney, fue un regalo hermoso de la Providencia divina.
Esta columna fue publicada el 8 de enero de 2024
Equipo Editorial Observatorio
Observatorio Duoc UC / Anuario 2024 / página 167
Observatorio de la Educación Superior Técnico Profesional - Producción y gestión del conocimiento
Estrategias para mejorar la
Progresión y Titulación en la sede Plaza Norte


Dentro del Plan Estratégico 2021 – 2025, la Institución define objetivos fundamentales que guiarán nuestro camino en estos años. El primer objetivo de nuestro plan de Desarrollo se establece como “Incrementar la progresión, titulación y empleabilidad”, asegurando siempre la calidad del proceso formativo. Esto implica mejorar el porcentaje de estudiantes que están al día en su progresión curricular y reducir el tiempo para su titulación.
En la sede Plaza Norte, hemos formado una comisión multidisciplinaria de colaboradores encargados de generar estrategias y acciones que apunten a mejorar el porcentaje de estudiantes al día en su progresión curricular. El objetivo es aumentar la titulación oportuna y reducir el tiempo de titulación. Esta comisión está compuesta por Francesca Razeto (Subdirectora Académica), Alejandra Pavez (Directora de Carrera), Maria Fernanda Contreras (Jefa DARA), Fernando Celis (Coordinador General Académico), Trixy Fuentes (Jefa del Programa de Lenguaje), Jorge Biggs (Jefe del Programa de Ética y Formación Cristiana), Maria Francisca Hinojosa (Jefa del programa de Matemáticas), Carla Fuentes (Subdirectora de Asuntos Estudiantiles), Adriana Vásquez (Coordinadora UABE), Francisca Cárdenas (Encargada de Financiamiento), Camila Pozo (Ingeniera en Control de Gestión) y Wladimir Ferrada (Director de Carrera).
Esta comisión sesiona de manera semanal o quincenal, dependiendo de los hitos establecidos por la Dirección de Estudios y Progresión Académica (DEPA), abordando los casos detectados. La naturaleza multidisciplinaria de la Comisión permite contar con perspectivas de todos los actores que pueden, de una u otra manera, brindar apoyo al estudiante, incluyendo áreas académicas, financieras y socioemocionales. El estudiante siempre debe estar en el centro de nuestro quehacer, por lo que buscamos identificar sus necesidades y focalizarnos en los mecanismos de acompañamiento y progresión estudiantil para ser un aliado y guía en su proceso de aprendizaje y desarrollo. Tal como se establece en el objetivo estratégico,
Observatorio Duoc UC / Anuario 2024 / página 168
Observatorio de la Educación Superior Técnico Profesional - Producción y gestión del conocimiento
debemos ser capaces de retener al estudiante, entendiendo su historia, destacando sus atributos y proporcionándole herramientas que le permitan progresar satisfactoriamente en su proceso formativo.
Desde la Dirección de Estudios y Progresión Académica se definen iniciativas estratégicas que permiten desarrollar estrategias y acciones en nuestra Sede para lograr este objetivo. Estas son: caracterización de estudiantes y titulados; programas e iniciativas de progresión estudiantil; modelos de predicción basados en big data y data analytics; programa de apoyo financiero y beneficios estudiantiles; y programas de bienestar estudiantil. Semanalmente, la Dirección de Gobierno de Datos y Análisis Institucional pone a disposición, en un panel en Power BI, datos de los estudiantes y las distintas alertas detectadas.
En este contexto, sabemos que no todos los estudiantes se matriculan antes del inicio de clases, y ser claros en esta información es fundamental para que los estudiantes tengan claridad en las acciones que deben realizar. En la sede Plaza Norte, un 4.5% de los estudiantes matriculados lo hicieron de manera tardía, es decir, 249 de 5548. Algunas de las acciones realizadas incluyen reuniones con el Director de Carrera para proporcionar apoyos y recomendaciones para el inicio del semestre, tales como: verificar la presencia en la lista de asistencia de todos los cursos correspondientes, confirmar la visualización de los cursos en el ambiente virtual de aprendizaje (AVA) y asistir regularmente a las clases. No olvidemos que #La Asistencia Hace La Diferencia, (hashtag creado por la Comisión para motivar la asistencia a clases).
Sabemos que el porcentaje de deserción más significativo se encuentra en los estudiantes de inicio. Los modelos predictivos basados en big data nos permiten analizar, por ejemplo, los resultados de

Observatorio Duoc UC / Anuario 2024 / página 169
Observatorio de la Educación Superior Técnico Profesional - Producción y gestión del conocimiento
la examinación diagnóstica y tener un predictor de cómo podemos orientar algunas asignaturas. La matrícula de inicio en la sede Plaza Norte fue de 1.777 estudiantes. Los programas transversales de Lenguaje y Matemáticas, en sus asignaturas de Habilidades Básicas de Comunicación y Nivelación en Matemáticas, tienen 1.644 y 1.772 inscritos respectivamente. En ambas asignaturas se rinde una examinación diagnóstica, logrando una cobertura de participación del total de inscritos del 89.9% en Lenguaje y 84.31% en Matemáticas.
En el gráfi co N°1, analizamos los resultados obtenidos por los estudiantes inscritos en las asignaturas de los programas, categorizándolos en 10 intervalos según el porcentaje de logro. Intervalo 1: entre 0% y 10%, intervalo 2: entre 10% y 20%, intervalo 3: entre 20% y 30%, y así sucesivamente. Con estos resultados, trabajamos en acciones dirigidas a los estudiantes que obtuvieron un porcentaje de logro igual o menor al 50%, considerando que el aumento en el porcentaje de logro al fi nalizar el curso no es mayor al 30%, según lo declarado por los programas. Algunas de las acciones realizadas incluyen ayudantías o reforzamientos bajo la iniciativa “Juntémonos a Estudiar”, la cual busca que los estudiantes puedan reforzar lo visto en clases con el apoyo de un docente del programa. Complementamos esto con la entrega de material físico, como libros proporcionados por la institución, buscando aumentar el tiempo de estudio fuera del horario de clases y lograr que los estudiantes con menor porcentaje de logro puedan aprobar los cursos.
Por otro lado, contar con datos actualizados de nuestros estudiantes es primordial para mantener el contacto con ellos. Esto nos llevó a establecer una campaña de actualización de datos: “Más conectados, mejor comunicados”, permitiendo a todos los estudiantes de la Sede Plaza Norte informarnos de cualquier actualización en su correo electrónico, teléfono u otro dato relevante. La campaña se inició enviando correos electrónicos a los estudiantes y generando acciones en redes sociales, como Instagram. Posteriormente, se realizaron intervenciones breves en asignaturas de programas transversales mediante un código QR. Asimismo, se difundió este código QR en la feria de Asesoría Académica. Finalizamos con intervenciones en asignaturas de especialidad y en los portafolios de títulos, resaltando la importancia del contacto para la titulación. En la actualidad, muchos estudiantes no atienden llamadas telefónicas, por lo que generamos un WhatsApp de contacto, aumentando significativamente la comunicación y respuestas de los estudiantes, permitiéndonos ofrecerles programas de apoyo.
Parte fundamental de nuestro trabajo ha sido la difusión de apoyos socioemocionales y para el aprendizaje. Contamos con instancias de apoyo psicológico y psicopedagógico que han sido clave para apoyar a los estudiantes en estas áreas. Generamos campañas constantes y enviamos correos electrónicos desde las Direcciones de Carrera, Subdirección de Asuntos Estudiantiles, Coordinadores de Carrera, Jefes de programas transversales y otros estamentos institucionales, contribuyendo a que el estudiante sienta apoyo en su proceso formativo.
Es fundamental revisar cada una de las acciones, validar su impacto e ir mejorándolas y actualizándolas según sea necesario. En este trabajo colaborativo, en el que están presentes todas las áreas de apoyo al estudiante, destacamos la incorporación de un propósito institucional: “Formamos personas para una sociedad mejor”, siempre teniendo presente que el estudiante es el centro de nuestro quehacer.
Esta columna fue publicada el 22 de julio de 2024
Observatorio Duoc UC / Anuario 2024 / página 170
Observatorio de la Educación Superior Técnico Profesional - Producción y gestión del conocimiento
Ética y cultura, una
mezcla virtuosa en Duoc UC

los programas
Afirmar[1] que “La formación ética de nuestros estudiantes ha sido uno de los principales objetivos de Duoc UC a lo largo de su historia”, resulta, a estas alturas, una perogrullada. Basta revisar los principales documentos institucionales para que esta verdad salte a la vista de manera evidente. A modo de ejemplo: nuestra Misión consiste en “formar personas en el ámbito técnico profesional, con una sólida base ética inspirada en los valores cristianos…”. Asímismo, nuestra visión declara: “Ser la institución más reconocida del ámbito técnico profesional para la formación de personas, que se distinga por la pertinencia de su preparación disciplinar, humana y ética…” y así podríamos seguir sumando múltiples páginas, que dan cuenta de la centralidad de la formación integral en nuestra institución.
Sin embargo, a pesar de su centralidad (y tal vez justamente por ella) esta tarea resulta, y ha resultado, de una complejidad enorme y su implementación curricular ha requerido de múltiples formulaciones y reformulaciones, las que seguramente seguirán a lo largo de los años.
La dificultad en la implementación de cualquier programa de formación ética no es exclusiva de nuestra institución, sino que reside en la naturaleza misma de la ética. Al no ser de carácter teórico, sino más bien práctico, la formación ética desarrollada exclusivamente desde el currículo resulta sumamente difícil, pues no tiene sentido que los estudiantes memoricen conceptos o conozcan teóricamente distintas miradas filosóficas sobre el tema: alguien puede manejar teóricamente todo lo necesario para comportarse de manera correcta y a la vez ser el peor de los rufianes. El mismo Aristóteles nos advierte de esta dificultad en el libro segundo de su Ética a Nicómaco: “No nos consagramos a estas indagaciones para saber que es la virtud, sino para aprender a hacernos virtuosos y buenos; porque de otra manera este estudio sería completamente inútil”.
[1] El autor hoy se desempeña en el mismo cargo en la sede Alameda de Duoc UC.
Observatorio Duoc UC / Anuario 2024 / página 171
Observatorio de la Educación Superior Técnico Profesional - Producción y gestión del conocimiento
Estamos pues, frente a una encrucijada: ¿cómo formar a nuestros alumnos en una disciplina práctica desde un currículo teórico? Esta dificultad, es franqueada en otras disciplinas con laboratorios, talleres, centros de simulación, entre otros; sin embargo, en el caso de la ética, la imposibilidad de practicar el discernimiento moral en contextos reales ha llevado a la Dirección de Ética a la implementación de nuevas maletas didácticas incorporando la metodología de casos, donde, junto al método socrático y la metodología inductiva, han aportado al desarrollo de la imaginación moral con muy buenos resultados.
Sin embargo, existen también otras formas de aportar formación ética a nuestros estudiantes, que se dan fuera del contexto curricular, o “extracurriculares” y que, a pesar de ser menos exploradas, aportan enormemente al cumplimiento de dichos objetivos.
En este sentido, es que los programas de Ética, Formación Cristiana y Cultura en conjunto con otros estamentos de nuestra sede San Carlos, hemos empezado un camino que integra la formación valórica con actividades culturales, aprovechando el sello artístico propio de varias de nuestras carreras. En esa unión de ética y arte, hemos encontrado una gran oportunidad para ampliar la formación valórica, ya que, a nuestro juicio, estas instancias juegan un papel fundamental en el desarrollo integral de los estudiantes, proporcionándoles un espacio para fomentar su sensibilidad, conocerse a sí mismos, explorar y expresar sus emociones, entre otras.
El arte y la cultura, en sus diversas formas, sirve como medio para expresar valores, dilemas morales y visiones del mundo. Brindan la oportunidad de explorar y comunicar sus propias convicciones a través de la apreciación y la creación artística. Esta reflexión contribuye a un mayor autoconocimiento, un componente esencial en el desarrollo de un carácter virtuoso. El mismo Aristóteles nos indica, a lo largo de su obra, la

Observatorio Duoc UC / Anuario 2024 / página 172
Observatorio de la Educación Superior Técnico Profesional - Producción y gestión del conocimiento

intrínseca identificación entre bien, belleza y verdad. Las buenas acciones son siempre bellas y viceversa, por tanto, la identificación entre ambas debería ser un supuesto en la formación ética de nuestros jóvenes. Entendiendo la profunda relación entre el arte y la ética, es que fuimos generando una interesante parrilla de actividades culturales durante el año 2023, entre las que queremos destacar dos actividades en particular: La primera fue un Concierto – Conversatorio sobre Música Sacra. Actividad en el marco de la Semana de la Fe y la Cultura, que fue organizada en conjunto con las carreras de la Escuela de Sonido y la Subdirección de Extensión de nuestra Sede. Permitió que nuestros estudiantes pudieran disfrutar de un concierto de cámara,

Observatorio Duoc UC / Anuario 2024 / página 173
Observatorio de la Educación Superior Técnico Profesional - Producción y gestión del conocimiento
con piezas de Bach, Vivaldi, Händel y Mozart, a cargo del prestigioso conjunto de cuerdas “Cuarteto Austral” integrado por Javaxa Flores, Jessica Carrasco, Isabel Flores y Valentina del Canto. Además, en un segundo momento tuvieron un espacio para aproximarse teóricamente a la música sacra, a través de un conversatorio con el destacado músico, productor musical y docente Cuti Aste, la historiadora y docente María de los Ángeles Viveros, junto a las integrantes del Cuarteto Austral.

La segunda actividad destacada fue la 1° Muestra de Artesanía, inserta en el marco de la semana del Programa de Cultura, y organizada en conjunto con las carreras de Diseño y el Programa de Artesanías del Instituto de Desarrollo Agropecuario (INDAP). Esta actividad contó con la participación de 10 artesanos provenientes de distintas regiones de nuestro país, por nuestra identidad. Junto con la muestra se realizaron dos talleres: “Tiento de Chivo como Materialidad” a cargo Kevin Soto, Talabartero de Curacaví ganador del Sello de Excelencia a la Artesanía 2023. Y el taller “Introducción a la Pilwa Lafquenche” a cargo de la artesana Juana Paillafil Llaima, Cestera del Lago Budi.
Estas actividades culturales extracurriculares, son vehículos educativos que trascienden a la mera apreciación artística y potencian de forma significativa el desarrollo ético de los estudiantes, ya que no solo los enriquecen intelectualmente y aportan en su bagaje cultural, sino que también operan como experiencias formativas que cultivan virtudes, fomentan la empatía, desarrollan la sabiduría práctica y contribuyen al bien común. Estas actividades extracurriculares no solo enriquecen la vida cultural de la Sede, sino que ofrecen también un terreno fértil para el desarrollo ético de los estudiantes, guiándolos hacia el desarrollo de la excelencia moral y contribuyendo a su propia plenitud.
Esta columna fue publicada el 6 de mayo de 2024.
Observatorio Duoc UC / Anuario 2024 / página 174
Observatorio de la Educación Superior Técnico Profesional - Producción y gestión del conocimiento
La inteligencia espiritual en el ámbito
de la formación de personas. Reflexiones sobre nuestra identidad católica y nuestro propósito institucional

Objetivo: Generar una instancia de reflexión, para colaboradores, administrativos y docentes, a fin de profundizar en la identidad católica de nuestra misión formadora de personas para una sociedad mejor.
Introducción
Hay algo grande en lo humano y también hay algo grande y pequeño en todo lo humano. Crecer toma tiempo. Y hay tiempo para todo, como reza el sabio Cohelet (Esclesiastés 3, en la Biblia). Si, hay tiempo para trabajar y tiempo para descansar, también hay tiempo para cansarse. ¿Quién no se ha cansado?
Como dicen algunos autores, vivimos en la sociedad del cansancio. Unos se detienen en el fenómeno del cansancio y otros en sus consecuencias. Algunos hablan de la posibilidad de quemarse y de perder el sentido. Pero el cansancio no lo es todo. A veces, cuando el panorama es más oscuro, una lucecita diminuta o una perspectiva diferente nos muestra una belleza escondida y diferente.
En el presente trabajo, me dispongo a adentrarme en la fascinante tarea de compartir con los miembros de nuestra institución, algunas ideas que he podido descubrir de la lectura de nuestra realidad y del desafío de educar personas para una sociedad mejor, según reza nuestro propósito institucional. Y que, con tanto orgullo, nos define como instituto de formación técnico profesional Duoc UC, que además tiene una identidad y misión católica.
En cuatro breves apartados, intento aproximarme a los desafíos que nos supone: 1) concebir bien nuestra identidad católica; 2) entender el contexto cultural en el cual nos desarrollamos y que denominamos: “de
Observatorio Duoc UC / Anuario 2024 / página 175
Observatorio de la Educación Superior Técnico Profesional - Producción y gestión del conocimiento
cansancio y desierto espiritual”; 3) valorar la importancia de la inteligencia espiritual en la formación de personas; y 4) optar por “la vía pulchris”, de la belleza, a pesar de lo desfavorable, feo y cansador que nos pueda parecer nuestro presente.
Al lector le ofrezco solo un barniz conceptual sistemático, como un “desde dónde entender lo que somos y hacemos” y un “hacia dónde podemos dirigirnos”, en pos de ser un aporte para las personas que formamos y en pos de revitalizar el propósito de cada uno de los que formamos parte de Duoc UC.
El compromiso y el aporte de todos engrandece lo que somos y lo que hacemos. San José, nos encamine hacia la belleza del trabajo bien hecho y la renovación de nuestro firme propósito.
1. “Formar personas para una sociedad mejor”. La identidad de la universidad católica
La naturaleza de las universidades católicas aparece descrita en algunos documentos conocidos.
La exhortación apostólica de Juan Pablo II “Ex Corde Ecclesiae” (1990)[1], se ha difundido convenientemente en nuestra institución y ha servido para orientar el ser y obrar de Duoc UC, ya que señala lo que la Iglesia entiende por Universidad o Instituto católico. Contamos con una definición “a modo de declaración de conceptos” que se ve reflejado en una VISIÓN y MISIÓN, que nos permite reconocer nuestra naturaleza, organización y funciones de cada miembro. Así, pues, en Duoc UC, nadie puede dudar que somos una institución de Iglesia y católica. También existe, por ejemplo, la constitución apostólica del Papa Francisco “Veritatis Gaudium” (2017)[2], sobre las universidades y facultades eclesiásticas, que no nos involucran directamente, pero nos sirve para soslayar la misión y el compromiso de las instituciones católicas sobre la búsqueda de la verdad y el servicio que se le presta a la humanidad por medio de la educación.
Es interesante, además, considerar la Instrucción de la Congregación para la Educación católica “La identidad de la escuela católica para una cultura del diálogo” (2022)[3], por medio de la cual, se indican algunas referencias importantes, hacia una mejor definición de lo que se entiende “por católico” (números 67-72), algunas alusiones a temas o ámbitos sensibles (números 79-83) y orientaciones para entender la misión de la institución católica en nuestra cultura actual (números 84-93).
Cuando volvemos nuestra mirada a la historia, podemos considerar el tremendo bien que ha hecho la universidad católica a nuestra sociedad a lo largo de los siglos, el legado cultural y social (que viene añadido a la búsqueda de la verdad en la libertad), no podemos sino pensar en la misión y tarea permanente que tenemos; en la responsabilidad que tenemos para con Dios y el rol que tenemos para con las personas y la sociedad del Chile de hoy.
[1] Papa Juan Pablo II, “Ex Corde Ecclesiae” (1990). https://www.vatican.va/content/john-paul-ii/es/apost_constitutions/documents/hf_jp-ii_apc_15081990_ex-corde-ecclesiae.html
[2] Papa Francisco, “Veritatis Gaudium” (2017). https://www.vatican.va/content/francesco/es/apost_constitutions/ documents/papa-francesco_costituzione-ap_20171208_veritatis-gaudium.html
[3] Congregación para la Educación Católica, Instrucción “La identidad de la escuela católica para una cultura del diálogo” (2022). https://www.vatican.va/roman_curia/congregations/ccatheduc/documents/rc_con_ccatheduc_doc_20220125_istruzione-identita-scuola-cattolica_sp.html
Observatorio Duoc UC / Anuario 2024 / página 176
Observatorio de la Educación Superior Técnico Profesional - Producción y gestión del conocimiento
a. Desde el concepto “católico” tomamos en serio la totalidad de nuestros miembros
El Catecismo de la Iglesia Católica (del año 1992)[4]. Dice que la palabra “católica” significa “universal” en el sentido de “según la totalidad” o “según la integridad”. Así, pues, la Iglesia es católica en un doble sentido: en cuanto a que Cristo está presente en toda la Iglesia y en cuanto que ha sido enviada a la totalidad del género humano. (números 830 – 831). Encontramos acá una cuestión que necesariamente tenemos que considerar a la hora de pretender entender y realizar nuestro trabajo, pues como nos lo señalan los documentos del Dicasterio para la Cultura y la Educación, la universidad católica desarrolla su ser entre sus miembros, todos distintos y variados. No todos tienen la misma adherencia a la fe. Ni es esta cualidad una condición sine qua non para ser parte de Duoc UC. Sin embargo, por la naturaleza misma de la universidad católica, a todos se nos pide orientarnos hacia la verdad, por ejemplo. Por ahí vamos redescubriendo la auténtica “Sapientia Christiana”[5].
En este aspecto, revisando la Constitución dogmática sobre la Iglesia “Lumen Gentium” (1964)[6], me es especialmente iluminador contemplar los números 14-16, donde se manifiestan los distintos grados de participación en la comunión con el Señor y con la Iglesia, pasando desde los fieles cristianos católicos (bautizados), a los bautizados en otra denominación cristiana, a los judíos, a los creyentes en Dios, hasta llegar a los que no creen pero que obran con buen corazón.
Esta consideración nos permite mirar con realismo y entusiasmo la totalidad de los miembros de nuestra institución, nos aligera el camino para colaborar con aquella intuición de nuestros fundadores (que, sin duda, obraron movidos por el Espíritu) y nos permite poder establecer diferentes estrategias para llegar a distintos grupos humanos (creyentes y no creyentes) sin renunciar a nuestra misión y labor más profunda.
b. El corazón de la misión: La dignidad humana
El número 7, de “Ex Corde Ecclesiae”, es tan claro que explicarlo sería redundar:
“En el mundo de hoy, caracterizado por unos progresos tan rápidos en la ciencia y en la tecnología, las tareas de la Universidad Católica asumen una importancia y una urgencia cada vez mayores. De hecho, los descubrimientos científicos y tecnológicos, si por una parte conllevan un enorme crecimiento económico e industrial, por otra imponen ineludiblemente la necesaria correspondiente búsqueda del significado, con el fin de garantizar que los nuevos descubrimientos sean usados para el auténtico bien de cada persona y del conjunto de la sociedad humana. Si es responsabilidad de toda Universidad buscar este significado, la
[4] “Catecismo de la Iglesia Católica” (1992). Ver apartado sobre la catolicidad de la Iglesia https://www.vatican.va/ archive/catechism_sp/p123a9p3_sp.html#III%20La%20Iglesia%20es%20cat%C3%B3lica
[5] Papa Juan Pablo II, “Sapientia Christina” (1979). Constitución apostólica sobre las universidades y facultades eclesiásticas. https://www.vatican.va/content/john-paul-ii/es/apost_constitutions/documents/hf_jp-ii_ apc_15041979_sapientia-christiana.html
[6] Concilio Vaticano II, Constitución apostólica sobre la Iglesia “Lumen gentium” (1964). https://www.vatican.va/ archive/hist_councils/ii_vatican_council/documents/vat-ii_const_19641121_lumen-gentium_sp.html
Observatorio Duoc UC / Anuario 2024 / página 177
Observatorio de la Educación Superior Técnico Profesional - Producción y gestión del conocimiento
Universidad Católica está llamada de modo especial a responder a esta exigencia; su inspiración cristiana le permite incluir en su búsqueda, la dimensión moral, espiritual y religiosa, y valorar las conquistas de la ciencia y de la tecnología en la perspectiva total de la persona humana.
En este contexto, las Universidades Católicas están llamadas a una continua renovación, tanto por el hecho de ser universidad, como por el hecho de ser católica. En efecto, «está en juego el significado de la investigación científica y de la tecnología, de la convivencia social, de la cultura, pero, más profundamente todavía, está en juego el significado mismo del hombre». Tal renovación exige la clara conciencia de que, por su carácter católico, la Universidad goza de una mayor capacidad para la búsqueda desinteresada de la verdad; búsqueda, pues, que no está subordinada ni condicionada por intereses particulares de ningún género”.
Que impresionante e innovador es poder descubrir y promocionar que el permanente desafío que ha asumido la educación católica ha sido siempre el cuidado y el desarrollo de la persona humana, su dignidad y el formar personas para el diálogo y una sociedad mejor. Innovador y valiente, sería reconocer y explicitar una opción por este valor de manera transversal en nuestra institución. Cosa que ya hacemos en la Misión, Visión y valores institucionales, pero parece que aún podemos hacer algo más, parece que los signos de los tiempos nos llaman a algo más. A todos.
2. Formar personas en una época de cansancio y desierto espiritual
Nuestra noble misión, pide que nuestra humanidad esté atenta a los contextos que vivimos. En este apartado, considero ciertos aspectos de la sociedad que algunos llaman: “la sociedad del cansancio”. a. “La sociedad del cansancio”
La “sociedad del cansancio” es un concepto desarrollado por el filósofo surcoreano Byung-Chul Han. En su libro “La sociedad del cansancio” (2010), el autor describe cómo la sociedad contemporánea ha evolucionado desde un modelo disciplinario, caracterizado por la obediencia a normas externas, hacia un modelo de autoexplotación, donde la presión por el rendimiento y la productividad proviene de uno mismo.
Entre los aspectos relevantes del libro, encontramos:
1. Autoexplotación: Las personas se convierten en explotadores de sí mismas, impulsadas por la necesidad de mejorar continuamente y ser más productivas, lo que lleva a un agotamiento constante.
2. Agotamiento y Fatiga: La constante autoexigencia y la sobrecarga de tareas provocan un estado generalizado de agotamiento y fatiga mental y física.
3. Positividad Tóxica: La sociedad del cansancio está marcada por una presión constante por mantener una actitud positiva y ser eficiente, lo que puede llevar a la negación de emociones negativas y al burnout.
4. Crisis de Identidad: La identidad de las personas se construye en gran medida en torno a su desempeño y logros, lo que puede causar una crisis de identidad cuando no se cumplen las expectativas autoimpuestas.
Observatorio Duoc UC / Anuario 2024 / página 178
Observatorio de la Educación Superior Técnico Profesional - Producción y gestión del conocimiento
5. Desaparición de Límites: Las fronteras entre el trabajo y la vida personal se desdibujan, haciendo que las personas estén siempre “conectadas” y disponibles, contribuyendo al agotamiento.
6. Problemas de Salud Mental: La presión constante y la autoexigencia pueden llevar a problemas de salud mental como la depresión, la ansiedad y el síndrome de burnout.
En síntesis, la “sociedad del cansancio” describe una era en la que la autoexigencia y la búsqueda incesante de rendimiento llevan a un estado de agotamiento generalizado, afectando tanto la salud mental como física de las personas.
b. La necesidad de recuperar el sentido, el equilibrio y la vida interior. Abandonando la vida hiperactiva
La formación espiritual cobra una relevancia especial en la llamada “sociedad del cansancio“, un concepto popularizado por el filósofo surcoreano Byung-Chul Han. En esta sociedad, caracterizada por una sobrecarga de estímulos, la presión por la productividad y el rendimiento constante, las personas a menudo experimentan agotamiento físico y mental.
La formación espiritual ofrece una vía para encontrar equilibrio y sentido en medio del ajetreo diario. Aquí algunos puntos clave sobre su importancia:
1. Reducción del Estrés: Las prácticas espirituales, como la meditación, la oración o el yoga, ayudan a calmar la mente y reducir los niveles de estrés. Esto es crucial en una sociedad donde el cansancio y la ansiedad son comunes.
2. Propósito y Significado: La espiritualidad puede proporcionar un sentido de propósito y significado más profundo, algo que muchas veces se pierde en la rutina diaria y la búsqueda constante de éxito material.
3. Conexión Personal y Comunitaria: La formación espiritual fomenta la conexión con uno mismo y con los demás, creando un sentido de comunidad y pertenencia que puede contrarrestar el aislamiento y la soledad.
4. Resiliencia Emocional: Las personas con una formación espiritual sólida suelen tener una mayor capacidad para enfrentar desafíos y adversidades, desarrollando una resiliencia emocional que les permite recuperarse más fácilmente del cansancio y el agotamiento.
5. Equilibrio y Armonía: La espiritualidad promueve un estilo de vida más equilibrado, enfocándose no solo en el trabajo y la productividad, sino también en el bienestar personal y la armonía con el entorno.
Así, pues, en una sociedad marcada por el cansancio y la fatiga, la formación espiritual se convierte en un recurso valioso para recuperar la calma, encontrar un propósito más allá del éxito material y fortalecer la resiliencia emocional y la conexión humana.
c. “El cansancio de los buenos”. El desaliento profesional o burnout
El cansancio es una realidad humana que nos afecta a todos. Pero no todos llevamos de la misma manera esta condición. A veces, el cansancio trasciende el punto de vista físico, llegando a manifestarse en la mente y en el espíritu.
Observatorio Duoc UC / Anuario 2024 / página 179
Observatorio de la Educación Superior Técnico Profesional - Producción y gestión del conocimiento
Según el psiquiatra Roberto Almada, en su libro “El cansancio de los buenos” (2012); el “burnout” estado de fatiga o frustración que se produce por la dedicación a una causa, forma de vida o de relación que no produce el fruto esperado. Este estado se manifiesta en una triada: Cansancio emocional, despersonalización y baja realización personal. Como discípulo del neurólogo y psiquiatra austriaco, Viktor Flankl (1905-1997), considera la logoterapia como una alternativa al desgaste profesional. Pues, las personas con un sentido son más capaces de perseverar en la vida y en situaciones complejas.
Es interesante destacar, cómo estos autores no niegan la posibilidad de experimentar el cansancio; muy por el contrario, lo afirman como una posibilidad humana. Sin embargo, establecen en la misma humanidad, y en el reconocimiento de nuestra propia verdad, las condiciones donde germina el descanso y el bienestar, en la medida en que somos honestos con nosotros mismos y nos ocupamos en los propósitos que dan sentido a nuestra existencia.
3. Formar personas con inteligencia espiritual
Uno de los elementos que diversos autores han reconocido de nuestra sociedad actual, es el olvido y la ignorancia de la dimensión metafísica o espiritual de realidad. A continuación, quisiera desarrollar, brevemente, dos aspectos sobre la necesidad de considerar la espiritualidad en el proceso del desarrollo integral de la persona, sin renunciar a la posibilidad de buscar, conocer y realizar al máximo el gigantesco potencial humano (físico y espiritual), evitando el reduccionismo únicamente materialista, que hoy por hoy prevalece en muchos ambientes.
a. Las inteligencias múltiples de Howard Gardner (1943-)
De la obra del psicólogo e investigador estadounidense, Howard Gardner, denominado “Las inteligencias múltiples” (1983), donde señala que no existe una inteligencia única en el ser humano, sino una diversidad de inteligencias que marcan las potencialidades y acentos significativos de cada individuo, trazados por las fortalezas y debilidades en toda una serie de escenarios de expansión de la inteligencia.
La inteligencia no es una cantidad que se pueda medir con un número como lo es el coeficiente intelectual (CI), sino la capacidad de ordenar los pensamientos y coordinarlos con las acciones. La inteligencia no es una sola, sino que existen tipos distintos. Su sistema para implementar las inteligencias múltiples está dedicado a estimular las potencialidades en los niños en un clima activo y afectivo como lo exige el siglo XXI.
La teoría de Gardner básica puede resumirse en las siguientes palabras: cada persona tiene ocho inteligencias, habilidades cognoscitivas. Estas inteligencias trabajan juntas, aunque como entidades semiautónomas. Cada persona desarrolla unas más que otras. Diferentes culturas y segmentos de la sociedad ponen diferentes énfasis en ellas.
* Inteligencia lingüística. En los niños y niñas se aprecia en su facilidad para escribir, leer, contar cuentos o hacer crucigramas.
Observatorio Duoc UC / Anuario 2024 / página 180
Observatorio de la Educación Superior Técnico Profesional - Producción y gestión del conocimiento
* Inteligencia lógico-matemática. Se aprecia en los menores por su interés en patrones de medida, categorías y relaciones. Facilidad para la resolución de problemas aritméticos, juegos de estrategia y experimentos.
* Inteligencia visual y espacial. Los niños y niñas piensan en imágenes y dibujos. Tienen facilidad para resolver rompecabezas, dedican el tiempo libre a dibujar, prefieren juegos constructivos, etc.
* Inteligencia musical. Los menores se manifiestan frecuentemente con canciones y sonidos. Identifican con facilidad los sonidos.
* Inteligencia corporal kinestésica. Facilidad para procesar el conocimiento a través de las sensaciones corporales. Los menores tienen una marcada capacidad para realizar actividades que requieren fuerza, rapidez, flexibilidad, coordinación óculo-manual y equilibrio.
* Inteligencia naturalista. Los niños y niñas piensan instintivamente. Tienden a dejarse llevar, observan el entorno, idean con material de la natura, etc.
* Inteligencia interpersonal (inteligencia social). Se comunican bien y son líderes en sus grupos. Entienden bien los sentimientos de los demás y proyectan con facilidad las relaciones interpersonales.
* Inteligencia intrapersonal. Relacionada con la capacidad de un sujeto de conocerse a sí mismo: sus reacciones, emociones y vida interior.
b. La inteligencia espiritual de Francesc Torralba (1967-)
Según el autor, filósofo y teólogo español, recientemente galardonado con el premio Ratzinger de filosofía 2023, algo parecido al premio nobel en la categoría mundial, en su libro “La inteligencia espiritual. Vivimos en un desierto espiritual” (2010):
La inteligencia espiritual es propia y característica de la condición humana y, además, posee un carácter universal. Todo ser humano, más allá de sus características externas e internas, posee este tipo de inteligencia a pesar de que pueda hallarse en grados muy distintos de desarrollo.
Lo propio de la dimensión espiritual es la salida de sí, la penetración en la estructura de las cosas. Es lo que le permite el fluir, que la persona se desprenda de sí misma y se abandone. La vida espiritual no es cerrazón, es apertura.
Una persona espiritualmente sensible no se contenta con el conocimiento superficial de las cosas, del mundo, de lo que le rodea; no le basta con una visión panorámica; pretende ir a fondo y en este caminar descubre una serie de elementos y propiedades, de niveles de la realidad que a simple vista le habían pasado desapercibidos. La vida espiritual es profundidad, movimiento hacia lo desconocido, interés por lo que está oculto, por lo que es invisible a los ojos.
La inteligencia espiritual impulsa a plantearnos interrogantes existenciales y a vivir experiencias que trascienden los limites habituales de los sentidos, que conectan con el fondo último de la realidad y nos acercan al descubrimiento del verdadero potencial de cada uno.
Observatorio Duoc UC / Anuario 2024 / página 181
Observatorio de la Educación Superior Técnico Profesional - Producción y gestión del conocimiento
La vida espiritual es el producto de la inteligencia espiritual. Lo espiritual es una emergencia humana, el aspecto más noble que hay en él, su función más elevada, le convierte en un ser distinto del bruto (Definición de Pico Della Mirándola). Así, la vida espiritual está en potencia en el ser humano, requiere de condiciones, contextos y de una educación para que se articule creativamente, para que alcance su máxima expresión. En nuestras sociedades se requiere el cultivo de tal dimensión, pues están dominadas por la velocidad, el funcionalismo y el economicismo. El materialismo teórico y práctico es el más grande obstáculo para reconocer la riqueza de la espiritualidad, pues reduce al ser humano a puro cuerpo.
¿Puede haber una espiritualidad laica? Indudablemente que sí. Pues se trata de una cuestión antropológica, y por ende pre-religiosa. La religión llena de contenidos y respuestas de sentido, las preguntas y el misterio.
¿Da lo mismo en qué creer? Indudablemente que no. La inteligencia espiritual se articula con los otros tipos de inteligencia, y por supuesto que la capacidad de religación pide un sustrato eminentemente racional.
Los poderes de la inteligencia espiritual:
* Búsqueda de sentido
* Preguntar último
* La capacidad de distanciamiento
* La autotrascendencia
* El asombro
* El autoconocimiento
* La facultad de valorar
* El gozo estético
* El sentido del misterio
* La búsqueda de la sabiduría
* El sentido de pertenencia al todo
* La superación de la dualidad
* El poder de lo simbólico
* La llamada interior
* La elaboración de ideales de vida
* La capacidad de religación
* La ironía y el humor
Observatorio Duoc UC / Anuario 2024 / página 182
Observatorio de la Educación Superior Técnico Profesional - Producción y gestión del conocimiento
El cultivo de la inteligencia espiritual:
* La práctica asidua de la soledad
* El gusto por el silencio
* La contemplación
* El ejercicio de filosofar
* Lo espiritual del arte
* El diálogo socrático
* El ejercicio físico
* El dulce no hacer nada
* La experiencia de la fragilidad
* El deleite musical
* La práctica de la meditación
* El ejercicio de la solidaridad
Los beneficios de la inteligencia espiritual:
* La riqueza interior: la creatividad
* Profundidad en la mirada
* Consciencia crítica y autocrítica
* La calidad de las relaciones
* La autodeterminación
* El sentido de los límites
* El conocimiento de las posibilidades
* Transparencia y receptividad
* Equilibrio interior
* La vida como proyecto
* Capacidad de sacrificio
* Vivencia plena del ahora
Observatorio Duoc UC / Anuario 2024 / página 183
Observatorio de la Educación Superior Técnico Profesional - Producción y gestión del conocimiento
La atrofia de la inteligencia espiritual:
* El sectarismo
* El fanatismo
* El gregarismo
* La banalidad
* El consumismo
* El vacío existencial
* El aburrimiento
* El auto engaño
* El gusto por lo vulgar
* La intolerancia
* El narcisismo
* La parálisis vital
La inteligencia espiritual, lejos de ser una capacidad que aísle al ser humano de su contexto natural y social, es un poder que, utilizado correctamente, consigue su efecto contrario: le hace más receptivo, más sensible, más plenamente integrado condigo mismo y con su entorno.
La educación integral exige la atención personalizada, libre del puro materialismo.
Dice Viktor Flankl: la educación debería impulsar en los jóvenes un proceso de descubrimiento del sentido. La educación no puede dar el sentido, hay que descubrirlo.
4. “Via pulchri”
Educar es algo grande, porque obliga a reconocerse pequeños e ignorantes, necesitados y vulnerables, cansados y quemados, inclusive. Así pues, en lo humano hay algo pequeño y también hay algo grande. Porque hay tiempo para aprender y también hay tiempo para aprender a enseñar.
Mi propuesta, tiene que ver con proponer a los integrantes de nuestra institución (no solo a los alumnos y alumnas) una vía diferente a la que por desgracia nos hemos ido acostumbrando. Se trata de lo que los clásicos podrían denominar: la via pulchri (del latín pulchrum, belleza). Pues en un contexto estéticamente feo, de cara a los diagnósticos y a lo que podemos ver en muchos aspectos de nuestra vida; a través de una mirada distinta, por la vía del trascendental filosófico de la belleza, podríamos acercarnos a lo que es auténticamente verdadero y bueno. Qué hermoso es bajar de la nube, dejar los conceptos abstractos de la academia para otro momento y hacer el ejercicio de mirar más allá, aun cuando esto pase por ocuparnos en el más acá. ¿Nos hemos fijado en lo bello que son nuestros ambientes en Duoc UC? ¿Nos hemos dado cuenta lo agradecidos que son nuestros estudiantes por estar en un lugar bonito, donde el verde es signo de la vida que no encuentran en otros lados?
Observatorio Duoc UC / Anuario 2024 / página 184
Observatorio de la Educación Superior Técnico Profesional - Producción y gestión del conocimiento
Ya lo decía Fiodor Dostoievski: “sólo la belleza salvará al mundo”, reflejando esa profunda convicción, de creer que este mundo estéticamente feo puede llegar a conocer la otra realidad que no vemos fácilmente, que nos trasciende y que habita en todas aquellas buenas obras que llenan de sentido el corazón y tocan el alma. Cuestión que el lector puede vislumbrar en el escritor ruso, fervientemente creyente en Cristo.
Esta propuesta se trata de una cuestión contracultural. ¿Y qué más contracultural que el mensaje de Jesús y la evangelización en una sociedad desencantada y agobiada? Y esto no es algo nuevo; sí, pero no; ya que, hasta ahora, y es cosa de mirar la historia; de diferentes maneras el Evangelio se nos ha presentado como una propuesta que llena de sentido y es capaz de transformar el corazón y el mundo.
Nos viene bien recordar las palabras del Papa Francisco: “La alegría del evangelio llena el corazón y la vida entera de los que se encuentran con Jesús. Quienes se dejan salvar por él son los liberados del pecado, de la tristeza del vacío interior, del aislamiento. Con Jesucristo siempre nace y renace la alegría” (Evangelii Gaudium, 2013).
Es en este aspecto donde la universidad católica, y en particular nuestro Duoc UC (Departamento universitario obrero campesino), está llamado a ser un renovado aporte a la sociedad, tal como en sus inicios fue la alternativa a una educación para todos. Podamos hoy, como una institución consolidada y exitosa, entregar a nuestra sociedad el modelo de una educación que responda a lo que la iglesia les pide a las universidades católicas en este tiempo.
¿Y dónde está la belleza? ¿Qué puede despertar el asombro en una sociedad cansada y enceguecida? Quizá nos haga bien darle espacio a la espiritualidad, al silencio y a la contemplación.
Esta columna fue publicada el 11 de noviembre de 2024
Observatorio Duoc UC / Anuario 2024 / página 185
Observatorio de la Educación Superior Técnico Profesional - Producción y gestión del conocimiento
Pasantías Docentes: un desafío
de humildad, motivación y profesionalismo

En nuestro constante camino para desarrollarnos personal y profesionalmente, como escuela de Turismo y Hotelería asumimos la importante misión de realizar junto a un equipo de docentes, una pasantía docente en una importante cadena hotelera mundial denominada Marriott international, específicamente en la marca Hotelera W una de las 27 marcas que tiene esta cadena hotelera, focalizada en un segmento de lujo. Esta empresa turística fue seleccionada para el piloto por su importante apoyo a la empleabilidad de nuestros titulados, por sus estándares de calidad y su proyección internacional, así como el creciente interés de nuestros estudiantes y titulados en emplearse en esta cadena, entre otras cosas por su clima laboral y desarrollo profesional.
Las docentes seleccionadas tampoco fueron elegidas al azar, fueron invitadas a esta experiencia por su destacada trayectoria docente, dos de ellas categorizadas y dos de ellas docentes asistentes, con indicadores de desempeño esperado y sobresaliente.
Previo a la ejecución fue necesario cumplir con aspectos administrativos tales como firma de convenio con la empresa turística, declaración jurada de candidatas asumiendo la voluntariedad, carta de pasantía con seguros y remuneración (a cargo de Duoc UC), informe de evaluación al final de la pasantía, evaluación del centro de práctica, Plan de Mejora y matriz de riesgo.
Este piloto que se desarrolló durante enero del 2022, con una duración de 3 semanas, tenía como objetivo general conectar al docente con la empresa hotelera y la comunidad mejorando sus competencias disciplinares. Sin embargo, fueron muchos otros objetivos logrados tales como un aprendizaje activo y vinculante de los docentes al poder interactuar con el medio de forma permanente llevando a la práctica a las empresas turísticas, mejorar la calidad docente transfiriendo al aula la experiencia desarrollada y vivida renovando su conocimiento práctico en un proceso continuo, fortalecer la vinculación con la empresa turística aplicando
Observatorio Duoc UC / Anuario 2024 / página 186
Observatorio de la Educación Superior Técnico Profesional - Producción y gestión del conocimiento
conocimientos variados en búsqueda de soluciones integrales y desde la visión docente un cambio de roles entre titulados que se encontraban trabajando en el hotel y que en algunas experiencias fueron sus jefes(as).
El proceso de pasantías contemplaba rotar semanalmente (jornada completa diaria) entre las distintas áreas hoteleras, estas son: Housekeeping, Alimentos y bebidas (AA&BB), Reuniones y Convenciones y Recepción; es decir, aquellas áreas claves de desarrollo profesional y empleabilidad de nuestros alumnos y alumnas de Turismo y hotelería y Administración hotelera, considerando una inducción previa que contemplaba reconocer la cultura W con todas sus particularidades. La rotación entre las distintas áreas era muy importante de ejecutar dado la experiencia que podían aportar nuestras docentes y la vivencia real permitía actualizar sus competencias para cada una de las asignaturas del currículo vigente.

Desde el punto de vista hotelero los beneficios se vieron plasmados en un plan de mejora realizado por nuestras docentes al final de su pasantía, quiénes mediante su experiencia, conocimiento y desarrollo lograron entregar el concepto de hospitalidad que traspasan a los alumnos y alumnas. Del mismo modo, en el aula, la experiencia desarrollada permitió tomar como ejemplo el hotel con todos sus procesos de sustentabilidad, tecnología de vanguardia y la cultura de trabajo inserta, vivenciada por ellas. Este aspecto sin duda es un beneficio para la empresa turística, dado que permite “formar “con un modelo conocido y actúa como semillero para la industria.
Otro aspecto importante de win-win se traduce en la experiencia que aporta Duoc UC con sus modelos y formación que permite traspasar y vincular a la industria con la cultura institucional.
El Hotel evaluó a nuestras docentes desde el punto de vista de su rendimiento, calidez y espíritu de servicio en forma destacada. Nuestras docentes también realizaron un proceso de evaluación respecto al conocimiento y cruce de competencias internas, logradas en cada una de las asignaturas que desarrollan y entregaron un informe de sugerencias para el desarrollo de pasantías posteriores.
Observatorio Duoc UC / Anuario 2024 / página 187
Observatorio de la Educación Superior Técnico Profesional - Producción y gestión del conocimiento
En voz de nuestras docentes los beneficios recibidos se resumen en:
Validación de sus conocimientos en el trabajo diario en un hotel; el orgullo de encontrar a titulados trabajando en el hotel logrando pertinencia de su carrera en la industria; poder actualizar mediante vivencias reales los distintos perfiles y nacionalidades; renovar conocimientos y aprender nuevas prácticas para la mejora en las asignaturas dictadas; recibir e intercambiar ideas entre los equipos; confirmar la pasión por nuestra industria en una instancia distinta a nuestro día a día donde la ansiedad y ganas de aportar con profesionales del área, una experiencia muy importante más allá de nuestros currículums, dado que nos valida frente a los estudiantes y pares donde se transmitirá que estamos latentes y compartimos mismas instancias en el mercado.
Compartimos también algunas sugerencias de esta experiencia: Realizar una inducción previa, que puede ejecutarse mediante el uso de la tecnología (Realidad Virtual) tal como el proyecto Hotel Virtual que en esta etapa ya se encuentra vinculada con la industria hotelera, adaptando el prototipo y personalizándolo a los hoteles en convenio. Este proyecto permite un proceso de inducción relevante que está disponible para todos nuestros estudiantes, previo a su práctica en hotelería de manera de familiarizarse con los tipos de habitaciones y protocolos de limpieza funciones del área de Housekeeping. Como Escuela seguiremos desarrollando la realidad virtual y ampliándola a otras áreas de competencias disciplinares ad hoc a nuestros estudiantes como recreaciones virtuales y juegos de áreas naturales, empresas turísticas, operadores y, por supuesto, incorporando otras áreas hoteleras a este aprendizaje lúdico virtual.
La duración de la pasantía debiera ser de 3 días a la semana en media jornada y rotar en 4 departamentos distintos. Tener una reunión previa de los encargados de cada área de la empresa para acordar su función como pasantes, así como para presentarse y conocer los protocolos del staff de cada área. Los futuros docentes que deseen participar de pasantías deben tomar la pasantía como una experiencia que aportará desde la humildad y profesionalismo de cada uno, con una actitud receptora y colaboradora entre las partes.
Comenzamos este artículo señalando esta experiencia como un desafío de humildad, porque en nuestro camino docente nos vamos especializando y creemos ser dueños de la verdad, pero con esta actividad nos damos cuenta de que nuestra vida debe estar en un continuo permanente de aprendizaje que permita proyectar esta necesidad en nuestros estudiantes, nuestras familias y nuestra comunidad y durante toda nuestra vida, como se plasma en nuestro modelo educativo basado en capabilities.
Los pasos siguientes como Escuela de Turismo y Hotelería contemplan desarrollar nuevamente esta actividad para nuestros docentes en empresas turísticas durante en el mes de enero del 2024, en un proceso continuo estándar y regular que vaya incorporando sugerencias, evaluaciones recibidas ejecutando el plan de seguimiento de acuerdo a indicadores de mejora y calidad para nuestros estudiantes que aportan al Plan de Desarrollo institucional en particular el modelo de calidad docente.
Esta columna de opinión fue publicada el 8 de enero de 2024
Observatorio Duoc UC / Anuario 2024 / página 188
Puertas abiertas al conocimiento de inglés:
English Corner, un espacio seguro para desarrollar las destrezas lingüísticas en comunidad

En entornos académicos, un “English Corner” se define como un espacio destinado a actividades informales y participativas relacionadas con el idioma inglés. En la sede San Carlos de Apoquindo, el programa de inglés implementó este concepto el año pasado (2023) como una iniciativa para enriquecer el aprendizaje del idioma. Este espacio, ubicado en la biblioteca de la Sede, ofrece a estudiantes, docentes y miembros de la comunidad educativa la oportunidad de sumergirse en el inglés de manera práctica y divertida, complementando las clases tradicionales.
Para enriquecer la propuesta del English Corner, hemos establecido actividades donde puedan participar diversos actores de la comunidad San Carlos. Estas interacciones entre diferentes personas prometen aportar nuevas perspectivas y enfoques innovadores teniendo un mayor alcance en la comunidad. Así una de nuestras participantes nos comenta como fue su experiencia “me gusta mucho el inglés, pero no tengo experiencia más allá de lo del colegio… fue bueno ir dándome cuenta de que cada día iba entendiendo de lo que hablaban los demás. Para mí como auxiliar fue súper reconfortante el poder participar […] Felicitaciones nomás y espero que esto siga y que podamos participar aún más para seguir aprendiendo” (Nayarette Poblete, Auxiliar de Servicios Generales). Por otro lado, también nos comentan que durante las actividades “me sorprendió mucho la participación de diferentes personas, fue un momento maravilloso. Lo disfruté muchísimo porque te permite tener un espacio para poder conversar. El idioma si no se practica es muy difícil poder hablarlo […] Espero que este espacio se siga realizando” (Rina Belcoñian, Docente Escuela de Diseño). Asimismo, uno de nuestros asistentes frecuentes nos comentó “I believe that the English Corner is a pretty good idea so that you can practice your English between your classes, meet new people […] it’s pretty
Observatorio Duoc UC / Anuario 2024 / página 189
Observatorio de la Educación Superior Técnico Profesional - Producción y gestión del conocimiento
fun, I like it” (Gonzalo Fuenzalida, Estudiante Ing. Sonido). Finalmente, nos comentan que el “English Corner nos entregó la oportunidad de fortalecer y mejorar nuestro inglés en una dinámica divertida, acogedora y cercana” (Javier Pinto, director de carrera).
Docentes English Corner
Es importante señalar que la implementación del English Corner ha requerido una cuidadosa planificación y coordinación por parte del equipo docente. Este primer año nació de la voluntad de los docentes por desarrollar este espacio, pero se están gestionando recursos para garantizar la disponibilidad de materiales para este próximo año. La iniciativa fue liderada por las docentes Daniela León y Verónica de Ferrari en conjunto con los docentes Francisca Contreras, Malgorzata Wisniewska, Paulina Echegoyen, Jean Tapia, y Sebastián González quienes semana a semana presentaban un abanico de actividades pensadas en los participantes del English Corner

Observatorio Duoc UC / Anuario 2024 / página 190
Observatorio de la Educación Superior Técnico Profesional - Producción y gestión del conocimiento
En relación a la variedad de actividades, la elección de estas y temas específicos se ha realizado con el objetivo de fomentar la participación activa y el aprendizaje lúdico del inglés. Desde debates y juegos de roles hasta conversaciones sobre música y cine en inglés, ya que cada actividad está diseñada para proporcionar una experiencia educativa única y atractiva. Incluso tuvimos una sesión de cierre al estilo Tiny Desk con la participación musical de estudiantes y docentes. Al participar en este espacio, los estudiantes tienen la oportunidad de aplicar en tiempo real lo aprendido en clase, desarrollando habilidades comunicativas de manera práctica y efectiva. Por otro lado, administrativos, docentes e incluso estudiantes con una alta competencia en el idioma que se eximieron de las clases regulares, y hasta ahora no tenían un espacio para practicar, se han beneficiado al poner en práctica el idioma.
Además, en cada sesión hemos solicitado a los participantes enviar sugerencias y propuestas de mejora a través de encuestas para ir recibiendo sus impresiones en tiempo real y así poder aplicar mejoras oportunamente. De este modo, este enfoque participativo nos ha permitido crear un nuevo plan de trabajo para este segundo año, así como adaptar y enriquecer continuamente las actividades ofrecidas.
Es importante destacar que enfrentamos desafíos logísticos al organizar el espacio, las actividades y garantizar la disponibilidad de recursos. Sin embargo, gracias a una coordinación eficiente y el compromiso de nuestro equipo, hemos superado estos obstáculos para ofrecer un English Corner bien estructurado y acogedor. Además, el gran recibimiento y apoyo que nos dio el equipo de Biblioteca de la Sede desde un comienzo es destacable, se unieron a la idea y semana tras semana nos brindaron el espacio para llevar a cabo las actividades.

Observatorio Duoc UC / Anuario 2024 / página 191
Observatorio de la Educación Superior Técnico Profesional - Producción y gestión del conocimiento
English Corner de la sede San Carlos de Apoquindo se presenta como un espacio extracurricular para la aplicación práctica de habilidades lingüísticas, contribuyendo al desarrollo de la fluidez y confianza en el uso y aprendizaje del idioma del inglés. A medida que avanzamos, nos comprometemos a perfeccionar y expandir este programa, garantizando que continúe siendo un espacio seguro donde la lengua inglesa cobra vida, enriqueciendo las experiencias educativas de nuestros estudiantes.

Proyectando hacia el futuro, se tiene la intención de expandir y perfeccionar el English Corner mediante una difusión más efectiva. Esto incluirá explorar la posibilidad de aumentar la participación y beneficiarios del programa, conectándolos con experiencias más extensas semana tras semana. Esta expansión promete consolidar la conexión entre el English Corner y las clases regulares, proporcionando una valiosa oportunidad de exposición al inglés, especialmente para aquellas carreras y sus mallas donde el programa de inglés no está altamente integrado.
Observatorio Duoc UC / Anuario 2024 / página 192
Observatorio de la Educación Superior Técnico Profesional - Producción y gestión del conocimiento
Taller de teatro para colaboradores.
De la oficina al escenario, potenciando el desarrollo organizacional

El viernes 15 de noviembre, en el Auditorio I de la sede San Carlos de Apoquindo, se realizó la presentación final de la obra teatral “Amigas por siempre” montada en el Taller de teatro para colaboradores. La convocatoria para el taller estuvo dirigida a colaboradores de Casa Central y Antonio Varas como un proyecto piloto que respondió a la alianza entre la Dirección General de Personas y la Escuela de Comunicación con la carrera de Actuación. La obra abordó temas actuales respecto de la familia, la pareja y la vida laboral; fue dirigido por el profesor Vittorio Yaconi y, además de la participación de los colaboradores de distintas áreas, en la presentación final la obra contó con la participación de estudiantes de Actuación quienes se subieron al escenario para contribuir con la puesta en escena en canto y movimiento, dirigidos por el profesor Francisco Gómez.
Un taller de teatro para colaboradores puede tener un impacto extraordinariamente positivo en el desarrollo personal, profesional y organizacional. Las herramientas teatrales no solo enriquecen las habilidades individuales, sino que también fortalecen la dinámica del equipo y promueven un ambiente laboral más saludable. A continuación, se detallan algunos beneficios claves y ejemplos prácticos:
1. Mejora de la comunicación interpersonal
El teatro se basa en la escucha activa, la claridad en la expresión y la adaptabilidad. Estas habilidades son fundamentales en el ámbito laboral, especialmente en entornos donde el trabajo en equipo es esencial.
Ejemplo: Un colaborador que mejora su capacidad para expresar ideas con claridad en una presentación puede captar mejor la atención de su audiencia, impulsando el éxito de proyectos o negociaciones.
Observatorio Duoc UC / Anuario 2024 / página 193
Observatorio de la Educación Superior Técnico Profesional - Producción y gestión del conocimiento

Los actores y actrices (Colaboradores de Duoc UC y estudiantes de la carrera de Actuación) finalizando la obra teatral frente al público invitado.
2. Fortalecimiento del trabajo en equipo
Las dinámicas teatrales fomentan la confianza mutua, la empatía y la colaboración. Los ejercicios grupales enseñan a los participantes a apoyarse y adaptarse a las necesidades del equipo, elementos clave para resolver problemas en conjunto.
Ejemplo: Improvisaciones grupales ayudan a los equipos a practicar cómo responder con rapidez y creatividad ante cambios inesperados, una habilidad crucial en entornos dinámicos.
3. Desarrollo de la creatividad y resolución de problemas
El teatro estimula el pensamiento fuera de lo convencional y la exploración de múltiples perspectivas para abordar un desafío. Estas competencias se traducen en soluciones innovadoras dentro de la organización.
Ejemplo: Un equipo que participa en un taller de teatro puede encontrar maneras más ingeniosas y humanas de mejorar procesos o resolver conflictos internos.
4. Manejo de emociones y resiliencia
Los ejercicios teatrales permiten explorar emociones en un entorno seguro, ayudando a los participantes a gestionar mejor el estrés, la frustración o el miedo al fracaso. Esto resulta en colaboradores más equilibrados y resilientes.
Ejemplo: Practicar técnicas teatrales de manejo emocional puede transmitir calma y confianza durante momentos críticos en la organización.
Observatorio Duoc UC / Anuario 2024 / página 194
Observatorio de la Educación Superior Técnico Profesional - Producción y gestión del conocimiento

Algunos de los colaboradores realizando ejercicios de respiración antes de comenzar la función teatral, dirigidos por el docente.
5. Fortalecimiento de la confianza y la autoconfianza
Subirse a un escenario, aunque sea en un contexto lúdico, ayuda a los colaboradores a superar inseguridades y a sentirse más cómodos al hablar en público o asumir roles de liderazgo.
Ejemplo: Un colaborador que antes era tímido puede volverse participativo en reuniones, proponiendo ideas valiosas y liderando iniciativas.
6.
Creación de un ambiente laboral positivo
Las herramientas escénicas promueven el humor, la espontaneidad y la conexión entre colegas. Esto fortalece las relaciones interpersonales, reduce tensiones y fomenta un sentido de pertenencia.
Ejemplo: Una institución que organiza regularmente talleres de teatro puede observar un aumento en la satisfacción laboral y una disminución en el ausentismo.
Observatorio Duoc UC / Anuario 2024 / página 195
Observatorio de la Educación Superior Técnico Profesional - Producción y gestión del conocimiento

Impacto Global en la organización
Cuando Duoc UC invierte en el desarrollo humano de sus colaboradores a través de talleres como el teatro está apostando por una cultura organizacional más dinámica, innovadora y empática. Estos aspectos no solo mejoran la productividad y la retención de talento, sino que también proyectan una imagen de marca más atractiva tanto para colaboradores como para el exterior. El escenario y la cultura no es solo un espacio de juego, sino una herramienta poderosa para transformar equipos y organizaciones desde adentro.
Esta columna fue publicada el 25 de noviembre de 2024
Observatorio Duoc UC / Anuario 2024 / página 196
Observatorio de la Educación Superior Técnico Profesional - Producción y gestión del conocimiento
Testimonio de la estudiante
de Diseño Gráfi co Camila Droguett Castro, en la Jornada de Inclusión de Duoc UC

Hola, soy Camila Droguett Castro, tengo 23 años, estudio Diseño Gráfico en el tercer semestre en la sede Padre Alonso Ovalle de Duoc UC y tengo Síndrome de Down[1].
Yo entré al kínder en el año 2006, al colegio Estados Unidos, de la comuna de Pudahuel donde vivo. En ese colegio recibí un diploma por mi esfuerzo.
Luego, estudié desde el 2007 al 2011 en el colegio Alexander Graham Bell de primero a cuarto básico.
Mi madre siempre tuvo la inquietud de cambiarme, ya que yo no recibía apoyo escolar suficiente. Entonces, en el 2011 logró matricularme en el colegio San Luis Beltrán, de la misma comuna.
En ese colegio estaban todas las posibilidades que yo requería, todos los apoyos, profesores y especialistas necesarios. Ellos siempre me apoyaron y confiaron en mí.
La integración no fue muy buena, ya que mis compañeros se juntaban entre ellos y no se dirigían a mí. De todas formas, tuve 4 amigas, con las que siempre me junté y hacíamos todos los trabajos juntas, hasta que ellas se fueron a los liceos destacados de Santiago. Yo seguí en el mismo colegio hasta cuarto medio y solo tuve amigos de integración.
Algo que me gustó mucho fue participar de los talleres de discapacidad, donde aprendí a pintar y obtuve el premio Arte Down que me entregaron en Valparaíso. A la premiación fuimos con mi mamá y recuerdo que lo pasamos muy bien.
[1] Mensaje de la estudiante pronunciado el jueves 18 de julio de 2024, en el Aula Magna de la sede Antonio Varas de Duoc UC.
Observatorio Duoc UC / Anuario 2024 / página 197
Observatorio de la Educación Superior Técnico Profesional - Producción y gestión del conocimiento
El año 2021 ingresé a Duoc UC y me encontré con un entorno completamente nuevo que yo desconocía por completo.
Cuando llegué al Instituto sentí cierta incomodidad debido a los cambios que implicaba. Pasar del colegio al instituto significaba enfrentarme a nuevos profesores, nuevos compañeros y a un nuevo proceso de adaptación. Además, los ramos eran completamente nuevos y desconocidos para mí.
Por otra parte, me tocó un contexto muy singular: las clases presenciales se convirtieron en sesiones virtuales debido a la pandemia COVID-19.
Este cambio repentino no disminuyó mi entusiasmo inicial; por el contrario, ingresé con una actitud positiva y un firme deseo de aprender. Desde el principio, mostré un compromiso absoluto con mis estudios, participando activamente en todas las clases virtuales y demostrando un interés genuino por conocer tanto a mis compañeros como a mis profesores.
A medida que fui avanzando en mi experiencia, me di cuenta de que mis temores eran infundados. Los profesores resultaron ser personas amables y comprometidas, dispuestas a brindarme todo su apoyo. Me sorprendió gratamente su respeto hacia mi condición y su dedicación para enseñarme de la mejor manera posible. Cada semestre he tenido tutores para mis asignaturas, como, por ejemplo, en inglés, semiótica, matemática, lenguaje, ética, branding y producción de sistemas gráficos.
También debo destacar la maravillosa experiencia que tuve con mis compañeros. Desde el primer día me hicieron sentir parte del grupo, sin importar mi condición. Siempre estuvieron dispuestos a ayudarme a comprender los temas y a integrarme en todas las actividades.
El año 2023 Duoc UC me dio la posibilidad de trabajar con el Centro UC Down. Ellos me asignaron a una tutora, a Edita Núñez, y con ella me reunía para conversar acerca de los profesores, tutores y sus apoyos en las clases. Reunirme con ella me dio mucha seguridad en mí misma y me ayudó a enfrentar mis labores académicas.
Una vez finalizada mi etapa en el instituto, aspiro a emplearme en el campo de estudio que he cursado. Deseo dedicar todo mi esfuerzo y habilidades para alcanzar mis metas y progresar en mi carrera profesional. Es fundamental para mí que mi condición no sea considerada un obstáculo, sino que se reconozca mi compromiso y competencia como profesional. Anhelo que las oportunidades laborales valoren la persona que soy y me brinden la posibilidad de demostrar mi dedicación y capacidad.
Además, me gustaría utilizar mi experiencia única como persona integrada para promover la inclusión en la sociedad, mostrando a los demás que las personas con síndrome de down o cualquier otra discapacidad tienen talentos y habilidades valiosas para ofrecerlos y ayudarles para lograr su objetivo.
Muchas gracias por su atención.
Esta columna fue publicada el 22 de julio de 2024
Observatorio Duoc UC / Anuario 2024 / página 198
Observatorio de la Educación Superior Técnico Profesional - Producción y gestión del conocimiento
Innovación y Sustentabilidad Investigación Aplicada,
Observatorio Duoc UC / Anuario 2024 / página 199
Observatorio de la Educación Superior Técnico Profesional - Producción y gestión del conocimiento
Desarrollo de Bioantagonistas para el
Control de Hongos
en Cerezos:
Un Proyecto Colaborativo de Investigación Aplicada

La idea de un proyecto que comenzó en clases, en la asignatura Mentalidad Emprendedora, entre estudiantes de Ingeniería agrícola y su docente, Paulina Navarro. Estas inquietudes llegaron hasta mí, buscando asesoría técnica que sustentara su hipótesis.
Desde estos encuentros surgió una serie de interrogantes y como empecé a investigar sobre patógenos transmitidos con herramientas de poda. A partir de esta indagación identifiqué la oportunidad de investigar una importante problemática en cerezos, actualmente principal especie frutal de nuestro país, relacionada con las pérdidas de producción debido a hongos de la madera. Las pérdidas causadas por estos hongos se relacionan con aumento de costos de producción y pérdidas de rendimiento entre el 8% al 70%.

Observatorio Duoc UC / Anuario 2024 / página 200
Observatorio de la Educación Superior Técnico Profesional - Producción y gestión del conocimiento
Actualmente, su solución es preventiva, utilizando fungicidas como pastas de poda o tratamientos preventivos como eliminación de ramillas afectadas y desinfección de herramientas de poda.
El objetivo del proyecto fue evaluar la efectividad in vitro de diferentes bioantagonistas en el control de estos hongos de la madera asociados a los cerezos. Se busca identificar bioantagonistas capaces de inhibir el crecimiento de los patógenos, comenzando en condiciones de laboratorio para luego estudiarlos in vivo y finalmente en condiciones reales de campo.
El proyecto se basa en la premisa de que el control biológico al ser una estrategia sostenible puede complementar a los actuales controles culturales y químicos; disminuyendo la incidencia y gravedad de los efectos de los hongos de la madera; impactando en el menor uso de agroquímicos, menor desarrollo de resistencia por parte de los patógenos y reduciendo el impacto ambiental.

Observatorio Duoc UC / Anuario 2024 / página 201
Observatorio de la Educación Superior Técnico Profesional - Producción y gestión del conocimiento
Se realizaron pruebas con distintos bioantagonistas y se espera que los resultados de esta investigación proporcionen información valiosa para mejorar las prácticas de manejo y disminuir las pérdidas de producción en huertos de cerezos, contribuyendo a la sostenibilidad y rentabilidad agrícola.
El equipo de trabajo estuvo conformado en primera instancia por dos alumnos de la carrera de Ingeniería Agrícola de la sede San Bernardo: Felipe Salazar y Manuel Hernández, quienes fueron parte de las primeras ideas respecto al control de cáncer bacteriano a partir de la desinfección de herramientas de poda. Y las docentes del Programa de Innovación y Emprendimiento, Claudia Umanzor, periodista y Claudia Carreras, ingeniero agrónomo. Posteriormente se sumaron Catalina Valdivia, Valentina Briones y Vanessa Cruz; completando el equipo.
Nuestra forma de trabajo se ha centrado en la colaboración de todos los integrantes desde su mirada y su experiencia. La organización del trabajo ha sido semanal, ya que el equipo se reúne dos días a la semana y se dividen las tareas e indagaciones científicas; fomentando la participación de todos los integrantes en las distintas actividades, ya sean de laboratorio, terreno o difusión.
Observatorio Duoc UC / Anuario 2024 / página 202
Observatorio de la Educación Superior Técnico Profesional - Producción y gestión del conocimiento
La metodología utilizada se basa en el método científi co y tiene un enfoque experimental. La primera fase es la recopilación de información, resultados y metodologías que pueden ser utilizadas y/o adaptadas a nuestros objetivos de trabajo. Posteriormente pasamos al trabajo de laboratorio, comenzando con la identifi cación de biocontroladores en ensayos in vitro, para la selección y caracterización de los más efi cientes; según los resultados de cada prueba el biocontrolador pasa o no a la siguiente fase. La tercera etapa son las pruebas in vivo, las que realizamospara evaluar la actividad biocontroladora de los distintos microorganismos seleccionados, en consorcios o de manera individual. La cuarta etapa será las pruebas de campo, en condiciones reales.
Entre cada etapa y frente a resultados adversos, se reevalúa la información de la primera fase, buscando mejorar las metodologías utilizadas según las observaciones que van surgiendo en el avance del proyecto y se discuten los diferentes caminos que se pueden seguir.
Cada fase ha sido planificada y documentada a través de nuestra bitácora de laboratorio y fotografías, lo que nos ayuda a mantener el orden y la trazabilidad de los resultados obtenidos. Todo esto nos ha llevado a realizar un trabajo metódico y a la vez dinámico, frente a diversos obstáculos que hemos enfrentado en el camino. También hemos contado con la asesoría de profesionales de otras instituciones, como la Universidad de Chile que nos han apoyado en la metodología. La interacción con otros pares ha sido fundamental para nuestro avance, así como el apoyo del equipo de la Dirección de investigación aplicada.
Respecto al proyecto, nuestras alumnas Valentina Briones Caamaño y Catalina Valdivia, nos expresaron sus opiniones. Valentina Briones Caamaño nos señaló: “Mi participación en el proyecto de investigación fue una experiencia que aportó significativamente en mi formación, pues pude profundizar en los conocimientos de fitopatología porque trabajamos con hongos, recolectamos información, sacar conclusiones y ver las diferencias en el desarrollo de cada uno. También trabajamos en equipo lo cual aprendí a coordinar tareas, compartir ideas y desarrollar una mayor afinidad entre el grupo. En este proyecto pude realizar labores en laboratorio que no había realizado durante la carrera las cuales me interesan mucho seguir desarrollando y continuar en proyectos que tengan relación a este”. Y Catalina Valdivia nos dijo: ”Fue gratificante participar por el aprendizaje de cosas nuevas como algunos tipos de hongos que no conocía, además gracias al trabajo realizado durante todo el año pudimos experimentar y retroalimentarlo por la profesora Claudia, ya que el proyecto tenía circunstancias que eran ensayo y error, de modo que logramos avanzar sabiendo que tipo de bacteria nos ayudaría contra el ataque de hongos de la madera, Cabe recalcar que el trabajo ejecutado era semanal, donde debíamos vigilar el cambio e inhibición de la bacteria”.
Asimismo, el investigador líder nos expresó: Liderar este proyecto ha sido una gran experiencia, he podido aplicar mis conocimientos del área de fi topatología y conocer y trabajar con estudiantes, en que cada integrante del equipo ha sido clave para el desarrollo del proyecto. Su participación no solo enriquece su experiencia educativa; sino que, además, ayuda a forjar y fortalecer lazos con la comunidad que es Duoc UC, conectarse de manera más estrecha con los docentes, la Dirección de investigación aplicada e innovación y la industria.
Trabajar con Claudia Umanzor, ha sido esencial en nuestro proyecto. Desde su mirada periodística, ha aportado en la búsqueda objetiva de información y una clara transmisión de esta.
Este proyecto es especial para mí, me ha permitido desarrollarme en el área de investigación, que es mi pasión, dentro de Duoc UC. Mezclar el área académica, investigación y vinculación con la industria;
Observatorio Duoc UC / Anuario 2024 / página 203
Observatorio de la Educación Superior Técnico Profesional - Producción y gestión del conocimiento

brindando nuevos conocimientos, perspectivas y herramientas que han favorecido mi crecimiento profesional, abriendo nuevas oportunidades. También he podido generar nuevos vínculos con otros docentes de distintas áreas, así como con otras áreas de Duoc UC.
El desarrollo de la investigación aplicada, innovación y transferencia tecnológica es crucial para una educación integral dentro de la Educación Superior Técnico Profesional, ya que les permite a los alumnos y alumnas afianzar y ampliar sus conocimientos, desarrollar el análisis crítico, resolución de problemas, búsqueda de información confiable, creatividad y el trabajo en equipo.
Es importante que los alumnos y alumnas se enfrenten a problemas reales y sean partícipes del desarrollo de la solución, considerando diferentes factores desde el presupuesto, tiempo, conocimientos, entre otros. En la investigación aplicada, el diálogo entre teoría y práctica cobra relevancia, en este sentido, cuenta el conocimiento y la creatividad y la manera de vincular distintas áreas.
Esta columna fue publicada el 27 de mayo de 2024
Observatorio Duoc UC / Anuario 2024 / página 204
Observatorio de la Educación Superior Técnico Profesional - Producción y gestión del conocimiento
Desarrollo de un Bioestimulante para
la producción de setas, en base a algas nativas de las Costas de Chile

El cultivo de champiñones en la actualidad se enfrenta a un aumento considerable. Cada vez son más las variedades que ofrece el mercado y muchas de ellas comienzan a ser muy apetecidas. Busca el consumidor mantener una dieta sana, incorporando la mayor cantidad de fibras y vitaminas diariamente. Esto nos lleva a pensar que podemos tener disponible diversas variedades de hongos durante todo el año, a través de la compra en los diversos mercados, como a través del autocultivo.
A través de esta información podemos desarrollar un gran potencial para el cultivo de champiñones comestibles, demostrando su rentabilidad económica, la cual puede ser mejorada por sobre los rangos promedios, sobre todo en participación en el mercado nacional, a través de la utilización de biopreparados en base a algas nativas de nuestras costas, aumentando las producciones de este tipo de cultivo, gracias al aporte de nutrientes.
El uso de este biopreparado puede considerarse un fertilizante en las producciones industriales, como también a nivel de pequeños productores.
Este tipo de producto permite mejorar los rendimientos de las producciones de champiñones, debido a que las algas marinas son utilizadas como bioestimulantes, porque pueden aportar fitohormonas, aminoácidos, antioxidantes, incrementando el valor nutricional, estimular el sistema de defensa contra patógenos y reducir la incidencia de enfermedades.
El proyecto se desarrolló en el marco de su adjudicación bajo la convocatoria Investigación Aplicada Desarrollo Experimental 2023 y, durante 2024, trabajaremos realizando pruebas con una empresa dedicada a la producción de champiñones para uso gastronómico en fresco y venta de productos de autocultivo, donde probaremos a nivel de ensayos, fórmula del biopreparado, dosis y momentos de aplicación.
Observatorio Duoc UC / Anuario 2024 / página 205
Observatorio de la Educación Superior Técnico Profesional - Producción y gestión del conocimiento

Queremos aportar a la industria en el sentido de fomentar el consumo de champiñones comestibles en la población, existiendo mejores precios y alternativas en el mercado, además de brindarle una ventaja a los pequeños productores de setas comestibles, mejorando sus producciones.
Desarrollo del proyecto
El equipo del proyecto de Investigación Aplicada Desarrollo Experimental 2023, se conformó por la necesidad de desarrollar algo innovador que considerara el cultivo de champiñones comestibles. Es así como con un grupo de estudiantes, tomamos la idea y la enfocamos en mejorar la producción mediante el uso de un recurso natural, de muy bajo costo como lo son las algas de la costa de nuestro país.
La conexión que se logró durante el desarrollo del proyecto fue admirable. Como grupo se tomaron decisiones de acuerdo con los inconvenientes que tuvimos, que fueron varios, de forma muy profesional, aportando ideas para lograr sacar adelante esta maravillosa idea.
Este proyecto fue desarrollado en el Centro Tecnológico de Duoc UC, ubicado en Pirque, donde las bajas temperaturas de otoño e invierno nos impidió lograr la primera etapa de nuestro proyecto, que fue lograr una fructificación de las cepas que logramos inocular en nuestro sustrato.
Observatorio Duoc UC / Anuario 2024 / página 206
Observatorio de la Educación Superior Técnico Profesional - Producción y gestión del conocimiento

La metodología que utilizamos fue experimentación a nivel de laboratorio, donde de forma artesanal fuimos preparando cada una de las etapas. Utilizamos cajas plásticas, bidones de agua, bolsas plásticas (mushbag), todo material que nos permitiera desarrollar el proyecto. Durante el desarrollo logramos controlar las variables más complejas, como lo es la temperatura, iluminación y humedad.

Observatorio Duoc UC / Anuario 2024 / página 207
Observatorio de la Educación Superior Técnico Profesional - Producción y gestión del conocimiento
Posterior a eso, se comenzaron a preparar los diversos extractos de algas, se probaron distintas dosis, momentos de aplicación, entre otros, para ser probados en nuestras producciones, donde logramos obtener diferencias entre las producciones con el sustrato sin tratamiento y sustratos con tratamientos.
Para el desarrollo de este proyecto durante este año, en la etapa de Escalamiento y Transferencia, el grupo de estudiantes ha cambiado. Muchos de ellos se vienen integrando, por lo cual debemos enfocarnos en la obtención de resultados basándonos en el procedimiento y técnicas ya probadas. Estamos muy dispuestos a incorporar ideas nuevas, procedimientos, estar constantemente dispuestos a aprender y trabajar para lograr los objetivos.
Testimonio estudiante
“Este proyecto de investigación aplicada ha sido una experiencia enriquecedora, que ha fortalecido diversos aspectos de mi formación. En primer lugar, me ha enseñado la importancia de la constancia y el rigor en el cuidado de la inocuidad, para prevenir la contaminación y garantizar el éxito del proyecto. Además, ha sido revelador descubrir que los proyectos innovadores pueden ser una manera de conseguir ingresos, siempre que estén bien ejecutados, demostrando que el éxito no está limitado a un único camino preestablecido.

Observatorio Duoc UC / Anuario 2024 / página 208
Observatorio de la Educación Superior Técnico Profesional - Producción y gestión del conocimiento
A lo largo del proyecto, he desarrollado habilidades prácticas y teóricas, así como una mayor comprensión del proceso de investigación aplicada y su impacto en el ámbito profesional.
Esta experiencia me ha permitido crecer tanto a nivel personal como profesional, preparándome para enfrentar desafíos futuros con determinación y creatividad”.
(Gabriel Lafertte, estudiante de Ingeniería Agrícola).
Opinión del investigador
Por mi profesión como Ingeniero Agrónomo me desarrollé como investigador en la empresa privada por muchos años, lo que me permitió conformar equipos de trabajo con profesionales de distintas áreas, comprendiendo la importancia y el aporte desde las diversas veredas, para lograr una solución a cierta problemática.
Desde el punto de la docencia, el desarrollar proyectos en el área de Investigación Aplicada, me ha permitido volver a mis inicios y mediante diversos procedimientos poder transmitirles a los alumnos y alumnas las experiencias enriquecedoras de esta área de trabajo.
En la actualidad me encuentro desarrollando el perfil de Docente Investigador y liderando 2 proyectos de DIAIT, uno de la convocatoria Investigación Aplicada Desarrollo experimental y otro de Escalamiento y Transferencia, ambas convocatorias 2024, donde las actividades de investigación se conjugan con las prácticas, para lograr la solución de problemáticas que enfrentamos desde la agricultura, pero de una forma innovadora.
Desde esta área es posible enfrentarnos a problemáticas que deseamos solucionar a nivel de sociedad, obtener resultados mediante evaluaciones y poder llevarlo a la docencia a través de la difusión de resultados.
El generar conocimiento y transmitirlos a los estudiantes de Duoc UC, les permite ampliar la forma de observar el escenario profesional al que se enfrentarán, les permite fortalecer la formación integral, mejora su capacidad de análisis, ya que cuentan con las herramientas para desenvolverse de una mejor forma, explorando áreas que no imaginan que existen, logrando excelentes resultados.
Personalmente el trabajar en esta área de Investigación me permite generar, difundir y transferir conocimiento, promoviendo la innovación, la cual impactará en la sociedad de forma positiva, pues lo que buscamos en el desarrollo del proyecto son soluciones, enfocadas en la agricultura sostenible.
Esta columna fue publicada el 20 de mayo de 2024
Observatorio Duoc UC / Anuario 2024 / página 209
Observatorio de la Educación Superior Técnico Profesional - Producción y gestión del conocimiento
El impacto del cambio climático
en la vitivinicultura chilena: Una solución innovadora para la reducción del alcohol en vinos

Parry Andrade Docente de la Escuela de Ingeniería, Recursos Naturales y Medioambiente de la sede Puente Alto de Duoc UC.
Hoy en día, Chile ostenta un prestigioso puesto en el ámbito de la producción y exportación de vinos. Siendo una nación relativamente pequeña, se encuentra entre los primeros países que producen y exportan vinos, solo siendo superado por algunas potencias históricas del vino. En este contexto, en el que el vino forma parte importante del pool de productos que exportamos, no es de extrañar que el cambio climático amenace fuertemente al sector. En lo más instantáneo, este fenómeno global ha impactado la producción del vino desde sus bases: amenazando la calidad de la uva. Con temperaturas medias durante el verano que van en aumento, las vides producen bayas con menor acidez y lo que es más complejo, con mayor contenido de azúcar al momento de cosecha.
Consecuentemente, este incremento en la tasa de acumulación de azúcar implica una graduación alcohólica probable mucho mayor, lo que incide en mayores riesgos de fermentaciones incompletas dado el contenido de alcohol y afecta negativamente la comercialización de los vinos. La percepción del efecto negativo del alcohol, junto con la tendencia a un estilo de vida más saludable, han llevado a los consumidores a preferir vinos más frescos, ligeros y con menor contenido de alcohol. A partir de este desafío es que nos propusimos como equipo intentar validar una apuesta algo arriesgada: utilizar la uva de raleo (el exceso de uva que se desecha durante la producción), como insumo para obtener un fermentado que, al ser mezclado con el vino, nos permitiese disminuir su grado alcohólico sin perder características sensoriales relevantes.
Observatorio Duoc UC / Anuario 2024 / página 210
Observatorio de la Educación Superior Técnico Profesional - Producción y gestión del conocimiento

Para poder llevar a cabo este proyecto, conformé un equipo con dos docentes: María Edith Jiménez y Leonard Molero quienes desde sus respectivas áreas realizaron importantes contribuciones al desarrollo del ensayo. Sin embargo, fue el equipo conformado por los estudiantes el que determinó que pudiésemos cumplir con los objetivos propuestos. Cada uno de los alumnos y alumnas que participó en el proyecto mostraron su motivación y entusiasmo en cada actividad que desarrollaron.
Estas actividades incluyeron desde la recolección de la uva de raleo y su posterior vinificación, hasta la producción del vino estándar con el que se mezclaría el vino de raleo. Una vez obtenidos los vinos y las mezclas, los estudiantes encargados participaron activamente en realizar las determinaciones fisicoquímicas de cada uno de los tratamientos, lo que permitiría observar si existían diferencias entre los distintos vinos.
Finalmente, durante la ejecución del ensayo, el equipo fue entrenado para poder validar a cada participante como evaluador entrenado de vinos, para obtener valiosa información sensorial de cada tratamiento. En esta última etapa, se trabajó de manera metódica en talleres conducentes a lograr la identificación de los gustos básicos y luego, estandarizar con un método riguroso las percepciones de los evaluadores, a fin de obtener datos que, dentro de su subjetividad, fuesen estadísticamente confiables.
Danitza Spaho, alumna del proyecto, nos comenta: “Participar en este proyecto me aportó conocimientos y habilidades relacionadas principalmente con el área vitivinícola. Obtuve experiencia práctica en el proceso de vinificación de la uva de raleo, desde la cosecha hasta la obtención del producto final, al que se le realizaron pruebas y mediciones en laboratorio, y también pude aprender a trabajar con mis sentidos en la cata del producto final. Otro punto importante fue aplicar el conocimiento adquirido en asignaturas anteriores, reforzando la comprensión y capacidad para aplicarlos en situaciones reales".
Observatorio Duoc UC / Anuario 2024 / página 211
Observatorio de la Educación Superior Técnico Profesional - Producción y gestión del conocimiento

Finalmente, “el trabajo en equipo, teniendo la necesidad de remar todos hacia el mismo lado para que el proyecto se llevara a cabo, aportó mucho en nuestra formación como profesionales. Trabajar en equipo y de la mano con el docente líder, resolviendo problemas y desafíos durante cada etapa del desarrollo de este proyecto también fue muy provechoso”.
Observando en retrospectiva considero que la gestión y ejecución del proyecto fue una experiencia tremendamente gratificante. Poder liderar este proyecto no solo implicó reunir docentes y estudiantes con un objetivo común, sino que también significó tomar en cuenta cada una de sus motivaciones y expectativas como insumo para potenciar su participación y aprendizaje. En ese sentido, creo que todo el equipo se vio fortalecido.
El proyecto se enmarca en un contexto en el que la industria requiere más opciones frente a las dificultades existentes, por lo que poder contribuir a este desafío resulta muy motivador. Me parece que la manera en la que se ha puesto énfasis en el desarrollo de investigación aplicada es clave, no solo para aportar a la industria, sino también para impactar de manera definitiva en el desarrollo de los estudiantes, quienes adquieren conocimientos y nuevas herramientas que, en el futuro, les permitirán aportar valor a su trabajo y, con ello, retroalimentar positivamente su desarrollo profesional.
Observatorio Duoc UC / Anuario 2024 / página 212
Observatorio de la Educación Superior Técnico Profesional - Producción y gestión del conocimiento

No quisiera terminar esta columna sin recordar las palabras que nos expresó respecto al proyecto Giancarlo Robba, quien nos brindó apoyo técnico durante la ejecución del proyecto y contribuyó con valiosos consejos profesionales, así como su participación en las evaluaciones sensoriales. Nos dijo: “El trabajo desarrollado en el proyecto tiene una proyección muy interesante, especialmente considerando lo que está enfrentando el país. Es muy positivo que Duoc UC esté potenciando la investigación aplicada, ya que al final, esto permite traducir la ciencia más dura en aspectos aplicables en la industria”.

Observatorio Duoc UC / Anuario 2024 / página 213
Observatorio de la Educación Superior Técnico Profesional - Producción y gestión del conocimiento
Expo Diseñar Sustentable


El pasado martes 28 de mayo se llevó a cabo en la sede San Carlos de Apoquindo la primera versión de “Expo diseñar sustentable”, organizada por el laboratorio de materiales sustentables Circulab el cual fue creado el año 2023 con el apoyo de la Dirección de sostenibilidad de nuestra institución, como una “Iniciativa piloto sostenible de la Escuela de Diseño” y que pertenece al DDHUB- Hub de Diseño de Duoc UC.

Observatorio Duoc UC / Anuario 2024 / página 214
Observatorio de la Educación Superior Técnico Profesional - Producción y gestión del conocimiento
El propósito del laboratorio es promover la implementación de prácticas sostenibles dentro y fuera de la comunidad de Duoc UC, a través de la enseñanza, orientación y apoyo de la comunidad de estudiantes y docentes en el desarrollo de proyectos de carácter académico y/o de innovación e investigación, con foco en el uso, desarrollo y la aplicación de materiales sustentables en los procesos de diseño.
El quehacer Circulab aborda dos líneas temáticas de trabajo: Biomateriales y Transformación Material de otros residuos (plásticos, textiles, etc.).
La línea temática “Biomateriales” es dirigida por la docente investigadora de la Escuela de Diseño Cristina Rivera, jefa también del laboratorio, quien enfoca su trabajo en la experimentación con residuos orgánicos (cáscara de huevo, aserrín, cenizas, cáscaras y cuescos de frutas o verduras, algas, entre otros) con los que se pueden generar biomateriales. Mientras que la línea temática “Transformación Material” es dirigida por la docente de la Escuela de Diseño Isidora Guarda y se enfoca en la experimentación con residuos industriales o domiciliarios (plástico de tapas de bebida, desechos textiles, corchos de botellas ya usados y desechos del proceso de impresión 3D, entre otros) con los que se pueden generar nuevos materiales. Si tenemos en cuenta que el 80% de los impactos ambientales de un proyecto se defi nen en la fase de diseño, podemos visualizar lo relevante que es formar a los estudiantes de esta disciplina en metodologías de diseño sustentable, ecodiseño y nuevos materiales con menor impacto. De hecho, Expo diseñar

Observatorio Duoc UC / Anuario 2024 / página 215
Observatorio de la Educación Superior Técnico Profesional - Producción y gestión del conocimiento
Sustentable se planteó como una gran oportunidad para transmitir e interesar a nuestros estudiantes en alternativas sustentables para diseñar el mañana, motivándolos a familiarizarse con nuevas metodologías, materiales y procesos que les permitan incorporar el diseño sustentable a sus proyectos. Reducir, reparar, reutilizar, repensar desde el diseño y generar economía circular fueron los conceptos centrales abordados en la actividad, a través de charlas, exhibición de productos y procesos, demostraciones de elaboración de biomateriales y de inyección de plástico reciclado, realizadas por distintos expositores, entre los cuales hubo empresas y emprendimientos del mercado local, varios de ellos titulados y docentes de la Escuela de Diseño.
Entre ellos se destacan los siguientes:
* Karün: @karun_chile
* Reparemos: @reparemos
* Studio Órbita: @studio.orbita.cl
* Revalora: @revalorachile
* Cálida Tirana: @calida_tirana
* Tenaz Slow Fashion: @tenaz_slow_fashion
* Rubrum: @rubrum.cl
* Circulab DDHUB

Observatorio Duoc UC / Anuario 2024 / página 216
Observatorio de la Educación Superior Técnico Profesional - Producción y gestión del conocimiento

Los resultados de la actividad fueron excelentes, no solo en términos de convocatoria (más de 200 visitantes) y de vinculación con el medio, sino que también porque se cumplió el objetivo planteado de interesar a nuestros estudiantes en la temática, lo cual se ha reflejado en una gran cantidad de contactos recibidos por las docentes a cargo de Circulab, buscando asesoría y apoyo para el desarrollo tanto de sus proyectos académicos como personales. Sin duda, es una actividad que deberá proyectarse en el tiempo.
Esta columna fue publicada el 24 de junio de 2024
Observatorio Duoc UC / Anuario 2024 / página 217
Observatorio de la Educación Superior Técnico Profesional - Producción y gestión del conocimiento
Gestión hídrica intrapredial utilizando
sistemas de aeronaves pilotadas por control remoto (RPAS)

El proyecto de Gestión Hídrica intrapredial utilizando drones, nació por la necesidad de tomar decisiones de riego con certeza y menor riesgo, basada en información representativa y oportunidad de los sectores de riego. Inicialmente desarrollamos el proyecto el año 2022 en el viñedo ubicado en el CTRN Duoc UC de Pirque, con el fin de evaluar si índices vegetacionales, como el NDVI, obtenido a partir de imágenes tomadas por un dron multiespectral, tienen un buen desempeño para predecir el estado hídrico del viñedo al contrastarlo con mediciones de potenciales hídricos de las plantas, resultando en un índice predictor bastante prometedor para estados fenológicos entre cuaja y pinta, en donde se realizan manejos de riego deficitario controlado. Luego, el proyecto se escaló, con financiamiento interno de Duoc UC, probando las mismas relaciones en cultivos de palto y naranjo en ladera de cerro, ubicados en una agrícola en María Pinto (Melipilla), esperando utilizar este método con drones como una forma más representativa, rápida y no invasiva para poder gestionar el estado hídrico de otros cultivos.
El equipo se conformó por docentes de la Escuela de Ingeniería, Medio Ambiente y Recursos Naturales: Cristóbal Parry (Agrícola, 2022-2023), Alberto Iriarte (Medio Ambiente, 2022) y, finalmente, se incorporó Cristhian Garcés (Agrícola, 2023), todos aportando en manejos de viñedo, frutales, tecnologías agrícolas y manejo de precisión. Tanto en el proyecto de desarrollo 2022 como escalamiento 2023 tuvo una alta convocatoria y participación de estudiantes, integrándose 10 alumnos en cada año.
Las actividades desarrolladas consistieron en realizar campañas de mediciones de humedad de suelo, potenciales hídricos de las plantas y vuelo de drones en naranjos y paltos durante el 2023, desde abril hasta octubre; y en las vides del CTRN, se realizaron mediciones en el periodo entre cuaja y pinta, desde noviembre hasta enero. Luego de realizar las mediciones en terreno, se trabajó en el procesamiento de imágenes
Observatorio Duoc UC / Anuario 2024 / página 218
Observatorio de la Educación Superior Técnico Profesional - Producción y gestión del conocimiento

multiespectrales para la obtención de índices vegetacionales y, finalmente, se realizaron regresiones entre variables de suelo, planta e índices multiespectrales, con el fin de encontrar relaciones estadísticamente significativas que sirvan como predictores del estado hídrico.
En paralelo al trabajo de mediciones, en colaboración con la Biblioteca de la sede Puente Alto, se organizaron una serie de exitosos talleres con los estudiantes participantes con el fin de fortalecer sus habilidades de trabajo en equipo, uso de herramientas digitales, elaboración de proyectos de investigación, búsqueda de información, y cultivar conocimientos en áreas de propiedad intelectual.
Desde el año 2022 hasta ahora, la investigación se ha transformado en una actividad realmente motivante y desafiante, en el sentido que ha permitido desarrollarme profesionalmente en el área de manejo de precisión del riego como también fortalecer habilidades de liderazgo de equipos.
Además de los resultados esperados del proyecto en sí, también se desarrollaron recursos de aprendizajes que podrán ser transferidos directamente a la academia, actualizando los conocimientos en el rubro. Por otra parte, la oportunidad de llevar un proyecto a largo plazo con más cercanía con los estudiantes, por el hecho de capacitarlos y supervisarlos en sus labores permanentemente, ha impactado directamente en su formación, desarrollando un perfil profesional diferenciador, contando con certificaciones que los han inspirado a seguir creciendo en el área de tecnologías agrícolas. Estoy muy orgullosa y agradecida por la participación activa, colaboración, empatía y destrezas desarrolladas por mis estudiantes durante ambos proyectos.
Observatorio Duoc UC / Anuario 2024 / página 219
Observatorio de la Educación Superior Técnico Profesional - Producción y gestión del conocimiento
Opiniones de colaboradores y estudiantes respecto del proyecto
En el proyecto continuamente preguntamos a las empresas colaboradoras del proyecto que piensan de lo que hacemos. En tal sentido, Hallan Ahumada, miembro de una empresa colaboradora del proyecto, nos expresó: “Colaborar con Duoc UC ha sido crucial para Dron Chile, especialmente en el avance hacia la agricultura 4.0. Esta asociación ha permitido una integración eficaz entre enseñanzas teóricas y aplicaciones prácticas en tecnologías emergentes de drones, fundamentales para la modernización agrícola. Duoc UC se ha destacado por su compromiso con la innovación y la implementación práctica de conocimientos, lo que ha sido vital para fomentar una comprensión profunda de la agricultura de precisión entre los estudiantes. Su enfoque en la calidad educativa y en proporcionar herramientas concretas para el mercado laboral en este sector específico ha sido inspirador. Esta colaboración no solo ha beneficiado a los estudiantes, sino que también ha reforzado la transición hacia prácticas agrícolas más eficientes y sostenibles, marcando un hito importante para futuros proyectos en agricultura 4.0”.

Observatorio Duoc UC / Anuario 2024 / página 220
Observatorio de la Educación Superior Técnico Profesional - Producción y gestión del conocimiento
Daniel Cabrera de Aquadetect, nos señaló: “Tuvimos una buena experiencia en nuestra participación del proyecto. Fue interesante aportar desde nuestra experticia en el análisis de suelo y raíces en situación de estrés hídrico. Destacamos el ambiente colaborativo que se generó y valoramos la integración de tecnologías innovadoras como la nuestra en la investigación y desarrollo de institutos y universidades”.
También preguntamos a nuestros estudiantes sus opiniones y perspectivas. Joane Salinas, alumna de cuarto año de Ingeniería Agrícola, nos expresó: “Quisiera comentar parte de mi experiencia en el proyecto de Gestión del riego con Drones desde el 2022 al 2023, donde tuve la oportunidad de enriquecerme con prácticas en terreno de labores del riego y estados hídricos optimistas de diferentes cultivos como la Vid, Palitos y Naranjos.
En primera instancia, el llamado que hizo la docente públicamente para participar de dicho proyecto, fue algo sorpresivo para mí persona, puesto que durante los años de carrera de Ingeniería Agrícola que aún sigo cursando, no había visto la oportunidad de llamado abierto públicamente a participar de estos proyectos que encuentro que motivan y refuerzan los aprendizajes y la experiencia que uno va adquiriendo como alumna, y que muchas veces, no se pueden llevar tan a la prácticamente por la carga de horarios y conocimientos más teóricos que se entregan en aulas.
Desde el inicio al fin del proyecto de la profesora María Edith, siempre hubo una coordinación y trabajo constante como equipo de trabajo con los alumnos y alumnas participantes, en donde se capacitó siempre a todos los integrantes para poder ejecutar las labores de mediciones y registro de los rangos hídricos de cada uno de los frutales en estudio, por lo que la ejecución de las tareas planificadas, se hacían cómodas, rápidas y sin dificultades para poder desarrollarlas. En conjunto a estas labores, pude reforzar el trabajo de mediciones de suelo que por pandemia no pude ver en terreno práctico en los semestres anteriores, por lo que me fue beneficioso para poder pulir esta área.
La oportunidad de adquirir conocimientos nuevos en el manejo de herramientas tecnológicas como el uso del dron, me aportó como estudiante para sentirme más segura para las futuras experiencias laborales que podría optar en campo, y para ver la posibilidad de internarse con más profundidad en el tema y manejo de este medio a futuro. La inducción, capacitación y evaluación del uso de esta herramienta fue con total conformidad y éxito para decir hoy que tenemos los conocimientos prácticos y teóricos de esta herramienta, que está siendo tan usada actualmente en el mundo agrícola y que pudimos evidenciar con el exitoso momento de adquirir nuestra licencia para manejo de Dron.
Por otro lado, en cuanto a la forma en que se implementó el proyecto, mencionar que siempre hubo una guía clara y efectiva que recibimos en conjunto; es decir, no solo de parte de la docente a cargo, sino de todo el resto del equipo de docentes que también se encargaban de entregarnos sus conocimientos para poder resolver nuestras dudas y cuestionamientos de algunos manejos en terrenos. Siendo esto para mí, un apoyo y motivación para seguir participando en estas actividades que valen la pena vivir durante el periodo estudiantil, integrando seguridad y manejos claros en términos académicos del rubro.
Me hubiera gustado que el proyecto pudiese haber escalado aún más y poder investigar otras áreas con el manejo del Dron, pues considero que es una herramienta muy útil, eficiente y de precisión para poder innovar en nuevos manejos que se pueden implementar en el área agrícola y poder encontrar a futuro, un mayor número de usuarios que la utilicen y opten por implementar esto en sus campos, pudiendo ser nosotros mismos participantes de este tipo de proyectos, asesores o capacitadores de estas labores para aportar con avances tecnológicos a pequeños agricultores”.
Observatorio Duoc UC / Anuario 2024 / página 221
Observatorio de la Educación Superior Técnico Profesional - Producción y gestión del conocimiento

La alumna Evolet Likankura que cursa el tercer año de la carrera de Ingeniería Agrícola, nos expresó: “Me permitió conocer la capacidad que tienen los drones de poder medir la gestión hídrica a través de Fotografías aéreas, siendo estas de gran resolución desde el aire, que nos permiten monitorear la distribución de agua en predios, también a través de sensores que pueden medir la humedad, temperatura, salinidad o calidad del agua, datos importantísimos para evaluar la salud de los recursos hídricos, imágenes multiespectrales que nos entregan información sobre la salud vegetativa en cuanto a la disponibilidad de agua en el suelo y si la eficiencia del riego es la más adecuada.
Toda esta información se procesa a través de un software especializado. Estas capturas nos servirán para conocer e identificar patrones de uso del agua, áreas con problemas de drenaje o infiltración y cambios en la cobertura del suelo que afecten la gestión hídrica.
También dentro de este proyecto a través de Biblioteca recibimos capacitaciones o talleres adicionales que van de la mano con el proyecto tales como:
Taller de “Excel”, donde aprendimos operaciones y funciones básicas.
Taller de “Búsqueda de información a través de artículos científicos”.
Taller de “Como desarrollar una investigación”.
Taller de “Herramientas digitales para el trabajo colaborativo”.
Taller de “Vigilancia tecnológica”.
Taller “Registro de marcas”.
Taller de “Propiedad intelectual”.
Observatorio Duoc UC / Anuario 2024 / página 222
Observatorio de la Educación Superior Técnico Profesional - Producción y gestión del conocimiento
Reforzamos lo aprendido en la asignatura de riego utilizando una Bomba Scholander, que nos permite evidenciar el potencial hídrico de los tejidos de una planta.
La humedad de suelo lo medimos a través de un software conectado de forma inalámbrica al celular, quien nos entregaba información de la humedad relativa, presión atmosférica y temperatura ambiente. Además, para poder obtener toda esta información es importante conocer el manejo de una nave pilotada a distancia. Para completar esta participación fui una de las seleccionadas para recibir el curso de capacitación como Operador de drones en Academia de Drones Chile y su correspondiente certificación a través de la DGAC. Además, la oportunidad de convalidar la práctica laboral con mi participación en este proyecto.
Por último, aprendí la importancia de incluir métodos con nuevas tecnologías, que nos entreguen información actualizada para favorecer tiempos y obtener respuestas más rápidas para hacer soluciones precisas y eficientes”.

Esta columna fue publicada el 3 de junio de 2024
Observatorio Duoc UC / Anuario 2024 / página 223
Observatorio de la Educación Superior Técnico Profesional - Producción y gestión del conocimiento
Innovación Tecnológica para el Cuidado
de Adultos Mayores: Proyecto ELEAM@TIC y la Detección de Caídas en Chile

Figueroa Colarte Docente Asociado e Investigador y Coordinador de Proyectos Tecnológicos en la sede Viña del Mar de Duoc UC.
En el año 2021, junto a mi equipo, iniciamos un proyecto de investigación aplicada experimental, que en 2022 se transformó en un proyecto de escalamiento, apoyado con fondos de la Dirección de Investigación Aplicada Innovación y Transferencia (Diait). Nuestro objetivo era claro: abordar la atención integral y la detección de caídas en los Establecimientos de Larga Estadía para Adultos Mayores (Eleam) en Chile. El proyecto “ELEAM@TIC” se enfoca en la incorporación de tecnología sensorial para mejorar la calidad de vida de los adultos mayores residentes en estos establecimientos.
La problemática principal que buscamos abordar es la alta incidencia de caídas entre los adultos mayores, un problema que es crítico y con consecuencias severas, como fracturas y pérdida de independencia. Ante la falta de soluciones efectivas, nos propusimos explorar el uso de sensores vestibles, o wereables, para la detección temprana de caídas.
Desde el inicio nuestro enfoque ha sido multidisciplinario, involucrando a expertos en tecnología, diseño de vestuario, fisioterapia, enfermería, así como a estudiantes y profesionales de diversas áreas. La metodología adoptada, basada en Design Thinking, nos permitió empatizar y desarrollar un prototipo tecnológico vestible con sensores avanzados, como acelerómetros y giroscopios, capaces de detectar movimientos bruscos y cambios de postura.
Los resultados preliminares fueron prometedores, mostrando una mejora significativa en la detección de caídas y alertando de manera oportuna al personal de atención. Esto no solo reduce el riesgo de lesiones graves, sino que también proporciona mayor seguridad y tranquilidad tanto para los residentes autovalentes, como para sus familias.
Observatorio Duoc UC / Anuario 2024 / página 224
Observatorio de la Educación Superior Técnico Profesional - Producción y gestión del conocimiento

El impacto esperado de “ELEAM@TIC” es profundo, con el potencial de transformar la atención en Eleam, promoviendo un entorno más seguro y tecnológicamente avanzado. A medida que escalamos el proyecto, anticipamos que esta solución innovadora, se convertirá en un estándar en la mejora de la calidad de vida de miles de personas mayores; es decir, actualmente empatizamos con más de 8000 residentes en Chile, y que son potenciales beneficiarios de nuestra solución.
El proyecto “ELEAM@TIC” se ha desarrollado con la colaboración de un equipo multidisciplinario comprometido y capacitado. La conformación del equipo ha sido crucial para abordar la problemática de la detección de caídas en los Establecimientos de Larga Estadía para Adultos Mayores (Eleam). El equipo estuvo compuesto por:
Observatorio Duoc UC / Anuario 2024 / página 225
Observatorio de la Educación Superior Técnico Profesional - Producción y gestión del conocimiento

1. Priscila Palacios Mora: Diseñadora industrial, Magíster en Educación mención Inclusión, con experiencia en vestuario e inclusión para adultos mayores.
2. Miguel Ortiz Vera: Ingeniero en Conectividad y Redes, Magíster en Ciberseguridad, con experiencia en IoT y redes.
3. Patricia Carvajal López: Enfermera y titulada de Ingeniería Informática, con experiencia en salud, IoT y arduino.
4. Fabiola Peña Tapia: Titulada de Fisioterapeuta con experiencia en salud y cuidado de adultos mayores.
5. Mauricio Figueroa Colarte: Ingeniero Civil en Informática, Magíster en Tecnologías de la Información, líder del proyecto con experiencia en gestión de proyectos e inteligencia artificial.
6. Almendra Quiñones Quiñones: Titulada de Ingeniería Informática, con experiencia en IoT, electrónica y robótica.
7. Martín Muñoz Toro: Titulado de Conectividad y Redes, con experiencia en IoT.
8. Gubica Muñoz Toledo: Titulada de Diseñadora de vestuario con experiencia en productos industriales.
Observatorio Duoc UC / Anuario 2024 / página 226
Observatorio de la Educación Superior Técnico Profesional - Producción y gestión del conocimiento

La metodología aplicada, se basa en Design Thinking y el proceso ROPES (Rapid Object-Oriented Process for Embedded Systems), permitiendo un enfoque estructurado y centrado en el usuario. El desarrollo y fases del proyecto se basan en las siguientes etapas:
1. Empatizar: Comprender las necesidades y experiencias de los adultos mayores y el personal de los Eleam mediante entrevistas y observaciones. Se aplicaron cuestionarios y se observaron las rutinas diarias para entender los desafíos desde la perspectiva del usuario final.
2. Definir: Sintetizar las observaciones para definir claramente los problemas y necesidades. Se identificaron patrones y temas comunes, creando declaraciones de problemas claros y concisos centrados en los usuarios.
3. Idear: Generar una amplia gama de ideas y soluciones posibles. Se organizaron sesiones de lluvia de ideas con el equipo multidisciplinario, fomentando un entorno de pensamiento libre y creativo.
4. Prototipar: Diseñar y desarrollar un prototipo vestible con sensores avanzados como acelerómetros y giroscopios, integrados en una prenda cómoda para los adultos mayores.
5. Probar: Realizar pruebas controladas para evaluar la eficacia del prototipo en la detección de caídas. Los resultados se analizaron para identificar áreas de mejora y optimizar el dispositivo.
6. Implementar y Monitorear: Implementar el prototipo en Eleam seleccionados y monitorear su uso, recopilando retroalimentación de los usuarios y el personal de atención para realizar mejoras continuas.
Observatorio Duoc UC / Anuario 2024 / página 227
Observatorio de la Educación Superior Técnico Profesional - Producción y gestión del conocimiento
Testimonio de una estudiante participante
Patricia Carvajal, estudiante de Ingeniería Informática, actualmente titulada: “Participar en el proyecto ELEAM@ TIC ha sido una experiencia transformadora. Como estudiante de ingeniería, la oportunidad de aplicar mis conocimientos en un contexto real, donde cada ajuste en nuestro diseño podría significar una mejora tangible en la vida de alguien, ha sido increíblemente enriquecedora. Este proyecto no solo ha complementado mi formación académica, sino que ha ampliado mi visión sobre cómo la tecnología puede servir a la sociedad.”
Testimonio de una empresa del Entorno
Roberto Ruiz, presidente de ASERVAL (Asociación de Eleam V Región): “La experiencia de colaborar con Duoc UC en el proyecto ELEAM@TIC ha sido muy buena. Desde el inicio, en pandemia, el compromiso y la innovación del equipo fueron evidentes. Aunque queda mucho por hacer y mejorar aún para hacer la transferencia real, pero ver cómo la tecnología y conocimientos pueden contribuir directamente a mejorar la calidad de vida de los adultos mayores ha sido gratificante y un claro ejemplo del impacto positivo que la colaboración entre academia y sector privado puede lograr”.
Conclusiones
Dirigir el proyecto “ELEAM@TIC” ha sido uno de los hitos más destacados de mi carrera en estos últimos tres años. Esta iniciativa ha reafirmado mi creencia en la investigación aplicada como un motor clave para la innovación y la transferencia tecnológica en el ámbito de la educación superior técnica y profesional.

Observatorio Duoc UC / Anuario 2024 / página 228
Observatorio de la Educación Superior Técnico Profesional - Producción y gestión del conocimiento

La posibilidad de trabajar en soluciones que combinan empatía y tecnología ha enriquecido significativamente mi trayectoria profesional. Este proyecto no solo me ha permitido aplicar conocimientos técnicos avanzados, sino también entender profundamente las necesidades de una población vulnerable, como son los adultos mayores en Eleam. Al desarrollar y probar soluciones tecnológicas que mejoran su calidad de vida, he visto de primera mano cómo la innovación puede tener un impacto tangible y positivo en la sociedad.
La relevancia de la investigación aplicada radica en su capacidad para traducir teorías y conceptos académicos en soluciones prácticas y efectivas. Este enfoque no solo beneficia a los estudiantes, al proporcionarles experiencias de aprendizaje reales y significativas, sino también a las comunidades, al ofrecer respuestas concretas a problemas reales. En el caso de “ELEAM@TIC”, la investigación ha ido más allá del aula, impactando directamente en la vida de los adultos mayores y el personal de los Eleam, beneficiarios de estas innovaciones.
Además, este proyecto ha subrayado la importancia de la transferencia tecnológica en la Educación Superior Técnico Profesional. La colaboración entre estudiantes, docentes y profesionales de diversas disciplinas ha sido fundamental para el desarrollo de soluciones efectivas. Esta sinergia no solo fomenta un entorno de aprendizaje dinámico y colaborativo, sino que también prepara a los estudiantes para enfrentar los desafíos del mundo laboral con una mentalidad innovadora y práctica.
Esta columna fue publicada el 3 de junio de 2024
Observatorio Duoc UC / Anuario 2024 / página 229
Observatorio de la Educación Superior Técnico Profesional - Producción y gestión del conocimiento
La contribución de proyectos
tecnológicos al bienestar animal
y
la
sustentabilidad: El caso del forraje hidropónico en Buinzoo

Gracias al apoyo técnico y al financiamiento de la Diait, logramos junto con mi equipo concretar la construcción de un sistema tecnológico de producción de plantas, el cual fue mutando debido a las diferentes circunstancias naturales de cada proyecto, estableciéndose como un módulo para producir forraje. Este forraje se puede obtener mediante el uso de fertilizantes disueltos en agua (hidropónico) o con los agregados metabólicos de peces (acuapónico).
Nuestro objetivo principal es generar alimento para animales utilizando poca agua y basado en un modelo de economía circular. Inicialmente, nos enfocamos en agricultores y ganaderos de zonas con escasez hídrica del norte de Chile, lo cual es una problemática urgente de abordar, por los efectos negativos que genera en aquellas comunidades agropecuarias donde nuestro proyecto tiene el potencial de aportar a las soluciones requeridas.
Los resultados esperados con este sistema incluyen producir forraje de manera escalonada cada semana, determinar tiempos de crecimiento, frecuencias de riego optima, niveles de temperatura y humedad relativa ideales. También se espera enriquecer las dietas y las estrategias de alimentación de distintos animales. Además, queremos demostrar la versatilidad del módulo al poder funcionar y aportar valor tanto para agricultores, granjas educativas, zoológicos, criaderos de aves y cerdos, como a escuelas, colegios y liceos.
Observatorio Duoc UC / Anuario 2024 / página 230
Observatorio de la Educación Superior Técnico Profesional - Producción y gestión del conocimiento

El equipo de trabajo se conformó con integrantes de las carreras de Ingeniería Agrícola e Ingeniería en Electricidad y Automatización de la sede Puente Alto. Esta unión de especialidades relacionadas a los recursos naturales y tecnología resultó ser muy acertada, ya que se generó una sinergia que impulso la creatividad y permitió adaptarse a los problemas que surgieron, obteniendo resultados que superaron nuestras expectativas. Mi colega Camilo Basay, junto con sus alumnos y alumnas, se encargaron de incluir sensores con un microcontrolador para monitorear las variables de temperatura, caudal y nivel. Mientras tanto, yo junto con mis estudiantes nos enfocamos en el sistema hidráulico, el control de riego y el sistema productivo. Aunque nuestras disciplinas estaban separadas, todos pudimos aprender unos de otros, complementando muy bien la ejecución de cada labor.
Se concretó un prototipo funcional que ocupa menos de 4 metros cuadrados, construido con distintas partes de PVC. Con estas piezas se armó una estructura tipo repisa de 3 cuerpos y 2 pisos que sostienen las 6 bandejas, lo que permite incorporar módulos anexos para expandir la capacidad productiva según sea necesario.
Como fase inicial, dibujé con lápiz y papel las distintas formas que podría tener el sistema, ajustando los diseños hasta llegar al mínimo viable. Luego, realicé la cubicación para entender las cantidades de materiales, insumos, herramientas y equipos necesarios para poder construirlo. Finalmente, la prueba de fuego fue la puesta en marcha, donde se accionó la bomba periférica para comprobar la prueba de hermeticidad y el funcionamiento del circuito hidráulico cerrado, obteniendo sistema totalmente operativo de manera satisfactoria.
Observatorio Duoc UC / Anuario 2024 / página 231
Observatorio de la Educación Superior Técnico Profesional - Producción y gestión del conocimiento

El siguiente turno fue incorporar semillas de trigo en cada bandeja y regarlas con los goteros acondicionados en la repisa. En menos de 2 semanas, se obtuvieron brotes germinados sobre 15 centímetros, con raíces entrelazadas formando un tapete verde comestible. Estos brotes alimentaron a distintos animales en condiciones controladas en el Centro Tecnológico de Recursos Naturales de Duoc UC en Pirque. En el segundo semestre del 2023, impulsé y gestioné una alianza estratégica con Buinzoo, donde transferimos el sistema a las instalaciones del parque. Utilizamos agua del estanque de peces que está en el hábitat de los lémures, ya que esta tiene los agregados metabólicos que sirven como nutrientes para las plantas. Estos nutrientes son estabilizados por un biofiltro que incorporamos al sistema utilizando tapas plásticas recicladas que alojan bacterias que naturalmente están en el ambiente y se encargan de transformar los elementos en formas asimilables por los cultivos, obteniendo resultados positivos al cosechar forraje fresco para los animales del zoológico.
La alumna Camila González, estudiante de ingeniería Agrícola, nos manifestó: “Tener la oportunidad de participar en un proyecto de estas dimensiones siendo solo estudiante de segundo año de ingeniería Agrícola, fue muy desafiante e interesante. Desde el primer momento, lo asumí como una gran responsabilidad, este proyecto ha sido una instancia de poder conocer distintos aspectos asociados al implementar algo totalmente nuevo a un contexto con un enfoque complejo y establecido, pero sin miedo a innovar. La alianza que se logró con Buin zoo fue realmente un logro muy importante. El trabajo en equipo y la constancia para siempre llegar al objetivo propuesto fueron mis bases para poder estar a la altura de lo que demandaba estar embarcado en esto, por otra parte, estudiar de manera autodidacta permitió ampliar mi visión e interesarme por otras áreas como lo que es el bienestar y nutrición animal, debido al producto que estaba bajo nuestra responsabilidad.”
Observatorio Duoc UC / Anuario 2024 / página 232
Observatorio de la Educación Superior Técnico Profesional - Producción y gestión del conocimiento
Como director del proyecto, tuve que coordinar las actividades de cada integrante, gestionando recursos para alcanzar objetivos, por lo que las habilidades de liderazgo fueron cruciales para mantener al equipo enfocado. En función a todo lo que se realizó en el proyecto, destaco la importancia de la planificación y el aporte de valor a mi trayectoria docente y profesional, marcando un hito que me permite extraer todo lo aprendido y aplicarlo en mis clases, generando un efecto positivo hacia las asignaturas que imparto.
Estoy convencido de que este tipo de iniciativas pueden generar un impacto positivo y tangible en el sector ambiental, social y productivo. Además, logran dejar una huella en las vidas de nuestros estudiantes, que al involucrarse en el proceso extrapolan los conocimientos adquiridos en situaciones reales, siendo la transferencia tecnológica el último eslabón que le da sentido a todo lo anterior, ya que al trasladar los resultados generados hacia las problemáticas o necesidades tanto de las personas como de empresas se logra concretar el propósito de hacer investigación aplicada.

Finalmente, el Dr. Alberto Duarte, Gerente de Bienestar animal del parque zoológico Buinzoo nos expresó refiriéndose a este proyecto: “Ha sido una experiencia interesante, al ver el funcionamiento del módulo y la producción de forraje, que ha servido para aportar a las estrategias de bienestar animal. En base a los resultados prometedores que sigan apareciendo, proyectamos poder tener unos de estos sistemas tecnológicos en la nueva huerta que tendrá el bioparque para contribuir a nuestra política de sustentabilidad y difusión educacional para nuestros visitantes”.
Esta columna fue publicada el 20 de mayo de 2024
Observatorio Duoc UC / Anuario 2024 / página 233
Observatorio de la Educación Superior Técnico Profesional - Producción y gestión del conocimiento
La experiencia del Proyecto Pyura
de la Escuela de Gastronomía en la sede San Andrés de Concepción

En conjunto con la Dirección de Investigación Aplicada y Transferencia Tecnológica de nuestra institución, nos embarcamos en un proyecto que marcaría un hito en nuestra labor educativa y de investigación: el proyecto Pyura, proceso hidro sostenible con el objetivo de abordar la problemática del consumo excesivo de agua en el sector gastronómico.

Observatorio Duoc UC / Anuario 2024 / página 234
Observatorio de la Educación Superior Técnico Profesional - Producción y gestión del conocimiento
Conscientes del impacto ambiental de nuestras acciones y de la importancia de fomentar prácticas sostenibles, nos propusimos encontrar dentro de nuestra sala de clases, una solución efectiva que contribuyera a reducir el desperdicio de agua y promover una gestión más eficiente de este recurso vital. Con esto esperamos desarrollar un sistema sostenible en el accionar de la cocina que permita reutilizar las aguas grises de lavado de manos y otras tareas de cocina de baja suciedad y con ella poder realizar nuevas tareas de aseo, así le damos un segundo uso a este valioso recurso que está, en algunos lugares del mundo, siendo un producto muy escaso y valioso.
Desarrollo del Proyecto
Para llevar a cabo este proyecto, conformamos un equipo multidisciplinario compuesto por expertos en el área de diseño industrial, diseño gráfico, biología, expertos ambientales y del área gastronómico, además de alumnos y alumnas de la escuela de diseño y gastronomía. Los estudiantes propusieron el nombre Pyura, inspirado en la especie marina Pyura chilensis, un animal filtrador de agua de la familia de los invertebrados. Este nombre refleja la esencia del proyecto y su propósito.

Observatorio Duoc UC / Anuario 2024 / página 235
Observatorio de la Educación Superior Técnico Profesional - Producción y gestión del conocimiento
Durante el desarrollo, nos enfocamos en la investigación de tecnologías de tratamiento de aguas grises y en la adaptación de ellas al contexto de un taller de cocina, considerando la cantidad de estudiantes que usan estos espacios y el recurso agua. La metodología empleada incluyó una exhaustiva revisión de la literatura científica, análisis de casos similares y pruebas piloto en nuestro propio taller de gastronomía. Dividimos el proyecto en varias fases, desde la caracterización de las aguas residuales hasta la implementación y validación del sistema de reutilización de aguas grises.
Después de meses de arduo trabajo, logramos desarrollar un sistema de tratamiento en dos etapas, que incluye un pretratamiento con cámaras cortadoras de jabones y grasas, seguido por un filtro de arena como tratamiento final. Estamos convencidos de que este sistema no solo contribuirá a reducir el consumo de agua en nuestro taller de cocina, sino que también sentará un precedente importante en la promoción de prácticas sostenibles en el sector gastronómico.

Experiencia del docente investigador
Liderar el proyecto Pyura ha sido una experiencia enriquecedora y gratificante para mí como docente e investigador. Este proyecto me ha permitido aplicar los conocimientos teóricos adquiridos en mi formación académica a un problema real y tangible. Además, ha sido emocionante trabajar en equipo con colegas y estudiantes apasionados por encontrar soluciones innovadoras a los desafíos ambientales de nuestro tiempo. Creo firmemente en la importancia de la investigación aplicada, la innovación y la transferencia tecnológica en la Educación Superior Técnico Profesional. Proyectos como Pyura no solo nos permiten contribuir al desarrollo de soluciones concretas a problemas reales, sino que también brindan a nuestros estudiantes la oportunidad de aprender haciendo, preparándolos para enfrentar los desafíos del mundo laboral con éxito y responsabilidad.
Observatorio Duoc UC / Anuario 2024 / página 236
Observatorio de la Educación Superior Técnico Profesional - Producción y gestión del conocimiento
El proyecto Pyura representa no solo un avance significativo en la gestión sostenible del agua en el sector gastronómico, sino también un ejemplo del compromiso de nuestra institución con la investigación aplicada y la formación integral de nuestros estudiantes. Estoy seguro de que los resultados de este proyecto tendrán un impacto positivo tanto en nuestra comunidad educativa como en el medio ambiente.
Experiencia del estudiantado
Patricio Ariel Contreras Muñoz, estudiante de Diseño Industrial nos expresó:
“Con el equipo Pyura realmente pude comprobar muchos de los conocimientos que adquirí en mi formación académica, tanto competencias técnicas como de comunicación, aplicándolos en un contexto real. En el transcurso actual de mi carrera, he visto reflejado los beneficios de participar en proyectos de esta envergadura. Ahora me siento mucho más preparado que antes para enfrentar desafíos del mundo laboral”.

“En cada reunión del proyecto, sentía un ambiente distinto al de salón de clases; más parecido a un verdadero equipo de trabajo, donde todos ejecutan sus habilidades y competencias únicas. Las personas involucradas en el proyecto son profesionales de excelencia y un grupo muy humano, lo que enriqueció mi desarrollo personal, académico y profesional que de otra manera no habría sido posible”.
“Valoro muchísimo que hayan incluido a un grupo de estudiantes dentro del proyecto. Por la experiencia, por el aprendizaje, por “hacer escuela”, por crear a Pyura, gracias”.
Esta columna fue publicada el 17 de junio de 2024
Observatorio Duoc UC / Anuario 2024 / página 237
Observatorio de la Educación Superior Técnico Profesional - Producción y gestión del conocimiento
Proyecto COIL 2024-02: Innovación y
Tecnología en la Prevención de Enfermedades Crónicas

En el marco de la educación multidisciplinaria y multicultural, la colaboración COIL (Collaborative Online International Learning) entre estudiantes de la Escuela de Informática y Telecomunicaciones de Duoc UC y estudiantes de Medicina del Tecnológico de Monterrey, es un claro ejemplo de cómo la tecnología y la medicina pueden converger para abordar desafíos globales en el área de la salud. En esta ocasión, el enfoque se ha centrado en desarrollar soluciones tecnológicas innovadoras que permitan prevenir de manera temprana enfermedades crónicas como la diabetes mellitus, la hipertensión y las enfermedades renales crónicas, con el objetivo de mejorar la calidad de vida de los pacientes afectados por estas condiciones. A través de esta colaboración, los estudiantes de ambas instituciones han trabajado de manera conjunta en la creación de propuestas tecnológicas orientadas a optimizar el manejo nutricional promoviendo hábitos alimenticios saludables y actividad física que permiten mitigar y frenar el avance de estas enfermedades. Asimismo, mediante esta colaboración, los participantes están desarrollando constantemente habilidades interculturales al trabajar con compañeros de un país y cultura distinta, fortaleciendo su capacidad para comunicarse y colaborar en un entorno global. Esta experiencia también ha fomentado la autonomía y la autogestión, ya que los estudiantes son responsables de organizar sus reuniones, coordinándose de manera remota cumpliendo con los hitos del proyecto de forma autónoma, siendo los verdaderos protagonistas de este proceso.
La interacción constante con sus pares de México promueve el trabajo en equipo multidisciplinario, una habilidad crítica en el mundo actual, donde la resolución de problemas complejos requiere la integración de conocimientos de diversas áreas. Los estudiantes deben combinar sus respectivas disciplinas y experticias para diseñar soluciones que no solo sean técnicamente viables, sino también relevantes desde el
Observatorio Duoc UC / Anuario 2024 / página 238
Observatorio de la Educación Superior Técnico Profesional - Producción y gestión del conocimiento
punto de vista clínico y médico. Esta capacidad de trabajar en equipos diversos y funcionales fortalece sus competencias de resolución de problemas y pensamiento crítico, al enfrentarse a situaciones reales que requieren una evaluación profunda y soluciones innovadoras.

Estudiantes de ambas instituciones trabajando colaborativamente sobre el contexto del Proyecto COIL 2024-02.

Reunión de Equipo multidisciplinario e intercultural preparando sus presentaciones para la sesión sincrónica.
Observatorio Duoc UC / Anuario 2024 / página 239
Observatorio de la Educación Superior Técnico Profesional - Producción y gestión del conocimiento

Estudiantes llevando a cabo sus presentaciones en la segunda sesión sincrónica junto a sus compañeros de México.
En términos de habilidades interpersonales, esta colaboración ha impulsado a los estudiantes a desarrollar su capacidad de comunicarse eficazmente, tanto dentro de sus equipos locales como con sus compañeros de México, lo que ha sido fundamental en un contexto multicultural y multidisciplinario. El uso de herramientas digitales y la necesidad de mantener reuniones sincrónicas entre diferentes zonas horarias también estimula su capacidad de gestión del tiempo y organización. Cada una de estas competencias no solo los prepara para desafíos académicos, sino que también les ofrece una ventaja competitiva en el mundo laboral, donde las habilidades blandas y técnicas deben combinarse para lograr resultados efectivos y significativos.
Por otro lado, es importante destacar que este proyecto COIL 2024-02 tributa directamente a tres Objetivos de Desarrollo Sostenible (ODS):
ODS 3: Salud y Bienestar, mediante el desarrollo de soluciones que mejoren la calidad de vida de los pacientes.
ODS 9: Industria, Innovación e Infraestructura, al aplicar tecnología de vanguardia para resolver problemas complejos en el ámbito de la salud.
ODS 10: Reducción de las Desigualdades, al crear soluciones accesibles que impacten a poblaciones vulnerables y contribuyan a disminuir la brecha en el acceso a servicios de salud.
Respecto al enfoque pedagógico, esta colaboración se basa en la implementación de metodologías activas como son el Aprendizaje Basado en Proyectos, el Aprendizaje Basado en Problemas, el Aprendizaje Basado en Investigación, y el Aprendizaje Colaborativo Internacional. Todas estas estrategias y metodologías han permitido que los estudiantes adquieran un aprendizaje profundo y significativo, enfrentándose a desafíos reales que exigen una constante integración de conocimiento, innovación y colaboración. Cada
Observatorio Duoc UC / Anuario 2024 / página 240
Observatorio de la Educación Superior Técnico Profesional - Producción y gestión del conocimiento

Estudiantes presentando las funcionalidades de sus aplicaciones móviles, web e hibrida en la segunda sesión sincrónica junto a sus compañeros de México.
etapa del proyecto COIL ha sido diseñada para fomentar la adaptabilidad, la gestión de proyectos y el pensamiento innovador, habilidades esenciales para los futuros profesionales en el sector tanto tecnológico como de la salud.
Es en este mismo contexto donde los propios estudiantes han destacado desde el inicio de este proyecto la oportunidad que representa para ellos en términos de crecimiento profesional y personal, y cómo estas estrategias, metodologías y experiencia internacional les ha permitido adquirir una nueva perspectiva sobre su futuro rol en la industria, entregándoles mayores herramientas para desenvolverse exitosamente en el mundo laboral.
Testimonio

Andrés Martínez GPY6111- 04D
Bajo mi punto de vista, esta oportunidad ha sido una experiencia enriquecedora no solo en tener la oportunidad de trabajar con estudiantes de otro país, sino también en lo profesional, puesto que nos estamos enfrentando a una situación real, donde tenemos que atender problemáticas y necesidades reales dentro del campo de la medicina y salud. Esta oportunidad permite ver no solo las herramientas que se han adquirido a lo largo de estos años, sino que también es una oportunidad para adquirir nuevas herramientas, como el desplante en las sesiones, el profesionalismo vinculado a las habilidades blandas, y la documentación en cuanto a cada etapa de desarrollo.
Observatorio Duoc UC / Anuario 2024 / página 241
Observatorio de la Educación Superior Técnico Profesional - Producción y gestión del conocimiento
Testimonio
Renata Besoain GPY6111- 010D
Mi participación en la colaboración COIL 2024-02 ha sido una experiencia altamente satisfactoria. Ha sido una gran oportunidad para conocer y aprender sobre diferentes culturas internacionales.
Mi interacción con mis pares de México ha sido una experiencia muy gratificante principalmente por enriquecer mi aprendizaje y fomentar un ambiente respetuoso. Con esta experiencia he podido potenciar tanto mis habilidades personales como profesionales, preparándome mejor para un futuro en mi carrera profesional y vida laboral.

Testimonio

Tomás Torres GPY6111- 010D
Participar en COIL 2024-02 ha sido una oportunidad increíble para conocer a personas de México y trabajar en condiciones cercanas a la vida profesional. Aunque al principio sentí algo de incertidumbre, la experiencia ha sido muy enriquecedora. Las reuniones sincrónicas y el trabajo asincrónico han permitido una colaboración ágil y dinámica, trabajar con compañeros de otra área ha sido muy gratificante. Gracias a esto he podido mejorar mis habilidades de trabajo en equipo, liderazgo y fortalecí lazos con personas de diferentes disciplinas y culturas.
Observatorio Duoc UC / Anuario 2024 / página 242
Observatorio de la Educación Superior Técnico Profesional - Producción y gestión del conocimiento
Testimonio
Karyme Vargas GPY6111- 04D
Este semestre he tenido la oportunidad de Colaborar en COIL 2024-02, y debo decir que la experiencia con mis compañeros de Monterrey ha sido sumamente enriquecedora. Trabajamos en conjunto para crear una solución tecnológica, y estoy muy satisfecha con los resultados que logramos como equipo. Este proyecto no solo ha fortalecido nuestras habilidades, sino que también nos ha permitido desarrollar competencias multiculturales y multidisciplinares de manera autónoma, gracias a nuestras reuniones sincrónicas internacionales.

Participar en COIL 2024 nos ha brindado la oportunidad de trabajar en un proyecto más serio, donde pudimos aplicar nuestras habilidades y competencias profesionales. Además, adquirimos nuevas destrezas que sin duda serán valiosas para nuestro desarrollo personal y profesional en el futuro.
Para terminar, es importante mencionar el cómo se gestó esta instancia de colaboración tan importante y enriquecedora para nuestros estudiantes, bajo ese contexto señalar que esta colaboración COIL se hizo posible inicialmente gracias a la gestión del Subdirector de la Escuela de Informática y Telecomunicaciones, Oscar Araya, quien impulsó mi participación en la capacitación de la Metodología COIL 2024-02, lo cual destaco y agradezco enormemente. Puesto que posterior a esta capacitación, la Subdirección de Internacionalización e Integración Institucional, a través de Alejandro Molina, analista de desarrollo de carrera y movilidad, me invita a participar formalmente de esta colaboración, que hoy involucra a mis dos secciones de tercer año de la carrera de Ingeniería en Informática, específicamente de la asignatura Gestión de Proyectos Informáticos GPY6111, por lo que cada una de estas acciones permitieron concretar el desarrollo de esta colaboración COIL 2024-02.
También quiero destacar a los directores de carrera de la Escuela de Informática y Telecomunicaciones de mi Sede Viña del Mar, Alejandra Gajardo y Diego Fernández, quienes han sido parte de esta colaboración promoviendo, apoyando y entregando a disposición todo lo necesario (equipo técnico, recursos tecnológicos y audiovisual) para llevar a cabo las distintas jornadas sincrónicas con los estudiantes y profesores de México. Estando presentes incluso en la primera jornada sincrónica, lo cual fue un hito importante para nuestros estudiantes. Por lo que puedo decir que si bien como Docente a cargo de esta asignatura y secciones me corresponde Liderar todo este proceso de colaboración en cuanto al diseño de actividades,
Observatorio Duoc UC / Anuario 2024 / página 243
Observatorio de la Educación Superior Técnico Profesional - Producción y gestión del conocimiento

plan de colaboración, diseño de hoja de ruta y programación, y en sí toda la logística requerida junto a mis homólogos del Tecnológico de Monterrey, esta colaboración ha sido un trabajo conjunto entre distintos actores que han permitido que nuestros estudiantes sigan recibiendo siempre una formación integral que permita tributar a lo declarado en la asignatura en cuanto a los resultados de aprendizaje e indicadores de logro. Viéndose potenciados aún más por elementos y aspectos de evaluación y experiencias relacionadas a la internacionalización de este proyecto.

Observatorio de la Educación Superior Técnico Profesional - Producción y gestión del conocimiento
En conclusión, la colaboración COIL entre Duoc UC y el Tecnológico de Monterrey no solo ha sido un éxito académico en lo que se lleva de esta, sino un ejemplo claro de cómo la educación técnico profesional puede preparar a los estudiantes para los desafíos globales, fomentando tanto su desarrollo profesional como su crecimiento personal. El trabajo multidisciplinario, la autogestión y el enfoque en la resolución de problemas reales son aspectos fundamentales que esta colaboración ha potenciado, y que sin duda alguna seguirán marcando la diferencia en la formación de las futuras generaciones de estudiantes de la Escuela de Informática y Telecomunicaciones de Duoc UC que puedan participar de una instancia de colaboración tan significativa y enriquecedora como esta.

Observatorio Duoc UC / Anuario 2024 / página 245
Observatorio de la Educación Superior Técnico Profesional - Producción y gestión del conocimiento
Proyecto Cron app

El proyecto Cron app nace ante un aumento de enfermedades crónicas tales como la hipertensión y diabetes. En primera instancia el proyecto consistía en una aplicación web y actualmente se está trabajando en una aplicación móvil para que todos los usuarios tengan acceso.
¿En qué consiste realmente? Imagina una aplicación móvil diseñada para cuidar de la salud de pacientes hipertensos, diabéticos y también con un módulo especializado en salud femenina. Bienvenido a Cron app, tu nuevo compañero digital para el seguimiento y control de tus registros clínicos de manera fácil y efectiva.

Observatorio Duoc UC / Anuario 2024 / página 246
Observatorio de la Educación Superior Técnico Profesional - Producción y gestión del conocimiento
Con nuestra aplicación, los pacientes hipertensos y diabéticos pueden monitorear sus niveles de presión arterial, glucosa, medicamentos, síntomas y también ver de forma estadística sus registros; pero eso no es todo, estamos emocionados de presentar nuestro nuevo módulo dedicado a la salud de la mujer, ofreciendo herramientas específicas para el seguimiento de ciclos menstruales, control de medicamentos hormonales y recordatorios para exámenes ginecológicos, además de un foro y ayuda en caso de violencia.
¿Qué hace única a Cron app?
No solo te permite registrar y analizar tus datos de salud de manera personalizada, sino que también te ofrece:
- Una aplicación integral: Las funcionalidades y herramientas están pensadas en los pacientes y realizadas por un equipo multidisciplinario.
- Recordatorios inteligentes: Nunca olvides medir tus niveles de glicemia o presión arterial con nuestras notificaciones personalizadas.
- Informes estadísticos: Accede a análisis visuales de tus registros para entender tu progreso.
- Seguridad y Privacidad: Tu información personal de salud está protegida.
Nuestro objetivo es empoderarte en tu propio cuidado de salud, proporcionándote herramientas simples pero poderosas para tomar el control de tu salud.
La estudiante Jane Cáceres nos expresó que “Mi participación en el proyecto Cron app ha sido una experiencia enriquecedora tanto a nivel profesional como personal. El contacto directo con pacientes y profesionales de salud ha sido fundamental debido al aprendizaje y cercanía que me han entregado”.

Observatorio Duoc UC / Anuario 2024 / página 247
Observatorio de la Educación Superior Técnico Profesional - Producción y gestión del conocimiento
Continuó opinando: “He tenido la oportunidad de interactuar con pacientes agradecidos debido a que estamos impactando en sus vidas de forma positiva, lo cual es verdaderamente gratificante, debido a que las patologías crónicas no son fáciles de sobrellevar y se necesita mucho apoyo”.
“En términos de mi desarrollo profesional, esta experiencia me ha permitido iniciar un proyecto desde cero, aprendiendo a gestionarlo, liderarlo y supervisarlo. Además, he adquirido habilidades en el ámbito de la salud digital, explorando nuevas herramientas y tecnologías que están transformando el sector de salud”.
“Esta experiencia me ha impulsado a considerar nuevas perspectivas y enfoques en mi carrera, inspirándome a seguir trabajando en proyectos que tengan un impacto significativo en la salud y el bienestar de las personas. Estoy entusiasmada por seguir aprendiendo y contribuyendo en este campo de constante evolución”.
Para nosotros estas opiniones son muy valiosas. Saber que estamos aportando y que los estudiantes logran nuevos y mejores aprendizajes.

Mi experiencia liderando el proyecto Cron App, una plataforma tecnológica enfocada en la trazabilidad y autogestión en pacientes crónicos diabéticos e hipertensos ha sido verdaderamente transformadora para mi carrera como docente. Este proyecto no solo me ha brindado la oportunidad de aplicar mis conocimientos teóricos en un entorno práctico y significativo, sino que también ha ampliado mi comprensión de la importancia de la investigación aplicada, la innovación y la transferencia tecnológica en la Educación Superior Técnico Profesional.
En primer lugar, liderar este proyecto me ha permitido integrar la teoría con la práctica de una manera que beneficia directamente a la comunidad. Al trabajar en estrecha colaboración con profesionales de la salud,
Observatorio Duoc UC / Anuario 2024 / página 248
Observatorio de la Educación Superior Técnico Profesional - Producción y gestión del conocimiento
investigadores y desarrolladores de tecnología, he podido ver cómo los conceptos académicos se traducen en soluciones tangibles que mejoran la calidad de vida de los pacientes crónicos. Esta experiencia ha reforzado mi convicción de que la investigación aplicada y la innovación son componentes esenciales de una educación de calidad, especialmente en el contexto de la Educación Técnico Profesional, donde la relevancia práctica es fundamental.
Además, este proyecto ha destacado la importancia de la transferencia tecnológica en la Educación Superior Técnico Profesional. Al colaborar con empresas e instituciones externas, hemos podido aprovechar su experiencia y recursos para desarrollar e implementar soluciones tecnológicas avanzadas. Esta colaboración no solo enriquece el proceso educativo al proporcionar a los estudiantes acceso a tecnologías de vanguardia, sino que también prepara a los graduados para enfrentar los desafíos del mundo laboral moderno, donde la capacidad de adaptarse a nuevas tecnologías es fundamental.

En resumen, mi experiencia liderando este proyecto ha fortalecido mi compromiso con la investigación aplicada, la innovación y la transferencia tecnológica en la Educación Superior Técnico Profesional. Creo firmemente que, al integrar estos elementos en nuestro enfoque educativo, podemos preparar a los estudiantes para ser líderes y agentes de cambio en sus campos respectivos, equipándolos con las habilidades y el conocimiento necesarios para abordar los desafíos del mundo real de manera efectiva y significativa.
Esta columna fue publicada el 17 de junio de 2024
Observatorio Duoc UC / Anuario 2024 / página 249
Observatorio de la Educación Superior Técnico Profesional - Producción y gestión del conocimiento
Proyecto Piloto, Revista Ciencia
Aplicada y Educación Duoc UC (CAED)
Katia Isamitt García

Subdirectora Académica de la sede Alameda de Duoc UC.
Hace cinco años, en la sede Alameda de Duoc UC, nació una inspiradora idea: la creación de un equipo de docentes investigadores comprometidos con el desarrollo de la innovación y el trabajo más allá del aula. Esta visión pionera fue encabezada por Margarita Zamora, docente de las carreras de Prevención de Riesgos y Lorena Pizarro, jefa de Biblioteca.
En un principio tuvimos la iniciativa de organizar talleres destinados a capacitar a los docentes en la generación de proyectos de investigación aplicada, con la finalidad de apoyarlos en sus ideas y poder concretarlas.
En el transcurso de estos años, esta comunidad de docentes se ha ido consolidando, no solo para trabajar en el área de investigación, si no también relacionando los proyectos con vinculación con el medio, con innovación, tecnología y sostenibilidad. Lo que comenzó como una semilla de cambio se ha convertido en un tejido cultural arraigado, con proyectos que se han concretado como hitos anuales de nuestra Sede. Este progreso ha sido posible gracias a la integración de elementos claves como la investigación, la innovación y la tecnología en la ejecución de estos proyectos.
El año pasado, la Dirección de Investigación Aplicada e Innovación de Duoc UC, lanzó un concurso de innovación corporativa, brindando una oportunidad para nuestro equipo, de realizar un proyecto piloto para nuestra comunidad de docentes investigadores de Duoc UC. Aprovechando este impulso, se gestó la idea de crear un espacio dedicado a la publicación de investigaciones por parte de docentes, fomentando así el desarrollo de habilidades para la redacción de artículos científicos. Esta iniciativa respondió a una necesidad detectada en la institución, que reconoce a la Investigación Aplicada como uno de sus pilares fundamentales y hoy de alta importancia para una próxima acreditación Institucional.
Observatorio Duoc UC / Anuario 2024 / página 250
Observatorio de la Educación Superior Técnico Profesional - Producción y gestión del conocimiento
Es así como en diciembre de 2023 nace la Revista Ciencia Aplicada y Educación Duoc UC (CAED), un espacio que acoge y promueve la producción científica de la comunidad de docentes de la sede Alameda. Esta revista, comprometida con la transparencia y el acceso abierto, ofrece a sus lectores la posibilidad de explorar libremente su contenido, bajo la licencia Creative Commons CC BY-NC-ND, los artículos publicados pueden ser copiados y distribuidos siempre y cuando se respeten las condiciones establecidas, garantizando así la difusión y el intercambio del conocimiento generado.
El comité editorial de nuestra revista está conformado por un equipo dedicado que ha sido fundamental en el impulso del tema de investigación e innovación en nuestra Sede. Cada miembro desempeña un rol específico en el funcionamiento de la revista, asegurando su calidad y excelencia.
Lorena Pizarro, nuestra Bibliotecaria Documentalista y Jefa de Biblioteca en Duoc UC sede Alameda, forma parte del equipo de Redacción y Edición. Su experiencia y dedicación garantizan una gestión eficiente de los contenidos de la revista.
Margarita Zamora, integrante también del equipo de Redacción y Edición, es Ingeniera Ambiental, Licenciada en Ingeniería Aplicada y PhD en Higiene Industrial y Ambiental. Su trayectoria como experta en Prevención de Riesgos y Salud Ocupacional respalda su rol como investigadora en áreas de interés como la salud ocupacional y la toxicología ambiental.
Katia Isamitt, Directora de la revista, Publicista, Comunicación Social, Máster en Comunicación Estratégica Corporativa. Subdirectora Académica en la sede Alameda, con el rol de aportar una visión integral y estratégica al equipo editorial.
CAED se posiciona como una plataforma que acoge diversos tipos de artículos, desde investigaciones originales hasta cartas a la directora. Estos trabajos son sometidos a un riguroso proceso de evaluación, que comprende desde la revisión inicial por parte del Equipo Editorial hasta la evaluación por pares externos bajo un modelo de revisión doble ciego. Esta metodología garantiza la calidad y el rigor de los contenidos publicados, promoviendo estándares internacionales de excelencia académica. El camino hacia la publicación en CAED no fue fácil, pero fue crucial el compromiso compartido de apoyo y colaboración entre los docentes, el equipo del proyecto y de la Dirección de Investigación Aplicada e Innovación. Desde la organización de talleres de escritura científica hasta la convocatoria del primer concurso para publicar artículos científicos, donde se buscó empoderar a los docentes en el proceso de generación y difusión del conocimiento.
Para la elaboración del primer volumen de nuestra revista, seleccionamos cuatro artículos que abordan una amplia gama de temas. En primer lugar, presentamos el artículo titulado ‘Análisis de la reprobación en asignaturas transversales en un programa de educación técnica superior’, redactado por los docentes Rubén Cruz Farías, Bryan Larenas Ramírez e Isabel Melo Carte.
Seguidamente, encontramos el artículo ‘Uso sustentable de aguas grises en el edificio de nuestra sede Alameda de Duoc UC’, elaborado por los profesores Víctor Muñoz Flores y Elizabeth Natividad Saenz Chavez.
El tercer artículo, fruto del esfuerzo de un estudiante y un colaborador, nos presenta un innovador ‘Sistema guía para personas ciegas en espacios de uso público’, escrito por Oscar Jiménez González y Matías Bello Vargas.
Observatorio Duoc UC / Anuario 2024 / página 251
Observatorio de la Educación Superior Técnico Profesional - Producción y gestión del conocimiento
Finalmente, cerramos este primer volumen con una interesante ‘Carta a la directora’ titulada ‘Incendios forestales y organización comunitaria’, escrita por el docente Cristian Rodríguez.
Cada uno de estos artículos ofrece una valiosa contribución al conocimiento y la reflexión en sus respectivos campos, reflejando el compromiso y la excelencia de nuestra comunidad académica. Estamos emocionados de compartir estos trabajos con ustedes y esperamos que inspiren a nuevas investigaciones y debates en nuestra comunidad educativa.
El lanzamiento de CAED representa un inicio en el camino hacia la transformación educativa de Duoc UC. Más allá de ser una revista académica, es un testimonio del compromiso de la institución con la excelencia y la innovación en la educación superior. A través de esta plataforma, se abre un espacio para la colaboración interdisciplinaria, el intercambio de ideas y la construcción de comunidades de aprendizaje. La revista permitirá ejercitar la escritura científica de nuestros docentes, publicar artículos en las áreas de interés de Duoc UC y que dichos artículos estarán abiertos al resto de la comunidad académica para aportar con nuevas miradas
El sueño compartido por la comunidad de docentes investigadores y el área de Investigación Aplicada e Innovación de Duoc UC es que CAED sirva como catalizador para el crecimiento y la expansión de esta comunidad. Se espera que más docentes se sumen a esta iniciativa, contribuyendo así a la construcción de un ecosistema de investigación vibrante y dinámico, tanto dentro de la institución como a nivel global. Uno de los principales desafíos que enfrentamos en el año 2024 es la participación de nuevos docentes interesados en la redacción de artículos científicos, tanto en nuestra Sede como en toda la institución. Para abordar este objetivo, estamos trabajando estrechamente en colaboración con la Dirección de Investigación e Innovación de Duoc UC. Nuestra meta para este año es la publicación de dos volúmenes de la revista, cada uno conteniendo al menos seis artículos científicos de alta calidad.
Extendemos una cordial invitación a todos a explorar nuestra revista, a sumergirse en la lectura de los artículos ya publicados y a considerar la posibilidad de participar en este emocionante desafío. Este es un llamado abierto a todos los docentes que deseen contribuir al avance del conocimiento y a la excelencia académica. ¡Esperamos contar con su participación y colaboración en este apasionante aporte!
Visítanos en: www.caed.cl
Esta columna de opinión fue publicada el 11 de marzo de 2024
Observatorio Duoc UC / Anuario 2024 / página 252
Observatorio de la Educación Superior Técnico Profesional - Producción y gestión del conocimiento
Reducción de la Brecha de Género en STEAM:
Experiencias y resultados del proyecto Inclusteam

El Proyecto Inclusteam, Talleres STEAM enriqueciendo las experiencias tecnológicas, socio emocionales para niños, niñas y jóvenes en escuelas chilenas, surge de la postulación a un proyecto de Investigación Aplicada. Es liderado por tres docentes de tres escuelas diferentes, Cristhian Beltrán (Escuela Ingeniería), Ana Quiero (Escuela Construcción), y por mí, Andrea Zambrano M. (Escuela Informática & Telecomunicaciones). El proyecto se llevó a cabo para abordar la persistente brecha de género, donde las mujeres son minoría. Al iniciar los talleres, se estableció el requerimiento de contar con participantes equitativos de ambos géneros.

Observatorio Duoc UC / Anuario 2024 / página 253
Observatorio de la Educación Superior Técnico Profesional - Producción y gestión del conocimiento
Estas actividades se desarrollaron en las instalaciones de Duoc UC de la sede San Andrés de Concepción, durante el año 2023, con el objetivo de enriquecer las experiencias tecnológicas y socioemocionales de los estudiantes. Los talleres fueron dirigidos por las Escuelas de Informática & Telecomunicaciones, con la participación externa del Colegio Marcela Paz y la empresa de psicólogos MITS (Música inclusión tecnología y sustentabilidad), respaldados por las instalaciones del CITT (Centro de Innovación y Transferencia Tecnológica). Inclusteam busca impactar de manera positiva en los jóvenes, motivándolos y fortaleciendo sus intereses como futuros profesionales. A través de actividades teóricas y prácticas, nuestro interés es que se oriente a los estudiantes en las áreas STEAM (ciencia, tecnología, ingeniería, arte y matemáticas), fomentando el desarrollo de sus habilidades e intereses de forma divertida y creativa.
En específico, el proyecto consiste en talleres modulares con niveles de dificultad progresiva, siguiendo las metodologías STEAM y Espiral, e incorporando contenidos innovadores y no convencionales del currículum nacional, como robótica, programación en Scratch, pensamiento lógico e impresión y modelado 3D, áreas de gran interés para los jóvenes de hoy en día.
Desarrollo del proyecto
La duración del proyecto fue de un año académico, y se desarrolló como un ACLE para el “Colegio Marcela Paz”, en el que intervenimos a estudiantes de enseñanza básica. El compromiso y la pasión de los estudiantes por aprender y participar en el proyecto fue realmente inspirador. Ver cómo llegaban cada viernes al Duoc UC tan emocionados y motivados nos recordaba por qué comenzamos con este proyecto. Fue gratificante ver cómo se mantenían entusiasmados a lo largo de los meses, demostrando su interés y dedicación por aprender y crecer. Este tipo de experiencias nos recuerdan el impacto social y positivo que podemos tener en la vida de los demás a través de la educación.

Observatorio Duoc UC / Anuario 2024 / página 254
Observatorio de la Educación Superior Técnico Profesional - Producción y gestión del conocimiento
Testimonio estudiante
En esta ocasión la estudiante Constanza Pávez, perteneciente a la Carrera de Ingeniería en Informática, nos comenta su experiencia como tutora:
"En mi formación, he adquirido conocimientos y habilidades blandas que no se enseñan en mi carrera, lo cual me ha ayudado, especialmente en el trabajo en equipo. Aprendí a trabajar con niños y a desenvolverme en entornos poco habituales, lo cual es muy útil para estar preparado ante cualquier problema en los talleres. Participaría nuevamente ya que cada actividad aporta nuevas experiencias. Trabajar en equipo me ha enseñado a escuchar, comunicarme de manera más efectiva y a resolver problemas en conjuntos. Además, el proyecto me permitió aplicar lo aprendido en situaciones reales. Participar en Inclusteam ha sido una experiencia enriquecedora tanto a nivel académico como personal. Estoy agradecida por formar parte de este proyecto inspirador”.
Opinión del investigador
El ser parte de la cara visible de este equipo de proyecto como investigador principal ha sido un gran desafío, ya que es nuevo e interesante el poder impactar a niños, niñas y jóvenes con experiencias significativas y novedosas, alejadas de sus actividades cotidianas, para despertar interés en las áreas STEAM. Todo el equipo recibió capacitación para trabajar con los menores, que cursaban sexto, séptimo y octavo básico. El proyecto es muy enriquecedor para los estudiantes, quienes aprendieron contenidos no tradicionales del currículum nacional como robótica, programación, pensamiento lógico e impresión y modelado 3D, temáticas que sin duda son de mucho interés para nuestra juventud. Esta experiencia los llevó a descubrir nuevas habilidades en ellos. Fue realmente gratificante ver cómo los niños y jóvenes se involucraban con entusiasmo en las actividades STEAM que les presentábamos.

Observatorio Duoc UC / Anuario 2024 / página 255
Observatorio de la Educación Superior Técnico Profesional - Producción y gestión del conocimiento

Su curiosidad y creatividad nos inspiraban a seguir adelante, adaptándonos constantemente para ofrecerles experiencias cada vez más enriquecedoras y estimulantes. Ver cómo descubrían nuevas habilidades, se enfrentaban a desafíos y desarrollaban su pensamiento lógico, como se les hacía fácil desarrollar las actividades y desafíos que les planteábamos nos recordaba por qué este proyecto era tan importante.
Confiamos en que sembramos una semilla de interés en la tecnología y la innovación en cada uno, y eso nos llena de orgullo y nos impulsa a trabajar por una educación más inclusiva y dinámica para las futuras generaciones. Este año 2024 continuamos con el desarrollo de Inclusteam, gracias a la adjudicación del proyecto en el marco de la convocatoria Escalamiento y Transferencia 2024 de la Dirección de Investigación Aplicada, Innovación y Transferencia.
Opinión de empresa del entorno
Daniel Uribe, docente a cargo del Acle en la corporación Educacional Marcela Paz, nos comenta: “Ha sido una experiencia muy enriquecedora, tanto para los alumnos, alumnas y para los docentes, dado que ambos han podido desarrollar nuevas habilidades de trabajo en equipo, fortalecer mediante las actividades realizadas la tolerancia la frustración, trabajar en mini proyectos reales y concretos donde se aplica STEAM, por lo tanto, se desarrollan conocimientos, actitudes, habilidades para poner en práctica las ciencias, tecnología, artes, matemáticas, lo que se ha traducido en la integración de conocimientos que aportar al perfil de nuestros estudiantes. Por otra parte, a todos les ha gustado la experiencia de ir a la sede San Andrés de Duoc UC en Concepción, donde pueden conocer la alta calidad de las instalaciones, ver el CITT (Centro de Innovación y Transferencia Tecnológica), donde han podido interactuar con drones, circuitos eléctricos, impresoras 3d, programación. Hay también un aspecto relevante que es la vinculación de los apoderados a conocer estos temas en la ceremonia de entrega de reconocimientos”.
Esta columna fue publicada el 27 de mayo de 2024
Observatorio Duoc UC / Anuario 2024 / página 256
Observatorio de la Educación Superior Técnico Profesional - Producción y gestión del conocimiento
Tecnología y Medio Ambiente:
Desarrollando Soluciones Sustentables para el Reciclaje de Plásticos en la Región del Biobío

Maquiplast nace desde la necesidad de buscar alternativas sostenibles para la reutilización del plástico de desecho que se desecha en la basura domiciliaria o industrial. El año 2022, junto a un equipo conformado por estudiantes y docentes, postulamos a la línea de Proyectos de Desarrollo Experimental de la DIAIT, donde buscábamos fabricar y desarrollar prototipos de máquinas que permitieran procesar desechos plásticos aumentando la capacidad de procesamiento de estos materiales en la Región del Biobío y luego reutilizar el material procesado para dar un segundo uso al plástico.

Observatorio Duoc UC / Anuario 2024 / página 257
Observatorio de la Educación Superior Técnico Profesional - Producción y gestión del conocimiento
A nivel de investigación trabajamos en el desarrollo de nuevos productos y formatos de materiales de construcción, para también ser capaces de determinar cuál es podría ser el impacto real de la tecnología en el procesamiento de plásticos en la región como parte de una solución global al procesamiento de plásticos.
Luego, el 2023 postulamos y adjudicamos en el llamado de la Línea de Escalamiento de Investigación aplicada, instancia en la cual apostamos con el equipo de Maquiplast a la búsqueda de transformación y valoración del Pellet plástico, orientado a la construcción mediante la reutilización del plástico en materiales de construcción, donde estudiamos las posibilidades del procesamiento de plástico con esta tecnología y con ello determinar la viabilidad de crear nuevos productos de construcción a partir del plástico reciclado.
En transferencia tecnológica se espera capacitar a establecimientos educativos de la región, en temas de reciclaje eficiente para vincular y educar a las nuevas generaciones en materias de sostenibilidad medioambiental, y divulgar los resultados obtenidos en revistas científicas asociadas al medio ambiente y sustentabilidad.
Por último, hay que mencionar que existe un interés creciente desde Municipalidades, instituciones de educación y pymes de gestión de residuos industriales que se encuentran trabajando en la temática de la reutilización del plástico.

Observatorio Duoc UC / Anuario 2024 / página 258
Observatorio de la Educación Superior Técnico Profesional - Producción y gestión del conocimiento
Desde el punto de vista de organización del equipo de trabajo, este se conformó con estudiantes de diversas carreras de nuestra institución: desde las escuelas de Ingeniería, Publicidad, Diseño Industrial, Construcción, entre otras, quienes acompañados de docentes logramos organizar equipos inherentes a sus disciplinas, desde donde desarrollamos un gran proyecto mancomunado.
Para abordar la investigación, primeramente, en las etapas de postulación trabajamos en la determinación de la necesidad u oportunidad detectada, luego en plantear la justificación, el estado del arte, nuestras hipótesis, objetivos generales y objetivos específicos. Desde lo operativo, en una reunión general nos reunimos quincenalmente a revisar los avances, propuestas nuevas, ensayos de campo que nos permitieron avanzar y dar consistencia al proyecto. Elaboramos calendarios, metas y objetivos alcanzables al corto, mediano y largo plazo contrastados con una calendarización propuesta desde la que evaluábamos los avances del proyecto.
También nos reuníamos en micro actividades/reuniones separadas por disciplina y nos juntábamos 2 a 3 veces a la semana, donde realizábamos avances de diversas índoles.
Desde el desarrollo y la confección del prototipo, realizamos un estudio de maquinaria existente en el mercado global para replicar y mejorar rendimiento y eficiencia. Se organizó la confección de planos, la planificación de compras, planificación de levantamiento de riesgos de actividades y protocolos de seguridad para trabajos, planificación detallada de actividades de equipos por especialidades mediante Gantt, junto con el análisis de resultados.
A lo anterior se suma la definición de las variables de proceso tales como la producción que era capaz de desarrollar los prototipos, sus tiempos de trabajo y eficiencias, entre otros.

Observatorio Duoc UC / Anuario 2024 / página 259
Observatorio de la Educación Superior Técnico Profesional - Producción y gestión del conocimiento

El trabajo desarrollado hacia el exterior también se logró hacer partícipe de las actividades con en el proyecto Maquiplast, y es así como se realizaron charlas educativas de concientización y educación medioambiental para estudiantes de instituciones de educación desde una edad temprana, sobre la correcta separación de residuos y el reciclaje del plástico efectivo y eficiente. Así, se sentaría una base sólida para un futuro más sostenible que comenzaría en el colegio, y, eventualmente, se extendería hasta los hogares de cada estudiante.
En último lugar, la colaboración entre Duoc UC y empresas asociadas al ámbito de la construcción es el último eje por considerar. Se busca contribuir a la economía circular de la región a través de la creación de pellets o ladrillos en base a plástico reciclado. Tomando como referencia el exitoso modelo de Ecoladrillos Conce, se reconoce que el plástico PET posee diversas características que lo hacen idóneo para aportar en esta industria.
Testimonio de un estudiante participante en el proyecto
Camila Huaiqueo Torres, nos señaló: “Desde un punto de vista personal me hace muy feliz ser parte de este proceso ya que en mi familia siempre tratamos en lo posible de ayudar al planeta. El disminuir la cantidad de plástico que uno utiliza en la vida diaria y reutilizarlos es el primer paso, pero con este proyecto finalmente estará al alcance de muchos estudiantes como yo el dar el siguiente paso que es el poder reciclar y darle un nuevo uso a este material. Desde un punto de vista disciplinar, como estudiante de publicidad
Observatorio Duoc UC / Anuario 2024 / página 260
Observatorio de la Educación Superior Técnico Profesional - Producción y gestión del conocimiento
puedo decir que este es mi primer acercamiento a lo que es trabajar con un cliente real. He puesto en práctica lo que he aprendido en mis estudios respecto a la creación de marca (Logo, personalidad de la marca, diseño de uniforme, entre otras cosas). También he puesto en práctica mis habilidades de dibujo. El ver como este proyecto avanza me hace sentir optimista sobre el futuro. Este proyecto ayudará a la sustentabilidad y abrirá paso a otros proyectos que puedan salvar el planeta juntos”.
Conclusiones
El proyecto Maquiplast de investigación aplicada e Innovación desarrollado en DUOC UC por el equipo multidisciplinario de docentes y estudiantes nos invitó a conocer, comprender, comprometernos e instalarnos en una línea de trabajo que nos permite incorporar a nuestro desarrollo docente nuevas y preciadas oportunidades de aprendizaje y crecimiento laboral.
El proyecto Maquiplast ha aportado a mi experiencia laboral en diversas áreas tales como:
- Trabajo con diversas disciplinas o profesiones tanto con docentes como con estudiantes, donde me ha permitido un aprendizaje técnico y de funcionamiento y aporte desde otras áreas a las temáticas investigadas.
- La vinculación con el medio, elemento fundamental para poder extender o expandir la información y el aprendizaje a partir de este tipo de proyectos de investigación aplicada hacia la comunidad externa a nuestra institución, tales como municipios, instituciones de educación particular y pública, de básica media y educación superior, juntas de vecinos, etc.
- La preocupación por el medio ambiente, donde hemos direccionado y liderado proyectos que tengan como foco el cuidado del medio ambiente o a lo menos aportar con un grano de arena desde nuestras trincheras a que esta temática tenga la atención y preponderancia que merece y, finalmente, aportar a la búsqueda de alternativas de desarrollo de tecnologías que permitan insertar ideas de nuevos productos o equipos en el ecosistema industrial o en otras posibles instancias.
Resumiendo, participar de Proyectos de Investigación Aplicada e Innovación me ha permitido elevar estándares en y para la investigación e innovación de productos que pueden y propenden a ser utilizados por la población, siendo un aporte o intentando aportar a la sociedad tanto desde lo tecnológico e innovador como desde la enseñanza de diversas materias al entorno social vecino y a las nuevas generaciones de niñas, niños y jóvenes de nuestro país.
Esta columna fue publicada el 3 de junio de 2024
Observatorio Duoc UC / Anuario 2024 / página 261
Observatorio de la Educación Superior Técnico Profesional - Producción y gestión del conocimiento
Vivienda CLT-R: un proyecto de
investigación aplicada basado en la innovación y la colaboración

Actualmente el déficit habitacional es un problema global, motivado por diversos factores como el crecimiento demográfico, la migración y los altos costos de construcción. En Latinoamérica, incluido Chile, este problema es especialmente acentuado en comparación con los países desarrollados. Según datos de la encuesta Casen 2022, se estima que se necesitan 935,000 nuevas viviendas en Chile para abordar este déficit, lo que muestra un incremento del 13% desde 2017.

Observatorio Duoc UC / Anuario 2024 / página 262
Observatorio de la Educación Superior Técnico Profesional - Producción y gestión del conocimiento
Ante este contexto, el Estado chileno ha implementado el Plan de Emergencia Habitacional (PEH), que incluye la promoción de tecnología e innovación a través de asociaciones público-privadas. En este marco, se fomenta el uso de viviendas industrializadas como una alternativa para agilizar los plazos de construcción, impulsar la innovación y la competencia local, elevar los estándares de calidad y reducir la generación de residuos.
En el ámbito de la producción forestal en Chile, se ha observado un declive desde 2012, con una reducción del 22.63% en las plantaciones de pino radiata. Las viviendas industrializadas representan una oportunidad para revitalizar esta industria y establecer colaboraciones estratégicas. Nuestro objetivo es posicionar el proyecto Vivienda CLT-R como una opción innovadora y factible de fabricar por pequeñas y medianas empresas madereras. Basada en paneles CLT reforzados con fibras, esta propuesta ofrece ventajas en resistencia térmica y mecánica. A través de esta columna, destacaremos los principales hitos del proyecto de investigación aplicada de la vivienda CLT-R y cómo buscamos destacar los beneficios de esta opción y promover su adopción como parte de las soluciones a este importante desafío nacional.

Observatorio Duoc UC / Anuario 2024 / página 263
Observatorio de la Educación Superior Técnico Profesional - Producción y gestión del conocimiento
La iniciativa comenzó en el 2021, como respuesta a la convocatoria de la Dirección de Investigación Aplicada, Innovación y Transferencia (DIAIT), que planteaba el desafío de “Optimización de recursos y eficiencia energética en cualquier proceso de construcción o habitabilidad de una estructura”. En colaboración con la empresa maderera Arnoldo Opazo y Cía. Ltda., y con el respaldo de la Escuela de Construcción y la sede San Bernardo, se buscaba inicialmente añadir valor al pino radiata mediante la creación y producción de paneles CLT.
En los últimos años, el enfoque del proyecto se ha ampliado hacia el desarrollo de un sistema constructivo para viviendas industrializadas con énfasis en la eficiencia energética. En la actualidad, estamos trabajando en un paquete de transferencia tecnológica que abarca la elaboración de proyectos de arquitectura y estructura utilizando metodología BIM, la caracterización y cubicación de elementos constructivos, así como la implementación de metodologías de fabricación, transporte y ensamblaje del sistema constructivo.

Uno de nuestros hitos más destacados fue la adjudicación en el 2023 de la convocatoria CORFO SÚMATE A INNOVAR CON IP Y CFT, donde desarrollamos el primer paquete de transferencia y culminamos con la construcción de un módulo 1:1 por parte de Maderas Arnoldo Opazo. En este proceso contamos con el apoyo de Roberto Toledo especialista de vínculo con la industria de la DIAIT. Este año continuaremos buscando financiamiento externo para avanzar hacia la construcción de un prototipo de vivienda funcional y habitable.
En el proyecto han participado o están participando 15 estudiantes de las carreras de Dibujo y Modelamiento Arquitectónico y Estructural, Técnicos e Ingenieros en Construcción. Sus tareas incluyen modelación BIM, estudios de campo, informes técnicos y registro de ensayos de laboratorio. Además, Cristóbal Medina Ayala, exalumno participante en el primer año, fue galardonado con el reconocimiento
Observatorio Duoc UC / Anuario 2024 / página 264
Observatorio de la Educación Superior Técnico Profesional - Producción y gestión del conocimiento
“Inspiradores 2024” en la categoría de innovación. Por otro lado, los docentes Javier Carrasco, Sebastián Carriel y Manuel Palma han sido figuras clave en la elaboración del sistema constructivo y han participado activamente en el proyecto durante los últimos años.
Asimismo, es muy importante mencionar el apoyo brindado por el director de carrera, Ignacio Miranda, quien ha promovido la visibilidad del proyecto mediante iniciativas de difusión, como nuestra reciente participación en el Congreso de Innovación en Desafíos Públicos 2024, celebrado en el Centro de Extensión UC. Ayelén Cruz, estudiante de Ingeniería en Construcción, destaca el impacto significativo que ha tenido su participación en este proyecto en diversos aspectos, tanto en su desarrollo académico como personal.
Durante el transcurso del proyecto, gracias a la elaboración de informes y las visitas técnicas, ha mejorado considerablemente su habilidad para redactar de manera efectiva y analizar procesos constructivos. En ese sentido, ha adquirido una mayor atención al detalle y una gestión más eficiente del tiempo.
Esta experiencia también le ha enseñado la importancia de la paciencia al comprender que un proyecto como este no se construye de la noche a la mañana, ya que requiere años de investigación por parte de profesores y compañeros. Aunque en ocasiones el entusiasmo puede generar el deseo de obtener resultados rápidos, Ayelén ha aprendido que una planificación meticulosa es esencial.
Además, valora esta vivencia por los recuerdos compartidos con compañeros y profesores, reconociendo la importancia del trabajo en equipo y la satisfacción que trae consigo, al comprender lo fácil y gratificante que puede ser el proceso cuando se trabaja de manera colaborativa.
Liderar este proyecto ha sido una experiencia enriquecedora y gratificante para mí como docente. Más allá de la satisfacción personal de contribuir al desarrollo académico y profesional de mis estudiantes, este proyecto ha sido una oportunidad invaluable para aplicar los conocimientos teóricos en un contexto práctico y relevante para la sociedad.

Observatorio Duoc UC / Anuario 2024 / página 265
Observatorio de la Educación Superior Técnico Profesional - Producción y gestión del conocimiento
Agradezco profundamente a la DIAIT por su apoyo continuo y su compromiso con vivienda CLT-R. Su respaldo ha sido fundamental para el desarrollo y éxito de esta iniciativa, permitiéndonos desarrollar un proyecto que ha forjado lazos sólidos con la industria y ha tenido un impacto positivo en la formación de nuestros estudiantes.
Participar en investigación aplicada, innovación y transferencia tecnológica es esencial para la Educación Superior Técnico Profesional. No solo permite que los estudiantes adquieran habilidades y competencias prácticas altamente demandadas en el mercado laboral, sino que también fomenta el espíritu de colaboración, creatividad y resolución de problemas, aspectos esenciales para su desarrollo integral como profesionales del futuro.
Además, este tipo de proyectos nos permite establecer vínculos estrechos con la industria, lo que enriquece la formación académica al alinearla con las necesidades y demandas del sector productivo. Asimismo, contribuye al desarrollo económico y social del país al impulsar la innovación y la adopción de tecnologías más eficientes y sostenibles en la construcción y otras áreas relevantes.
En resumen, la investigación aplicada y la transferencia tecnológica son pilares fundamentales para la educación superior técnico profesional, fortaleciendo la formación de los estudiantes y promoviendo el desarrollo económico y social del país.
Por último, Martín Opazo, Gerente de Maderas Arnoldo Opazo y Cía. Ltda, resalta que ha sido una experiencia increíblemente enriquecedora desde el punto de vista profesional y también humano. Considera que las iniciativas de investigación aplicada ofrecen la oportunidad de compartir y desarrollar ideas en colaboración con instituciones de educación superior, esto resulta fundamental para el crecimiento y la innovación en las pequeñas y medianas empresas (pymes). La colaboración y el intercambio de conocimientos nos permiten enfrentar los desafíos del futuro con confianza y creatividad. En un mundo cada vez más conectado, la sinergia entre pymes y academia es crucial para su éxito continuo. Así que sigamos fomentando esta cultura de colaboración y aprendizaje mutuo, porque juntos somos más fuertes.
Esta columna fue publicada el 27 de mayo de 2024
Observatorio Duoc UC / Anuario 2024 / página 266
Observatorio de la Educación Superior Técnico Profesional - Producción y gestión del conocimiento
Digital en Educación Transformación
Observatorio Duoc UC / Anuario 2024 / página 267
Observatorio de la Educación Superior Técnico Profesional - Producción y gestión del conocimiento
Adopción digital permanente:
Más allá del cambio y la obsolescencia tecnológica

Alejandra Salinas Flores Especialista en Adopción Digital
A partir de las nuevas exigencias que ha impulsado la aceleración tecnológica de los últimos años, como consecuencia en gran medida por la pandemia COVID-19, junto al advenimiento de la llamada cuarta revolución industrial, se ha desafiado a diversos sistemas e instituciones a experimentar múltiples transformaciones (culturales, sociales, políticas, tecnológicas, etc.) tanto organizacionales como individuales. Si a esto le sumamos la complejidad de nuestro entorno, que post guerra fría se caracterizaba con el acrónimo en inglés VUCA (volátil, incierto, complejo y ambiguo), y que ahora ha sido actualizado por el concepto BANI (por los términos en inglés: B de frágil, A de ansiedad, N de no lineal e I de incomprensible) que define una realidad de caos y confusión, quebradiza e inestable, entonces nos resulta imperativo desarrollar sistemas resilientes y potenciar nuestra capacidad de adaptación a través del upskilling (mejorar las habilidades ya existentes) y reskilling (adquirir nuevas habilidades).
Ahora bien, resulta lógico pensar que todos estos cambios se realizan principalmente desde la tecnología, como principal motor de aceleración. No obstante, se visibiliza que en el futuro, más allá del impacto que pueda tener la inteligencia artificial, el foco estará puesto en las personas y el desarrollo de sus capacidades; y es aquí cuando resultará fundamental movilizar dicha evolución a través de la adopción digital permanente.
Bajo esta premisa, es importante comprender que cuando hablamos de adopción digital, se cruzan las fronteras tecnológicas y transitamos además por transformaciones culturales y organizacionales, complejizando así la mirada sistémica en torno a las estrategias de las cuales podríamos disponer al momento de gestionar un proceso de cambio. La aproximación a la concepción del cambio como un fenómeno transformacional y continuo, ha permitido el desarrollo de distintas metodologías para gestionar el cambio: el modelo fundacional de cambio organizacional de Kurt Lewin (1947) de sus tres fases Descongelar –
Observatorio Duoc UC / Anuario 2024 / página 268
Observatorio de la Educación Superior Técnico Profesional - Producción y gestión del conocimiento
Cambiar – Congelar; el modelo de los 8 pasos para el cambio de John Kotter (1996), quien releva el sentido de urgencia y la consolidación de nuevas prácticas culturales; la actualización del modelo de Lewin por Weick y Quinn (1999) con foco en el cambio evolutivo y continuo en sus tres fases Congelar – Rebalancear – Descongelar; por nombrar solo algunos modelos. Sin duda alguna, que estas propuestas han respondido al deseo de adaptabilidad de los seres humanos, quienes “somos interpelados a poner en valor la capacidad de innovación y flexibilidad en las metodologías, los enfoques, la accesibilidad, la disponibilidad, la usabilidad, la detección y el abordaje de brechas, entre otros” (Quilodrán, 2022).
En este mismo contexto, resulta pertinente impulsar la visión sistémica del cambio, no solo como una respuesta al entorno, sino más bien, a un cambio generativo en el sentido de promover nuevas formas de funcionamiento de las organizaciones. Lo anterior, con foco en la generación de capacidades que propicien nuevas estrategias, proactividad en la gestión, así como en el desarrollo y la implementación de nuevas tecnologías. Ya no se trata solamente de aprender a adaptarnos al cambio planificado y estructurado (como el de Lewin), ahora nos desafía un aprendizaje flexible, dinámico y por sobre todo ágil. Y es que resulta inevitable no pensar en agilidad cuando hablamos de adopción digital, más aún si se enfatiza el concepto de adaptabilidad en contextos de obsolescencia tecnológica. Dado lo anterior, surge el concepto de gestión del cambio ágil, siendo Melanie Franklin (2014) una de las referentes profesionales en esta área, quien explica que la gestión del cambio ágil comprende el cambio como un proceso constante, estrechamente vinculado con las rutinas diarias de trabajo, que se optimizan de manera progresiva y reiterada, en lugar de verlo como la realización de proyectos específicos. La respuesta a cualquier desafío se desarrolla a medida que evolucionan los factores que impulsan dicho cambio. En lugar de contar con planes detallados desde el inicio, el cambio progresa a medida que se profundiza nuestro entendimiento de la situación (citado por Soto y Sannino, 2022).

Observatorio Duoc UC / Anuario 2024 / página 269
Observatorio de la Educación Superior Técnico Profesional - Producción y gestión del conocimiento
Otro enfoque que vincula la gestión del cambio para una adopción digital con las metodologías ágiles es precisamente el Lean Change Management de Jason Litlle (2020) quien visualiza las etapas de Hallazgos (similar al diagnóstico) – Opciones (diseño del plan de acción)– Experimentos (implementación y estimación de impactos). Los resultados de esta última etapa, pasan a ser el punto inicial para sucesivos Hallazgos, lo que genera un ciclo continuo de cambio adaptativo (citado por Soto y Sannino, en Cea, 2022).
Tal como se ha señalado a lo largo de esta columna, la adopción digital nos desafía a ser flexibles y receptivos frente al aprendizaje continuo que acciona el uso de nuevos sistemas tecnológicos, que responden a procesos de cambios holísticos e integrales. En este sentido, Malcom Knowles (1984) traería al análisis el concepto de Andragogía (dado su origen etimológico que proviene del griego andros “ser humano, persona mayor” y ago “conducir, guiar”), quien lo definió como “el arte de enseñar a los adultos a aprender” (Fasce, 2006, p.69). Si consideramos que para lograr una adopción digital satisfactoria debemos tener una disposición abierta al aprendizaje como una constante, resulta clave comprender los principios andragógicos que sustentan la facilitación de los procesos de aprendizaje en el adulto a lo largo de toda su vida. Y es que la Andragogía, mediante una práctica cimentada en la participación activa y la igualdad de condiciones, busca fomentar el razonamiento, la autodirección, la mejora en la calidad de vida y el ingenio en el aprendiz adulto. Esto con la finalidad de entregar las herramientas necesarias para su desarrollo personal pleno. Adicionalmente, esta metodología otorga la posibilidad de que el adulto comprometido con su educación se involucre de forma directa en su proceso de aprendizaje (Alcalá, 1997). Precisamente, esto se relaciona directamente con la alfabetización digital que requiere voluntad y predisposición positiva ante nuevas experiencias de aprendizaje, en contextos de adopción digital. En consecuencia, desde una perspectiva andragógica, el adulto que se enfrenta a procesos de cambios tecnológicos busca un aprendizaje significativo que le proporcione nuevas herramientas para su desarrollo laboral y personal, mediante las etapas que conforman la adaptabilidad en entornos digitales.
¿Cómo se interrelacionan o incorporan todos estos elementos en la transformación digital de Duoc UC?
En nuestro Plan de Desarrollo 2021 – 2025, una de las líneas de acción es “Fomentar una cultura digital, innovadora y participativa”, que busca el desarrollo de nuestra comunidad fortaleciendo sus capacidades para evolucionar y adaptarse a los cambios, promoviendo así la digitalización, la innovación y la participación de todas y todos. En esta misma línea, se posiciona el propósito de la Dirección General de Servicios Digitales, que es “desarrollar un ecosistema de servicios y productos digitales centrados en nuestros usuarios”, conformándose así la Unidad de Adopción Digital: como una estrategia transversal al ciclo de vida de nuestros productos y servicios digitales, mediante la incorporación de metodologías que permitan orientar y facilitar a los equipos y usuarios a adaptarse a los distintos cambios, propios de los procesos de transformación digital institucional, promoviendo y fortaleciendo una cultura adaptativa de nuevos productos y sistemas de trabajo.
Principios de la Adopción Digital en Duoc UC
Gestionar el cambio de manera adaptativa (agilidad u otras metodologías) hacia la adopción de una cultura digital y de innovación al interior de Duoc UC.
Observatorio Duoc UC / Anuario 2024 / página 270
Observatorio de la Educación Superior Técnico Profesional - Producción y gestión del conocimiento
Anticipar y prever riesgos adaptativos en la implementación de iniciativas digitales, contribuyendo a la gestión de los proyectos.
Convocar y generar adhesión en la comunidad educativa con información oportuna y canales de retroalimentación que contribuyan a mejorar la implementación de las iniciativas digitales.
Apoyar a las y los líderes del Duoc UC en la generación de sentido e incorporación efectiva de los equipos a los cambios necesarios para la instalación de la adopción digital.
De esta manera, se busca potenciar la propuesta de valor de la Dirección General de Servicios Digitales, asegurando una integración efectiva y eficiente de las tecnologías digitales en la institución, además de movilizar a estudiantes, docentes y administrativos a adaptarse a los desafíos propios de la transformación digital que nos tensiona día a día.
Podemos concluir que la adopción digital trasciende a los procesos de incorporación tecnológica, constituyendo un desafío integral que abarca tanto transformaciones culturales, organizacionales y personales. Las metodológicas de cambio, desde Kurt Lewin hasta las prácticas ágiles, enfatizan la importancia de la agilidad y la proactividad en momentos de cambio. Este enfoque no solo responde a la necesidad de adaptarse a nuevas realidades, sino que también promueve el desarrollo de habilidades que permitan a individuos e instituciones prosperar en un entorno digital complejo y en constante evolución. La adopción digital, por tanto, se convierte en un pilar fundamental para fomentar una cultura de innovación y aprendizaje que beneficie a toda la comunidad Duoc UC, preparándola para futuros desafíos y oportunidades.
Referencias
Alcalá, A. (1997). ¿Es la Andragogía una Ciencia? Universidad Nacional de Venezuela. https://es.scribd.com/document/422722014/Es-La-Andragogia-Una-Ciencia
Daniel, S., & Sannino, D. (2022). Tensiones del desarrollo organizacional en contextos In P. Cea (Ed.), Trabajo y organización en transformación. Universidad del Desarrollo / RIL editores.
Fasce, E. (2006). Andragogía. Revista de Educación en Ciencias de la Salud, 3(2), 69–71.
Knowles, M. (1995). The Modern Practice of Adult Education: From Pedagogy to Andragogy. Cambridge Adult Education.
Kotter, J. P. (1996). Leading Change. Harvard Business School Press.
Lewin, K. (1951). Field theory in social science. Tavistock Publications.
Little, J. (2014) Lean Change Management: prácticas innovadoras para el manejo del cambio organizacional. Happy Melly Express
Quilodrán, S. (2022). Aprendiendo de las crisis como recurso para construir futuro. Reflexiones en torno a la experiencia In P. Cea (Ed.), Trabajo y organización en transformación. Universidad del Desarrollo / RIL editores.
Weick, K. E., & Quinn, R. E. (1999). Organizational change and development. Annual review of psychology, 50, 361–386. https://doi.org/10.1146/annurev.psych.50.1.361
Esta columna fue publicada el 13 de mayo de 2024
Observatorio Duoc UC / Anuario 2024 / página 271
Observatorio de la Educación Superior Técnico Profesional - Producción y gestión del conocimiento
Aprendizaje con drones
desde la metateoría de David Kolb


En el dinámico mundo de la Educación Técnico Profesional, la innovación pedagógica es clave para formar a los futuros profesionales. En este contexto, la incorporación de tecnologías emergentes y el diseño de estrategias didácticas efectivas son fundamentales. Un ejemplo notable es la experiencia desarrollada en la carrera de Técnico en Topografía de la sede Valparaíso de Duoc UC, donde el proceso formativo ha sido transformado mediante el uso de drones y la aplicación de la metateoría del aprendizaje de David Kolb.
Esta iniciativa nos ha permitido incentivar la adquisición de competencias técnicas, promoviendo la autonomía y la capacidad de los estudiantes para enfrentar desafíos reales en su campo. Esta estrategia innovadora, que sirvió de puente entre la teoría y la práctica, ha mejorado significativamente el aprendizaje de los contenidos.
A partir de esta experiencia, participamos en el IX Seminario de Innovación Pedagógica de la Pontificia Universidad Católica con la ponencia titulada “Aprendizaje con Drones desde la Metateoría de David Kolb”. Como docentes de la sede Valparaíso de Duoc UC, fue un honor ser parte de este evento, donde nuestra presentación fue la única seleccionada de un Centro de Formación Técnica. Este logro nos permitió compartir en el ámbito académico nuestras buenas prácticas y la aplicación de metodologías pedagógicas.
En dicha ponencia, al igual que en varias otras, se abordó la pandemia COVID-19 como una de las principales causas que llevaron a replantearse el proceso educativo, enfrentando la necesidad de generar estrategias e innovaciones que permitieran un aprendizaje significativo y adaptado a los nuevos entornos de aprendizaje para los estudiantes.
En la carrera de Técnico en Topografía de Duoc UC, emprendimos la búsqueda de una metodología que conectara con el estudiante actual y potenciara sus habilidades de análisis y planificación. Decidimos, entonces, incorporar herramientas tecnológicas relevantes, como el uso de drones, con vistas a su futura aplicación laboral.
Observatorio Duoc UC / Anuario 2024 / página 272
Observatorio de la Educación Superior Técnico Profesional - Producción y gestión del conocimiento

Estudiantes de Técnico Geomático realizan vuelo de drones. Planificación en base al análisis de las complejidades realizadas en las salidas a terreno anteriores en cerro Florida Valparaíso.
Esta práctica se fundamenta en la metateoría del aprendizaje de Kolb, que destaca la importancia de la experiencia y su conexión con el conocimiento previo. Como señalan Tripodoro y De Simone: “la experiencia cobra sentido cuando se vincula con el conocimiento previo y se desarrollan andamiajes conceptuales que permiten aplicar el nuevo conocimiento a nuevas situaciones, tanto teóricas como prácticas”.
Siguiendo esta premisa, diseñamos experiencias de aprendizaje que permitieron a los estudiantes desarrollar competencias específicas en la técnica de vuelo y uso de drones. Según Wiggins y McTighe, el uso de drones facilita “recopilar datos, tomar fotografías, crear mapas y videos, lo que despierta el interés de los estudiantes”. La integración de estos dispositivos en nuestras clases se realizó mediante la delimitación de experiencias con objetivos claros, garantizando el interés y la perseverancia de los estudiantes en las actividades formativas. El trabajo se organizó en la asignatura de Levantamiento Satelital, donde los estudiantes llevaron a cabo actividades siguiendo la metodología de aprendizaje de Kolb. Inicialmente, aplicaron sus conocimientos en un levantamiento GNSS y un vuelo de dron en el cerro Bellavista de Valparaíso. Luego, procesaron los datos y obtuvieron una primera ortofoto.
A partir de este producto, los estudiantes pasaron a la fase de observación reflexiva, analizando los resultados obtenidos en función de las expectativas de un mandante, utilizando la normativa del MOP. Los errores identificados se convirtieron en oportunidades de mejora, lo que nos llevó a la etapa de conceptualización abstracta de Kolb. Con un nuevo plan, volvimos al terreno para realizar un nuevo levantamiento, aplicando las mejoras propuestas por los propios estudiantes.
Observatorio Duoc UC / Anuario 2024 / página 273
Observatorio de la Educación Superior Técnico Profesional - Producción y gestión del conocimiento

Configuración de equipos, Drones y libreta, para realizar vuelo programado en cerro Florida.
Este proceso motivó profundamente a los estudiantes, quienes vieron cómo sus propuestas e implementaciones mejoraron significativamente los resultados obtenidos. Además, esta experiencia se enriqueció al vincularnos con otras escuelas de Duoc UC. Por ejemplo, colaboramos con la carrera de Ingeniería Agrícola, donde estudiantes utilizaron las ortofotos en la asignatura de Sistema de Información Geográfica para realizar análisis de riesgos y sociales en zonas reales. De esta manera, regresamos al modelo de Kolb, aplicando nuevos elementos en la planificación de los vuelos con drones y generando productos adaptados a las necesidades de un mandante real.
Este enfoque no solo ha permitido que nuestros estudiantes desarrollen experiencia y autonomía, sino que también les ha proporcionado herramientas y metodologías de trabajo útiles en su futuro profesional y en la resolución de problemas en su vida diaria. Estamos convencidos de que estas competencias son fundamentales en la formación de nuestros estudiantes y que este tipo de experiencias contribuyen significativamente a su éxito en el ámbito laboral.
Al observar los resultados obtenidos y el impacto positivo en la formación de nuestros estudiantes, queda claro que la integración de tecnologías emergentes y metodologías pedagógicas innovadoras puede transformar significativamente la Educación Técnico Profesional. La pregunta que surge entonces es: ¿Qué otros elementos de las diversas teorías educativas podríamos explorar para seguir potenciando el aprendizaje de los futuros profesionales técnicos? Los invitamos a reflexionar sobre este desafío y a continuar investigando cómo podemos enriquecer nuestras prácticas docentes para responder a las necesidades de un mundo en constante cambio.
Esta columna fue publicada el 9 de septiembre de 2024
Observatorio Duoc UC / Anuario 2024 / página 274
Observatorio de la Educación Superior Técnico Profesional - Producción y gestión del conocimiento
C1DO1: Un nuevo paso de Duoc UC
en la implementación de tecnologías educativas

Ayala Maraboli Jefe de Proyectos de Tecnologías Educativas
El tiempo pasa sin que nos demos cuenta. Y es en momentos como estos en los que esta afirmación se hace aún más patente. Han sido dos años y medio los que llevamos trabajando en la implementación de C1DO1 en Duoc UC. Camino que, sin dudas, ha tenido altos y bajos, que ha significado un esfuerzo enorme para una gran cantidad de áreas dentro de nuestra institución, y como no, un desafío gigantesco para todos. Sin embargo, si miramos en retrospectiva debemos estar orgullosos de lo que hemos logrado.
Mejorar el proceso de aprendizaje y experiencia de nuestros estudiantes es uno de los objetivos definidos en nuestro Plan de Desarrollo Institucional 2021-2025. Desde la Dirección de Experiencia y Aprendizaje Digital, parte de la Vicerrectoría Académica, somos responsables de apoyar en el cumplimiento de esta meta a través de la incorporación de tecnologías educativas digitales que sean pertinentes e innovadoras, con el foco de preparar a profesionales altamente capacitados para un mundo laboral en constante evolución. En este contexto es que el 2021 nos embarcamos en el reto de implementar esta tecnología educativa, convirtiéndose en uno de los proyectos más ambiciosos que hemos tenido hasta ahora. Iniciamos el desafío con acciones concretas, las llamadas pruebas de concepto, en las que comenzamos a probar la metodología y plataforma en una pequeña cantidad de asignaturas, avanzando rápidamente el 2022 aumentando a 12 asignaturas que reunían a 3.740 estudiantes, de los cuales 1.200 realizaron la actividad en C1DO1. Sin duda, el salto más importante se dio el 2023, cuando esta tecnología llegó a 21 asignaturas que reunían más de 20.000 estudiantes, de los cuales 7.600 llevaron a cabo las actividades. En total, durante todo este período, C1DO1 ha impactado a las 9 Escuelas, a las 19 sedes, 3 Programas Transversales y a cerca de 700 docentes de nuestra institución.
Observatorio Duoc UC / Anuario 2024 / página 275
Observatorio de la Educación Superior Técnico Profesional - Producción y gestión del conocimiento
Pero ¿por qué C1DO1? Porque es una tecnología que ofrece potenciar el proceso de enseñanza y aprendizaje de nuestros estudiantes a través de la adquisición de habilidades prácticas mediante la retroalimentación oportuna, recibida a tiempo y de manera regular; específica, centrándose en aspectos particulares de desempeño identificando fortalezas y debilidades; constructiva, porque es entregada de manera positiva y proactiva con interés en fomentar el crecimiento de los estudiantes; personalizada, porque se adapta a cada estudiante; y basada en evidencia, porque se fundamenta en observaciones concretas para ser objetiva y confiable.
Así como también ofrece otros beneficios como:
Permitir el entrenamiento continuo sin la presencia del instructor o profesor.
Ayudar a la gestión del tiempo del docente y del estudiante, ya que las actividades y la retroalimentación se pueden hacer en cualquier momento y desde cualquier lugar.
Potenciar la curva de aprendizaje y entrenamiento oculto ya que por medio de la retroalimentación el estudiante realiza la actividad varias veces, lo que llamamos el aprendizaje acumulado.
Aumentar la capacidad docente de dar retroalimentación a través de la recolección de datos, porque la retroalimentación de cada actividad permite obtener información estadística que luego puede ser analizada en favor de la eficiencia del proceso de aprendizaje.
La automatización del aprendizaje, porque la data recogida puede ser incorporada a algoritmos de inteligencia artificial y, de esta manera, optimizar procedimientos y recursos docentes.
¿Cómo funciona? C1DO1 es tanto una plataforma como una metodología que posibilita que el docente grabe un video o explicación sobre cómo realizar una actividad, para que luego el estudiante la realice, se grabe y suba su propio video. Este material puede ser retroalimentado directamente por el docente en la misma plataforma a través de distintos formatos como audio, video, texto, dibujo y/u otros. El proceso de retroalimentación, además, es apoyado y medido por un instrumento de evaluación ad hoc para que el docente pueda evaluar el “aprender haciendo” del estudiante. Es justamente esta capacidad para proporcionar retroalimentación detallada y personalizada la que es fundamental para el desarrollo de competencias prácticas en nuestros estudiantes, al mismo tiempo que ofrece a los docentes una herramienta valiosa para mejorar sus técnicas de enseñanza, potenciando los resultados obtenidos.
Las características de la herramienta, y el cambio cultural que implicaba, hicieron que la complejidad del proyecto fuera alta. Por ello, requerimos involucrar a una gran cantidad de áreas y profesionales de Duoc UC para que ayudaran en el correcto desarrollo del mismo. Lo primero que hicimos fue crear una estrategia de implementación basada en lo que llamamos “verticales”, o mesas de trabajo. Es así como tuvimos:
Verticales de Acompañamiento, encargada de mejorar la adopción y uso efectivo de la metodología y la plataforma educativa por parte de los docentes.
Verticales de Capacitación, que fortaleció las habilidades de los docentes en nuevas metodologías y tecnologías poniendo especial énfasis en estrategias de retroalimentación.
Verticales de Comunicaciones, enfocada en mantener una comunicación efectiva y transparente con los principales stackeholders.
Observatorio Duoc UC / Anuario 2024 / página 276
Observatorio de la Educación Superior Técnico Profesional - Producción y gestión del conocimiento
Verticales de Control de Gestión, que garantizó una implementación eficaz de la metodología en la institución.
Verticales de Data, para mejorar la toma de decisiones a través de la visualización efectiva de datos.
Verticales de Diseño Instruccional, con foco en innovar en el diseño instruccional para enriquecer la experiencia de aprendizaje.
Verticales de Integraciones, con el objetivo de optimizar la integración de LMS para mejorar la experiencia del usuario.
Verticales de Soporte, para garantizar un soporte efectivo y eficiente para los usuarios.
Y la estrategia tuvo sus frutos, porque no solo pudimos aumentar exponencialmente la cantidad de estudiantes, docentes, escuelas y sedes involucradas en los pilotos desarrollados hasta ahora, sino que también pudimos integrar con éxito C1DO1 al ecosistema AVA; capacitar a docentes en el uso de la tecnología, poniendo especial énfasis en estrategias de retroalimentación efectiva para sus estudiantes y, crear actividades específicas y pertinentes para cada asignatura involucrada en los pilotos, entre otros logros que obtuvimos trabajando colaborativamente.
Pero eso no fue todo. Gradualmente, los niveles de satisfacción fueron aumentando tanto en estudiantes como en docentes. Es así como, sólo durante el 2023, el 67% de los estudiantes calificaron como “útil” la retroalimentación obtenida a través de la plataforma, un aumento de más de 4% comparado con el primer semestre del mismo año. Asimismo, un 70% de ellos afirmó que pudo realizar correctamente las actividades dispuestas en la plataforma. Y un 78% declaró que estas actividades eran pertinentes para la asignatura en la que utilizaron C1DO1. Asimismo, un 63% indicó que la plataforma es agradable de utilizar, registrando un aumento de 10%.

Observatorio Duoc UC / Anuario 2024 / página 277
Observatorio de la Educación Superior Técnico Profesional - Producción y gestión del conocimiento
Los resultados descritos anteriormente, si bien son positivos, también somos conscientes de que debemos seguir mejorándolos. Es por ello, y en línea con la esencia de trabajo colaborativo de este proyecto es que, mediante una encuesta de satisfacción a los involucrados, así como también a una visita que hicimos a todas las sedes, pudimos recabar información sobre las oportunidades de mejora que tenía la plataforma. Con esa información, aplicamos un plan de mejora que implicó diversas modificaciones a C1DO1 que aplicamos durante el primer semestre de este año, y que estamos seguros contribuirán no solo en el proceso de enseñanza y aprendizaje de nuestros estudiantes, sino que también en la gestión diaria de nuestros docentes y administrativos. ¿Qué hicimos? Integramos la tecnología con el libro de calificaciones, de manera de que los docentes puedan evaluar directamente los trabajos desarrollados por sus estudiantes. Asimismo, la plataforma se integró con el portal de videos de Duoc UC, Kaltura, lo que permite que los videos instructivos de las actividades estén disponibles en aquella plataforma que facilita su edición y actualización en caso de requerirlo. Agregamos una instancia para que los estudiantes puedan responder a la retroalimentación entregada por sus docentes, fomentando la comunicación entre ambos y democratizando el proceso. Configuramos la plataforma para que posibilite el evaluar trabajos en grupo de manera automática, algo que en la versión anterior no se podía. Por último, junto al equipo de Diseño Instruccional Digital, se crearon actividades con evaluaciones sumativas dentro de las asignaturas, lo que aumentará la participación en ellas durante el próximo semestre.
Así las cosas, luego de este extenso período de desarrollo del proyecto, C1DO1 iniciará sus actividades durante el segundo semestre del 2024, convirtiéndose en un recurso disponible en la maleta didáctica de las siguientes asignaturas:
En total, durante el segundo semestre del 2024 C1DO1 impactará a más de 15.000 estudiantes, correspondientes a 8 Escuelas y 1 Programa Transversal, en todas las sedes donde se impartan las asignaturas mencionadas en la tabla anterior.
Agradecemos a todas las áreas y equipos que hicieron posible el alcanzar este hito: Escuelas, Programas Transversales, Dirección de Desarrollo de Programas, Dirección General de Servicios Digitales, Centro de Formación Docente, Gobierno de Datos y Análisis Institucional, Jefes UAP y Docentes. Todos ellos, sin distinción, demostraron un enorme compromiso, con quienes seguiremos trabajando para perfeccionar el uso de esta innovadora herramienta.
Esta columna fue publicada el 15 de julio de 2024
Observatorio Duoc UC / Anuario 2024 / página 278
Observatorio de la Educación Superior Técnico Profesional - Producción y gestión del conocimiento
Una nueva comunidad en Duoc UC CiberVoluntarios:
Claudio Alcota Henríquez
Subdirector de Proyectos de la Escuela de Informática y Telecomunicaciones de Duoc UC
Radiografía Digital

En el marco del Mes de la Ciberseguridad (Ley Nº21.113), es crucial reflexionar sobre los crecientes desafíos que enfrentan tanto jóvenes como adultos mayores en el mundo digital. El estudio “Radiografía Digital de Personas Mayores”, de ClaroVTR y Criteria, reveló que, en 2024, el 29% de los adultos mayores ha sido víctima de fraudes digitales. Aunque muchos han adoptado medidas de protección, como verificar la confiabilidad de los sitios Web y comparar información para evitar noticias falsas, un preocupante 12% aún no sigue prácticas básicas de seguridad, lo que los deja expuestos a estafas.
Por otro lado, el más reciente estudio “Radiografía Digital de Niños, Niñas y Adolescentes” de ClaroVTR y Criteria, reveló que más de la mitad de los adolescentes ha sido contactado con finos engañosos para realizar estafas. Este aumento, que ha crecido del 49% al 56% en un año, deja en evidencia la vulnerabilidad de los jóvenes, especialmente entre los 14 y 16 años. Este grupo es particularmente propenso a prácticas como el sexting, lo que los exponen a mayores riesgos de sufrir sextorsión o pornovenganza., quienes practican sexting con mayor frecuencia y, por ende, están en mayor riesgo de sufrir extorsión sexual o difusión no consentida de imágenes íntimas.
Por otro lado, el más reciente estudio “Radiografía Digital de Niños, Niñas y Adolescentes” de ClaroVTR y Criteria reveló que más de la mitad de los adolescentes ha sido contactada con finos engañosos para realizar estafas. Este porcentaje ha aumentado del 49% al 56% en solo un año, lo que evidencia una creciente vulnerabilidad en los jóvenes, especialmente entre los 14 y 16 años. Este grupo es particularmente propenso a prácticas como el sexting, lo que los exponen a mayores riesgos de sufrir sextorsión o pornovenganza.
Observatorio Duoc UC / Anuario 2024 / página 279
Observatorio de la Educación Superior Técnico Profesional - Producción y gestión del conocimiento
Este panorama revela que tanto adultos mayores como adolescentes enfrentan un creciente riesgo de ciberdelito, a pesar de que muchas medidas de seguridad toman. La rápida evolución de las estafas digitales requiere una mayor concienciación y educación en ciberseguridad para todos los grupos etarios.
Las nuevas formas de estafa digital: Cómo la inteligencia artifi cial está cambiando las estafas
En la era digital, las estafas no son lo que solían ser. Hoy en día, los ciberdelincuentes han perfeccionado sus técnicas para engañar a las personas y obtener información sensible, como contraseñas de redes sociales y claves bancarias. Estos fraudes, que ya afectan a una amplia gama de usuarios, ahora cuentan con un aliado inquietante: La inteligencia artificial.
Un reciente estudio del Centro Nacional de Análisis Criminal (Cenacrim) de la PDI ha revelado cómo esta tecnología está potenciando estafas de manera alarmante. Ya no hablamos solo de engaños simples, sino de fraudes complejos que utilizan IA para hacerlos casi indistinguibles de interacciones reales.
Imaginemos recibir una llamada con la voz exacta de un ser querido, pidiendo ayuda económica urgente, o un mensaje del banco con todos los antecedentes correctos, solicitando que verifiques una transacción. Estos escenarios, que antes parecían fantasías, son ahora una realidad producto de la inteligencia artificial. A continuación, alguna de las técnicas que hoy en día se utilizan con mayor frecuencia:
Clonación de voz: Automatización de llamadas; herramientas de IA generativa (se refiere a creación de audios falsos que simulan ser llamadas reales); password spraying (utilizan una contraseña obtenida en otros sitios a través de herramientas de IA); plataformas de inversión en criptomonedas; intervención de redes WiFi; carga de celulares en lugares públicos; pishing (envío de correos o mensajes haciéndose pasar por promociones); malware (infectar los dispositivos como smartphone y computadores); ataques de ingeniería social(estafadores se hacen pasar por operadores que requieren datos o personas cercanas que necesitan ayuda económica).
La Comunidad de CiberVoluntarios Duoc UC
Frente a estos desafíos, en Duoc UC hemos decidido tomar acción para ser parte de la solución. Desde la Escuela de Informática y Telecomunicaciones, presentamos la Comunidad de CiberVoluntarios, un esfuerzo colectivo formado por estudiantes, docentes, titulados y colaboradores que comparten un objetivo común: promover la ciberseguridad y fomentar las buenas prácticas digitales en nuestra sociedad.
Nuestro propósito es claro y ambicioso: Queremos reducir la brecha digital y favorecer la inclusión tecnológica, brindando apoyo y capacitación en el uso seguro de tecnologías digitales a quienes más lo necesitan. Esto incluye a niños de educación básica, adultos mayores y cualquier grupo que enfrente dificultades para desenvolverse en el entorno digital.
Observatorio Duoc UC / Anuario 2024 / página 280
Observatorio de la Educación Superior Técnico Profesional - Producción y gestión del conocimiento
Nombre
Sebastián Carrasco
Javier Gonzalez
Pía Olivares
Ethan Leiva
Diego Muñoz
Lilian Zapata
Matías Olivera
Crishna Varela
Lucía Salazar
Nicolas Rivera
Moira Bittner
Alondra Salas
Angie Silva
Franco Vásquez
Francisca Alarcón
Marcelo Caballero
Maximiliano Alberto
Marilyn Correa
Joan Garcés
Raquel Rehbein
Bárbara Ortega
Katherine Padilla
Mabel Reyes
Gonzalo Araneda
Dania Ordenes
Alexabet Villasmil
Amaro Pinto
Benjamín Bustamante
Matías Maureira
Yasmín Parra
Sebastián Altamirano
Ismael Consuegra
Carlos De Ferrari
Carrera Sede
Ingeniería en Informática Alameda
Ingeniería en Informática Alameda
Ingeniería en Infraestructura Tecnológica Antonio Varas
Ingeniería en Informática Antonio Varas
Ingeniería en Desarrollo de Software Campus Virtual
Desarrollo de aplicaciones Campus Virtual
Ingeniería en Informática Maipú
Ingeniería en Informática Maipú
Ingeniería en Informática Melipilla
Ingeniería en Informática Melipilla
Ingeniería en Informática Padre Alonso de Ovalle
Ingeniería en Informática Padre Alonso de Ovalle
Ingeniería en Informática Plaza Norte
Ingeniería en Conectividad y Redes Plaza Norte
Ingeniería en Informática Plaza Oeste
Analista Programador Computacional Plaza Vespucio
Ingeniería en Informática Plaza Vespucio
Ingeniería en Informática Puente Alto
Ingeniería en Informática Puente Alto
Ingeniería en Informática Puerto Montt
Ingeniería en Informática Puerto Montt
Ingeniería en Conectividad y Redes San Andrés de Concepción
Ingeniería en Conectividad y Redes San Andrés de Concepción
Administración de redes San Bernardo
Administración de redes San Bernardo
Ingeniería en Informática San Carlos de Apoquindo
Ingeniería en Informática San Carlos de Apoquindo
Ingeniería en Conectividad y Redes San Joaquín
Ingeniería en Conectividad y Redes San Joaquín
Informática Biomédica Valparaíso
Ingeniería en Informática Valparaíso
Ingeniería en Conectividad y Redes Viña del Mar
Ingeniería en Informática Viña del Mar
Observatorio Duoc UC / Anuario 2024 / página 281
Observatorio de la Educación Superior Técnico Profesional - Producción y gestión del conocimiento
La comunidad la conforman personas apasionadas por las tecnologías, que de manera voluntaria comparten su tiempo y conocimientos para ayudar a otros a comprender y aprovechar mejor las herramientas digitales. Su labor no solo consiste en enseñar a usar tecnologías, sino también en promover la alfabetización digital, y lo más importante, fomentar la confianza y seguridad en el uso de internet. La educación en ciberseguridad es fundamental para que todos, sin importar su edad o nivel de experiencia, puedan navegar en un entorno digital de manera segura y eficiente.
El quehacer de la comunidad está sobre la base de campañas de concientización, talleres interactivos y eventos, en los que compartirán conocimientos de forma práctica y accesible. Estas actividades buscan empoderar a las personas con las herramientas necesarias para identificar y prevenir riesgos digitales. Cada taller, cada charla y cada interacción es una oportunidad para generar un cambio positivo y ayudar a que más personas se sientan seguras y capacitadas en el mundo digital.
Esta iniciativa no se centra únicamente en la tecnología, sino en las personas. Es el compromiso de una comunidad por apoyar a quienes más lo necesitan, por cerrar la brecha digital y por hacer del espacio virtual un lugar más seguro para todos. En Duoc UC creemos firmemente que la ciberseguridad es una responsabilidad compartida, y por eso estamos formando una red de apoyo que está dispuesta a dar un paso al frente.
Hoy damos inicio a esta comunidad con la presentación de quienes lideran a los CiberVoluntarios. Ellos serán los responsables de guiar y coordinar nuestras actividades, y con su pasión y compromiso, estoy seguro de que, juntos, lograremos marcar una diferencia significativa en nuestra comunidad.
“Recuerda: La ciberseguridad depende de todas y todos”
CiberVoluntarios Duoc UC 2024
• Adrián Omar Gutiérrez Sánchez, titulado Duoc UC
• Nicolás Alfred Contador Vilches, docente Duoc UC
Referencias:
• “Ley n°21.113”; Biblioteca del Congreso Nacional de Chile / BCN; https://www.bcn.cl/leychile/navegar?idNorma=1123489
• “Los principales riesgos digitales que enfrentan jóvenes y personas mayores en Chile”; La Tercera; https://www.latercera.com/ piensa-digital/noticia/los-principales-riesgos-digitales-que-enfrentan-jovenes-y-personas-mayores-en-chile/QC5UPAZHTBAH5EXHFNBXDN4GVU/#
• “Mucho cuidado: conoce las 9 nuevas estafas de los ciberdelincuentes”; La Tercera; https://www.latercera.com/servicios/noticia/mucho-cuidado-conoce-las-9-nuevas-estafas-de-los-ciberdelincuentes/XE4LRSTSWFFJDIYKHXTDWTZOYA/
• “Radiografía Digital 2024”; VTR.COM; https://vtr.com/radiografia-digital
Esta columna fue publicada el 28 de octubre de 2024
Observatorio Duoc UC / Anuario 2024 / página 282
Observatorio de la Educación Superior Técnico Profesional - Producción y gestión del conocimiento
Docente Holograma: La tecnología
que revolucionará el proceso de enseñanza-aprendizaje

Deninson Rangel Moreno Jefe de Proyectos de Tecnologías Educativas. Dirección de Experiencia y Aprendizaje Digital de Duoc UC.
Mejorar la experiencia y el aprendizaje de nuestros estudiantes. Este es uno de los objetivos que se declaran en el Plan de Desarrollo Duoc UC 2021-2025, y en el cual se enfoca en gran medida el trabajo que desarrolla la Vicerrectoría Académica de nuestra institución. En este camino es relevante reconocer que existen diversos factores y acciones que inciden en el cumplimiento de esta meta: Nuevas instalaciones, más y mejores docentes, actividades extracurriculares, entre muchos otros.
La tecnología es un ítem clave también en este proceso. La implementación de nuevas herramientas, estrategias y maneras de llevar a cabo el proceso de enseñanza y aprendizaje es un aspecto importante para poder justamente mejorar la experiencia y los aprendizajes que nuestros estudiantes obtienen en sus planes de estudio, preparándolos de la mejor manera para enfrentar los desafíos de un mundo en constante cambio.
Ahora bien, de nada sirven las tecnologías si no tenemos docentes que sepan sacar el mayor provecho de ellas; que se sientan cómodos usándolas; y que saben apoyar a sus estudiantes en su uso también. Es por ello que la implementación de tecnologías en nuestra institución viene acompañada fuertemente de acciones tendientes a fomentar una cultura digital, innovadora y participativa, una de las estrategias también declaradas en el Plan de Desarrollo 2021-2025. De manera que todos podamos aprovechar la innovación en pos de prepararnos para el futuro.
El trabajo en este sentido no solo no se detiene, sino que avanza con fuerza. Prueba de ello es que el pasado mes de agosto hemos lanzado un nuevo proyecto titulado Docente Holograma en la sede San Andrés de Concepción, y que convierte a nuestra institución en pionera en Sudamérica en su uso. La llegada de esta tecnología es consecuencia de un trabajo de exploración sistemática de tecnologías que puedan
Observatorio Duoc UC / Anuario 2024 / página 283
Observatorio de la Educación Superior Técnico Profesional - Producción y gestión del conocimiento
aportar a nuestro Modelo Educativo, y en esta oportunidad vimos la docencia holográfica como una manera de acercar a los mejores docentes y expertos de la industria a esas zonas más remotas en las que es difícil alcanzar estos aprendizajes.
La nueva tecnología, que ya comenzó a ser utilizada, transforma la enseñanza y el aprendizaje con profesores proyectados en tiempo real en forma de hologramas, rompiendo no solo la barrera demográfica, sino que también mejorando la interacción y la motivación de los estudiantes a través de una experiencia educativa dinámica y cercana.
¿Cómo funciona en la práctica? Durante el presente año implementamos una sala transmisora en la sede Antonio Varas de nuestra institución, desde la cual los docentes hologramas desarrollarán sus clases de forma sincrónica. Esta sala cuenta con tecnología de punta que permite a los docentes proyectar sus clases, escuchar e interactuar con sus estudiantes. En tanto, en la sede San Andrés de Concepción instalamos una sala receptora, donde estarán los estudiantes de las asignaturas que hoy por hoy están utilizando esta tecnología. Ellos podrán ver al docente holograma presente en el aula, conversar con él, así como también con sus compañeros y ver la proyección del material de apoyo de sus docentes. Esta innovadora implementación nos permite llevar la enseñanza a un nuevo nivel de inmersión y participación. Los estudiantes pueden interactuar con el docente holográfico de la misma manera que lo harían con un docente que se encuentre presencial: Haciendo preguntas, participando en discusiones y colaborando en proyectos, todo mientras experimentan la sensación de estar frente a su presencia física. Asimismo, los docentes holograma contarán con el apoyo de un docente facilitador, quien estará en las salas apoyándolos con todo lo que necesiten en relación al correcto funcionamiento de la tecnología, de manera de facilitar su trabajo.
Y los beneficios de esta tecnología no se acaban ahí. Esta innovación también permitirá que:
Los docentes pueden estar disponibles para dar clases en varios lugares al mismo tiempo, lo que maximiza su eficiencia.
Superar las limitaciones geográficas al permitir la participación de estudiantes ubicados en diferentes sedes o incluso en ubicaciones remotas, lo que promueve la inclusión y la accesibilidad.
Oportunidades de colaboración internacional, pudiéndose establecer acuerdos de colaboración con otras instituciones o empresas para compartir el acceso a docentes holográficos.
Nuevas oportunidades para aquellas asignaturas con dificultad de prospecto docente.
Facilitar la participación de expertos y profesionales de todo el mundo como profesores invitados, lo que enriquece la experiencia educativa al brindar una variedad de perspectivas y conocimientos.
El Docente Holograma, por tanto, no solo representa una oportunidad para enriquecer el aprendizaje mediante la visualización tridimensional y la interactividad, sino que también abre nuevas puertas para la colaboración global al permitir la participación de expertos y profesionales de todo el mundo, sin las limitaciones de la distancia física.
Observatorio Duoc UC / Anuario 2024 / página 284
Observatorio de la Educación Superior Técnico Profesional - Producción y gestión del conocimiento
Al implementar esta tecnología de vanguardia se busca fomentar un entorno de aprendizaje dinámico, inclusivo y centrado en el estudiante, donde la innovación y la excelencia académica sean los pilares fundamentales. De esta forma, demostramos nuevamente nuestro compromiso con preparar a nuestros estudiantes para sobresalir en un mundo digital y conectado, equipándose con las habilidades y conocimientos necesarios para triunfar en su futuro profesional y contribuir de manera significativa a la sociedad.
El trabajo llevado a cabo hasta ahora no hubiese sido posible si no fuera porque una gran cantidad de áreas se involucraron en este proyecto cumpliendo diversos roles. Es así como la Dirección de Desarrollo de Programas generó las maletas didácticas que nos sirvieron de guía para la preparación de las experiencias de aprendizaje basadas en telepresencia; la Dirección de Servicios de Infraestructura fueron los encargados de toda la habilitación física de las salas transmisora y receptora tanto en la sede San Andrés de Concepción como en la sede Antonio Varas; el área de Diseño Instruccional Digital diseñó y desarrolló la estrategia tecno-pedagógica del proceso de incorporación de la tecnología educativa en la asignatura, asegurando el cumplimiento de los resultados de aprendizaje establecidos en la Maleta Didáctica; la Dirección General de Servicios Digitales dispuso de los habilitadores tecnológicos que nos permitieron poner en funcionamiento la tecnología involucrada en el proyecto; la Dirección de Gobierno de Datos y Análisis Institucional generará las encuestas que nos permitirán medir la satisfacción y la experiencia del estudiante que tendrán clases con los Docente Holograma; la Dirección de Marketing y Comunicaciones consolidó todos los temas asociados a los planes de comunicación para los distintos públicos objetivos; y la Dirección de Estudios y Progresión Estudiantil apoyará la medición de impacto de incorporación de tecnologías mediante los parámetros académicos institucionales y presupuesto la sede San Andrés de Concepción que de una forma positiva, colaborativa y ágil trabajamos para lograr el éxito la puesta en marcha del proyecto. A todos estos equipos queremos agradecerles por el esfuerzo y compromiso que demostraron para poder llegar hasta este punto en el proyecto. Así como también el interés en fortalecer la formación de nuestros estudiantes mediante esta innovación que estamos llevando a cabo.
Hoy, lejos de terminar nuestro trabajo, comienzan nuevos desafíos en torno al Docente Holograma. Ya que tenemos el deber de analizar sus resultados durante el semestre, la satisfacción de nuestros estudiantes, cuánto potenció su aprendizaje, entre otros factores. Por tanto, la colaboración entre áreas continuará fuertemente para que tanto los estudiantes como los docentes, puedan obtener el mayor provecho de esta tecnología.
Esta columna fue publicada el 16 de septiembre de 2024
Observatorio Duoc UC / Anuario 2024 / página 285
Observatorio de la Educación Superior Técnico Profesional - Producción y gestión del conocimiento
El Centro de Competencias Ágiles–Playbook
para impulsar la cultura ágil, innovadora y colaborativa dentro de la Dirección General de Servicios Digitales
Carlos Manzur Vicencio

Líder Ágile. Centro de Competencias Ágiles
La Dirección General de Servicios Digitales de Duoc UC (DGSD) está experimentando un cambio significativo que beneficia a toda su comunidad al enfocarse en la creación y mejora ágil de productos tecnológicos. Este cambio se manifiesta en varios aspectos importantes.
En primer lugar, este nuevo enfoque está impulsando la innovación y la creatividad en todos los equipos. Esto implica probar nuevas ideas y adaptarse a las necesidades de estudiantes, docentes y colaboradores, lo que conduce a soluciones enfocadas en entregar valor al usuario final.
En segundo lugar, se fomenta un ambiente de aprendizaje continuo entre los equipos. Al recibir retroalimentación constante y realizar cambios oportunos, están constantemente buscando formas de mejorar, lo que los mantiene actualizados frente a los cambios y desafíos institucionales.
En este contexto, surge el Centro de Competencias Ágiles con el propósito de impulsar la transformación ágil desde la DGSD. Su objetivo principal es fomentar la colaboración, promover la innovación y mejorar la eficiencia en los procesos y la entrega de valor. Además, busca ser un referente para otros equipos compartiendo conocimientos y experiencias con enfoques ágiles.
Como parte de su compromiso con la innovación y la colaboración, el Centro de Competencias Ágiles presenta su nuevo Playbook metodológico, diseñado internamente para proporcionar a los colaboradores una guía completa en frameworks ágiles y mejorar su desempeño en proyectos digitales.
Observatorio Duoc UC / Anuario 2024 / página 286
Observatorio de la Educación Superior Técnico Profesional - Producción y gestión del conocimiento

Actividad de retrospectiva en conjunto con el equipo de Educación Continua de Duoc UC.
¿Qué es exactamente un Playbook? Es una herramienta diseñada para introducir de manera rápida y sencilla a las personas en los diferentes marcos ágiles (frameworks) utilizados en la institución y la industria del desarrollo de software. Este recurso será útil tanto para actores clave en ceremonias ágiles como para participantes en proyectos desarrollados con estos métodos de trabajo.
Dentro del Playbook, pueden encontrar:
Lanzamiento Playbook Metodológico CCA
Historia del manifiesto ágil y sus principios fundamentales.
Descripción detallada de los frameworks ágiles más relevantes.
Profundización en el framework Scrum, ampliamente utilizado en la actualidad.
Comparativa entre proyectos ágiles y tradicionales, resaltando ventajas y desafíos en el contexto de la institución.
La DGSD invita a todos los colaboradores y miembros de la comunidad académica a explorar este Playbook y contribuir con sus observaciones y sugerencias. Este recurso se concibe como un documento vivo y dinámico destinado a evolucionar y mejorar continuamente con la retroalimentación de quienes lo utilizan.
Observatorio Duoc UC / Anuario 2024 / página 287
Observatorio de la Educación Superior Técnico Profesional - Producción y gestión del conocimiento
Con este lanzamiento, la DGSD reafirma su compromiso con la excelencia en la gestión de proyectos digitales, la adopción de prácticas ágiles y el fortalecimiento de una cultura organizacional innovadora y colaborativa. Para acceder al Playbook y obtener más detalles, visita el enlace al final de este articulo o comunícate al correo cca@duoc.cl para más información.
Otras iniciativas del CCA
Así mismo hay otras actividades que estamos realizando como Centro de Competencias Ágiles (CCA) que van en la línea de poder entregar, comunicar y socializar nuevas formas de trabajar. Entre ellas el Showcase este evento quincenal tiene como propósito el poder mostrar los avances en iniciativas y proyectos, además de poder educar respecto al uso de metodologías prácticas ágiles a nuestros equipos.

Lanzamiento Playbook Metodológico CCA.
Eventos como los Showcase nos brindan la oportunidad de cultivar una cultura y mentalidad ágil, que trasciende los límites de los proyectos tecnológicos para abordar la forma en que los equipos se relacionan e interactúan. La agilidad surge como respuesta precisa a las necesidades, dinámicas y cambios del entorno empresarial, promoviendo la flexibilidad, la colaboración, la transparencia y la adaptabilidad como pilares fundamentales.
Ahora bien, no solo generamos instancias internas de colaboración, si no que participamos en otras actividades de la industria, precisamente en abril de este año el Centro de Competencias Ágiles de Duoc UC participó y fue patrocinador oficial del encuentro Agile en Chile 2024. Esta actividad tiene como propósito el de reunir a destacados exponentes de la agilidad de toda Latinoamérica para compartir experiencias, conocimientos y prácticas en torno a la agilidad.
Observatorio Duoc UC / Anuario 2024 / página 288
Observatorio de la Educación Superior Técnico Profesional - Producción y gestión del conocimiento

Showcase 9 del Centro de Competencias Ágiles.
La conferencia ofrece un espacio para aprender, establecer redes de contacto y discutir las tendencias y prácticas ágiles actuales. Participar en Ágiles en Chile 2024 es importante por las siguientes razones. Es una oportunidad para actualizarse sobre las últimas prácticas y estrategias en el desarrollo de software ágil y en la agilidad empresarial. Así mismo, este tipo de instancias permite conectar con otras empresas e instituciones en el ámbito de la agilidad que estén llevando un proceso de cambio similar al que estamos viviendo en la DGSD, lo cual puede abrir puertas a nuevas oportunidades de colaboración. Acá contamos con ponencias como la del Tecnológico de Monterrey y su área denominada “techvolution” la cual lleva un proceso de cambio parecido al que vivimos nosotros.
Al interactuar con expertos, colegas y áreas similares en otras organizaciones, se pueden obtener nuevas ideas y perspectivas que impulsen la innovación dentro de nuestra institución. Asistir y participar contribuye al crecimiento y fortalecimiento de la comunidad ágil en Latinoamérica. Ágiles en Chile 2024 fue una instancia valiosa para que el CCA se mantenga a la vanguardia en el campo de la agilidad.
Finalmente, esperamos el seguir aportando desde nuestro conocimiento metodológico a diversas áreas de Duoc UC como la Dirección General de Personas con la cual hemos trabajado en conjunto impulsando la implementación y adopción de prácticas agiles en el día a día de los colaboradores de dicha área por medio del proyecto: Ágiles DGP. Y esperamos además colaborar con el Centro de Innovación y Transferencia Tecnológica (CITT) de la Escuela de informática y Telecomunicaciones para desarrollar actividades que vayan en la línea de difundir la agilidad como practica tanto en la comunidad de estudiantes, como en los docentes que desarrollan proyectos en el CITT.
Observatorio Duoc UC / Anuario 2024 / página 289
Observatorio de la Educación Superior Técnico Profesional - Producción y gestión del conocimiento

En esta misma línea durante el mes de agosto de este año realizaremos el 1er seminario de Competencias Ágiles en la sede Maipú de Duoc UC, actividad que busca el reunir a exponentes de la agilidad a compartir experiencias y buenas prácticas al utilizar estos modelos de trabajo, además de dar a conocer a nuestra comunidad de estudiantes los beneficios de trabajar en agilidad. Este seminario estará acompañado en la tarde por talleres prácticos donde podrán participar estudiantes, docentes y colaboradores interesados en aprender más del mundo ágil.
Finalmente te invitamos a visitar nuestra página de Intranet y revisar interesante material como nuestro Playbook metodológico:
https://duoccl0.sharepoint.com/sites/DireccionGeneraldeServiciosDigitales/SitePages/cca.aspx
Puedes además comunicarte con nosotros al mail cca@duoc.cl
Esta columna de opinión fue publicada el 13 de mayo de 2024
Observatorio Duoc UC / Anuario 2024 / página 290
Observatorio de la Educación Superior Técnico Profesional - Producción y gestión del conocimiento
Gestionando la incertidumbre:
estrategias de anticipación en productos digitales

Daniel Carrasco Medina Subdirector de Experiencia de Usuario y Adopción de Duoc UC
Las instituciones de educación superior se someten a procesos de acreditación que desafían toda la estructura organizativa y nos hacen reflexionar sobre nuestra contribución en la formación de personas que, año a año, confían en esta institución para continuar con su trayectoria educativa. Un componente clave de este proceso –y razón por la cual la utilizo como ancla–, es la propensión al mejoramiento continuo para asegurar la calidad en los servicios que entregamos a estudiantes. La tecnología, y también los servicios digitales, se están convirtiendo en un pilar fundamental para adaptarse a las necesidades cambiantes de los estudiantes, docentes, titulados y colaboradores. Actúan como una plataforma esencial para innovar y mejorar la experiencia educativa, especialmente en un tiempo marcado por la aceleración tecnológica, invenciones, disrupciones, en fin.
Por ejemplo, la tecnología puede desempeñar un papel crucial en la personalización de la educación. Los sistemas digitales pueden recopilar y analizar datos sobre el rendimiento y las preferencias de los estudiantes, lo que permite a las instituciones adaptar su oferta educativa a las necesidades individuales de cada alumno y alumna. Otro ejemplo, los servicios digitales pueden actuar como un medio de soporte, proporcionando un espacio seguro para la comunicación, el intercambio de ideas y la colaboración. Estos servicios pueden ayudar a los estudiantes a sentirse más conectados con su institución y entre sus compañeros, lo que puede aumentar su compromiso y, por tanto, mejorar sus capacidades, competencias y resultados de aprendizaje.
Algo en común y muy beneficioso tienen ambos ejemplos, y es que nos empujan a la anticipación. Ejercicio valioso en cuanto se transforma en una herramienta clave para gestionar la incertidumbre, concepto ícono del tiempo que nos ha tocado vivir, tanto así, que hasta existe un índice mundial para medirlo: el World Uncertainty Index (WUI).
Observatorio Duoc UC / Anuario 2024 / página 291
Observatorio de la Educación Superior Técnico Profesional - Producción y gestión del conocimiento
Pues bien, ¿cómo formular entonces, una estrategia que permita otorgar dirección y certezas dentro de este entorno? A mí parecer, bien vendría apostar por la anticipación como eje principal. La creación de mapas de riesgos y oportunidades derivados de los diversos escenarios proyectados nos facilitará tomar decisiones con una visión más completa. Estos mapas nos brindarán una guía clara para cada decisión que se tome, considerando no solo la situación actual, sino también los posibles efectos futuros. Con esto, podemos tomar en cuenta la probabilidad de que ocurran ciertos eventos y prepararnos adecuadamente para ellos, brindando una estrategia de mitigación y aprovechamiento de oportunidades más eficiente y eficaz.
Para el desarrollo de nuestras líneas de acción, estamos intentado adoptar este concepto incluyéndolo a cada una de las actividades de nuestra hoja de ruta. Acá comparto algunas:
Comenzar desde un profundo conocimiento de las necesidades de los usuarios: Buscamos acompañar de un proceso robusto de investigación de usuarios (test con usuarios, recolección de analítica de uso, entrevistas, entre otras) todas aquellas intervenciones que modelarán una nueva experiencia digital para la comunidad. Con esto, buscamos anticiparnos a una entrega que podría obtener una baja adopción y mitigamos riesgos de no-uso e insatisfacción.
Involucrar a las partes interesadas –de casa central y sedes– en la priorización de sus iniciativas digitales: Estando cerca de las Direcciones, Subdirecciones y sus equipos de especialistas, podemos establecer marcos de trabajo, compartirnos información y ubicar las iniciativas en el tiempo, esto último es importante porque gestionamos la expectativa y sentido de urgencia. Al mismo tiempo, podemos anticipar lo relacionado al esfuerzo y conformación de equipos de trabajo, tanto con profesionales de Duoc UC, como con nuestros proveedores.
Generar lineamientos y estándares en el uso de tecnologías y productos emergentes, promoviendo la adopción del software institucional: El uso de estándares garantiza que un producto sea fiable y de buena calidad. Junto con transformarse en una herramienta de eficiencia, los estándares y lineamientos otorgan un marco de acción que ayuda a los equipos a desarrollar en tiempo y forma. Actualmente, las tecnologías emergentes nos obligan a desarrollar lineamientos que vayan adecuándose a la realidad y que habiliten al mismo tiempo la experimentación y las pruebas de concepto, todas dentro de un marco institucional. Una vez más, buscamos anticiparnos a escenarios que podrían poner en riesgo la privacidad de datos o la ciberseguridad, como es el caso de los sistemas denominados como Shadow IT*
Instalar capacidades en la gestión y estrategia de producto: Un cambio reciente, ha sido nuestra re-organización en unidades producto, cada una compuesta por tres roles claves: Product Manager (Líder o Responsable de Producto), Product Designer (Diseñador de Producto) y Tech Lead (Líder Técnico), todos perfiles que encuentran su homólogo en la industria digital y que hacen más factible su comparación en el mercado. Al mismo tiempo, la incorporación de estos nuevos perfiles a la Dirección General de Servicios Digitales, nos pone un desafío importante en la atracción del mejor talento digital y junto con ello, a seleccionar profesionales motivados por impactar en la trayectoria educativa de los miles de estudiantes de nuestra institución.
Así, la anticipación estratégica nos está abriendo nuevos espacios de colaboración que permiten aumentar nuestra capacidad de ver cuanto antes, nuevas posibilidades para brindar mejores experiencias y servicios para nuestros estudiantes. Todo este trabajo, unido a la participación activa de las distintas unidades
Observatorio Duoc UC / Anuario 2024 / página 292
Observatorio de la Educación Superior Técnico Profesional - Producción y gestión del conocimiento
de Duoc UC, nos permitirá abrazar la incertidumbre como una oportunidad gestionada, que aumentará nuestra capacidad para influir en los escenarios futuros.
*Shadow IT o en español “TI en la sombra”, hace referencia al uso de sistemas, dispositivos, software, aplicaciones y servicios de tecnología de la información sin la aprobación del departamento central que gobierna los servicios digitales en la institución.
**CSAT (Customer Satisfaction Score) es un índice de satisfacción que se obtiene a través de una puntuación dada por los usuarios de un producto o servicio en una escala de 1 a 5. Regularmente como respuesta a la pregunta “¿Qué tan satisfecho(a) estás con el producto X?”
Esta columna fue publicada el 13 de mayo de 2024
Observatorio Duoc UC / Anuario 2024 / página 293
Observatorio de la Educación Superior Técnico Profesional - Producción y gestión del conocimiento
Innovación y diversidad:
La Escuela IT de Duoc UC como referente en tendencias internacionales

Coordinador
Tecnológica
En un mundo cada vez más digitalizado, las Tecnologías de la Información se posicionan como el motor de la transformación económica y social. La Escuela de Informática y Telecomunicaciones de Duoc UC, a través de iniciativas como el Centro de Innovación y Transferencia Tecnológica (CITT), el Centro Tecnológico y el programa Más Mujeres en las TICs, no solo aborda desafíos locales, sino que también van en línea con las tendencias tecnológicas de Europa. Estas acciones colocan a la institución como un referente en la Educación Técnico Profesional.
El CITT: Innovación aplicada y transferencia tecnológica
El CITT de Duoc UC se ha consolidado como un espacio de colaboración donde convergen academia, industria y comunidad para desarrollar soluciones reales a problemas concretos. Este modelo de innovación aplicada está perfectamente alineado con lo que en Europa se conoce como Innovación Abierta, un enfoque ampliamente adoptado en universidades técnicas y centros de investigación como el TRUST Lab de la Universidad Politécnica de Cartagena, donde actualmente participo. En ambos contextos, la integración de habilidades técnicas con desafíos del mundo real permite a los estudiantes adquirir una experiencia formativa única.
El Centro Tecnológico: Conectividad, inteligencia artificial y XR
El Centro Tecnológico de Duoc UC avanza en áreas emergentes como la inteligencia artificial, 5G y ciberseguridad, adaptándose a las prioridades globales. Un aspecto particularmente destacable es su trabajo en tecnologías de Realidad Extendida (XR), incluyendo realidad virtual y aumentada, las cuales abren nuevas puertas en el ámbito educativo y profesional.
Observatorio Duoc UC / Anuario 2024 / página 294
Observatorio de la Educación Superior Técnico Profesional - Producción y gestión del conocimiento

Tendencias Tecnológicas que están siendo investigadas en el Telefónica Technology & Automation Lab, Distrito Telefónica.
Recientemente, tuve la oportunidad de visitar el Nokia eXtended Reality Lab en España, donde pude observar cómo estas tecnologías están siendo desarrolladas para mejorar la comunicación y la conexión humana y emocional. La experiencia fue reveladora, al mostrar cómo XR no solo es una herramienta tecnológica, sino también un puente para resolver problemas sociales y potenciar experiencias significativas.
En este sentido, el Centro Tecnológico, a través del Laboratorio de Innovación y Desarrollo Tecnológico (LIDETI), está explorando aplicaciones similares. Desde el uso de realidad virtual en el manejo emocional hasta proyectos que mejoran el rendimiento deportivo a través de entornos controlados, el Centro Tecnológico no solo sigue las tendencias internacionales, sino que también las adapta a las necesidades locales, marcando un impacto tangible en la comunidad.
Más Mujeres en las TICs: La diversidad como motor de la innovación
Aumentar la participación femenina en áreas STEM (Ciencia, Tecnología, Ingeniería y Matemáticas) sigue siendo un desafío tanto en Chile como en Europa. Iniciativas como Más Mujeres en las TICs de Duoc UC han demostrado ser una respuesta efectiva para cerrar esta brecha. Este programa, a través de mentorías, talleres y proyectos prácticos, no solo fomenta el acceso de las mujeres a estas áreas, sino que también garantiza su permanencia y éxito.
En España, programas como “Ciencia y Tecnología en Femenino” buscan metas similares, reconociendo que la diversidad de género impulsa la innovación. La experiencia europea reafirma que programas como Más Mujeres en las TICs están en el camino correcto y que su fortalecimiento es clave para abordar los desafíos del siglo XXI.
Observatorio Duoc UC / Anuario 2024 / página 295
Observatorio de la Educación Superior Técnico Profesional - Producción y gestión del conocimiento

Internacionalización: Abriendo fronteras para la innovación
En un contexto global, es esencial que nuestros estudiantes tengan la oportunidad de vivir de primera mano las tendencias tecnológicas en el extranjero. Experiencias como las vividas en las jornadas 5G/6G de TelecoRenta, Telecofórum, Talent4Cyber de TRUST Lab y el Nokia eXtended Reality Lab me han demostrado el valor de la internacionalización como herramienta educativa.
Además, mi participación como mentor en el programa Digitaliza tu Pueblo en España ha sido especialmente enriquecedora. Este proyecto fomenta la creación de soluciones tecnológicas para comunidades rurales, combinando innovación con impacto social. Guiar a jóvenes en el desarrollo de iniciativas que mejoran la calidad de vida en sus localidades reafirma la importancia de aplicar la tecnología como un medio para transformar vidas. Este tipo de experiencias internacionales nos enseñan a abordar desafíos desde perspectivas diversas y a volver con ideas frescas para contribuir a una sociedad más justa y equitativa en Chile.
La posibilidad de que estudiantes y docentes interactúen con tecnologías emergentes, exploren nuevos enfoques y compartan conocimientos en otros contextos culturales no solo enriquece su formación, sino que también los prepara para ser agentes de cambio para una sociedad mejor.
Observatorio Duoc UC / Anuario 2024 / página 296
Observatorio de la Educación Superior Técnico Profesional - Producción y gestión del conocimiento

Un modelo educativo con proyección internacional
El éxito de la Escuela IT radica no solo en sus programas innovadores, sino también en su visión integral que conecta educación, industria y sociedad. La Vinculación con el Medio (VcM) en Duoc UC, si bien es un complemento a estas iniciativas, juega un rol esencial al conectar estas propuestas con las necesidades reales del entorno, generando soluciones prácticas y sostenibles.
Durante mi participación en eventos internacionales, he observado cómo las instituciones educativas europeas priorizan la colaboración con la industria y el aprendizaje práctico. Este enfoque, que Duoc UC ya ha adoptado, no solo mejora la calidad de la formación técnica, sino que también posiciona a la institución como un actor clave en el desarrollo global.
Hacia un futuro conectado
A través de iniciativas como el CITT, el Centro Tecnológico y Más Mujeres en las TICs, la Escuela IT de Duoc UC está liderando el camino en áreas emergentes como inteligencia artificial, ciberseguridad, conectividad y XR. Estas acciones no solo están alineadas con las tendencias internacionales, sino que también reflejan un compromiso con la innovación, la inclusión y el desarrollo humano.
En un mundo donde la tecnología es cada vez más central para el progreso social, Duoc UC se posiciona como un referente que transforma no solo la vida de sus estudiantes, sino también el futuro de las comunidades a las que impacta.
Esta columna fue publicada el 25 de noviembre de 2025
Observatorio Duoc UC / Anuario 2024 / página 297
Observatorio de la Educación Superior Técnico Profesional - Producción y gestión del conocimiento
La investigación aplicada desde
el Centro Tecnológico de la Escuela de Informática y Telecomunicaciones. Investigación Aplicada en Duoc UC

Cristián Eduardo Molina Pedernera Docente Investigador, Centro Tecnológico (CeT) de Escuela de Informática y Telecomunicaciones de Duoc UC.
El campo de la investigación aplicada ha ganado una atención significativa en los últimos años incentivado principalmente por políticas gubernamentales como la Ley N°21.105, 2018 e iniciativas privadas que buscan transitar hacia una economía enriquecida por la tecnología y la innovación (Guevara-Pezoa, 2023). A su vez, en el ámbito académico se utiliza como un medio para cerrar el vacío entre el conocimiento académico y las aplicaciones prácticas del mundo real.
La investigación aplicada se centra en la resolución de problemas prácticos y la generación de conocimientos directamente aplicables a situaciones concretas. Implica también trabajos originales realizados para adquirir nuevos conocimientos, pero, a diferencia de la investigación básica, se crean para responder a un problema específico desde todos los ámbitos de la sociedad (OECD, 2018). Este tipo de investigación utiliza los principios científicos y los hallazgos previos para desarrollar innovaciones, mejorar procesos o crear nuevos productos que respondan a necesidades específicas de la sociedad o el mercado, desempeñando un papel crucial en la transferencia de conocimientos desde el ámbito académico hacia el sector productivo, contribuyendo así al progreso tecnológico y al desarrollo socioeconómico (Duoc, 2022).
Observatorio Duoc UC / Anuario 2024 / página 298
Observatorio de la Educación Superior Técnico Profesional - Producción y gestión del conocimiento

Equipo de Desarrollo proyecto EmotionLab 1er Lugar DemoDay 2023. Estudiantes de las Escuelas de Comunicación, Salud e Informática y Telecomunicaciones junto al Docente Investigador Cristian Molina.
Centro Tecnológico de la Escuela de Informática y Telecomunicaciones
El Centro Tecnológico de Duoc UC, iniciativa del plan estratégico de la Escuela de Informática y Telecomunicaciones de Duoc UC, tiene el propósito de potenciar la creación de proyectos de innovación tecnológica, fomentar el desarrollo de investigación aplicada y generar transferencia tecnológica, a través de nuestros docentes y estudiantes como protagonistas, procurando un entorno multidisciplinario y en colaboración con los sectores público, privado, academia y la sociedad en general.
Se desea posicionar a la Escuela de Informática y Telecomunicaciones de Duoc UC, como un líder en el desarrollo de soluciones tecnológicas creativas, innovadoras y efectivas, que permita entregar respuestas a los desafíos actuales de la sociedad.
Líneas prioritarias de investigación
Con el fin de consolidar el trabajo en Investigación Aplicada, Innovación y Transferencia Tecnológica, la Escuela de Informática y Telecomunicaciones ha establecido cinco líneas prioritarias de investigación. Estas líneas incluyen Inteligencia Artificial, Ciberseguridad, Tecnología 5G e IoT, Robótica y Metaverso. El objetivo de desarrollar estas líneas es abordar soluciones tecnológicas que aumenten la productividad, reduzcan costos y mejoren la calidad de la producción y los servicios en diversos sectores industriales del país.
Observatorio Duoc UC / Anuario 2024 / página 299
Observatorio de la Educación Superior Técnico Profesional - Producción y gestión del conocimiento

Participación del Docente Investigador Cristian Molina en el Smart City Summit 2024 30 ideas para el cambio. Ponencia “Realidad Virtual como herramienta para distintas soluciones”. Centro Tecnológico Duoc UC.
Metaverso
En este sentido, la transformación digital y la irrupción del metaverso se integran cada vez con mayor celeridad en la vida de las personas, ofreciendo numerosas posibilidades terapéuticas y soluciones para mejorar la calidad de vida. La idea del Metaverso es la creación de una realidad virtual donde las sociedades estén compuestas por avatares en un entorno digital (Park & Kim, 2022). Esta tecnología en el ámbito educativo permitirá crear experiencias de aprendizaje más inmersivas, reducir la brecha de escenarios reales sustituyéndolos con entornos virtuales que generen en el estudiante la capacidad para experimentar de manera segura durante su aprendizaje. Por consiguiente, las tendencias en el diseño de interfaces deben incluir interacción, que resulte familiar y fluida, narrativa y audio, elementos que permitan utilizar el sentido humano proporcionando una experiencia de aprendizaje inmersiva, enriquecedora y significativa (Lepez, 2022).
En consecuencia, desde el 2023 se implementa en el Centro Tecnológico el Laboratorio de Investigación y Desarrollo con Tecnologías Inmersivas (LIDETI) un espacio de experimentación donde se estudia a los usuarios en su hábitat cotidiano, lo que en la literatura se conoce como LIVING LABS (Canales & Muñoz, 2024) y que nace con el objetivo de aportar hacia la transformación tecnológica de la institución incursionando en nuevas estrategias pedagógicas y nuevas tecnologías para favorecer el aprendizaje de nuestros estudiantes, donde se utiliza la realidad virtual, la realidad aumentada o mixta, que son un conjunto de técnicas que permiten a los usuarios interactuar con el mundo real y virtual de forma inmersiva (Cabero &
Observatorio Duoc UC / Anuario 2024 / página 300
Observatorio de la Educación Superior Técnico Profesional - Producción y gestión del conocimiento
Fernández, 2018). La realidad virtual y aumentada superpone elementos digitales, como imágenes y sonidos, al mundo real a través de dispositivos como smartphones o gafas especiales, mientras que la realidad mixta combina elementos tanto del mundo real como del virtual, permitiendo la interacción en tiempo real con ambos entornos (Campo-Prieto et al., 2021).
En LIDETI se busca promover a nuestros estudiantes hacia la investigación, desarrollo e innovación, alineado con las políticas institucionales, de gobierno y empresariales, para que su formación cuente con el sello diferenciador de Duoc UC y que puedan aportar al desarrollo de la sociedad. Esto se realiza a través de la ejecución de distintos proyectos de investigación aplicada donde participan estudiantes y docentes de distintas escuelas, como la de Comunicación, Diseño, Salud e Informática y Telecomunicaciones. El objetivo de LIDETI es diseñar, desarrollar e Implementar experiencias de aprendizaje con dispositivos tecnológicos inmersivos con el objetivo de favorecer el proceso de enseñanza y aprendizaje de los estudiantes, utilizando metodologías como el Desingn Thinkin y Scrum herramientas clave para abordar proyectos de investigación aplicada.
Dentro de los proyectos destacables está el prototipo de realidad virtual “EmotionLab” el cual pretende simular un entorno lo más parecido a situaciones académicas de alta exigencia para aplicar experiencias de aprendizaje por medio de realidad virtual inmersiva para la identificación y gestión de emociones en sujetos que ingresan a la educación superior. Por otro, lado está el proyecto “NeuroFlex VR” el cual pretende establecer que la realidad virtual puede ser una herramienta prometedora para mejorar la salud cognitiva y física en los adultos mayores. Y Finalmente el prototipo “SportMind VR” diseñado como herramienta pedagógica para la regulación emocional de deportistas de alto rendimiento.

Observatorio Duoc UC / Anuario 2024 / página 301
Observatorio de la Educación Superior Técnico Profesional - Producción y gestión del conocimiento
El desarrollo de estos proyectos ha permitido generar nuevo conocimiento, elaborar artículos científicos y participar en espacios de difusión científica como el II Congreso Internacional de Investigación Educativa (CIIE 2024) celebrado en agosto del presente año y el IXº Congreso Iberoamericano de Psicología del Deporte, a celebrarse en octubre de este año, en la Facultad de Ciencias de la Educación y el Deporte de la Universidad de Vigo, España.
Tanto estudiantes como docentes que participan en proyectos que involucran tecnologías inmersivas que impactan la sociedad (donde está integrada la producción de conocimiento) consideran que esto es crucial para su educación y el desarrollo de habilidades del siglo XXI. En estos entornos, cultivan habilidades como la resolución de problemas y el pensamiento crítico, mientras adquieren experiencia práctica con métodos y herramientas de investigación. Esta implicación es esencial para su crecimiento y la adquisición de competencias vitales para la era moderna.
Además, la participación en estos proyectos fomenta la creatividad y la innovación, permitiendo a los estudiantes y docentes explorar nuevas formas de aplicar las tecnologías inmersivas en diversos campos. Esta experiencia no solo enriquece su formación académica, sino que también los prepara para enfrentar los desafíos del mundo laboral actual y futuro, donde la adaptabilidad y el dominio de las nuevas tecnologías son cada vez más valorados.
Finalmente, esta productividad académica es la que genera proyectos de gran utilidad, investigaciones, registro de propiedad intelectual, publicaciones científicas y tecnológicas, que pueden ser a futuro productos financiados por fondos públicos o privados que avalan la importancia del desarrollo de estas tecnologías.
Referencias
Cabero, J., & Fernández, B. (2018). Las tecnologías digitales emergentes entran en la Universidad: RA y RV. RIED. Revista Iberoamericana de Educación a Distancia, 21(2), 119. https://doi.org/10.5944/ried.21.2.20094
Campo-Prieto, P., Cancela, J. M., & Rodríguez-Fuentes, G. (2021). Immersive virtual reality as physical therapy in older adults: Present or future (systematic review). Virtual Reality, 25(3), 801-817. https://doi.org/10.1007/s10055-020-00495-x
Canales, L. E., & Muñoz, R. A. (2024). Laboratorio de investigación aplicada a la educación técnico-profesional en Chile. RAN. Revistas Academia y Negocios, 10(1), 234-236. https://doi.org/10.29393/ran-prc-10lilr20010
Duoc, U. C. (2022). Investigación aplicada. Biblioteca Digital Dirección de Innovación e Investigación Aplicada.
Guevara-Pezoa, F. (2023). Educación técnico-profesional: En rumbo a transformarse en actor clave para el ecosistema de innovación chileno. Rumbos TS. Un espacio crítico para la reflexión en Ciencias Sociales, 29, 31-46. https://doi.org/10.51188/rrts. num29.720
Lepez, C. O. (2022). Metaverso y educación: Una revisión panorámica. Metaverse Basic and Applied Research, 1, 2. https://doi. org/10.56294/mr20222
OECD. (2018). Manual de Frascati 2015: Guía para la recopilación y presentación de información sobre la investigación y el desarrollo experimental. OECD. https://doi.org/10.1787/9789264310681-es
Park, S.-M., & Kim, Y.-G. (2022). A Metaverse: Taxonomy, Components, Applications, and Open Challenges. IEEE Access, 10, 42094251. https://doi.org/10.1109/access.2021.3140175
Esta columna fue publicada el 23 de septiembre de 2024
Observatorio Duoc UC / Anuario 2024 / página 302
Los desafíos de la ciberseguridad

La ciberseguridad se ha convertido en un pilar fundamental para garantizar la continuidad operacional y la protección de los activos de información en las instituciones de educación superior. Con la transformación digital (TX) avanzando rápidamente, enfrentamos un aumento de nuestra dependencia y uso de tecnologías y sistemas, lo que amplía la superficie de ataque. Si a este incremento le sumamos la aparición permanente de nuevas amenazas, junto con la vasta cantidad de datos sensibles que se manejan en la institución, son hechos que nos convierte en objetivos atractivos para los ciberdelincuentes. Para enfrentar estos desafíos, es necesario adoptar un enfoque integral que involucre tanto la implementación de tecnologías como la construcción de una cultura de ciberseguridad.
Debemos recordar que Chile fue el cuarto país de Latinoamérica más afectado por ciberataques durante 2023, siendo superado solo por Brasil, México y Argentina[1].
1. La superficie de ataque: Un reto en expansión
El número creciente de sistemas, plataformas y herramientas digitales utilizados en una institución como Duoc UC, con más de 108.000 estudiantes, conlleva considerablemente un aumento en la superficie de ataque. Cada nuevo sistema o tecnología implementada puede introducir vulnerabilidades que los atacantes podrían explotar. Desde los entornos de aprendizaje virtual hasta los sistemas de gestión académica, todos los componentes de esta infraestructura digital deben ser monitoreados y protegidos para evitar brechas de seguridad.
[1] EntelDigital.
Observatorio Duoc UC / Anuario 2024 / página 303
Observatorio de la Educación Superior Técnico Profesional - Producción y gestión del conocimiento
El monitoreo continuo de las infraestructuras críticas y la realización de auditorías, tanto internas como externas, son clave para identificar y mitigar vulnerabilidades. Es esencial realizar pruebas de penetración en las redes (pentesting) de manera periódica, lo que permite probar la seguridad de los sistemas y corregir debilidades antes de que sean aprovechadas en un ataque real.
La implementación de controles de seguridad como el multifactor de autenticación (MFA) y el cifrado de datos en reposo y en tránsito es un primer paso, pero el verdadero desafío radica en mantenerse al día frente a las nuevas amenazas y vulnerabilidades que surgen constantemente. El análisis de eventos y alertas de seguridad, que en muchas instituciones grandes puede superar los miles de alertas mensuales, requiere un enfoque automatizado mediante el uso de tecnologías como la inteligencia artificial y el aprendizaje automático. En Duoc UC, por ejemplo, tenemos entre 100.000 y 300.000 eventos detectados y bloqueados al mes por nuestros sistemas de seguridad perimetral, más de 150.000 eventos bloqueados por antivirus al mes y más de 400 alertas del SOC (Centro de operaciones de seguridad) atendidas por nuestro equipo de ciberseguridad al mes.
2. Cultura de ciberseguridad: Un enfoque integral
Una de las principales lecciones en ciberseguridad es que la responsabilidad no es exclusiva del equipo técnico.Es fundamental que cada miembro de nuestra comunidad educativa, desde estudiantes hasta proveedores externos, estén involucrados en la protección de la información para mantener la información personal a salvo y proteger a Duoc UC. Sin esta participación activa de cada uno de nosotros, cualquier medida técnica que se implemente podría quedar vulnerable a los errores humanos.
Capacitación continua
Un aspecto clave en la creación de una cultura de ciberseguridad es la capacitación continua. Todos los colaboradores deben estar capacitados para identificar amenazas comunes como correos electrónicos de phishing, usar contraseñas seguras y manejar con precaución la información sensible. Iniciativas como el curso de ciberseguridad que se ha implementado para todos en la institución, con el 70% de participantes ya capacitados, son pasos esenciales. El desafío es alcanzar el 100% de colaboradores formados en buenas prácticas de ciberseguridad. Sin embargo, la capacitación no puede ser un evento aislado. Las amenazas cibernéticas evolucionan rápidamente, por lo que es necesario que las instituciones actualicen y refuercen constantemente el conocimiento de su comunidad sobre nuevas tácticas de ataque y las mejores maneras de mitigarlas.
Concientización
La concientización es otro pilar esencial. No basta con formar a la comunidad académica; también es necesario que todos comprendan porqué es importante la ciberseguridad. Las campañas internas, como los ejercicios simulados de phishing, son una excelente manera de mantener el tema en la mente de todos. Este tipo de simulaciones permiten identificar errores comunes y corregirlos de manera constructiva. En Duoc UC estos ejercicios nos han permitido reducir el porcentaje de personas que caen en intentos de phishing del 20% al 4%, lo que demuestra la efectividad de estas tácticas.
Observatorio Duoc UC / Anuario 2024 / página 304
Observatorio de la Educación Superior Técnico Profesional - Producción y gestión del conocimiento
Otras herramientas como videos educativos sobre el uso adecuado del correo electrónico, el manejo de contraseñas y la importancia de realizar respaldos regulares también nos están ayudando a reforzar esta concientización. Además, el acceso a un sitio dedicado a la ciberseguridad en la intranet de Duoc UC ofrece a la comunidad una fuente confiable de información y recursos para mantenerse al tanto de las mejores prácticas[2].
Simulaciones
Las simulaciones de ciberataques son una herramienta poderosa para preparar a la institución ante incidentes reales. Estos simulacros permiten probar la capacidad de respuesta de los equipos y la efectividad de las políticas de seguridad y controles existentes. Tal como ocurre con los simulacros de incendio, las simulaciones de ciberseguridad permiten a la comunidad reaccionar rápidamente ante una situación de emergencia, minimizando los daños y asegurando la continuidad operacional.
Además, estos ejercicios permiten identificar las áreas más vulnerables de la organización, facilitando la asignación de recursos y esfuerzos hacia los puntos más críticos. Las instituciones de educación superior que practican regularmente estas simulaciones están mejor preparadas para enfrentar ciberataques en el mundo real[3].
3. Protección de datos: un activo crítico
Los datos personales y académicos de los estudiantes y colaboradores se han convertido en uno de los activos más valiosos y vulnerables de las instituciones educativas. La privacidad de los estudiantes y la confidencialidad de sus registros son objetivos frecuentes de los ciberdelincuentes, quienes pueden buscar extorsión o venta de información en mercados ilegales.
Una fuga de datos no solo puede interrumpir las operaciones diarias de la institución, sino que también puede generar consecuencias legales y dañar la reputación. Por ello, es imperativo implementar estrictas políticas de protección de datos. Esto incluye la encriptación de la información tanto en reposo como en tránsito, la gestión cuidadosa de los accesos y la realización de auditorías de seguridad regulares.
4. Continuidad operacional: Preparación para lo inevitable
Uno de los riesgos más grandes que enfrenta una institución de educación superior es la interrupción de sus operaciones debido a un ciberataque. Un ataque exitoso puede detener clases, exámenes y afectar tanto el registro académico como los servicios administrativos.
[2]. Videos de la campaña de ciberseguridad aquí: https://www.youtube.com/playlist?list=PLCt7oZdUU6CQa2kWBq1oqYys17xhYIGXp
[3]. Conoce el sitio de Seguridad de la Información y Ciberseguridad en la Intranet de Duoc UC.
Observatorio Duoc UC / Anuario 2024 / página 305
Observatorio de la Educación Superior Técnico Profesional - Producción y gestión del conocimiento
Para mitigar este riesgo, es esencial contar con un Plan de Continuidad del Negocio (BCP) que identifique los riesgos principales, estime el impacto potencial y establezca medidas para minimizar los daños. La preparación incluye pruebas regulares de estos planes a través de simulaciones de ciberataques y pentesting.
Un buen plan de continuidad asegura que, incluso en el peor de los casos, la institución pueda reanudar rápidamente sus operaciones, protegiendo tanto su reputación como la experiencia educativa de los estudiantes.
Consideraciones finales
Los desafíos de ciberseguridad en las instituciones de educación superior son vastos y complejos. Para enfrentarlos de manera efectiva, es esencial adoptar un enfoque integral que abarque tanto la implementación de soluciones tecnológicas avanzadas como la creación de una cultura de ciberseguridad. Desde la capacitación continua y las simulaciones hasta la protección estricta de los datos y la preparación para asegurar la continuidad operacional, cada aspecto de la ciberseguridad debe ser gestionado de manera proactiva.
Las instituciones que invierten en ciberseguridad no solo protegen sus operaciones y reputación, sino que también garantizan un entorno seguro y confiable para su comunidad educativa. ¡En Duoc UC la ciberseguridad es tarea de todas y todos!
Esta columna fue publicada el 28 de octubre de 2024
Observatorio Duoc UC / Anuario 2024 / página 306
Observatorio de la Educación Superior Técnico Profesional - Producción y gestión del conocimiento
Más Mujeres en ciberseguridad

En Chile, en el mes de octubre conmemoramos el Mes de la Ciberseguridad, un pilar fundamental para el desarrollo de cualquier economía. En nuestro país, el desafío de formar profesionales en esta área está creciendo de manera significativa. En plena era digital, la demanda de expertos en ciberseguridad es más urgente que nunca. No obstante, este reto se ve agravado por la baja participación de mujeres en un sector históricamente dominado por hombres.
El informe de la Política Nacional de Ciberseguridad 2023-2028 consignó un objetivo clave: Fomentar la participación femenina en roles técnicos y de liderazgo. Esta meta no solo es un paso hacia la equidad de género, sino que responde a una demanda creciente de talento en un área con un notable déficit de profesionales. Actualmente, solo el 27% de los puestos en ciberseguridad en Chile están ocupados por mujeres. Esta cifra no solo constituye un problema de representación, sino una vulnerabilidad en un campo en donde la diversidad de perspectivas es crucial.
La ciberseguridad enfrenta desafíos cada vez más complejos. Solo en el primer trimestre de 2024, el Equipo de Respuesta a Incidentes de Seguridad (CSIRT) del Gobierno gestionó 54 incidentes de ciberseguridad en los sectores público y privado. Ante esta realidad, se vuelve imperativo implementar programas que formen profesionales en el área, aprovechando también esta oportunidad para fomentar la participación femenina en las áreas STEM (Ciencia, Tecnología, Ingeniería y Matemáticas) desde una edad temprana. Las estadísticas revelan que solo el 19.7% de los matriculados en estas carreras son mujeres, lo que indica que la brecha de género comienza mucho antes de la entrada al mercado laboral.
El Foro Económico Mundial ha informado que las empresas con un liderazgo de género diverso obtienen mayores márgenes operativos y toman mejores decisiones empresariales. Aplicar un plan de ciberseguridad con éxito requiere un pensamiento creativo, flexible y estratégico, conexión humana y comunicación a nivel organizativo. Equilibrar la brecha de género en ciberseguridad no es solo un imperativo moral; es una
Observatorio Duoc UC / Anuario 2024 / página 307
Observatorio de la Educación Superior Técnico Profesional - Producción y gestión del conocimiento
necesidad estratégica para garantizar la seguridad y el éxito empresarial, considerando que la ciberseguridad enfrenta desafíos más complejos y en constante evolución, las mujeres aportan diferentes enfoques y formas de pensar, lo que enriquece la capacidad de un equipo para resolver problemas de manera más creativa e innovadora y donde las decisiones rápidas y estratégicas son cruciales, un enfoque inclusivo puede marcar la diferencia entre prevenir o sufrir una violación de seguridad y fortalecer su competitividad en un mundo digital cada vez más desafiante.
A nivel global, la escasez de talento en ciberseguridad es alarmante; en el informe Strategic Cybersecurity Talent Framework 2024, del Foro Económico Mundial, menciona una escasez de casi 4 millones de profesionales en ciberseguridad. Esta situación resalta la necesidad urgente de atraer a más personas, especialmente a mujeres, a este campo laboral. Es fundamental cambiar la percepción sobre las capacidades de las mujeres en carreras tecnológicas, priorizando su participación en puestos de ciberseguridad y, eventualmente, en posiciones de liderazgo. Para lograrlo, iniciativas como programas de mentoría, becas y redes de apoyo son esenciales para empoderar a las mujeres interesadas en esta área. Hacemos un llamado urgente a priorizar la inclusión del talento femenino en las disciplinas STEM, y en particular en el ámbito de la ciberseguridad. Solo así podremos contar con profesionales altamente capacitados que aporten soluciones valiosas en un entorno digital en constante evolución. Para Chile, es fundamental que la formación técnica en ciberseguridad se convierta en una prioridad nacional, garantizando una preparación diversa y robusta para enfrentar las amenazas del futuro. La ciberseguridad no solo necesita más mujeres, sino también las perspectivas únicas y complementarias que pueden surgir de la colaboración entre hombres y mujeres, hacia una solución integral, inclusiva, equitativa y sostenible.
Esta columna fue publicada el 28 de octubre de 2024
Observatorio Duoc UC / Anuario 2024 / página 308
Observatorio de la Educación Superior Técnico Profesional - Producción y gestión del conocimiento
Mes de la ciberseguridad en Duoc UC
Óscar Araya Tagle

Subdirector de la Escuela de Informática y Telecomunicaciones de Duoc UC.
Octubre ha sido un mes trascendental para Duoc UC, enmarcado en el Mes de la Ciberseguridad, un mes que no solo pone de relieve la importancia de la ciberseguridad en la sociedad, sino que también reafirma el compromiso de nuestra institución con la formación integral de nuestros estudiantes, la vinculación con la industria y la comunidad en este ámbito crítico.
A lo largo del mes se han desarrollado una serie de actividades por parte de la Escuela de Informática y Telecomunicaciones, con más de 15 conferencias y desafíos que han involucrado tanto a nuestros estudiantes como a destacados profesionales de la industria con participación a nivel nacional, en donde han participado durante el mes más de 900 estudiantes. Desde la inauguración del mes en Viña del Mar, pasando por los seminarios, en Maipú, Concepción, Valparaíso, Puerto Montt y campus virtual, hasta los Desafíos CTF (Capture the Flag) realizados en Melipilla, nuestros estudiantes han tenido la oportunidad de enfrentarse a escenarios reales y simulados, que ponen en valor la relevancia e importancia que entrega Duoc UC a este tipo de actividades, enriqueciendo el proceso formativo de nuestros estudiantes.
Otra actividad muy esperada fue el evento realizado en conjunto con la Pontificia Universidad Católica y el Ejército de Chile, Primer Ejercicio de Gestión de Crisis Ciberlab para la infraestructura critica, donde un equipo de estudiante y docente de Duoc UC, tanto de la Escuela de Informática como Escuela de Ingeniería, participaron en la construcción de una maqueta a escala de un aeropuerto, con el propósito de realizar distintos ejercicios de simulación. Además de ello los estudiantes participaron en un desafío (Capture the Flag) en donde participaron más de 60 equipos de distintitas organizaciones públicas y privadas, todos profesionales de la ciberseguridad. Nuestros estudiantes y docentes obtuvieron desacatada participación consiguiendo un 4° lugar en este desafío.
Observatorio Duoc UC / Anuario 2024 / página 309
Observatorio de la Educación Superior Técnico Profesional - Producción y gestión del conocimiento

de estudiante, docentes y colaboradores de
Entre los eventos más destacados, el 7mo Seminario Internacional de Ciberseguridad de la Escuela de Investigaciones de Chile – PDI fue un hito significativo para Duoc UC, primer año en que participamos en la organización del evento, donde expertos nacionales e internacionales debatieron sobre las nuevas amenazas en el ciberespacio y las estrategias que tanto el sector público como privado deben adoptar para enfrentarlas.
Nuestro docente Nicolás Contador, Coordinador de Línea Nacional de Ciberseguridad tuvo desacatada participación, realizando una ponencia en la feria tecnológica del seminario, sobre su experiencia implementando un Centro de Operaciones de Ciberseguridad de código abierto y libre, en nuestro Centro Tecnológico.
Uno de los puntos más altos, fue la realización de nuestro SummIT de Ciberseguridad, que se llevó a cabo en la sede Plaza Norte de Duoc UC.Entre los principales oradores estuvieron: Francisco Guzmán, Presidente de ACTI, Kenneth Pugh, Senador de la República de Chile y Cristián Bravo, Director del CSIRT de Gobierno de Chile, que aportaron una visión integral sobre las amenazas emergentes y las soluciones innovadoras que las organizaciones deben implementar para proteger sus sistemas. Participaron también Daniel Álvarez, Coordinador Nacional de Ciberseguridad del Gobierno de Chile, además destacamos la participación Rocío Ortiz del Centro de Innovación UC y Danic Maldonado, Comisario de la Jefatura Nacional de Cibercrimen.
Además, la presencia de experto internacional que nos visitaba desde Estados Unidos, como Dmitry Bestúzhev, ex director del Equipo Global de Investigación y Análisis de Kaspersky en América Latina, quien además de destacar en su ponencia, compartió con toda la comunidad académica su vasta experiencia sobre las amenazas más recientes en el ciberespacio, subrayando la importancia de mantenerse a la vanguardia en el uso de tecnologías emergentes, como la inteligencia artificial, para anticipar y contrarrestar ataques sofisticados, temas que también profundizo en un importante taller realizado durante la jornada para nuestros estudiantes y docentes.
Observatorio Duoc UC / Anuario 2024 / página 310
Observatorio de la Educación Superior Técnico Profesional - Producción y gestión del conocimiento

Durante este SummIT, también se dio cuenta del trabajo que se vienen realizando por parte de nuestra Escuela, profundizado el trabajo realizado en Ciberseguridad, yendo más allá, incorporando un línea de especialización en ciberseguridad para todas las carreras de las Escuela de Informática y Telecomunicaciones, a través de optativos que incluyen módulos como Ciberseguridad en Sistemas Operativos y Redes, Ciberseguridad en Desarrollo de software, Tecnologías Cloud y Contenedores, Ciberseguridad Ofensiva y Defensiva, con esto nuestros estudiantes adquieren competencias claves que les permiten identificar, mitigar y resolver ciber amenazas que cada vez son más complejas y sofisticadas. Además, hemos desarrollado programas de educación continua, como el Diplomado en Ciberseguridad Avanzada y el Diplomado en Ciberseguridad Corporativa, que se suman a la oferta existente. Diseñados para profesionales que buscan actualizar sus conocimientos, enfrentar los crecientes desafíos que experimentan las organizaciones en todo el mundo y la fuerte demanda por profesionales en el área de ciberseguridad.
Observatorio Duoc UC / Anuario 2024 / página 311
Observatorio de la Educación Superior Técnico Profesional - Producción y gestión del conocimiento

En los últimos años, hemos avanzado de manera sólida y consistente en la formación de profesionales altamente especializados en ciberseguridad, respondiendo eficazmente tanto a las demandas del mercado como a los desafíos de nuestra sociedad. Nuestro enfoque curricular, acompañado de una activa vinculación con el medio, nos ha permitido colaborar estrechamente con organizaciones públicas y privadas, consolidando el papel clave de Duoc UC en la preparación de profesionales no solo capacitados técnicamente, sino también con un fuerte compromiso ético, esenciales para enfrentar los retos del futuro.
Observatorio Duoc UC / Anuario 2024 / página 312
Transformando el Aprendizaje Digital:
Mi Experiencia en Blackboard Academy y su impacto en mi rol como docente y asesor UAP

A fines del año 2019, nos vimos obligados a adaptarnos rápidamente a una modalidad de enseñanza completamente nueva: las clases online. No estábamos preparados para esto, pero era solo el inicio de una serie de cambios que nos afectaría en los años siguientes, no solo en nuestro trabajo, sino también en nuestra forma de vida. En ese entonces, apenas sabíamos manejar plataformas de videoconferencia y, mucho menos, cómo planificar actividades que mantuvieran a nuestros estudiantes motivados y comprometidos en un ambiente virtual desconocido. Fue un proceso de aprendizaje constante, enfrentándonos a retos y buscando formas innovadoras de seguir entregando una educación de calidad. Paulatinamente, desde el 2021 comenzamos a retomar lo que conocíamos como la normalidad y en el 2022, Duoc UC toma un nuevo desafío: la implementación de Blackboard Ultra, una versión mejorada de nuestro AVA. Luego de habernos familiarizado con la versión anterior y haber aprovechado sus potencialidades al máximo, comenzamos con una nueva plataforma que traía consigo múltiples oportunidades, también nuevos retos. Con tiempo y esfuerzo, logramos dominar sus funciones, viendo en cada actualización la oportunidad de mejorar nuestra práctica docente.
Estas dos realidades, la enseñanza online y el cambio en la plataforma, se unieron de manera significativa mediante en una serie de capacitaciones sobre Enseñanza y Aprendizaje Digital, dictado por Blackboard Academy. Este programa se componía de tres cursos, cada uno de dos meses de duración: Fundamentos en la Enseñanza y Aprendizaje Digital, para identificar los elementos esenciales de un curso a distancia; Diseño de la Enseñanza y Aprendizaje Digital, enfocado en la creación de cursos en un entorno virtual desde cero; y Excelencia en la Enseñanza y Aprendizaje Digital, que se centraba en la evaluación y mejora
Observatorio Duoc UC / Anuario 2024 / página 313
Observatorio de la Educación Superior Técnico Profesional - Producción y gestión del conocimiento
de cursos en línea. Como asesor en Tecnología Educativa de la Unidad de Apoyo Tecnológico (UAP), tuve la oportunidad de participar en estos cursos, reflexionando sobre cómo nuestra práctica docente puede adaptarse para ser efectiva en entornos virtuales.
Aunque actualmente solo imparto clases presenciales, el aprendizaje logrado en estas capacitaciones ha sido un gran aporte para mi labor. En primer lugar, me ha ayudado a buscar formas más efectivas de presentar los contenidos en el Aula Virtual de Aprendizaje (AVA). Aunque la estructura general de nuestros cursos es establecida de manera centralizada, siempre hay espacios para mejorar y personalizar, ya sea en la forma o en el contenido, con el objetivo de ofrecer la mejor experiencia posible a nuestros estudiantes. Además, las reflexiones constantes durante las sesiones, orientadas a la enseñanza online, me llevaron a cuestionar mis prácticas presenciales y buscar maneras de mejorarlas, aprovechando los mismos recursos que ya utilizo.
Uno de los aprendizajes más valiosos de esta capacitación ha sido la importancia de la evaluación constante, tanto en la creación como en la implementación de un curso. La retroalimentación, tanto de pares como de estudiantes, proporciona información crucial para mejorar futuras versiones del curso. Este proceso de evaluación también es fundamental en la enseñanza presencial: no todas las actividades o metodologías producen los resultados esperados, y solo a través de la reflexión crítica y la apertura a comentarios podemos mejorar. Además, cada curso tiene una realidad única, por lo que debemos adaptar nuestras estrategias a las características y necesidades específicas de cada grupo.
El aporte de estas capacitaciones también ha tenido un impacto positivo en mi rol de asesor UAP en Tecnologías Educativas. Por un lado, el tener la posibilidad de utilizar la plataforma Blackboard Ultra para la creación de cursos online de modo experimental, permite adquirir una soltura que es fundamental al momento de acompañar a los docentes que requieren asesorías, no tan solo respondiendo sus dudas puntuales, sino también mostrando nuevas formas de poder abordar sus dificultades, mejorando así la experiencia de los docentes con la plataforma. Además, desde una perspectiva educativa, los contenidos aprendidos permiten mirar las problemáticas que puedan tener los docentes y cómo se resuelven a través del acompañamiento tecnológico, enriqueciendo las actividades, de modo que resulten motivadoras para nuestros estudiantes.
Estoy muy agradecido con la institución por brindarme la oportunidad de participar en esta capacitación, volver a estudiar siempre representa un desafío, pero en la docencia, estos desafíos son necesarios. Necesitamos trabajar en la mejora continua, no solo en la disciplina que enseñamos, sino también en las metodologías que utilizamos. Cada instancia de formación es una oportunidad para crecer, y debemos aprovecharlas al máximo.
Esta columna fue publicada el 4 de noviembre de 2024
Observatorio Duoc UC / Anuario 2024 / página 314
Transformación digital y educación:
novedades
del nuevo CAPE de redes y telecomunicaciones para el 2025
Óscar Araya Tagle

Subdirector de la Escuela de Informática y Telecomunicaciones
de Duoc UC.
En la era digital en la que vivimos, la conectividad y las telecomunicaciones juegan un rol crucial en la transformación de nuestras sociedades. En este contexto, los programas de estudios en tecnología exigen de una ágil actualización, diferenciarse con innovación y estar a la vanguardia, adaptándose a las necesidades cambiantes del sector y ofreciendo soluciones formativas que respondan a los retos del futuro.
La nueva propuesta curricular del CAPE para el 2025 se centra en fortalecer tanto el nivel técnico como el profesional de sus programas. Esta renovación se enfoca en desarrollar perfiles que no solo dominen las tecnologías emergentes, sino que también sean capaces de integrar conceptos de tecnología, sustentabilidad e innovación en sus prácticas. La formación en ciberseguridad, inteligencia artificial e internet de las cosas, se ha convertido en una prioridad, preparando a los estudiantes para enfrentar las amenazas y desafíos del mundo digital moderno. Además, la analítica de datos y el diseño ágil de soluciones de innovación, son competencias esenciales que se abordan en el nuevo currículo, asegurando que los futuros profesionales tengan una comprensión profunda de las necesidades del negocio y las capacidades técnicas para satisfacerlas.
La incorporación de metodologías activas y el uso de tecnologías de punta en el proceso educativo, es otro punto para destacar es la implementación de experiencias de aprendizaje inmersivas a través de la realidad virtual. Esta innovadora metodología complementa las prácticas en laboratorios de redes, ofreciendo a los estudiantes una experiencia educativa que simula situaciones reales de manera segura y controlada, dentro las cuales se consideran: el trabajo en altura y espacios confinados, riesgo eléctrico, armado de PC y fusión de fibra óptica. Este tipo de escenarios prácticos son especialmente significativos para preparar a los estudiantes de la mejor forma para el mundo laboral exigente, donde deberán enfrentar y resolver problemas complejos en tiempo real.
Observatorio Duoc UC / Anuario 2024 / página 315
Observatorio de la Educación Superior Técnico Profesional - Producción y gestión del conocimiento
Entre otras novedades, se ha incorporado Especializaciones en las áreas de Ciberseguridad, IoT (Internet de las Cosas) y Automatización en Redes. Estas especializaciones tienen por objetivo, permitir que los estudiantes profundicen aún más en estas tecnologías y áreas de interés, adquiriendo competencias específicas siendo de gran utilidad en el ámbito profesional. Por otra parte, la incorporación de estas especializaciones responde a la creciente demanda de profesionales altamente capacitados en sectores clave de la tecnología, asegurando así que nuestros estudiantes estén a la vanguardia y preparados para los desafíos del futuro.
Las certificaciones en diversas tecnologías, como las que se ofrecen por CISCO, EC-Council y Redhat, forman parte del plan de estudios. Estas certificaciones no solo validan los conocimientos adquiridos, sino que también aumentan la empleabilidad de los egresados, quienes salen al mercado laboral con credenciales reconocidas internacionalmente.
El nuevo CAPE de Redes y Telecomunicaciones para el 2025 representa una actualización significativa en la formación de profesionales en esta área, la cual está en constante desarrollo tanto en el mundo como en nuestro país. Este avance responde a la necesidad de abordar importantes proyectos de telecomunicaciones que conectan personas y ciudades en lugares remotos, enfrentando desafíos en la seguridad de infraestructuras críticas. Además, se impulsa el desarrollo de ciudades inteligentes (Smart Cities) que proporcionan servicios más digitales, automatizados, eficientes y sustentables para una sociedad mejor.
Esta columna fue publicada el 15 de julio de 2024
Observatorio Duoc UC / Anuario 2024 / página 316
Observatorio de la Educación Superior Técnico Profesional - Producción y gestión del conocimiento
en Latinoamérica, el Tecnológico de Monterrey Visita inmersiva a un referente
José Ignacio Muñoz Faundez

Cientista de Datos y Análisis BI. Dirección de Estudios y Progresión Estudiantil.
Hace un par de semanas, tuve la oportunidad de participar en un viaje académico al Tecnológico de Monterrey como parte de mi programa de magíster. Esta experiencia resultó ser un verdadero enriquecimiento profesional y personal. Además de sumergirme en un ambiente de constante innovación, donde pude: ampliar mis conocimientos sobre las últimas tendencias en IA, establecer una valiosa red de contactos con profesionales y docentes de diversas disciplinas, y encontrar inspiración en proyectos pioneros que están redefiniendo la educación superior. Sin duda, esta experiencia ha impulsado mi desarrollo profesional y me ha motivado a buscar nuevas oportunidades de aprendizaje, las que espero implementar junto a mi equipo en Duoc UC.
El Tecnológico de Monterrey es una universidad privada, rankeada entre las 200 mejores del mundo en 2025[1], la séptima mejor de América Latina, siendo un referente en innovación y tecnología en la región. Entre los muchos aspectos que destacan, se identifican tres características que me parece hay que resaltar: la armonía de sus instalaciones, un campus altamente sustentable y creativo, y la palpable integración de la tecnología en el ambiente académico.
Campus armónico
A primera vista, la estética y funcionalidad del campus del TEC destaca. Entre sus amplias áreas verdes, diseñadas para el descanso y la recreación, resalta el “Espacio de Reflexión”. Dicha estructura representa a la potente geografía del valle de Monterrey, siendo un lugar silencioso y desconectado que invita a una experiencia de introspección y tranquilidad.
[1]. Conoce el sitio de Seguridad de la Información y Ciberseguridad en la Intranet de Duoc UC.
Observatorio Duoc UC / Anuario 2024 / página 317
Observatorio de la Educación Superior Técnico Profesional - Producción y gestión del conocimiento

Además, recorren libremente el campus: patos, pavos reales y hasta ciervos, generando una atmósfera de respeto por la naturaleza, un lujo en medio de un campus tan tecnológico.
En cada rincón, se pueden observar representaciones de la identidad del TEC representados en un carnero, mascota oficial, que da el nombre “Borregos” a los equipos deportivos y de actividades de competencia en general. Este nombre muestra el orgullo de estudiantes, los cuales se sienten representados, llevando los colores e insignias alusivas.
Campus orientado a la innovación y Sustentabilidad
El TEC no solo busca ser un referente académico, sino también un líder en innovación y sostenibilidad. Sus instalaciones están alineadas con estos objetivos, promoviendo la creatividad y la conciencia ecológica en cada rincón.
Sustentable: uno de los pilares del desarrollo es que sea sustentable y sostenible. De cierta forma, el TEC intenta “concientizar con el ejemplo”, y esto se puede observar en diferentes aspectos. Uno de ellos, es la biblioteca, la cual nos comentaron, fue construida utilizando madera reciclada de la antigua biblioteca. Además, en toda la universidad se encuentran puntos de hidratación diseñados para minimizar el desperdicio de agua, algo crucial en una ciudad como Monterrey, que ha enfrentado sequías en los últimos años.
Uno de los futuros proyectos en esta línea, es la construcción de un nuevo edificio que utilizará 100% de energías limpias, cuenta con materiales reciclados y disminuye su impacto ambiental (con medidas como aislación térmica y ahorro de energía).
Observatorio Duoc UC / Anuario 2024 / página 318
Observatorio de la Educación Superior Técnico Profesional - Producción y gestión del conocimiento
Emprendimiento: Monterrey se ha convertido en un “hub” de empresas tecnológicas que permiten la integración entre el medio empresarial y la universidad. Por ello, se fomentan habilidades necesarias para emprender. Durante la visita, distintos empresarios compartieron sus experiencias sobre los retos y beneficios de emprender, ofreciendo una visión realista y práctica a los estudiantes (“lo bueno, lo malo y lo difícil” de emprender).
Fomento de creatividad: para cumplir con una metodología orientada a la resolución de problemas, enfoque en la exploración e investigación, se requiere un entorno propicio. El campus está adaptado con diferentes colores en las salas y espacios de recreación para propiciar la creatividad. Además, las salas cuentan con mobiliario que facilita el desplazamiento y permite “romper el esquema” de las salas tradicionales con el objetivo de fomentar la discusión y el trabajo colaborativo.
Tecnología en el campus y los estudiantes en el centro
Si bien, se destaca como una universidad altamente vinculada con el entorno empresarial, el TEC se preocupa de llevar la tecnología al campus e integrarla en sus instalaciones con el propósito de ponerla a disposición de sus estudiantes. Más allá de declararlo, la tecnología es palpable:
Oxxo smart – grab&go: servicio que permite la autoatención mediante un sistema de monitoreo con cámaras y sensores. El pago de los productos se realiza utilizando una App que puede descargarse gratuitamente y activarla al enlazar una tarjeta. No tiene caja ni guardias, literalmente “grab and go”.
Data center: unas semanas antes de llegar, fue inaugurado un data center, el cual está orientado al almacenamiento de información en la nube y procesamiento datos. Si bien, este tipo de servicios puede contratarse con proveedores, la importancia de contar con servidores internos se basa en la oportunidad de generar desarrollos propios, autonomía en la investigación, altos niveles de seguridad y privacidad de la información.
Realidad Aumentada: esta tecnología para mejorar la experiencia inmersiva en el aprendizaje de los estudiantes. Además, cuenta con aplicaciones de realidad virtual (VR) mediante cursos prácticos que usan esta metodología para “practicar tareas de alto riesgo, pero a bajo costo”. Algunos ejemplos que mostraron:
o Realizar operaciones a pacientes virtuales pudiendo monitoreas los signos vitales para practicar procesos quirúrgicos (sin exponer la integridad de pacientes reales).
o Revisión de equipos industriales para evaluar fallas en el sistema y que realicen las reparaciones correspondientes para el correcto funcionamiento. En ese caso, se exponen diferentes indicadores mediante el uso de sensores para entregar mayor realismo a la toma de decisiones.
Otra aplicación inmersiva es el metaverso, donde su implementación se basa en una representación del campus que permite conocer las instalaciones, entrega “tips” de la conducta adecuada en el campus y que permite la interacción entre estudiantes dentro de la plataforma. Desde esta perspectiva su uso está más orientado a la experiencia que al aprendizaje.
Observatorio Duoc UC / Anuario 2024 / página 319
Observatorio de la Educación Superior Técnico Profesional - Producción y gestión del conocimiento

Gemelos digitales: corresponde a otra aplicación de realidad aumentada donde se simula una solución tecnológica (como una línea de producción), se parametriza y se enlaza a un símil en la realidad (mediante sensores, cámaras, controladores, entre otros). De esta forma, todo lo que sucede en la realidad, se puede controlar físicamente, pero también desde la simulación 3D generada por computadora.
Centro de manufactura aditiva: el TEC, así como Duoc UC, cuentan con un espacio para el desarrollo de impresiones 3D. El TEC, tiene impresoras a libre disposición de los estudiantes para que impriman sus proyectos. Cada estudiante lleva su material, agenda un horario y cuentan con una cantidad de ‘tokens’ que equivale al cobro por uso.
Además, existen talleres y charlas orientados a comprender el alcance de esta tecnología, ya que tiene usos diferentes a nivel industrial y existen variados tipos de manufactura que puede desarrollarse utilizando estas técnicas. Se concientiza del uso responsable de recursos y la minimización de los residuos (reciclando y reutilizando si es posible).
Análisis de sentimiento con IA: otra línea de proyectos en implementación es un sistema que detecta los estados de ánimo de los estudiantes durante la clase (utiliza cámaras para grabar
Observatorio Duoc UC / Anuario 2024 / página 320
Observatorio de la Educación Superior Técnico Profesional - Producción y gestión del conocimiento
las caras e identificar patrones en la expresión) cuyo propósito es entregar mayores herramientas a los docentes para que comprendan a sus estudiantes. Para esta aplicación, no se guarda la información individual sino a nivel de sección para garantizar el respeto a la privacidad.
Laboratorio para desarrollo de conducción autónoma: existe un laboratorio de vehículos autónomos donde se desarrollan prototipos de productos que intentan obtener datos para entrenar automóviles que conduzcan sin necesidad de un conductor. Si bien, la normativa en Chile no permite tales niveles de autonomía, saber que estudiantes del TEC están trabajando en ello, es interesante y demuestra que se podría promover iniciativas similares en nuestra institución.
En instancias de pruebas, se observa que el vehículo puede mejorar su desempeño en aceleración y curvas, no obstante, es una máquina capaz de conducirse automáticamente.
Uso de robótica: hay una línea de trabajo que se encarga de potenciar los mecanismos que permiten la interacción del vehículo con el entorno y le “enseñan” los patrones necesarios para “tomar decisiones”:
Cuentan con un robot autónomo que permite generar representaciones del entorno combinando la visión por computadora y el uso de sensores (tipo radar).
o Participé de un curso de automatización donde controlamos una pequeña “garra” siguiendo los patrones visuales que un usuario indica mediante la captura de imágenes por la cámara web.
En mi opinión, en contraste con la normativa chilena, se observan brechas en el tema de la ciberseguridad (no se mencionaron aspectos de seguridad de la información o lineamientos para desarrollos seguros). Para cerrar esta experiencia, les comento que Deninson Rangel escribió sobre la experiencia de colaboración entre TEC y Duoc UC en la implementación del Docente Holograma para potenciar el proceso de enseñanza-aprendizaje. Te dejo la columna por acá: Ver Observatorio.
En conclusión, contar con referentes como el Tecnológico de Monterrey nos permite establecer benchmarks para plantearnos nuevos desafíos, especialmente en un contexto internacional. Su enfoque en innovación, sustentabilidad y tecnología nos impulsa a avanzar como institución, formando profesionales preparados para un mundo en constante evolución.
1. Fuente: QS world ranking 2025
https://conecta.tec.mx/es/noticias/nacional/institucion/tec-de-monterrey-en-top-200-mundial-en-qsworld-rankings-2025
Esta columna fue publicada el 4 de noviembre de 2024
Observatorio Duoc UC / Anuario 2024 / página 321
Observatorio de la Educación Superior Técnico Profesional - Producción y gestión del conocimiento
Observatorio de la Educación Superior Técnico Profesional y gestión del conocimiento

Observatorio Duoc UC / Anuario 2024 / página 322